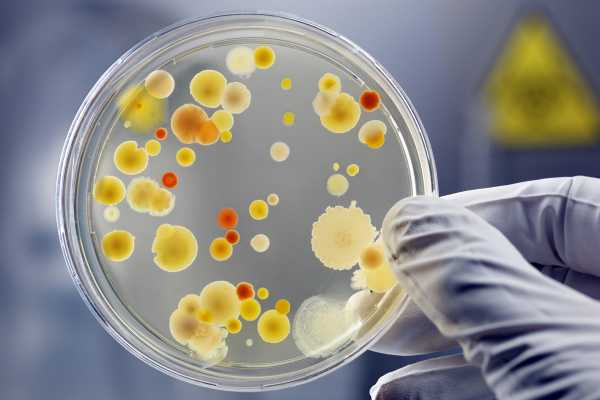

ΠΠ°ΠΊ Π½Π°ΡΠΈΠ½Π°Π΅ΡΡΡ ΠΊΠΎΠ½ΡΡΠ½ΠΊΡΠΈΠ²ΠΈΡ? — ΡΠ½ΡΠΈΠΊΠ»ΠΎΠΏΠ΅Π΄ΠΈΡ Ochkov.net
Π‘Π»Π΅Π·ΠΎΡΠ΅ΡΠ΅Π½ΠΈΠ΅, Π·ΡΠ΄, ΠΎΡΡΡΠ΅Π½ΠΈΠ΅ Β«ΠΏΠ΅ΡΠΊΠ°Β» Π² Π³Π»Π°Π·Π°Ρ β ΠΎΡΠ½ΠΎΠ²Π½ΡΠ΅ ΠΏΡΠΈΠ·Π½Π°ΠΊΠΈ ΠΊΠΎΠ½ΡΡΠ½ΠΊΡΠΈΠ²ΠΈΡΠ°. Π‘ Π½ΠΈΡ ΠΎΠ±ΡΡΠ½ΠΎ Π±ΠΎΠ»Π΅Π·Π½Ρ Π½Π°ΡΠΈΠ½Π°Π΅ΡΡΡ, ΠΏΠΎΡΠ»Π΅ ΡΠ΅Π³ΠΎ ΠΏΠΎΡΠ²Π»ΡΡΡΡΡ Π΄ΡΡΠ³ΠΈΠ΅, ΡΠΏΠ΅ΡΠΈΡΠΈΡΠ΅ΡΠΊΠΈΠ΅ ΡΠΈΠΌΠΏΡΠΎΠΌΡ. ΠΡΠΈ Π½Π΅ΠΊΠΎΡΠΎΡΡΡ ΡΠΎΡΠΌΠ°Ρ ΡΡΠΎΠ³ΠΎ Π½Π΅Π΄ΡΠ³Π° Ρ Π±ΠΎΠ»ΡΠ½ΠΎΠ³ΠΎ ΡΠ½Π°ΡΠ°Π»Π° ΠΏΠΎΠ²ΡΡΠ°Π΅ΡΡΡ ΡΠ΅ΠΌΠΏΠ΅ΡΠ°ΡΡΡΠ° ΡΠ΅Π»Π°, Π²ΠΎΠ·Π½ΠΈΠΊΠ°ΡΡ Π³ΠΎΠ»ΠΎΠ²Π½ΡΠ΅ Π±ΠΎΠ»ΠΈ. Π Π°ΡΡΠΌΠΎΡΡΠΈΠΌ ΠΏΠ΅ΡΠ²ΠΈΡΠ½ΡΠ΅ ΡΠΈΠΌΠΏΡΠΎΠΌΡ ΡΠ°Π·Π»ΠΈΡΠ½ΡΡ Π²ΠΈΠ΄ΠΎΠ² ΠΊΠΎΠ½ΡΡΠ½ΠΊΡΠΈΠ²ΠΈΡΠ°.
Π§ΡΠΎ ΡΠ°ΠΊΠΎΠ΅ ΠΊΠΎΠ½ΡΡΠ½ΠΊΡΠΈΠ²ΠΈΡ: ΠΎΠ±ΡΠ°Ρ Ρ Π°ΡΠ°ΠΊΡΠ΅ΡΠΈΡΡΠΈΠΊΠ° Π·Π°Π±ΠΎΠ»Π΅Π²Π°Π½ΠΈΡ

ΠΠΎΠ½ΡΡΠ½ΠΊΡΠΈΠ²ΠΈΡ β ΡΡΠΎ Π²ΠΎΡΠΏΠ°Π»ΠΈΡΠ΅Π»ΡΠ½ΠΎΠ΅ ΠΏΠΎΡΠ°ΠΆΠ΅Π½ΠΈΠ΅ ΡΠΎΠ΅Π΄ΠΈΠ½ΠΈΡΠ΅Π»ΡΠ½ΠΎΠΉ ΠΎΠ±ΠΎΠ»ΠΎΡΠΊΠΈ Π³Π»Π°Π·Π°, ΠΈΠ»ΠΈ ΠΊΠΎΠ½ΡΡΠ½ΠΊΡΠΈΠ²Ρ. ΠΠ½Π° ΡΠ²Π»ΡΠ΅ΡΡΡ Π½Π°ΡΡΠΆΠ½ΡΠΌ ΠΏΠΎΠΊΡΠΎΠ²ΠΎΠΌ Π³Π»Π°Π·Π½ΠΎΠ³ΠΎ ΡΠ±Π»ΠΎΠΊΠ° ΠΈ Π²ΡΠΏΠΎΠ»Π½ΡΠ΅Ρ Π΄Π²Π΅ Π²Π°ΠΆΠ½Π΅ΠΉΡΠΈΠ΅ Π΄Π»Ρ Π½ΠΎΡΠΌΠ°Π»ΡΠ½ΠΎΠ³ΠΎ Π΅Π³ΠΎ ΡΡΠ½ΠΊΡΠΈΠΎΠ½ΠΈΡΠΎΠ²Π°Π½ΠΈΡ ΡΡΠ½ΠΊΡΠΈΠΈ: Π·Π°ΡΠΈΡΠ½ΡΡ ΠΈ ΡΠ΅ΠΊΡΠ΅ΡΠΎΡΠ½ΡΡ. ΠΠ±Π΅ΡΠ΅Π³Π°Π΅Ρ Π²Π½ΡΡΡΠ΅Π½Π½ΠΈΠ΅ ΡΡΡΡΠΊΡΡΡΡ Π³Π»Π°Π·Π° ΠΎΡ Π²Π½Π΅ΡΠ½Π΅Π³ΠΎ Π²ΠΎΠ·Π΄Π΅ΠΉΡΡΠ²ΠΈΡ, Π° ΡΠ°ΠΊΠΆΠ΅ ΡΠΏΠΎΡΠΎΠ±ΡΡΠ²ΡΠ΅Ρ ΡΠ²Π»Π°ΠΆΠ½Π΅Π½ΠΈΡ Π΅Π³ΠΎ ΠΏΠΎΠ²Π΅ΡΡ Π½ΠΎΡΡΠΈ. ΠΠ»Π°Π³ΠΎΠ΄Π°ΡΡ ΠΊΠΎΠ½ΡΡΠ½ΠΊΡΠΈΠ²Π΅ Π³Π»Π°Π·Π½ΠΎΠ΅ ΡΠ±Π»ΠΎΠΊΠΎ ΡΠ²ΠΎΠ±ΠΎΠ΄Π½ΠΎ Π΄Π²ΠΈΠ³Π°Π΅ΡΡΡ.Β
ΠΠ½ΠΎΠ³ΠΈΠ΅ Π³Π»Π°Π·Π½ΡΠ΅ Π·Π°Π±ΠΎΠ»Π΅Π²Π°Π½ΠΈΡ ΠΎΡΠ΅Π½Ρ ΡΠ°ΡΡΠΎ ΠΎΡΡΠ°ΠΆΠ°ΡΡΡΡ ΠΈΠΌΠ΅Π½Π½ΠΎ Π½Π° ΡΠΎΡΡΠΎΡΠ½ΠΈΠΈ ΡΠΎΠ΅Π΄ΠΈΠ½ΠΈΡΠ΅Π»ΡΠ½ΠΎΠΉ ΠΎΠ±ΠΎΠ»ΠΎΡΠΊΠΈ. Π‘Π°ΠΌΡΠΌΠΈ ΡΠ°ΡΠΏΡΠΎΡΡΡΠ°Π½Π΅Π½Π½ΡΠΌΠΈ ΠΈΠ· Π½ΠΈΡ ΡΠ²Π»ΡΡΡΡΡ ΠΊΠΎΠ½ΡΡΠ½ΠΊΡΠΈΠ²ΠΈΡΡ. Π‘ ΡΠ°Π·Π½ΡΠΌΠΈ ΡΠΎΡΠΌΠ°ΠΌΠΈ ΠΈ ΡΠΈΠΏΠ° ΡΡΠΎΠ³ΠΎ Π½Π΅Π΄ΡΠ³Π° ΡΡΠ°Π»ΠΊΠΈΠ²Π°Π΅ΡΡΡ ΠΏΠΎΡΡΠ΄ΠΊΠ° 70% Π»ΡΠ΄Π΅ΠΉ. Π ΠΎΠ±ΡΠ΅ΠΌ Π²ΠΈΠ΄Π΅ Π΄Π°Π½Π½ΡΡ ΠΏΠ°ΡΠΎΠ»ΠΎΠ³ΠΈΡ ΠΌΠΎΠΆΠ½ΠΎ ΠΎΠΏΠΈΡΠ°ΡΡ ΠΊΠ°ΠΊ Π²ΠΎΡΠΏΠ°Π»ΠΈΡΠ΅Π»ΡΠ½ΡΠΉ ΠΏΡΠΎΡΠ΅ΡΡ, ΠΏΠΎΡΠ°ΠΆΠ°ΡΡΠΈΠΉ ΠΊΠΎΠ½ΡΡΠ½ΠΊΡΠΈΠ²Ρ. ΠΠ΄Π½Π°ΠΊΠΎ ΡΠ°ΠΊΠΎΠ΅ ΠΎΠΏΡΠ΅Π΄Π΅Π»Π΅Π½ΠΈΠ΅ Π±ΡΠ΄Π΅Ρ ΡΠ»ΠΈΡΠΊΠΎΠΌ ΠΏΠΎΠ²Π΅ΡΡ Π½ΠΎΡΡΠ½ΡΠΌ. ΠΠΎΠ½ΡΡΠ½ΠΊΡΠΈΠ²ΠΈΡ ΠΏΡΠΈΠ½ΠΈΠΌΠ°Π΅Ρ ΡΠ°Π·Π½ΡΠ΅ ΡΠΎΡΠΌΡ ΠΈ, Π² Π·Π°Π²ΠΈΡΠΈΠΌΠΎΡΡΠΈ ΠΎΡ ΡΠΏΡΠΎΠ²ΠΎΡΠΈΡΠΎΠ²Π°Π²ΡΠ΅Π³ΠΎ Π²ΠΎΡΠΏΠ°Π»Π΅Π½ΠΈΠ΅ ΡΠ°ΠΊΡΠΎΡΠ°, ΠΊΠ»Π°ΡΡΠΈΡΠΈΡΠΈΡΡΠ΅ΡΡΡ Π½Π° ΠΌΠ½ΠΎΠΆΠ΅ΡΡΠ²ΠΎ ΡΠΈΠΏΠΎΠ². ΠΠΎΡΠ΅ΠΌΡ Π²Π°ΠΆΠ½ΠΎ ΠΎΠΏΡΠ΅Π΄Π΅Π»ΠΈΡΡ Ρ Π°ΡΠ°ΠΊΡΠ΅Ρ ΠΏΡΠΎΡΠ΅ΠΊΠ°Π½ΠΈΡ ΠΈ Π²ΠΈΠ΄ Π±ΠΎΠ»Π΅Π·Π½ΠΈ? ΠΡ ΡΡΠΎΠ³ΠΎ Π·Π°Π²ΠΈΡΠΈΡ ΡΠΏΠΎΡΠΎΠ± Π»Π΅ΡΠ΅Π½ΠΈΡ. ΠΠ°ΠΆΠ΄Π°Ρ ΠΈΠ· ΡΠ°Π·Π½ΠΎΠ²ΠΈΠ΄Π½ΠΎΡΡΠ΅ΠΉ ΠΊΠΎΠ½ΡΡΠ½ΠΊΡΠΈΠ²ΠΈΡΠ° ΡΠΎΠΏΡΠΎΠ²ΠΎΠΆΠ΄Π°Π΅ΡΡΡ Π½Π°Π±ΠΎΡΠΎΠΌ ΡΠΏΠ΅ΡΠΈΡΠΈΡΠ΅ΡΠΊΠΈΡ ΠΈ Π½Π΅ΡΠΏΠ΅ΡΠΈΡΠΈΡΠ΅ΡΠΊΠΈΡ ΠΏΡΠΈΠ·Π½Π°ΠΊΠΎΠ². Π£Π·Π½Π°Π΅ΠΌ, ΠΊΠ°ΠΊ ΠΏΡΠΎΡΠ²Π»ΡΠ΅ΡΡΡ Π²ΠΎΡΠΏΠ°Π»Π΅Π½ΠΈΠ΅, ΠΊΠ°ΠΊΠΈΠ΅ ΡΠΈΠΌΠΏΡΠΎΠΌΡ Π±ΠΎΠ»Π΅Π·Π½ΠΈ Π²ΠΎΠ·Π½ΠΈΠΊΠ°ΡΡ ΡΠ°Π½ΡΡΠ΅ ΠΈ ΠΊΠ°ΠΊ ΠΎΡΠ»ΠΈΡΠΈΡΡ ΠΎΠ΄ΠΈΠ½ Π΅Π΅ ΡΠΈΠΏ ΠΎΡ Π΄ΡΡΠ³ΠΎΠ³ΠΎ.

ΠΠ·-Π·Π° ΡΠ΅Π³ΠΎ ΠΊΠΎΠ½ΡΡΠ½ΠΊΡΠΈΠ²ΠΈΡ Π²ΠΎΠ·Π½ΠΈΠΊΠ°Π΅Ρ?
ΠΠΎΡΠΏΠ°Π»Π΅Π½ΠΈΠ΅ ΡΠΎΠ΅Π΄ΠΈΠ½ΠΈΡΠ΅Π»ΡΠ½ΠΎΠΉ ΠΎΠ±ΠΎΠ»ΠΎΡΠΊΠΈ ΠΌΠΎΠΆΠ΅Ρ Π±ΡΡΡ Π²ΡΠ·Π²Π°Π½ΠΎ ΡΠ°Π·Π»ΠΈΡΠ½ΡΠΌΠΈ ΠΏΡΠΈΡΠΈΠ½Π°ΠΌΠΈ. Π Π±ΠΎΠ»ΡΡΠΈΠ½ΡΡΠ²Π΅ ΡΠ»ΡΡΠ°Π΅Π² Π²ΠΈΠ½ΠΎΠ²Π½ΠΈΠΊΠ°ΠΌΠΈ Π·Π°Π±ΠΎΠ»Π΅Π²Π°Π½ΠΈΡ ΡΡΠ°Π½ΠΎΠ²ΡΡΡΡ Π±Π°ΠΊΡΠ΅ΡΠΈΠΈ: ΡΡΡΠ΅ΠΏΡΠΎΠΊΠΎΠΊΠΊΠΈ, ΡΡΠ°ΡΠΈΠ»ΠΎΠΊΠΎΠΊΠΊΠΈ, Π³ΠΎΠ½ΠΎΠΊΠΎΠΊΠΊΠΈ, ΠΏΠ½Π΅Π²ΠΌΠΎΠΊΠΎΠΊΠΊΠΈ ΠΈ ΠΏΡ. Π’Π°ΠΊΠΆΠ΅ Π²ΡΠ·Π²Π°ΡΡ Π²ΠΎΡΠΏΠ°Π»ΠΈΡΠ΅Π»ΡΠ½ΡΠΉ ΠΏΡΠΎΡΠ΅ΡΡ ΡΠΏΠΎΡΠΎΠ±Π½Ρ Π²ΠΈΡΡΡΡ, Π³ΡΠΈΠ±ΠΊΠΈ, Ρ Π»Π°ΠΌΠΈΠ΄ΠΈΠΈ ΠΈ Π΄ΡΡΠ³ΠΈΠ΅ ΠΏΠ°ΡΠ°Π·ΠΈΡΡ. ΠΠΎΠ½ΡΡΠ½ΠΊΡΠΈΠ²ΠΈΡΡ, ΠΏΡΠΎΠ²ΠΎΡΠΈΡΡΠ΅ΠΌΡΠ΅ ΡΡΠΈΠΌΠΈ Π²ΠΎΠ·Π±ΡΠ΄ΠΈΡΠ΅Π»ΡΠΌΠΈ, ΡΠ²Π»ΡΡΡΡΡ Π·Π°ΡΠ°Π·Π½ΡΠΌΠΈ. ΠΠΌΠΈ ΠΌΠΎΠΆΠ½ΠΎ Π·Π°ΡΠ°Π·ΠΈΡΡΡΡ Π²ΠΎΠ·Π΄ΡΡΠ½ΠΎ-ΠΊΠ°ΠΏΠ΅Π»ΡΠ½ΡΠΌ ΠΈΠ»ΠΈ ΠΊΠΎΠ½ΡΠ°ΠΊΡΠ½ΠΎ-Π±ΡΡΠΎΠ²ΡΠΌ ΠΏΡΡΠ΅ΠΌ. Π‘ΡΡΠ΅ΡΡΠ²ΡΠ΅Ρ ΠΈ Π³ΡΡΠΏΠΏΠ° Π½Π΅Π·Π°ΡΠ°Π·Π½ΡΡ ΠΏΠ°ΡΠΎΠ»ΠΎΠ³ΠΈΠΉ ΡΡΠΎΠ³ΠΎ ΡΠΈΠΏΠ°, Π½Π°ΠΏΡΠΈΠΌΠ΅Ρ, Π°Π»Π»Π΅ΡΠ³ΠΈΡΠ΅ΡΠΊΠΈΠ΅ ΠΊΠΎΠ½ΡΡΠ½ΠΊΡΠΈΠ²ΠΈΡΡ.
ΠΠ°ΠΊΡΠ΅ΡΠΈΠ°Π»ΡΠ½ΡΠΉ ΠΊΠΎΠ½ΡΡΠ½ΠΊΡΠΈΠ²ΠΈΡ, Π²ΡΠ·Π²Π°Π½Π½ΡΠΉ ΠΏΠ½Π΅Π²ΠΌΠΎΠΊΠΎΠΊΠΊΠΎΠΌ, Π½Π°Π·ΡΠ²Π°Π΅ΡΡΡ ΠΏΠ½Π΅Π²ΠΌΠΎΠΊΠΎΠΊΠΊΠΎΠ²ΡΠΌ. Π’Π°ΠΊΠΆΠ΅ Π²ΡΠ΄Π΅Π»ΡΡΡΡΡ ΡΡΡΠ΅ΠΏΡΠΎΠΊΠΎΠΊΠΊΠΎΠ²ΡΠΉ, Π³ΠΎΠ½ΠΎΠΊΠΎΠΊΠΊΠΎΠ²ΡΠΉ, ΡΡΠ°ΡΠΈΠ»ΠΎΠΊΠΎΠΊΠΊΠΎΠ²ΡΠΉ ΡΠΈΠΏΡ Π²ΠΎΡΠΏΠ°Π»Π΅Π½ΠΈΡ. ΠΠΈΡΡΡΠ½ΡΠ΅ ΡΠ°Π·Π΄Π΅Π»ΡΡΡΡΡ Π½Π° Π³Π΅ΡΠΏΠ΅ΡΠΈΡΠ΅ΡΠΊΠΈΠ΅ ΠΈ Π°Π΄Π΅Π½ΠΎΠ²ΠΈΡΡΡΠ½ΡΠ΅. ΠΠ»Π»Π΅ΡΠ³ΠΈΡΠ΅ΡΠΊΠΈΠ΅ ΠΊΠ»Π°ΡΡΠΈΡΠΈΡΠΈΡΡΡΡΡΡ Π½Π° ΡΠ΅Π·ΠΎΠ½Π½ΡΠ΅, ΠΏΠΎΠ»ΠΈΠ½ΠΎΠ·Π½ΡΠ΅ ΠΈ Ρ.Π΄. ΠΠΎ Ρ Π°ΡΠ°ΠΊΡΠ΅ΡΡ ΠΏΡΠΎΡΠ΅ΠΊΠ°Π½ΠΈΡ ΠΊΠΎΠ½ΡΡΠ½ΠΊΡΠΈΠ²ΠΈΡΡ Π±ΡΠ²Π°ΡΡ ΠΎΡΡΡΡΠΌΠΈ ΠΈ Ρ ΡΠΎΠ½ΠΈΡΠ΅ΡΠΊΠΈΠΌΠΈ. ΠΠ΅ΠΊΠΎΡΠΎΡΡΠ΅ Π±ΠΎΠ»Π΅Π·Π½ΠΈ, ΠΊΠ°ΠΊ Π²ΠΎΡΠΏΠ°Π»Π΅Π½ΠΈΡ Π³ΡΠΈΠ±ΠΊΠΎΠ²ΠΎΠΉ ΡΡΠΈΠΎΠ»ΠΎΠ³ΠΈΠΈ, ΠΈΠΌΠ΅ΡΡ ΠΏΠΎΠ΄ΠΎΡΡΡΡΡ ΡΠΎΡΠΌΡ. ΠΠ½ΡΠΌΠΈ ΡΠ»ΠΎΠ²Π°ΠΌΠΈ, Π²ΠΈΠ΄ΠΎΠ² ΡΠ°ΡΡΠΌΠ°ΡΡΠΈΠ²Π°Π΅ΠΌΠΎΠ³ΠΎ Π½Π΅Π΄ΡΠ³Π° ΠΎΡΠ΅Π½Ρ ΠΌΠ½ΠΎΠ³ΠΎ. Π§ΡΠΎΠ±Ρ ΠΎΡΠ»ΠΈΡΠΈΡΡ ΠΈΡ Π΄ΡΡΠ³ ΠΎΡ Π΄ΡΡΠ³Π°, Π½Π΅ΠΎΠ±Ρ ΠΎΠ΄ΠΈΠΌΠΎ Π·Π½Π°ΡΡ Ρ Π°ΡΠ°ΠΊΡΠ΅ΡΠ½ΡΠ΅ Π΄Π»Ρ Π½ΠΈΡ ΡΠΈΠΌΠΏΡΠΎΠΌΡ.
ΠΠ°ΠΊ Π½Π°ΡΠΈΠ½Π°Π΅ΡΡΡ ΠΊΠΎΠ½ΡΡΠ½ΠΊΡΠΈΠ²ΠΈΡ?
ΠΠ½ΡΠ΅Π½ΡΠΈΠ²Π½ΠΎΡΡΡ ΡΠΈΠΌΠΏΡΠΎΠΌΠΎΠ² ΠΌΠΎΠΆΠ΅Ρ Π±ΡΡΡ ΡΠ°Π·Π½ΠΎΠΉ. Π₯Π°ΡΠ°ΠΊΡΠ΅Ρ ΠΈΡ ΠΏΡΠΎΡΠ²Π»Π΅Π½ΠΈΡ ΠΎΠΏΡΠ΅Π΄Π΅Π»ΡΠ΅ΡΡΡ ΡΠΈΠΏΠΎΠΌ Π²ΠΎΡΠΏΠ°Π»Π΅Π½ΠΈΡ ΠΈ ΡΠΎΡΡΠΎΡΠ½ΠΈΠ΅ΠΌ Π·Π΄ΠΎΡΠΎΠ²ΡΡ ΡΠ΅Π»ΠΎΠ²Π΅ΠΊΠ°, Π΅Π³ΠΎ ΠΈΠΌΠΌΡΠ½ΠΈΡΠ΅ΡΠΎΠΌ. ΠΡΠ»ΠΈ ΠΊΠΎΠ½ΡΡΠ½ΠΊΡΠΈΠ²ΠΈΡ ΠΏΡΠΈΠ½ΠΈΠΌΠ°Π΅Ρ ΠΎΡΡΡΡΡ ΡΠΎΡΠΌΡ, ΠΏΡΠΈΠ·Π½Π°ΠΊΠΈ Π²ΠΎΠ·Π½ΠΈΠΊΠ°ΡΡ ΠΏΡΠ°ΠΊΡΠΈΡΠ΅ΡΠΊΠΈ ΡΡΠ°Π·Ρ. Π£ Π±ΠΎΠ»ΡΠ½ΠΎΠ³ΠΎ ΡΠ°Π·Π²ΠΈΠ²Π°Π΅ΡΡΡ ΡΠ»Π΅Π·ΠΎΡΠ΅ΡΠ΅Π½ΠΈΠ΅, ΡΠΈΠ»ΡΠ½Π°Ρ ΡΡΠ²ΡΡΠ²ΠΈΡΠ΅Π»ΡΠ½ΠΎΡΡΡ ΠΊ ΡΠ²Π΅ΡΡ, Π·ΡΠ΄ Π² Π³Π»Π°Π·Ρ. ΠΠ½ΠΎΠ³Π΄Π° ΠΏΠ°ΡΠΈΠ΅Π½ΡΡ ΠΆΠ°Π»ΡΡΡΡΡ Π½Π° Π±ΠΎΠ»Π΅Π²ΡΠ΅ ΠΎΡΡΡΠ΅Π½ΠΈΡ Π² Π³Π»Π°Π·Π½ΠΎΠΌ ΡΠ±Π»ΠΎΠΊΠ΅ ΠΈΠ»ΠΈ ΡΡΠ°Π·Ρ ΠΎΠ±ΠΎΠΈΡ . ΠΡΠ΅ ΡΡΠΈ ΡΠΈΠΌΠΏΡΠΎΠΌΡ ΠΏΡΠΎΡΠ²Π»ΡΡΡΡΡ ΠΎΠ΄Π½ΠΎΠ²ΡΠ΅ΠΌΠ΅Π½Π½ΠΎ. ΠΡΠΈ Ρ ΡΠΎΠ½ΠΈΡΠ΅ΡΠΊΠΎΠΌ ΠΊΠΎΠ½ΡΡΠ½ΠΊΡΠΈΠ²ΠΈΡΠ΅ ΠΎΠ½ΠΈ ΡΠΌΠ΅ΡΠ΅Π½Π½ΡΠ΅. ΠΠ½ΠΈ Π½Π΅ Π΄ΠΎΡΡΠ°Π²Π»ΡΡΡ ΡΠ°ΠΊΠΎΠ³ΠΎ ΡΠΈΠ»ΡΠ½ΠΎΠ³ΠΎ Π΄ΠΈΡΠΊΠΎΠΌΡΠΎΡΡΠ°, ΠΊΠ°ΠΊ ΠΏΡΠΈ ΠΎΡΡΡΠΎΠΌ ΠΏΡΠΎΡΠ΅ΠΊΠ°Π½ΠΈΠΈ Π²ΠΎΡΠΏΠ°Π»ΠΈΡΠ΅Π»ΡΠ½ΠΎΠ³ΠΎ ΠΏΡΠΎΡΠ΅ΡΡΠ°. ΠΠ΅ΠΊΠΎΡΠΎΡΡΠ΅ Π΄ΠΎΠ»Π³ΠΎΠ΅ Π²ΡΠ΅ΠΌΡ Π½Π΅ ΠΎΠ±ΡΠ°ΡΠ°ΡΡ Π²Π½ΠΈΠΌΠ°Π½ΠΈΠ΅ Π½Π° Π±ΠΎΠ»Π΅Π·Π½Ρ, ΠΈΠ·-Π·Π° ΡΠ΅Π³ΠΎ ΠΎΠ½Π° ΠΎΡΠ»ΠΎΠΆΠ½ΡΠ΅ΡΡΡ. Π Π½Π΅ΠΉ ΠΏΡΠΈΡΠΎΠ΅Π΄ΠΈΠ½ΡΡΡΡΡ Π΄ΡΡΠ³ΠΈΠ΅ ΠΎΡΡΠ°Π»ΡΠΌΠΎΠΏΠ°ΡΠΎΠ»ΠΎΠ³ΠΈΠΈ.
Π ΠΎΡΡΡΠΎΠΉ ΡΠΎΡΠΌΠ΅ ΠΏΠΎΡΡΠΈ Π²ΡΠ΅Π³Π΄Π° ΠΏΡΠΎΡΠ΅ΠΊΠ°ΡΡ Π±Π°ΠΊΡΠ΅ΡΠΈΠ°Π»ΡΠ½ΡΠ΅ ΠΈ Π°Π»Π»Π΅ΡΠ³ΠΈΡΠ΅ΡΠΊΠΈΠ΅ ΠΊΠΎΠ½ΡΡΠ½ΠΊΡΠΈΠ²ΠΈΡΡ. ΠΠΈΡΡΡΠ½ΡΠ΅ Π·Π°Π±ΠΎΠ»Π΅Π²Π°Π½ΠΈΡ ΠΌΠΎΠ³ΡΡ Π±ΡΡΡ Ρ ΡΠΎΠ½ΠΈΡΠ΅ΡΠΊΠΈΠΌΠΈ ΠΈ ΠΎΡΡΡΡΠΌΠΈ. Π’Π°ΠΊ, Π½Π°ΠΏΡΠΈΠΌΠ΅Ρ, Π²ΠΎΡΠΏΠ°Π»Π΅Π½ΠΈΠ΅ ΠΊΠΎΠ½ΡΡΠ½ΠΊΡΠΈΠ²Ρ, ΠΏΡΠΈΡΠΈΠ½ΠΎΠΉ ΠΊΠΎΡΠΎΡΠΎΠ³ΠΎ ΡΡΠ°Π»ΠΈ Π°Π΄Π΅Π½ΠΎΠ²ΠΈΡΡΡΡ, ΡΠΎΠΏΡΠΎΠ²ΠΎΠΆΠ΄Π°Π΅ΡΡΡ Ρ Π°ΡΠ°ΠΊΡΠ΅ΡΠ½ΡΠΌΠΈ Π΄Π»Ρ ΠΎΡΡΡΡΡ ΡΠ΅ΡΠΏΠΈΡΠ°ΡΠΎΡΠ½ΡΡ Π²ΠΈΡΡΡΠ½ΡΡ ΠΈΠ½ΡΠ΅ΠΊΡΠΈΠΉ ΠΏΡΠΈΠ·Π½Π°ΠΊΠ°ΠΌΠΈ: Π½Π°ΡΠΌΠΎΡΠΊ, ΠΊΠ°ΡΠ΅Π»Ρ, ΠΆΠ°Ρ, ΠΎΠ·Π½ΠΎΠ±. ΠΡΠΈΠ±ΠΊΠΎΠ²ΡΠ΅ ΠΊΠΎΠ½ΡΡΠ½ΠΊΡΠΈΠ²ΠΈΡΡ ΠΏΡΠΈΠ½ΠΈΠΌΠ°ΡΡ Π² Π±ΠΎΠ»ΡΡΠΈΠ½ΡΡΠ²Π΅ ΡΠ»ΡΡΠ°Π΅Π² ΠΏΠΎΠ΄ΠΎΡΡΡΡΡ ΠΈΠ»ΠΈ Ρ ΡΠΎΠ½ΠΈΡΠ΅ΡΠΊΡΡ ΡΠΎΡΠΌΡ. ΠΠΎΠ³ΠΎΠ²ΠΎΡΠΈΠΌ ΠΎΠ± ΡΡΠΎΠΌ ΠΏΠΎΠ΄ΡΠΎΠ±Π½Π΅Π΅.

ΠΠ°ΠΊ ΠΏΠΎΡΠ²Π»ΡΠ΅ΡΡΡ ΠΊΠΎΠ½ΡΡΠ½ΠΊΡΠΈΠ²ΠΈΡ Π±Π°ΠΊΡΠ΅ΡΠΈΠ°Π»ΡΠ½ΠΎΠΉ ΡΡΠΈΠΎΠ»ΠΎΠ³ΠΈΠΈ?
ΠΠΎΠ·Π½ΠΈΠΊΠ°Π΅Ρ ΠΎΠ½ ΡΠΎΠ»ΡΠΊΠΎ ΠΏΠΎΡΠ»Π΅ Π½Π΅ΠΏΠΎΡΡΠ΅Π΄ΡΡΠ²Π΅Π½Π½ΠΎΠ³ΠΎ ΠΊΠΎΠ½ΡΠ°ΠΊΡΠ° ΠΌΠΈΠΊΡΠΎΠ±Π° ΡΠΎ ΡΠ»ΠΈΠ·ΠΈΡΡΠΎΠΉ ΠΎΠ±ΠΎΠ»ΠΎΡΠΊΠΎΠΉ Π³Π»Π°Π·Π°. ΠΡΠΎΠΌΡ ΠΌΠΎΠ³ΡΡ ΡΠΏΠΎΡΠΎΠ±ΡΡΠ²ΠΎΠ²Π°ΡΡ ΡΠ»Π΅Π΄ΡΡΡΠΈΠ΅ ΡΠ°ΠΊΡΠΎΡΡ:
- ΡΡΠ°Π²ΠΌΡ Π³Π»Π°Π·Π½ΡΡ ΡΠ±Π»ΠΎΠΊ;
- ΠΏΠΎΠΏΠ°Π΄Π°Π½ΠΈΠ΅ ΠΈΠ½ΡΠ΅ΠΊΡΠΈΠΈ Π² Ρ ΠΎΠ΄Π΅ ΠΎΠΏΠ΅ΡΠ°ΡΠΈΠΈ Π½Π° Π³Π»Π°Π·Π°Ρ ΠΈΠ»ΠΈ ΠΏΠΎΡΠ»Π΅ ΠΏΡΠΎΡΠ΅Π΄ΡΡΡ Π² ΠΏΠ΅ΡΠΈΠΎΠ΄ ΡΠ΅Π°Π±ΠΈΠ»ΠΈΡΠ°ΡΠΈΠΈ;
- ΠΈΠ½ΡΠ΅ΠΊΡΠΈΠΎΠ½Π½ΡΠ΅ ΠΊΠΎΠΆΠ½ΡΠ΅ Π·Π°Π±ΠΎΠ»Π΅Π²Π°Π½ΠΈΡ;
- Π΄Π΅ΡΠ΅ΠΊΡΡ ΡΠ΅ΡΡΠ°ΠΊΡΠΈΠΈ β Π°ΡΡΠΈΠ³ΠΌΠ°ΡΠΈΠ·ΠΌ, ΠΌΠΈΠΎΠΏΠΈΡ, Π³ΠΈΠΏΠ΅ΡΠΌΠ΅ΡΡΠΎΠΏΠΈΡ, ΠΏΡΠ΅ΡΠ±ΠΈΠΎΠΏΠΈΡ;
- Π³Π»Π°Π·Π½ΡΠ΅ ΠΈΠ½ΡΠ΅ΠΊΡΠΈΠΎΠ½Π½ΡΠ΅ Π±ΠΎΠ»Π΅Π·Π½ΠΈ β Π±Π»Π΅ΡΠ°ΡΠΈΡ, ΠΊΠ΅ΡΠ°ΡΠΈΡ;
- ΡΠΈΠ½Π΄ΡΠΎΠΌ Β«ΡΡΡ ΠΎΠ³ΠΎ Π³Π»Π°Π·Π°Β» ΠΈ ΠΏΡΠΎΡΠΈΠ΅ ΠΎΡΡΠ°Π»ΡΠΌΠΎΠ»ΠΎΠ³ΠΈΡΠ΅ΡΠΊΠΈΠ΅ ΠΏΠ°ΡΠΎΠ»ΠΎΠ³ΠΈΠΈ Π½Π΅ΠΈΠ½ΡΠ΅ΠΊΡΠΈΠΎΠ½Π½ΠΎΠΉ ΠΏΡΠΈΡΠΎΠ΄Ρ;
- ΠΏΠ»ΠΎΡ Π°Ρ Π³ΠΈΠ³ΠΈΠ΅Π½Π°, Π² ΡΠΎΠΌ ΡΠΈΡΠ»Π΅ Π½Π΅ΠΊΠ°ΡΠ΅ΡΡΠ²Π΅Π½Π½Π°Ρ ΠΎΡΠΈΡΡΠΊΠ° ΠΊΠΎΠ½ΡΠ°ΠΊΡΠ½ΡΡ Π»ΠΈΠ½Π·;
- Π±ΠΎΠ»Π΅Π·Π½ΠΈ ΠΠΠ -ΠΎΡΠ³Π°Π½ΠΎΠ².

ΠΡΡΡΡΠΎΠΌΡ ΡΠ°Π·Π²ΠΈΡΠΈΡ Π²ΠΎΡΠΏΠ°Π»Π΅Π½ΠΈΡ ΡΠΏΠΎΡΠΎΠ±ΡΡΠ²ΡΠ΅Ρ ΠΈ ΠΎΡΠ»Π°Π±Π»Π΅Π½Π½Π°Ρ ΠΈΠΌΠΌΡΠ½Π½Π°Ρ ΡΠΈΡΡΠ΅ΠΌΠ°. ΠΡΠ»ΠΈ ΡΠ΅Π»ΠΎΠ²Π΅ΠΊ ΠΏΠ΅ΡΠ΅ΠΎΡ Π»Π°Π΄ΠΈΠ»ΡΡ, ΡΠΈΠ΄ΠΈΡ Π½Π° ΠΈΠ·Π½ΡΡΡΡΡΠ΅ΠΉ Π΄ΠΈΠ΅ΡΠ΅, ΡΠΎ Π²Π΅ΡΠΎΡΡΠ½ΠΎΡΡΡ Π²ΠΎΠ·Π½ΠΈΠΊΠ½ΠΎΠ²Π΅Π½ΠΈΡ ΠΊΠΎΠ½ΡΡΠ½ΠΊΡΠΈΠ²ΠΈΡΠ° ΠΏΠΎΡΠ»Π΅ Π²ΠΎΠ·Π΄Π΅ΠΉΡΡΠ²ΠΈΡ Π½Π° ΠΊΠΎΠ½ΡΡΠ½ΠΊΡΠΈΠ²Ρ ΠΏΠ°ΡΠΎΠ³Π΅Π½Π½ΡΡ ΠΌΠΈΠΊΡΠΎΠ±ΠΎΠ² ΡΠ²Π΅Π»ΠΈΡΠΈΠ²Π°Π΅ΡΡΡ.
ΠΠ°ΠΊ Π½Π°ΡΠΈΠ½Π°Π΅ΡΡΡ ΠΊΠΎΠ½ΡΡΠ½ΠΊΡΠΈΠ²ΠΈΡ ΡΡΠΎΠ³ΠΎ ΡΠΈΠΏΠ°? ΠΠ½ΠΊΡΠ±Π°ΡΠΈΠΎΠ½Π½ΡΠΉ ΠΏΠ΅ΡΠΈΠΎΠ΄ ΠΎΠ±ΡΡΠ½ΠΎ ΠΊΠΎΡΠΎΡΠΊΠΈΠΉ. ΠΠ΅ΡΠ²ΡΠ΅ ΠΏΡΠΈΠ·Π½Π°ΠΊΠΈ ΠΌΠΎΠ³ΡΡ ΠΏΠΎΡΠ²ΠΈΡΡΡΡ ΡΠΆΠ΅ ΡΠ΅ΡΠ΅Π· ΡΡΡΠΊΠΈ ΠΏΠΎΡΠ»Π΅ Π·Π°ΡΠ°ΠΆΠ΅Π½ΠΈΡ. Π Π½ΠΈΠΌ ΠΎΡΠ½ΠΎΡΡΡΡΡ:
- ΡΠ²Π΅ΡΠΎΡΡΠ²ΡΡΠ²ΠΈΡΠ΅Π»ΡΠ½ΠΎΡΡΡ ΠΈ ΡΠ²ΡΠ·Π°Π½Π½Π°Ρ Ρ Π½Π΅ΠΉ Π±ΠΎΠ»Ρ Π² Π³Π»Π°Π·Π½ΡΡ ΡΠ±Π»ΠΎΠΊΠ°Ρ ;
- ΠΆΠΆΠ΅Π½ΠΈΠ΅ ΠΈ Π·ΡΠ΄;
- ΠΏΠΎΠΊΡΠ°ΡΠ½Π΅Π½ΠΈΠ΅ ΠΊΠΎΠ½ΡΡΠ½ΠΊΡΠΈΠ²Ρ ΠΈ ΠΊΡΠ°Π΅Π² Π²Π΅ΠΊ;
- ΠΎΡΠ΄Π΅Π»Π΅Π½ΠΈΠ΅ ΡΠΊΡΡΡΠ΄Π°ΡΠ° Π³Π½ΠΎΠΉΠ½ΠΎΠ³ΠΎ ΠΈΠ»ΠΈ ΡΠ»ΠΈΠ·ΠΈΡΡΠΎΠ³ΠΎ Ρ Π°ΡΠ°ΠΊΡΠ΅ΡΠ°;
- ΠΎΠ±ΡΠ°Π·ΠΎΠ²Π°Π½ΠΈΠ΅ ΡΠ΅ΡΠΎΠ²Π°ΡΡΡ ΠΏΠ»Π΅Π½ΠΎΠΊ Π½Π° ΠΏΠΎΠ²Π΅ΡΡ Π½ΠΎΡΡΠΈ ΡΠΎΠ΅Π΄ΠΈΠ½ΠΈΡΠ΅Π»ΡΠ½ΠΎΠΉ ΠΎΠ±ΠΎΠ»ΠΎΡΠΊΠΈ.
ΠΡΠΈ ΡΡΠ°ΡΠΈΠ»ΠΎΠΊΠΎΠΊΠΊΠΎΠ²ΠΎΠΌ ΠΊΠΎΠ½ΡΡΠ½ΠΊΡΠΈΠ²ΠΈΡΠ΅ Π½Π°Π±Π»ΡΠ΄Π°Π΅ΡΡΡ Π±ΠΎΠ»ΡΡΠΎΠ΅ ΠΊΠΎΠ»ΠΈΡΠ΅ΡΡΠ²ΠΎ ΡΠ»ΠΈΠ·ΠΈ ΠΈ Π³Π½ΠΎΡ. Π£ Π±ΠΎΠ»ΡΠ½ΠΎΠ³ΠΎ Π·Π°ΠΌΠ΅ΡΠ½ΠΎ ΠΎΡΠ΅ΠΊΠ°ΡΡ Π²Π΅ΠΊΠΈ ΠΈ ΡΠΊΠ»Π΅ΠΈΠ²Π°ΡΡΡΡ ΡΠ΅ΡΠ½ΠΈΡΡ ΠΏΠΎ ΡΡΡΠ°ΠΌ. ΠΡΠ΄ ΠΈ ΡΠ»Π΅Π·ΠΎΡΠ΅ΡΠ΅Π½ΠΈΠ΅ Π²ΠΎΠ·Π½ΠΈΠΊΠ°ΡΡ ΠΏΡΠ°ΠΊΡΠΈΡΠ΅ΡΠΊΠΈ ΡΡΠ°Π·Ρ ΠΏΠΎΡΠ»Π΅ Π·Π°ΡΠ°ΠΆΠ΅Π½ΠΈΡ. Π§Π΅Π»ΠΎΠ²Π΅ΠΊ ΡΡΠ΅Ρ Π³Π»Π°Π·Π° ΡΡΠΊΠ°ΠΌΠΈ, ΠΎΠ½ΠΈ ΠΊΡΠ°ΡΠ½Π΅ΡΡ, ΠΊΠΎΠ½ΡΡΠ½ΠΊΡΠΈΠ²Π° ΠΈ Π²Π΅ΠΊΠΈ ΠΎΡΠ΅ΠΊΠ°ΡΡ Π΅ΡΠ΅ Π±ΠΎΠ»ΡΡΠ΅. ΠΡΠΎΠΌΠ΅ ΡΠΎΠ³ΠΎ, ΠΌΠΈΠΊΡΠΎΠ±Ρ ΠΏΠΎΠΏΠ°Π΄Π°ΡΡ Π½Π° ΡΠ»ΠΈΠ·ΠΈΡΡΡΡ Π²ΡΠΎΡΠΎΠ³ΠΎ Π³Π»Π°Π·Π½ΠΎΠ³ΠΎ ΡΠ±Π»ΠΎΠΊΠ°, ΠΈΠ·-Π·Π° ΡΠ΅Π³ΠΎ ΡΠΎΡΡΠΎΡΠ½ΠΈΠ΅ ΠΏΠ°ΡΠΈΠ΅Π½ΡΠ° ΡΡ ΡΠ΄ΡΠ°Π΅ΡΡΡ.

ΠΠ½Π΅Π²ΠΌΠΎΠΊΠΎΠΊΠΊΠΎΠ²ΡΠΉ ΠΊΠΎΠ½ΡΡΠ½ΠΊΡΠΈΠ²ΠΈΡ Π½Π°ΡΠΈΠ½Π°Π΅ΡΡΡ Ρ Π·ΡΠ΄Π° ΠΈ ΠΎΠ±ΠΈΠ»ΡΠ½ΠΎΠ³ΠΎ Π²ΡΠ΄Π΅Π»Π΅Π½ΠΈΡ ΡΠ»ΠΈΠ·ΠΈΡΡΠΎ-Π³Π½ΠΎΠΉΠ½ΠΎΠ³ΠΎ ΡΠΊΡΡΡΠ΄Π°ΡΠ°. Π’Π°ΠΊΠΆΠ΅ Π½Π°Π±Π»ΡΠ΄Π°ΡΡΡΡ ΠΊΡΠΎΠ²ΠΎΠΈΠ·Π»ΠΈΡΠ½ΠΈΡ. Π Π½ΠΈΡ ΡΠ²ΠΈΠ΄Π΅ΡΠ΅Π»ΡΡΡΠ²ΡΠ΅Ρ Π½Π°Π»ΠΈΡΠΈΠ΅ ΠΌΠ½ΠΎΠ³ΠΎΡΠΈΡΠ»Π΅Π½Π½ΡΡ ΠΊΡΠ°ΡΠ½ΡΡ ΡΠΎΡΠ΅ΠΊ Π½Π° ΠΊΠΎΠ½ΡΡΠ½ΠΊΡΠΈΠ²Π΅. ΠΠ΅ΠΊΠΈ Π±ΠΎΠ»ΡΠ½ΠΎΠ³ΠΎ ΠΎΡΠ΅ΠΊΠ°ΡΡ ΡΠΈΠ»ΡΠ½ΠΎ, ΡΡΠΎ ΠΈΠ½ΠΎΠ³Π΄Π° ΠΏΡΠΈΠ²ΠΎΠ΄ΠΈΡ ΠΊ ΠΏΠΎΠ»Π½ΠΎΠΌΡ ΠΈΡ ΡΠΌΡΠΊΠ°Π½ΠΈΡ. ΠΠΎΠ½ΠΎΠΊΠΎΠΊΠΊΠΎΠ²ΡΠΉ ΠΊΠΎΠ½ΡΡΠ½ΠΊΡΠΈΠ²ΠΈΡ, ΠΊΠΎΡΠΎΡΡΠΉ Π΄ΠΈΠ°Π³Π½ΠΎΡΡΠΈΡΡΠ΅ΡΡΡ ΠΏΡΠ΅ΠΈΠΌΡΡΠ΅ΡΡΠ²Π΅Π½Π½ΠΎ Ρ Π½ΠΎΠ²ΠΎΡΠΎΠΆΠ΄Π΅Π½Π½ΡΡ , Π·Π°ΡΡΠΆΠ°ΡΡΠΈΡ ΡΡ ΠΎΡ ΠΌΠ°ΡΠ΅ΡΠΈ ΠΏΡΠΈ ΠΏΡΠΎΡ ΠΎΠΆΠ΄Π΅Π½ΠΈΠΈ ΠΏΠΎ ΡΠΎΠ΄ΠΎΠ²ΡΠΌ ΠΏΡΡΡΠΌ, Π³Π»Π°Π·Π° ΠΏΠΎΠ»Π½ΠΎΡΡΡΡ Π·Π°ΠΊΡΡΠ²Π°ΡΡΡΡ ΠΈΠ·-Π·Π° ΠΎΡΠ΅ΠΊΠΎΠ². Π ΠΊΠΎΠ½ΡΡΠ½ΠΊΡΠΈΠ²Π°Π»ΡΠ½ΠΎΠΌ ΠΌΠ΅ΡΠΊΠ΅ ΡΠΊΠ°ΠΏΠ»ΠΈΠ²Π°Π΅ΡΡΡ Π³Π½ΠΎΠΉ. ΠΠ½ Π΄ΠΎΡΡΠ°Π²Π»ΡΠ΅Ρ ΡΠΈΠ»ΡΠ½ΡΠΉ Π΄ΠΈΡΠΊΠΎΠΌΡΠΎΡΡ, Π²ΡΠ·ΡΠ²Π°Π΅Ρ Π·ΡΠ΄ ΠΈ ΠΆΠΆΠ΅Π½ΠΈΠ΅, ΡΠ΅Π±Π΅Π½ΠΎΠΊ ΠΏΠΎΡΡΠΎΡΠ½Π½ΠΎ ΠΏΠ»Π°ΡΠ΅Ρ. ΠΡΠΈΡ ΠΎΠ΄ΠΈΡΡΡ ΠΈΡΠΊΡΡΡΡΠ²Π΅Π½Π½ΠΎ ΡΠ°Π·ΠΌΡΠΊΠ°ΡΡ Π²Π΅ΠΊΠΈ ΠΌΠ°Π»ΡΡΠ° ΠΈ ΡΠ΄Π°Π»ΡΡΡ ΡΠΊΡΡΡΠ΄Π°Ρ.
ΠΠΈΡΡΠ΅ΡΠΈΡΠΈΡΠ΅ΡΠΊΠΈΠΉ ΠΊΠΎΠ½ΡΡΠ½ΠΊΡΠΈΠ²ΠΈΡ, ΠΊΠΎΡΠΎΡΡΠΉ ΡΠ°ΠΊΠΆΠ΅ ΡΠ°ΡΠ΅ Π²ΡΡΠ²Π»ΡΠ΅ΡΡΡ Ρ Π΄Π΅ΡΠ΅ΠΉ, ΠΏΡΠΎΡΠ²Π»ΡΠ΅ΡΡΡ Π² ΡΠΏΠ»ΠΎΡΠ½Π΅Π½ΠΈΠΈ Π²Π΅ΠΊ ΠΈ ΡΡΠΊΠΎ Π²ΡΡΠ°ΠΆΠ΅Π½Π½ΠΎΠΌ ΠΏΠΎΠΊΡΠ°ΡΠ½Π΅Π½ΠΈΠΈ ΡΠ»ΠΈΠ·ΠΈΡΡΠΎΠΉ Π³Π»Π°Π·Π°. ΠΠ· ΠΊΠΎΠ½ΡΡΠ½ΠΊΡΠΈΠ²Π°Π»ΡΠ½ΠΎΠ³ΠΎ ΠΌΠ΅ΡΠΊΠ° Π²ΡΠ΄Π΅Π»ΡΠ΅ΡΡΡ ΡΠ»ΠΈΠ·Ρ Ρ ΡΡΠΊΡΠΎΠ²ΠΈΡΠ΅ΠΉ. Π‘ΠΏΠ΅ΡΠΈΡΠΈΡΠ΅ΡΠΊΠΈΠΉ ΠΏΡΠΈΠ·Π½Π°ΠΊ Π·Π°Π±ΠΎΠ»Π΅Π²Π°Π½ΠΈΡ β ΠΎΠ±ΡΠ°Π·ΠΎΠ²Π°Π½ΠΈΠ΅ ΠΏΠ»Π΅Π½ΠΎΠΊ Π½Π° ΠΊΠΎΠ½ΡΡΠ½ΠΊΡΠΈΠ²Π΅. Π£Π΄Π°Π»ΡΡΡ ΠΈΡ Π½Π΅Π»ΡΠ·Ρ, ΡΠ°ΠΊ ΠΊΠ°ΠΊ ΠΎΠ½ΠΈ ΠΏΠ»ΠΎΡΠ½ΠΎ ΠΏΡΠΈΠ»Π΅Π³Π°ΡΡ ΠΊ ΡΠΊΠ°Π½ΡΠΌ ΡΠΎΠ΅Π΄ΠΈΠ½ΠΈΡΠ΅Π»ΡΠ½ΠΎΠΉ ΠΎΠ±ΠΎΠ»ΠΎΡΠΊΠΈ. ΠΡΠ΄Π΅Π»Π΅Π½ΠΈΠ΅ ΠΈΡ Π²Π°ΡΠΎΠΉ ΠΈΠ»ΠΈ Π±ΠΈΠ½ΡΠΎΠΌ ΡΡΠ°Π½ΠΎΠ²ΠΈΡΡΡ ΠΏΡΠΈΡΠΈΠ½ΠΎΠΉ ΠΊΡΠΎΠ²ΠΎΡΠ΅ΡΠ΅Π½ΠΈΠΉ. ΠΠ΄Π½Π°ΠΊΠΎ ΠΎΠΏΠ°ΡΠ½Ρ Π½Π΅ ΡΡΠΎΠ»ΡΠΊΠΎ ΠΎΠ½ΠΈ, ΡΠΊΠΎΠ»ΡΠΊΠΎ ΡΡΠ±ΡΡ, ΠΊΠΎΡΠΎΡΡΠ΅ Π±ΡΠ΄ΡΡ ΡΠΎΡΠΌΠΈΡΠΎΠ²Π°ΡΡΡΡ ΠΏΠΎΠ·Π΄Π½Π΅Π΅. Π ΡΠ±ΡΠ΅Π²Π°Π½ΠΈΠ΅ ΠΌΠΎΠΆΠ΅Ρ ΠΏΡΠΈΠ²Π΅ΡΡΠΈ ΠΊ ΡΡΠΈΡ ΠΈΠ°Π·Ρ, Π·Π°Π²ΠΎΡΠΎΡΡ Π²Π΅ΠΊ ΠΈ Π΄ΡΡΠ³ΠΈΠΌ Π΄Π΅ΡΠ΅ΠΊΡΠ°ΠΌ, ΠΊΠΎΡΠΎΡΡΠ΅ ΠΏΡΠΈΡ ΠΎΠ΄ΠΈΡΡΡ ΡΡΡΡΠ°Π½ΡΡΡ ΠΎΠΏΠ΅ΡΠ°ΡΠΈΠ²Π½ΠΎ.

ΠΡΠ΅ ΠΎΠ΄Π½ΠΎΠΉ ΡΠ°ΡΠΏΡΠΎΡΡΡΠ°Π½Π΅Π½Π½ΠΎΠΉ ΡΠ°Π·Π½ΠΎΠ²ΠΈΠ΄Π½ΠΎΡΡΡΡ ΠΊΠΎΠ½ΡΡΠ½ΠΊΡΠΈΠ²ΠΈΡΠ° ΡΠ²Π»ΡΠ΅ΡΡΡ Π²ΠΎΡΠΏΠ°Π»Π΅Π½ΠΈΠ΅, Π²ΡΠ·Π²Π°Π½Π½ΠΎΠ΅ ΡΠΈΠ½Π΅Π³Π½ΠΎΠΉΠ½ΠΎΠΉ ΠΏΠ°Π»ΠΎΡΠΊΠΎΠΉ β ΡΡΠ»ΠΎΠ²Π½ΠΎ-ΠΏΠ°ΡΠΎΠ³Π΅Π½Π½ΡΠΌ ΠΌΠΈΠΊΡΠΎΠΎΡΠ³Π°Π½ΠΈΠ·ΠΌΠΎΠΌ, ΠΊΠΎΡΠΎΡΡΠΉ Π°ΠΊΡΠΈΠ²ΠΈΠ·ΠΈΡΡΠ΅ΡΡΡ ΠΏΡΠΈ ΠΎΡΠ»Π°Π±Π»Π΅Π½Π½ΠΎΠΌ ΠΈΠΌΠΌΡΠ½ΠΈΡΠ΅ΡΠ΅. ΠΠ°ΡΠΈΠ½Π°Π΅ΡΡΡ ΠΊΠΎΠ½ΡΡΠ½ΠΊΡΠΈΠ²ΠΈΡ Ρ ΡΠΈΠ»ΡΠ½ΠΎΠ³ΠΎ Π·ΡΠ΄Π°, ΠΆΠΆΠ΅Π½ΠΈΡ, ΡΠ΅ΠΆΡΡΠ΅ΠΉ Π±ΠΎΠ»ΠΈ Π² Π³Π»Π°Π·Π°Ρ ΠΈ ΡΠ»Π΅Π·ΠΎΡΠ΅ΡΠ΅Π½ΠΈΡ.
ΠΡΠ΅ ΡΡΠΈ ΡΠΈΠΌΠΏΡΠΎΠΌΡ Ρ Π°ΡΠ°ΠΊΡΠ΅ΡΠ½Ρ Π΄Π»Ρ Π²ΠΎΡΠΏΠ°Π»ΠΈΡΠ΅Π»ΡΠ½ΡΡ ΠΏΡΠΎΡΠ΅ΡΡΠΎΠ² Π±Π°ΠΊΡΠ΅ΡΠΈΠ°Π»ΡΠ½ΠΎΠΉ ΡΡΠΈΠΎΠ»ΠΎΠ³ΠΈΠΈ, ΠΏΡΠΎΡΠ΅ΠΊΠ°ΡΡΠΈΡ Π² ΠΎΡΡΡΠΎΠΉ ΡΠΎΡΠΌΠ΅. ΠΡΡΡΡΡΡΠ²ΠΈΠ΅ Π°Π΄Π΅ΠΊΠ²Π°ΡΠ½ΠΎΠ³ΠΎ Π»Π΅ΡΠ΅Π½ΠΈΡ, Π½Π΅ΡΠΎΠ±Π»ΡΠ΄Π΅Π½ΠΈΠ΅ ΠΏΡΠ΅Π΄ΠΏΠΈΡΠ°Π½ΠΈΠΉ Π²ΡΠ°ΡΠ°, ΠΎΡΠ΅Π½Ρ ΡΠ»Π°Π±ΠΎΠ΅ Π·Π΄ΠΎΡΠΎΠ²ΡΠ΅ ΠΌΠΎΠ³ΡΡ ΠΏΡΠΈΠ²Π΅ΡΡΠΈ ΠΊ ΡΠΎΠΌΡ, ΡΡΠΎ ΠΊΠΎΠ½ΡΡΠ½ΠΊΡΠΈΠ²ΠΈΡ ΡΡΠ°Π½Π΅Ρ Ρ ΡΠΎΠ½ΠΈΡΠ΅ΡΠΊΠΈΠΌ. ΠΠ½ ΡΠΎΠΏΡΠΎΠ²ΠΎΠΆΠ΄Π°Π΅ΡΡΡ ΡΠ°ΠΊΠΈΠΌΠΈ ΠΆΠ΅ ΡΠΈΠΌΠΏΡΠΎΠΌΠ°ΠΌΠΈ, ΠΊΠ°ΠΊ ΠΈ Π²ΡΡΠ΅ΠΏΠ΅ΡΠ΅ΡΠΈΡΠ»Π΅Π½Π½ΡΠ΅ Π²ΠΈΠ΄Ρ ΠΏΠ°ΡΠΎΠ»ΠΎΠ³ΠΈΠΈ, ΠΎΠ΄Π½Π°ΠΊΠΎ ΠΎΠ½ΠΈ ΡΠΆΠ΅ Π±ΠΎΠ»Π΅Π΅ ΡΠΌΠ΅ΡΠ΅Π½Π½ΡΠ΅. Π£ ΠΏΠ°ΡΠΈΠ΅Π½ΡΠ° Π½Π°Π±Π»ΡΠ΄Π°ΡΡΡΡ Π»Π΅Π³ΠΊΠΎΠ΅ ΠΏΠΎΠΊΡΠ°ΡΠ½Π΅Π½ΠΈΠ΅ ΠΊΠΎΠ½ΡΡΠ½ΠΊΡΠΈΠ²Ρ ΠΈ Π²Π΅ΠΊ, ΠΎΡΡΡΠ΅Π½ΠΈΠ΅ Β«ΠΏΠ΅ΡΠΊΠ°Β» Π² Π³Π»Π°Π·Π°Ρ ΠΊ ΠΊΠΎΠ½ΡΡ Π΄Π½Ρ, ΠΏΠΎΡΡΠΎΡΠ½Π½ΠΎΠ΅, Π½ΠΎ Π½Π΅ ΡΠΈΠ»ΡΠ½ΠΎΠ΅ ΠΆΠΆΠ΅Π½ΠΈΠ΅ ΠΈ Π·ΡΠ΄. Π’Π°ΠΊΠΆΠ΅ ΡΠ°Π·Π²ΠΈΠ²Π°ΡΡΡΡ ΠΏΡΠΈΠ·Π½Π°ΠΊΠΈ Π°ΡΡΠ΅Π½ΠΎΠΏΠΈΠΈ. ΠΡΠ³Π°Π½Ρ Π·ΡΠ΅Π½ΠΈΡ Π±ΡΡΡΡΠΎ ΡΡΡΠ°ΡΡ, ΡΠ½ΠΈΠΆΠ°Π΅ΡΡΡ Π·ΠΎΡΠΊΠΎΡΡΡ. Π£Ρ ΡΠ΄ΡΠ΅Π½ΠΈΠ΅ Π·ΡΠΈΡΠ΅Π»ΡΠ½ΡΡ ΡΡΠ½ΠΊΡΠΈΠΉ Π³ΠΎΠ²ΠΎΡΠΈΡ ΠΎ ΡΠΎΠΌ, ΡΡΠΎ ΠΊΠΎΠ½ΡΡΠ½ΠΊΡΠΈΠ²ΠΈΡ ΠΎΡ Π²Π°ΡΠΈΠ» ΡΠΆΠ΅ ΠΈ ΡΠΎΠ³ΠΎΠ²ΡΡ ΠΎΠ±ΠΎΠ»ΠΎΡΠΊΡ.

ΠΠ°ΠΊ Π½Π°ΡΠΈΠ½Π°Π΅ΡΡΡ ΠΊΠΎΠ½ΡΡΠ½ΠΊΡΠΈΠ²ΠΈΡ Π²ΠΈΡΡΡΠ½ΠΎΠ³ΠΎ ΡΠΈΠΏΠ°?
ΠΠΈΡΡΡΡ, ΠΏΠΎΠΏΠ°Π΄Π°Ρ Π² ΠΎΡΠ³Π°Π½ΠΈΠ·ΠΌ, ΠΏΡΠΈΠ²ΠΎΠ΄ΡΡ ΠΊ ΡΠΈΡΡΠ΅ΠΌΠ½ΠΎΠΌΡ ΡΡ ΡΠ΄ΡΠ΅Π½ΠΈΡ ΡΠΎΡΡΠΎΡΠ½ΠΈΡ. ΠΠΎΠ½ΡΡΠ½ΠΊΡΠΈΠ²ΠΈΡ ΠΏΡΠΈ Π²ΠΈΡΡΡΠ½ΡΡ ΠΈΠ½ΡΠ΅ΠΊΡΠΈΡΡ ΡΡΠ°Π½ΠΎΠ²ΠΈΡΡΡ ΡΠΎΠΏΡΡΡΡΠ²ΡΡΡΠ΅ΠΉ ΠΏΠ°ΡΠΎΠ»ΠΎΠ³ΠΈΠ΅ΠΉ. Π‘ΠΈΠΌΠΏΡΠΎΠΌΡ Π΅Π³ΠΎ Π·Π°Π²ΠΈΡΡΡ ΠΎΡ ΠΊΠΎΠ½ΠΊΡΠ΅ΡΠ½ΠΎΠ³ΠΎ Π²ΠΈΡΡΡΠ°. Π§Π°ΡΠ΅ Π²ΡΠ΅Π³ΠΎ Π΄ΠΈΠ°Π³Π½ΠΎΡΡΠΈΡΡΡΡΡΡ Π°Π΄Π΅Π½ΠΎΠ²ΠΈΡΡΡΠ½ΡΠΉ ΠΈ Π³Π΅ΡΠΏΠ΅ΡΠΈΡΠ΅ΡΠΊΠΈΠΉ ΡΠΈΠΏΡ Π²ΠΎΡΠΏΠ°Π»Π΅Π½ΠΈΡ ΡΠΎΠ΅Π΄ΠΈΠ½ΠΈΡΠ΅Π»ΡΠ½ΠΎΠΉ ΠΎΠ±ΠΎΠ»ΠΎΡΠΊΠΈ. ΠΠ΄Π΅Π½ΠΎΠ²ΠΈΡΡΡΡ ΡΠ½Π°ΡΠ°Π»Π° ΠΏΡΠΈΠ²ΠΎΠ΄ΡΡ ΠΊ ΡΠ°Π·Π²ΠΈΡΠΈΡ ΠΠ ΠΠ. ΠΡΠΈΠ·Π½Π°ΠΊΠΈ ΡΡΠΎΠ³ΠΎ Π·Π°Π±ΠΎΠ»Π΅Π²Π°Π½ΠΈΡ ΠΈΠ·Π²Π΅ΡΡΠ½Ρ ΠΊΠ°ΠΆΠ΄ΠΎΠΌΡ:
- ΠΏΠΎΠ²ΡΡΠ΅Π½Π½Π°Ρ ΡΠ΅ΠΌΠΏΠ΅ΡΠ°ΡΡΡΠ° ΡΠ΅Π»Π°;
- Π½Π°ΡΠΌΠΎΡΠΊ;
- ΠΊΠ°ΡΠ΅Π»Ρ;
- Π±ΠΎΠ»Π΅Π²ΡΠ΅ ΠΎΡΡΡΠ΅Π½ΠΈΡ Π² Π³ΠΎΡΠ»Π΅ ΠΏΡΠΈ ΡΠ³Π»Π°ΡΡΠ²Π°Π½ΠΈΠΈ;
- ΡΠ²Π΅Π»ΠΈΡΠ΅Π½ΠΈΠ΅ Π»ΠΈΠΌΡΠ°ΡΠΈΡΠ΅ΡΠΊΠΈΡ ΡΠ·Π»ΠΎΠ²;
- Π³ΠΎΠ»ΠΎΠ²Π½ΡΠ΅ Π±ΠΎΠ»ΠΈ.

ΠΠΎΠ½ΡΡΠ½ΠΊΡΠΈΠ²ΠΈΡ Π²ΠΎΠ·Π½ΠΈΠΊΠ°Π΅Ρ ΡΠΎΠ»ΡΠΊΠΎ Π² ΡΠ΅Π·ΡΠ»ΡΡΠ°ΡΠ΅ ΠΏΠΎΠΏΠ°Π΄Π°Π½ΠΈΡ Π°Π΄Π΅Π½ΠΎΠ²ΠΈΡΡΡΠΎΠ² Π½Π° ΠΊΠΎΠ½ΡΡΠ½ΠΊΡΠΈΠ²Ρ. ΠΡΠΈ ΠΠ ΠΠ ΡΠ°ΠΊΠΎΠ΅ ΡΠ»ΡΡΠ°Π΅ΡΡΡ Π½Π΅ΡΠ΅Π΄ΠΊΠΎ. ΠΠ°Π½Π½Π°Ρ ΠΈΠ½ΡΠ΅ΠΊΡΠΈΡ ΠΎΡΠ»ΠΈΡΠ°Π΅ΡΡΡ Π²ΡΡΠΎΠΊΠΎΠΉ ΠΊΠΎΠ½ΡΠ°Π³ΠΈΠΎΠ·Π½ΠΎΡΡΡΡ. ΠΠΈΡΡΡ ΠΌΠΎΠΆΠ΅Ρ ΠΏΠΎΠΏΠ°ΡΡΡ Π² Π³Π»Π°Π· Ρ ΠΏΠ»Π°ΡΠΊΠ°, ΡΠ°Π»ΡΠ΅ΡΠΊΠΈ ΠΈΠ»ΠΈ ΡΡΠΊ. ΠΠΎΡΠΏΠ°Π»Π΅Π½ΠΈΠ΅ ΡΠ»ΠΈΠ·ΠΈΡΡΠΎΠΉ Π²ΠΎΠ·Π½ΠΈΠΊΠ°Π΅Ρ ΡΠΎΠ»ΡΠΊΠΎ ΡΠΏΡΡΡΡ Π½Π΅ΡΠΊΠΎΠ»ΡΠΊΠΎ Π΄Π½Π΅ΠΉ ΠΈΠ»ΠΈ Π½Π΅Π΄Π΅Π»Ρ. ΠΠ°ΡΠ°Π»ΠΎ Π΅Π³ΠΎ Π½Π΅ ΡΠ°ΠΊΠΎΠ΅ ΡΡΡΠ΅ΠΌΠΈΡΠ΅Π»ΡΠ½ΠΎΠ΅, ΠΊΠ°ΠΊ ΠΏΡΠΈ ΠΎΡΡΡΠΎΠΌ Π±Π°ΠΊΡΠ΅ΡΠΈΠ°Π»ΡΠ½ΠΎΠΌ ΠΊΠΎΠ½ΡΡΠ½ΠΊΡΠΈΠ²ΠΈΡΠ΅. ΠΠΎΠ»ΡΠ½ΠΎΠΉ Π·Π°ΠΌΠ΅ΡΠ°Π΅Ρ, ΡΡΠΎ ΠΏΠΎΡΠ²ΠΈΠ»ΡΡ Π·ΡΠ΄ ΠΈ ΠΆΠΆΠ΅Π½ΠΈΠ΅. ΠΠ°Π»Π΅Π΅ ΡΠ°Π·Π²ΠΈΠ²Π°Π΅ΡΡΡ ΡΠ»Π΅Π·ΠΎΡΠ΅ΡΠ΅Π½ΠΈΠ΅. ΠΠ»Π°Π·Π° ΠΊΡΠ°ΡΠ½Π΅ΡΡ, Π²Π΅ΠΊΠΈ ΠΎΡΠ΅ΠΊΠ°ΡΡ. ΠΡΠ΅ ΡΠ΅ΡΠ΅Π· 2-3 Π΄Π½Ρ Π½Π°Π±Π»ΡΠ΄Π°Π΅ΡΡΡ Π²ΡΠ΄Π΅Π»Π΅Π½ΠΈΠ΅ ΡΠ»ΠΈΠ·ΠΈ. ΠΡΠΈ ΠΊΠ°ΡΠ°ΡΠ°Π»ΡΠ½ΠΎΠΉ ΡΠΎΡΠΌΠ΅ Π²ΠΈΡΡΡΠ½ΠΎΠ³ΠΎ ΠΊΠΎΠ½ΡΡΠ½ΠΊΡΠΈΠ²ΠΈΡΠ° Π³Π»Π°Π·Π° ΠΏΠΎΡΡΠΈ Π½Π΅ ΠΊΡΠ°ΡΠ½Π΅ΡΡ, Π²ΡΠ΅ ΠΏΡΠΈΠ·Π½Π°ΠΊΠΈ ΡΠΌΠ΅ΡΠ΅Π½Π½ΡΠ΅, ΡΠΊΡΡΡΠ΄Π°ΡΠ° ΠΌΠ°Π»ΠΎ. ΠΠΎΠ»Π΅Π·Π½Ρ ΠΏΡΠΎΡΠ΅ΠΊΠ°Π΅Ρ Π±Π΅Π· ΡΠΈΠ»ΡΠ½ΠΎΠ³ΠΎ Π΄ΠΈΡΠΊΠΎΠΌΡΠΎΡΡΠ° Π΄Π»Ρ ΠΏΠ°ΡΠΈΠ΅Π½ΡΠ°. ΠΠΎΠ»Π½ΠΎΠ΅ Π²ΡΠ·Π΄ΠΎΡΠΎΠ²Π»Π΅Π½ΠΈΠ΅ Π½Π°ΡΡΡΠΏΠ°Π΅Ρ ΡΠ΅ΡΠ΅Π· 2-3 Π½Π΅Π΄Π΅Π»ΠΈ. ΠΠ°ΡΠΈΠ΅Π½Ρ, ΠΊΠ°ΠΊ ΠΏΡΠ°Π²ΠΈΠ»ΠΎ, ΠΏΡΠ΅Ρ ΠΏΡΠΎΡΠΈΠ²ΠΎΠ²ΠΈΡΡΡΠ½ΡΠ΅ ΠΏΡΠ΅ΠΏΠ°ΡΠ°ΡΡ ΠΎΡ ΠΠ ΠΠ, ΠΏΡΠΈΠ½ΠΈΠΌΠ°Π΅Ρ Π²ΠΈΡΠ°ΠΌΠΈΠ½Ρ, ΡΡΠΎ ΡΠΏΠΎΡΠΎΠ±ΡΡΠ²ΡΠ΅Ρ ΠΈ ΡΡΡΡΠ°Π½Π΅Π½ΠΈΡ ΡΠΈΠΌΠΏΡΠΎΠΌΠΎΠ² Π²ΠΎΡΠΏΠ°Π»Π΅Π½ΠΈΡ ΠΊΠΎΠ½ΡΡΠ½ΠΊΡΠΈΠ²Ρ. ΠΠ½ΠΎΠ³Π΄Π° Π±ΠΎΠ»Π΅Π·Π½Ρ ΠΎΡΠ»ΠΎΠΆΠ½ΡΠ΅ΡΡΡ. ΠΠ° ΡΠ»ΠΈΠ·ΠΈΡΡΠΎΠΉ ΠΎΠ±ΡΠ°Π·ΡΡΡΡΡ ΡΠΎΠ»Π»ΠΈΠΊΡΠ»Ρ β ΠΈΠ½ΡΠΈΠ»ΡΡΡΠ°ΡΡ, ΠΏΡΠ΅Π΄ΡΡΠ°Π²Π»ΡΡΡΠΈΠ΅ ΡΠΎΠ±ΠΎΠΉ ΡΠΊΠΎΠΏΠ»Π΅Π½ΠΈΠ΅ Π»ΠΈΠΌΡΡ ΠΈ ΠΊΡΠΎΠ²ΠΈ. ΠΠ·-Π·Π° Π½ΠΈΡ ΠΏΠΎΡΡΠΎΡΠ½Π½ΠΎ ΡΠ΅ΠΊΡΡ ΡΠ»Π΅Π·Ρ. ΠΡΠΎ ΠΏΡΠΈΠ²ΠΎΠ΄ΠΈΡ ΠΊ ΡΠ°Π·Π²ΠΈΡΠΈΡ Π±Π»Π΅ΡΠ°ΡΠΎΡΠΏΠ°Π·ΠΌΠ°, ΠΊΠΎΠ³Π΄Π° Π²Π΅ΠΊΠΈ Π½Π΅ΠΏΡΠΎΠΈΠ·Π²ΠΎΠ»ΡΠ½ΠΎ ΡΠΌΡΠΊΠ°ΡΡΡΡ.Β

Π€ΠΎΠ»Π»ΠΈΠΊΡΠ»ΡΡΠ½ΡΠΉ ΠΊΠΎΠ½ΡΡΠ½ΠΊΡΠΈΠ²ΠΈΡ β ΡΡΠΎ Π½Π΅ ΡΠ°ΠΌΠ°Ρ ΡΠ»ΠΎΠΆΠ½Π°Ρ ΡΠΎΡΠΌΠ° Π²ΠΈΡΡΡΠ½ΠΎΠ³ΠΎ Π²ΠΎΡΠΏΠ°Π»Π΅Π½ΠΈΡ ΡΠ»ΠΈΠ·ΠΈΡΡΠΎΠΉ Π³Π»Π°Π·Π°. ΠΡΠ²Π°Π΅Ρ, ΡΡΠΎ Π½Π° Π½Π΅ΠΉ Π½Π°ΡΠΈΠ½Π°ΡΡ ΠΏΠΎΡΠ²Π»ΡΡΡΡΡ ΠΏΠ»Π΅Π½ΠΊΠΈ ΡΠ΅ΡΠΎΠ³ΠΎ ΠΈΠ»ΠΈ ΠΆΠ΅Π»ΡΠΎΠ²Π°ΡΠΎΠ³ΠΎ ΡΠ²Π΅ΡΠ°. ΠΠ½ΠΈ Π΄ΠΎΡΡΠ°ΡΠΎΡΠ½ΠΎ ΡΠΎΠ½ΠΊΠΈΠ΅ ΠΈ Π±ΡΡΡΡΠΎ ΡΠ΄Π°Π»ΡΡΡΡΡ ΡΠ°ΠΌΠΏΠΎΠ½ΠΎΠΌ. ΠΡΠΈ ΡΡΠΆΠ΅Π»ΠΎΠΌ ΠΏΡΠΎΡΠ΅ΠΊΠ°Π½ΠΈΠΈ Π±ΠΎΠ»Π΅Π·Π½ΠΈ ΡΡΠΈ ΠΎΠ±ΡΠ°Π·ΠΎΠ²Π°Π½ΠΈΡ ΡΠΏΠ»ΠΎΡΠ½ΡΡΡΡΡ. Π’ΠΎΠ³Π΄Π° ΠΈΡ ΠΎΡΠ΄Π΅Π»ΡΡΡ Π½Π΅ ΡΠ΅ΠΊΠΎΠΌΠ΅Π½Π΄ΡΠ΅ΡΡΡ. ΠΠ°ΠΊ ΠΈ ΠΏΡΠΈ Π΄ΠΈΡΡΠ΅ΡΠΈΡΠΈΡΠ΅ΡΠΊΠΎΠΌ ΠΊΠΎΠ½ΡΡΠ½ΠΊΡΠΈΠ²ΠΈΡΠ΅, ΡΡΠΎ Π²ΡΠ·ΡΠ²Π°Π΅Ρ ΠΊΡΠΎΠ²ΠΎΡΠ΅ΡΠ΅Π½ΠΈΡ. ΠΠ»Π΅Π½ΠΎΡΠ½Π°Ρ ΡΠΎΡΠΌΠ° Π²ΠΎΡΠΏΠ°Π»Π΅Π½ΠΈΡ Π΄ΠΈΠ°Π³Π½ΠΎΡΡΠΈΡΡΠ΅ΡΡΡ ΡΠ΅Π΄ΠΊΠΎ ΠΈ Π² ΠΎΡΠ½ΠΎΠ²Π½ΠΎΠΌ Ρ Π΄Π΅ΡΠ΅ΠΉ. ΠΠ΄Π½Π°ΠΊΠΎ ΠΎΠ½Π° ΠΎΡΠ΅Π½Ρ ΠΎΠΏΠ°ΡΠ½Π°Ρ, Π»Π΅ΡΠΈΡΡΡ Π΄ΠΎΠ»Π³ΠΎ ΠΈ ΠΈΠ½ΠΎΠ³Π΄Π° ΡΠΎΠΏΡΠΎΠ²ΠΎΠΆΠ΄Π°Π΅ΡΡΡ ΠΎΡΠ»ΠΎΠΆΠ½Π΅Π½ΠΈΡΠΌΠΈ, ΡΠ²ΡΠ·Π°Π½Π½ΡΠΌΠΈ Ρ ΡΡ ΡΠ΄ΡΠ΅Π½ΠΈΠ΅ΠΌ Π·ΡΠ΅Π½ΠΈΡ.
ΠΠ°ΠΊ ΠΏΡΠΎΡΠ²Π»ΡΠ΅ΡΡΡ Π³Π΅ΡΠΏΠ΅ΡΠΈΡΠ΅ΡΠΊΠΈΠΉ ΠΊΠΎΠ½ΡΡΠ½ΠΊΡΠΈΠ²ΠΈΡ?
Π²ΠΈΡΠ°ΠΌΠΈΠ½Ρ ΠΈ Π²ΠΎΠ²ΡΠ΅ΠΌΡ Π½Π°ΡΠΈΠ½Π°Π΅Ρ Π»Π΅ΡΠΈΡΡ Π²ΡΠ΅ Π±ΠΎΠ»Π΅Π·Π½ΠΈ, ΡΠ΅Π΄ΠΊΠΎ ΠΆΠ°Π»ΡΠ΅ΡΡΡ Π½Π° Π³Π΅ΡΠΏΠ΅Ρ. ΠΠΊΡΠΈΠ²ΠΈΠ·ΠΈΡΡΠ΅ΡΡΡ ΡΡΠΎΡ Π²ΠΈΡΡΡ ΠΏΡΠΈ ΠΎΡΠ»Π°Π±Π»Π΅Π½Π½ΠΎΠΌ ΠΈΠΌΠΌΡΠ½ΠΈΡΠ΅ΡΠ΅. ΠΡΠΈ ΡΡΠΎΠΌ ΠΏΠΎΡΠ²ΠΈΡΡΡΡ Π΅Π³ΠΎ ΠΏΡΠΈΠ·Π½Π°ΠΊΠΈ ΠΌΠΎΠ³ΡΡ ΠΏΠΎΡΡΠΈ Π² Π»ΡΠ±ΠΎΠΉ ΠΎΠ±Π»Π°ΡΡΠΈ ΡΠ΅Π»Π°, Π² ΡΠΎΠΌ ΡΠΈΡΠ»Π΅ Π½Π° ΠΎΡΠ³Π°Π½Π°Ρ Π·ΡΠ΅Π½ΠΈΡ. ΠΠ»Ρ Π³Π΅ΡΠΏΠ΅ΡΠΈΡΠ΅ΡΠΊΠΎΠ³ΠΎ ΠΊΠΎΠ½ΡΡΠ½ΠΊΡΠΈΠ²ΠΈΡΠ° Ρ Π°ΡΠ°ΠΊΡΠ΅ΡΠ½ΠΎ ΠΎΠ±ΡΠ°Π·ΠΎΠ²Π°Π½ΠΈΠ΅ Π½Π° ΠΊΠΎΠΆΠ΅ Π²ΠΎΠΊΡΡΠ³ Π³Π»Π°Π· ΠΈ Π½Π° Π²Π΅ΠΊΠ°Ρ ΠΌΠ½ΠΎΠ³ΠΎΡΠΈΡΠ»Π΅Π½Π½ΡΡ ΠΏΡΠ·ΡΡΡΠΊΠΎΠ². ΠΠ½ΠΈ Π·ΡΠ΄ΡΡ, ΡΠ΅ΡΡΡΡΡ, Π²ΡΠ·ΡΠ²Π°ΡΡ ΠΆΠΆΠ΅Π½ΠΈΠ΅. ΠΡΠ΄Π°Π²Π»ΠΈΠ²Π°ΡΡ ΠΈ ΡΠ°ΡΡΠ΅ΡΡΠ²Π°ΡΡ ΡΡΠΈ Π½ΠΎΠ²ΠΎΠΎΠ±ΡΠ°Π·ΠΎΠ²Π°Π½ΠΈΡ Π½Π΅Π»ΡΠ·Ρ. ΠΡ ΡΠΈΡΠ»ΠΎ Π±ΡΠ΄Π΅Ρ ΡΠ²Π΅Π»ΠΈΡΠΈΠ²Π°ΡΡΡΡ. ΠΠΎΠ½ΡΡΠ½ΠΊΡΠΈΠ²Π° ΠΏΡΠΈ Π³Π΅ΡΠΏΠ΅ΡΠΈΡΠ΅ΡΠΊΠΎΠΌ Π²ΠΎΡΠΏΠ°Π»Π΅Π½ΠΈΠΈ ΡΠΈΠ»ΡΠ½ΠΎ ΠΊΡΠ°ΡΠ½Π΅Π΅Ρ.Β

ΠΠ°Π±ΠΎΠ»Π΅Π²Π°Π½ΠΈΠ΅ Π»Π΅ΡΠΈΡΡΡ ΠΏΡΠΎΡΠΈΠ²ΠΎΠ³Π΅ΡΠΏΠ΅ΡΠΈΡΠ΅ΡΠΊΠΈΠΌΠΈ ΠΏΡΠ΅ΠΏΠ°ΡΠ°ΡΠ°ΠΌΠΈ. ΠΠΏΠ°ΡΠ½ΠΎΡΡΡ ΠΏΠ°ΡΠΎΠ»ΠΎΠ³ΠΈΠΈ Π² ΡΠΎΠΌ, ΡΡΠΎ Π½Π΅ Π²ΡΠ΅ ΠΎΡΠ²Π΅ΡΡΡΠ²Π΅Π½Π½ΠΎ ΠΏΠΎΠ΄Ρ ΠΎΠ΄ΡΡ ΠΊ Π΅Π΅ Π»Π΅ΡΠ΅Π½ΠΈΡ. ΠΠΎ-ΠΏΠ΅ΡΠ²ΡΡ , ΡΠ°ΠΌ ΠΏΠΎ ΡΠ΅Π±Π΅ Π³Π΅ΡΠΏΠ΅Ρ Π±Π΅Π· Π»Π΅ΡΠ΅Π½ΠΈΡ ΠΌΠΎΠΆΠ΅Ρ ΠΏΡΠΈΠ²Π΅ΡΡΠΈ ΠΊ ΡΡ ΡΠ΄ΡΠ΅Π½ΠΈΡ Π·ΡΠ΅Π½ΠΈΡ. ΠΠΎ-Π²ΡΠΎΡΡΡ , ΠΎΡΡΡΡΡΡΠ²ΠΈΠ΅ ΠΏΠΎΠ»Π½ΠΎΡΠ΅Π½Π½ΠΎΠΉ ΡΠ΅ΡΠ°ΠΏΠΈΠΈ ΠΏΡΠΈΠ²ΠΎΠ΄ΠΈΡ ΠΊ ΡΠ°Π·Π²ΠΈΡΠΈΡ Π±Π°ΠΊΡΠ΅ΡΠΈΠ°Π»ΡΠ½ΠΎΠΉ ΠΈΠ½ΡΠ΅ΠΊΡΠΈΠΈ. Π ΡΠ°ΠΊΠΈΡ ΡΠ»ΡΡΠ°ΡΡ Π±ΠΎΠ»Π΅Π·Π½Ρ Π·Π°ΡΡΠ³ΠΈΠ²Π°Π΅ΡΡΡ. ΠΠ°ΠΊ ΡΠΆΠ΅ Π±ΡΠ»ΠΎ ΡΠ°ΡΡΠΊΠ°Π·Π°Π½ΠΎ ΡΠ°Π½Π΅Π΅, ΠΊΠΎΠ½ΡΡΠ½ΠΊΡΠΈΠ²ΠΈΡΡ, Π²ΡΠ·Π²Π°Π½Π½ΡΠ΅ Π±Π°ΠΊΡΠ΅ΡΠΈΡΠΌΠΈ, ΠΏΡΠΎΡΠ΅ΠΊΠ°ΡΡ ΠΏΡΠ΅ΠΈΠΌΡΡΠ΅ΡΡΠ²Π΅Π½Π½ΠΎ Π² ΠΎΡΡΡΠΎΠΉ ΡΠΎΡΠΌΠ΅. ΠΠΎ Π²ΡΠ΅ΠΌ ΠΏΡΠΈΠ·Π½Π°ΠΊΠ°ΠΌ Π³Π΅ΡΠΏΠ΅ΡΠ° Π΄ΠΎΠ±Π°Π²Π»ΡΡΡΡΡ ΡΠΈΠΌΠΏΡΠΎΠΌΡ Π±Π°ΠΊΡΠ΅ΡΠΈΠ°Π»ΡΠ½ΠΎΠ³ΠΎ Π²ΠΎΡΠΏΠ°Π»Π΅Π½ΠΈΡ, ΠΎ Π½Π°ΡΠ°Π»Π΅ ΠΊΠΎΡΠΎΡΠΎΠ³ΠΎ ΡΠ²ΠΈΠ΄Π΅ΡΠ΅Π»ΡΡΡΠ²ΡΡΡ ΠΎΡΠ΅ΡΠ½ΠΎΡΡΡ, Π³ΠΈΠΏΠ΅ΡΠ΅ΠΌΠΈΡ, ΡΠ»Π΅Π·ΠΎΡΠ΅ΡΠ΅Π½ΠΈΠ΅, ΡΠ²Π΅ΡΠΎΠ±ΠΎΡΠ·Π½Ρ ΠΈ Π³Π½ΠΎΠΉΠ½ΡΠ΅ Π²ΡΠ΄Π΅Π»Π΅Π½ΠΈΡ.
ΠΠ·-Π·Π° ΡΠ΅Π³ΠΎ ΠΏΠΎΡΠ²Π»ΡΠ΅ΡΡΡ Π³ΡΠΈΠ±ΠΊΠΎΠ²ΡΠΉ ΠΊΠΎΠ½ΡΡΠ½ΠΊΡΠΈΠ²ΠΈΡ?
ΠΡΠ° ΡΠ°Π·Π½ΠΎΠ²ΠΈΠ΄Π½ΠΎΡΡΡ Π²ΠΎΡΠΏΠ°Π»Π΅Π½ΠΈΡ ΠΊΠΎΠ½ΡΡΠ½ΠΊΡΠΈΠ²Ρ ΠΎΡΠ»ΠΈΡΠ°Π΅ΡΡΡ ΠΏΠΎ ΡΠΎΡΠΌΠ΅ ΠΏΡΠΎΡΠ΅ΠΊΠ°Π½ΠΈΡ ΠΎΡ Π²ΠΈΡΡΡΠ½ΠΎΠ³ΠΎ ΠΈ Π±Π°ΠΊΡΠ΅ΡΠΈΠ°Π»ΡΠ½ΠΎΠ³ΠΎ ΠΊΠΎΠ½ΡΡΠ½ΠΊΡΠΈΠ²ΠΈΡΠΎΠ². ΠΠ°Π·ΡΠ²Π°Π΅ΡΡΡ ΠΎΠ½Π° ΠΎΡΡΠ°Π»ΡΠΌΠΎΠΌΠΈΠΊΠΎΠ·ΠΎΠΌ, ΠΊΠΎΡΠΎΡΡΠΉ ΠΎΠ±ΡΡΠ½ΠΎ Π½ΠΎΡΠΈΡ ΠΏΠΎΠ΄ΠΎΡΡΡΡΠΉ ΠΈΠ»ΠΈ Ρ ΡΠΎΠ½ΠΈΡΠ΅ΡΠΊΠΈΠΉ Ρ Π°ΡΠ°ΠΊΡΠ΅Ρ. ΠΠ΅ΡΠΈΡΡΡ Π±ΠΎΠ»Π΅Π·Π½Ρ Π΄ΠΎΡΡΠ°ΡΠΎΡΠ½ΠΎ Π΄ΠΎΠ»Π³ΠΎ, ΡΠ°ΠΊ ΠΊΠ°ΠΊ Π°Π½ΡΠΈΠ±ΠΈΠΎΡΠΈΠΊΠΈ ΠΏΠΎΠΌΠΎΠ³Π°ΡΡ Π½Π΅ Π²ΡΠ΅Π³Π΄Π°.
ΠΠ° ΠΊΠΎΠΆΠ΅ ΡΠ΅Π»ΠΎΠ²Π΅ΠΊΠ°, Π² ΡΠΎΠΌ ΡΠΈΡΠ»Π΅ Π½Π° Π»ΠΈΡΠ΅, ΠΎΠ±ΠΈΡΠ°Π΅Ρ ΠΌΠ½ΠΎΠΆΠ΅ΡΡΠ²ΠΎ Π²ΠΈΠ΄ΠΎΠ² Π³ΡΠΈΠ±ΠΊΠΎΠ². Π ΠΎΡΠ½ΠΎΠ²Π½ΠΎΠΌ ΠΎΠ½ΠΈ Π²ΡΠ΅ ΡΡΠ»ΠΎΠ²Π½ΠΎ-ΠΏΠ°ΡΠΎΠ³Π΅Π½Π½ΡΠ΅, ΡΠΎ Π΅ΡΡΡ Π½Π΅ ΠΏΡΠ΅Π΄ΡΡΠ°Π²Π»ΡΡΡ ΠΎΠΏΠ°ΡΠ½ΠΎΡΡΠΈ Π΄Π»Ρ Π·Π΄ΠΎΡΠΎΠ²ΡΡ, Π½ΠΎ Π΄ΠΎ ΠΎΠΏΡΠ΅Π΄Π΅Π»Π΅Π½Π½ΠΎΠ³ΠΎ ΠΌΠΎΠΌΠ΅Π½ΡΠ°. Π‘ΡΠΎΠΈΡ ΡΠ΅Π»ΠΎΠ²Π΅ΠΊΡ ΠΏΡΠΎΡΡΡΠ΄ΠΈΡΡΡΡ, ΠΏΠ΅ΡΠ΅ΠΎΡ Π»Π°Π΄ΠΈΡΡΡΡ, ΠΊΠ°ΠΊ ΠΌΠΈΠΊΡΠΎΠ±Ρ Π½Π°ΡΠΈΠ½Π°ΡΡ ΡΠ°Π·ΠΌΠ½ΠΎΠΆΠ°ΡΡΡΡ. ΠΡΠ»ΠΈ ΠΎΠ½ΠΈ ΠΏΠΎΠΏΠ°Π΄Π°ΡΡ Π½Π° ΠΊΠΎΠ½ΡΡΠ½ΠΊΡΠΈΠ²Ρ, Π²ΠΎΠ·Π½ΠΈΠΊΠ°Π΅Ρ Π²ΠΎΡΠΏΠ°Π»ΠΈΡΠ΅Π»ΡΠ½ΡΠΉ ΠΏΡΠΎΡΠ΅ΡΡ. Π Π°ΡΠΏΠΎΠ»Π°Π³Π°ΡΡΠΈΠΌΠΈ ΡΠ°ΠΊΡΠΎΡΠ°ΠΌΠΈ ΠΊ Π΅Π³ΠΎ ΡΠ°Π·Π²ΠΈΡΠΈΡ ΡΠ²Π»ΡΡΡΡΡ:
- ΡΠ°Ρ Π°ΡΠ½ΡΠΉ Π΄ΠΈΠ°Π±Π΅Ρ;
- ΠΊΠ°ΡΠΈΠ΅Ρ;
- ΠΌΠΈΠΊΠΎΠ·;
- ΡΡΠ°Π²ΠΌΡ Π³Π»Π°Π·;
- ΠΊΠΎΠ½ΡΠ°ΠΊΡΠ½ΡΠΌΠΈ Π»ΠΈΠ½Π·Π°ΠΌΠΈ.Β

Π Π³ΡΡΠΏΠΏΡ ΡΠΈΡΠΊΠ° Π²Ρ ΠΎΠ΄ΡΡ Π»ΡΠ΄ΠΈ, ΠΏΡΠΈΠ½ΠΈΠΌΠ°ΡΡΠΈΠ΅ Π³Π»ΡΠΊΠΎΠΊΠΎΡΡΠΈΠΊΠΎΡΡΠ΅ΡΠΎΠΈΠ΄Ρ ΠΈ Π°Π½ΡΠΈΠ±ΠΈΠΎΡΠΈΠΊΠΈ. ΠΡΠΈΠ±ΠΊΠΈ Π±ΡΡΡΡΠΎ ΡΠ°Π·ΠΌΠ½ΠΎΠΆΠ°ΡΡΡΡ Π² ΡΡΠ»ΠΎΠ²ΠΈΡΡ ΠΏΠΎΠ²ΡΡΠ΅Π½Π½ΠΎΠΉ Π²Π»Π°ΠΆΠ½ΠΎΡΡΠΈ. ΠΠ°ΠΏΡΠ»Π΅Π½Π½Π°Ρ ΠΈΠ»ΠΈ Π·Π°Π΄ΡΠΌΠ»Π΅Π½Π½Π°Ρ Π°ΡΠΌΠΎΡΡΠ΅ΡΠ° ΡΠ°ΠΊΠΆΠ΅ ΡΠ²Π»ΡΠ΅ΡΡΡ Π΄Π»Ρ Π½ΠΈΡ Π±Π»Π°Π³ΠΎΠΏΡΠΈΡΡΠ½ΠΎΠΉ ΡΡΠ΅Π΄ΠΎΠΉ.
Π‘ΠΈΠΌΠΏΡΠΎΠΌΡ Π³ΡΠΈΠ±ΠΊΠΎΠ²ΠΎΠ³ΠΎ Π²ΠΎΡΠΏΠ°Π»Π΅Π½ΠΈΡ ΠΊΠΎΠ½ΡΡΠ½ΠΊΡΠΈΠ²Ρ
ΠΡΠΈ Π³ΡΠΈΠ±ΠΊΠΎΠ²ΠΎΠΌ ΠΊΠΎΠ½ΡΡΠ½ΠΊΡΠΈΠ²ΠΈΡΠ΅ Π½Π°Π±Π»ΡΠ΄Π°ΡΡΡΡ ΡΠΌΠ΅ΡΠ΅Π½Π½ΠΎΠ΅ ΠΏΠΎΠΊΡΠ°ΡΠ½Π΅Π½ΠΈΠ΅ ΠΊΠΎΠ½ΡΡΠ½ΠΊΡΠΈΠ²Ρ ΠΈ Π½Π΅Π·Π½Π°ΡΠΈΡΠ΅Π»ΡΠ½ΡΠ΅ Π²ΡΠ΄Π΅Π»Π΅Π½ΠΈΡ ΡΠ»ΠΈΠ·ΠΈ. ΠΡΠΈ ΡΡΠΆΠ΅Π»ΠΎΠΌ ΠΏΡΠΎΡΠ΅ΠΊΠ°Π½ΠΈΠΈ Π±ΠΎΠ»Π΅Π·Π½ΠΈ ΠΏΠΎΡΠ²Π»ΡΡΡΡΡ ΡΠΎΠ»Π»ΠΈΠΊΡΠ»Ρ, Π²ΡΠ΄Π΅Π»ΡΠ΅ΡΡΡ Π³Π½ΠΎΠΉΠ½ΡΠΉ ΡΠΊΡΡΡΠ΄Π°Ρ. ΠΠ΅ΠΊΠΎΡΠΎΡΡΠ΅ Π²ΠΈΠ΄Ρ Π³ΡΠΈΠ±ΠΊΠΎΠ² ΠΏΡΠΈΠ²ΠΎΠ΄ΡΡ ΠΊ ΠΎΠ±ΡΠ°Π·ΠΎΠ²Π°Π½ΠΈΡ ΡΠ·Π² Π½Π° ΡΠΎΠ΅Π΄ΠΈΠ½ΠΈΡΠ΅Π»ΡΠ½ΠΎΠΉ ΠΎΠ±ΠΎΠ»ΠΎΡΠΊΠ΅. ΠΠ°Π½Π΄ΠΈΠ΄Π° ΡΡΠ°Π½ΠΎΠ²ΠΈΡΡΡ ΠΏΡΠΈΡΠΈΠ½ΠΎΠΉ ΡΠΎΡΠΌΠΈΡΠΎΠ²Π°Π½ΠΈΡ ΡΠ΅ΡΠΎΠ²Π°ΡΠΎ-ΠΆΠ΅Π»ΡΡΡ ΠΏΠ»Π΅Π½ΠΎΠΊ Π² ΠΊΠΎΠ½ΡΡΠ½ΠΊΡΠΈΠ²Π°Π»ΡΠ½ΠΎΠΌ ΠΌΠ΅ΡΠΊΠ΅. ΠΡΠΈ Π°ΡΠΏΠ΅ΡΠ³ΠΈΠ»Π»Π΅Π·Π΅ Π½Π° ΡΠ»ΠΈΠ·ΠΈΡΡΠΎΠΉ Π²ΠΈΠ΄Π½Ρ ΡΠΎΡΠΎΡΠΊΠΎΠ²ΡΠ΅ ΡΠ°Π·ΡΠ°ΡΡΠ°Π½ΠΈΡ. Π‘ΠΈΠΌΠΏΡΠΎΠΌΡ Π½Π΅ ΠΎΡΠ»ΠΈΡΠ°ΡΡΡΡ ΡΡΠΊΠΎΠΉ Π²ΡΡΠ°ΠΆΠ΅Π½Π½ΠΎΡΡΡΡ, ΡΡΠΎ Π½Π°Π±Π»ΡΠ΄Π°Π΅ΡΡΡ ΠΏΡΠΈ ΠΎΡΡΡΠΎΠΌ ΠΏΡΠΎΡΠ΅ΠΊΠ°Π½ΠΈΠΈ Π²ΠΎΡΠΏΠ°Π»Π΅Π½ΠΈΡ. ΠΠ΄Π½Π°ΠΊΠΎ Π² ΡΡΠΎΠΌ ΠΈ Π·Π°ΠΊΠ»ΡΡΠ°Π΅ΡΡΡ ΠΊΠΎΠ²Π°ΡΡΡΠ²ΠΎ Π³ΡΠΈΠ±ΠΊΠΎΠ²ΠΎΠ³ΠΎ ΠΊΠΎΠ½ΡΡΠ½ΠΊΡΠΈΠ²ΠΈΡΠ°. ΠΠ°ΡΠ°ΡΡΡΡ ΠΎΠ½ ΡΠ°Π·Π²ΠΈΠ²Π°Π΅ΡΡΡ ΠΏΠ°ΡΠ°Π»Π»Π΅Π»ΡΠ½ΠΎ Ρ Π±Π»Π΅ΡΠ°ΡΠΈΡΠΎΠΌ ΠΈΠ»ΠΈ ΠΊΠ΅ΡΠ°ΡΠΈΡΠΎΠΌ. Π£ Π½Π΅ΠΊΠΎΡΠΎΡΡΡ ΠΏΠ°ΡΠΈΠ΅Π½ΡΠΎΠ² Π²ΠΎΠ·Π½ΠΈΠΊΠ°Π΅Ρ ΠΊΠ΅ΡΠ°ΡΠΎΠΊΠΎΠ½ΡΡΠ½ΠΊΡΠΈΠ²ΠΈΡ. ΠΡΠΈ ΠΏΠ°ΡΠΎΠ»ΠΎΠ³ΠΈΠΈ ΡΠΎΠΏΡΠΎΠ²ΠΎΠΆΠ΄Π°ΡΡΡΡ ΡΡ ΡΠ΄ΡΠ΅Π½ΠΈΠ΅ΠΌ Π·ΡΠ΅Π½ΠΈΡ.

ΠΠ»Π»Π΅ΡΠ³ΠΈΡΠ΅ΡΠΊΠΈΠΉ ΠΊΠΎΠ½ΡΡΠ½ΠΊΡΠΈΠ²ΠΈΡ ΠΈ Π΅Π³ΠΎ ΠΏΠ΅ΡΠ²ΡΠ΅ ΠΏΡΠΈΠ·Π½Π°ΠΊΠΈ
ΡΠ²Π»Π°ΠΆΠ½ΡΡΡΠΈΠΌΠΈ ΠΊΠ°ΠΏΠ»ΡΠΌΠΈ ΠΈ ΠΏΡΠΎΡΠΈΠ²ΠΎΠ°Π»Π»Π΅ΡΠ³Π΅Π½Π½ΡΠΌΠΈ Π»Π΅ΠΊΠ°ΡΡΡΠ²Π΅Π½Π½ΡΠΌΠΈ ΠΏΡΠ΅ΠΏΠ°ΡΠ°ΡΠ°ΠΌΠΈ. Π£ Π±ΠΎΠ»ΡΡΠΈΠ½ΡΡΠ²Π° Π°Π»Π»Π΅ΡΠ³ΠΈΠΊΠΎΠ² ΠΎΠ½ΠΈ Π½Π°Ρ ΠΎΠ΄ΡΡΡΡ ΠΏΠΎΠ΄ ΡΡΠΊΠΎΠΉ. ΠΠΎΠΌΠΈΠΌΠΎ Π·ΡΠ΄Π°, Π±ΠΎΠ»ΡΠ½ΠΎΠ³ΠΎ Π±Π΅ΡΠΏΠΎΠΊΠΎΡΡ ΡΠ»Π΅Π΄ΡΡΡΠΈΠ΅ ΡΠΈΠΌΠΏΡΠΎΠΌΡ:
- ΡΠ»Π΅Π·ΠΎΡΠ΅ΡΠ΅Π½ΠΈΠ΅ ΠΊΠ°ΠΊ ΡΠ΅Π°ΠΊΡΠΈΡ Π½Π° ΡΡΡ ΠΎΡΡΡ ΡΠΎΠ³ΠΎΠ²ΠΈΡΡ;
- ΠΆΠΆΠ΅Π½ΠΈΠ΅, ΡΠ΅ΠΆΡΡΠΈΠ΅ Π±ΠΎΠ»ΠΈ Π² Π³Π»Π°Π·Ρ, ΠΎΡΡΡΠ΅Π½ΠΈΠ΅ Β«ΠΏΠ΅ΡΠΊΠ°Β»;
- ΠΏΠΎΠ²ΡΡΠ΅Π½Π½Π°Ρ ΡΡΠΎΠΌΠ»ΡΠ΅ΠΌΠΎΡΡΡ ΠΎΡΠ³Π°Π½ΠΎΠ² Π·ΡΠ΅Π½ΠΈΡ;
- Π²ΠΎΠ·Π½ΠΈΠΊΠ½ΠΎΠ²Π΅Π½ΠΈΠ΅ ΡΡΠΏΠΈ Π½Π° ΡΠ»ΠΈΠ·ΠΈΡΡΠΎΠΉ, Π²Π΅ΠΊΠ°Ρ ΠΈ Π»ΠΈΡΠ΅;
- Π²ΡΡΠ°ΠΆΠ΅Π½Π½ΠΎΠ΅ ΠΏΠΎΠΊΡΠ°ΡΠ½Π΅Π½ΠΈΠ΅ ΠΊΠΎΠ½ΡΡΠ½ΠΊΡΠΈΠ²Ρ;
- Π½Π°ΡΠΌΠΎΡΠΊ.

ΠΠ»Π»Π΅ΡΠ³ΠΈΡΠ΅ΡΠΊΠΈΠ΅ ΠΊΠΎΠ½ΡΡΠ½ΠΊΡΠΈΠ²ΠΈΡΡ ΡΠ°ΠΊΠΆΠ΅ Π±ΡΠ²Π°ΡΡ ΡΠ°Π·Π½ΡΠΌΠΈ. ΠΡΠΈ ΠΏΠΎΠ»Π»ΠΈΠ½ΠΎΠ·Π½ΠΎΠΉ ΡΠΎΡΠΌΠ΅, ΠΊΠΎΡΠΎΡΠ°Ρ Π±Π΅ΡΠΏΠΎΠΊΠΎΠΈΡ Π°Π»Π»Π΅ΡΠ³ΠΈΠΊΠ° Π²Π΅ΡΠ½ΠΎΠΉ ΠΈ Π»Π΅ΡΠΎΠΌ Π² ΠΏΠ΅ΡΠΈΠΎΠ΄ ΡΠ²Π΅ΡΠ΅Π½ΠΈΡ ΡΠ°ΡΡΠ΅Π½ΠΈΠΉ, Π½Π°Π±Π»ΡΠ΄Π°Π΅ΡΡΡ Π·ΡΠ΄, ΡΠ»Π΅Π·ΠΎΡΠ΅ΡΠ΅Π½ΠΈΠ΅ ΠΈ Π²ΡΠ΄Π΅Π»Π΅Π½ΠΈΡ. ΠΡΠΈ Π°Π»Π»Π΅ΡΠ³ΠΈΠΈ Π½Π° Π»Π΅ΠΊΠ°ΡΡΡΠ²Π° ΠΊ ΠΆΠΆΠ΅Π½ΠΈΡ, Π·ΡΠ΄Ρ ΠΈ ΠΏΠΎΠΊΡΠ°ΡΠ½Π΅Π½ΠΈΡ ΠΊΠΎΠ½ΡΡΠ½ΠΊΡΠΈΠ²Ρ ΠΏΡΠΈΡΠΎΠ΅Π΄ΠΈΠ½ΡΠ΅ΡΡΡ ΡΠ°ΠΊΠΎΠΉ ΡΠΈΠΌΠΏΡΠΎΠΌ, ΠΊΠ°ΠΊ ΡΠ½ΠΈΠΆΠ΅Π½ΠΈΠ΅ ΠΎΡΡΡΠΎΡΡ Π·ΡΠ΅Π½ΠΈΡ. ΠΡΠΎ ΠΏΡΠΎΠΈΡΡ ΠΎΠ΄ΠΈΡ ΠΈΠ·-Π·Π° ΡΠΎΠ³ΠΎ, ΡΡΠΎ Π²ΠΎΡΠΏΠ°Π»Π΅Π½ΠΈΠ΅ ΠΎΡ Π²Π°ΡΡΠ²Π°Π΅Ρ ΡΠΎΠ³ΠΎΠ²ΠΈΡΡ.
ΠΠ΅ΡΠΏΠΎΠΊΠΎΡΡΠΈΠΉ Π·ΡΠ΄ ΠΌΠΎΠΆΠ΅Ρ ΡΡΠ°ΡΡ ΠΏΡΠΈΡΠΈΠ½ΠΎΠΉ Π·Π°ΡΠ°ΠΆΠ΅Π½ΠΈΡ ΠΊΠΎΠ½ΡΡΠ½ΠΊΡΠΈΠ²Ρ Π±Π°ΠΊΡΠ΅ΡΠΈΡΠΌΠΈ. ΠΠΎΠ»ΡΠ½ΠΎΠΉ ΡΠ΅ΡΠ΅Ρ Π³Π»Π°Π·Π° ΡΡΠΊΠ°ΠΌΠΈ ΠΈ Π·Π°Π½ΠΎΡΠΈΡ Π² Π½ΠΈΡ ΠΌΠΈΠΊΡΠΎΠ±Ρ. ΠΡΠΎΠ±Π΅Π½Π½ΠΎ ΡΠ°ΡΡΠΎ ΡΠ°ΠΊΠΎΠ΅ ΡΠ»ΡΡΠ°Π΅ΡΡΡ Ρ Π΄Π΅ΡΠ΅ΠΉ. ΠΠ°ΠΊ ΡΠ΅ΠΏΠ΅ΡΡ ΠΏΠΎΠ½ΡΡΠ½ΠΎ, Π΄Π»Ρ Π°Π»Π»Π΅ΡΠ³ΠΈΡΠ΅ΡΠΊΠΎΠ³ΠΎ ΠΈ Π±Π°ΠΊΡΠ΅ΡΠΈΠ°Π»ΡΠ½ΠΎΠ³ΠΎ ΠΎΡΡΡΠΎΠ³ΠΎ ΠΊΠΎΠ½ΡΡΠ½ΠΊΡΠΈΠ²ΠΈΡΠ° Ρ Π°ΡΠ°ΠΊΡΠ΅ΡΠ½Ρ ΠΏΠΎΡΡΠΈ ΠΎΠ΄ΠΈΠ½Π°ΠΊΠΎΠ²ΡΠ΅ ΡΠΈΠΌΠΏΡΠΎΠΌΡ. ΠΠ΄Π½Π°ΠΊΠΎ Π±ΠΎΠ»Π΅Π·Π½ΠΈ Π³Π»Π°Π·, Π²ΡΠ·Π²Π°Π½Π½ΡΠ΅ Π±Π°ΠΊΡΠ΅ΡΠΈΡΠΌΠΈ, ΠΏΠΎΡΡΠΈ Π²ΡΠ΅Π³Π΄Π° ΡΠΎΠΏΡΠΎΠ²ΠΎΠΆΠ΄Π°ΡΡΡΡ Π²ΡΠ΄Π΅Π»Π΅Π½ΠΈΠ΅ΠΌ ΡΠ»ΠΈΠ·ΠΈ ΠΈΠ»ΠΈ Π³Π½ΠΎΡ. ΠΡΠΈ ΠΏΠΎΡΠ²Π»Π΅Π½ΠΈΠΈ ΡΡΠΎΠ³ΠΎ ΠΏΡΠΈΠ·Π½Π°ΠΊΠ° Π²ΡΡΠ°Π΅Ρ ΡΠ΅ΡΡ ΠΎ Π½Π°Π·Π½Π°ΡΠ΅Π½ΠΈΠΈ Π°Π½ΡΠΈΠ±Π°ΠΊΡΠ΅ΡΠΈΠ°Π»ΡΠ½ΡΡ ΡΡΠ΅Π΄ΡΡΠ² ΠΈ Π°Π½ΡΠΈΠ±ΠΈΠΎΡΠΈΠΊΠΎΠ².
Π§Π΅ΠΌ ΠΎΠΏΠ°ΡΠ΅Π½ ΠΊΠΎΠ½ΡΡΠ½ΠΊΡΠΈΠ²ΠΈΡ?
ΠΡ ΠΏΠ΅ΡΠ΅ΡΠΈΡΠ»ΠΈΠ»ΠΈ ΠΎΡΠ½ΠΎΠ²Π½ΡΠ΅, ΡΠ°ΠΌΡΠ΅ ΡΠ°ΡΠΏΡΠΎΡΡΡΠ°Π½Π΅Π½Π½ΡΠ΅ ΡΠ°Π·Π½ΠΎΠ²ΠΈΠ΄Π½ΠΎΡΡΠΈ ΠΊΠΎΠ½ΡΡΠ½ΠΊΡΠΈΠ²ΠΈΡΠ°. Π‘ΡΡΠ΅ΡΡΠ²ΡΡΡ ΡΠ°ΠΊΠΆΠ΅ Ρ Π»Π°ΠΌΠΈΠ΄ΠΈΠΉΠ½ΡΠΉ, Π°Π½Π³ΡΠ»ΡΡΠ½ΡΠΉ ΠΈ Π΄ΡΡΠ³ΠΈΠ΅ ΡΠΈΠΏΡ Π²ΠΎΡΠΏΠ°Π»Π΅Π½ΠΈΡ ΡΠ»ΠΈΠ·ΠΈΡΡΠΎΠΉ Π³Π»Π°Π·Π°. ΠΠ½ΠΈ ΡΠΎΠΏΡΠΎΠ²ΠΎΠΆΠ΄Π°ΡΡΡΡ ΡΠ°ΠΊΠΈΠΌΠΈ ΠΆΠ΅ ΡΠΈΠΌΠΏΡΠΎΠΌΠ°ΠΌΠΈ, Π½ΠΎ Π΅ΡΡΡ ΠΈ ΡΠΏΠ΅ΡΠΈΡΠΈΡΠ΅ΡΠΊΠΈΠ΅ ΠΏΡΠΈΠ·Π½Π°ΠΊΠΈ, ΠΊΠΎΡΠΎΡΡΠ΅ Π½Π΅ Π²ΡΠ΅Π³Π΄Π° Π·Π°ΠΌΠ΅ΡΠ½Ρ ΠΏΡΠΈ ΠΏΠ΅ΡΠ²ΠΈΡΠ½ΠΎΠΌ ΠΎΡΠΌΠΎΡΡΠ΅. Π ΡΠ²ΡΠ·ΠΈ Ρ ΡΡΠΈΠΌ ΠΏΡΠΈ ΠΏΠΎΠ΄ΠΎΠ·ΡΠ΅Π½ΠΈΠΈ Π½Π° ΡΡ ΠΈΠ»ΠΈ ΠΈΠ½ΡΡ ΡΠΎΡΠΌΡ ΡΡΠΎΠ³ΠΎ Π·Π°Π±ΠΎΠ»Π΅Π²Π°Π½ΠΈΡ Π²ΡΠ°Ρ Π½Π°Π·Π½Π°ΡΠ°Π΅Ρ Π±Π°ΠΊΡΠ΅ΡΠΈΠΎΠ»ΠΎΠ³ΠΈΡΠ΅ΡΠΊΠΈΠ΅ ΠΈΡΡΠ»Π΅Π΄ΠΎΠ²Π°Π½ΠΈΡ, Π°Π»Π»Π΅ΡΠ³ΠΈΡΠ΅ΡΠΊΠΈΠ΅ ΠΏΡΠΎΠ±Ρ ΠΈ Π΄ΡΡΠ³ΠΈΠ΅ Π°Π½Π°Π»ΠΈΠ·Ρ, ΠΏΠΎΠ·Π²ΠΎΠ»ΡΡΡΠΈΠ΅ Π²ΡΡΠ²ΠΈΡΡ ΠΊΠΎΠ½ΠΊΡΠ΅ΡΠ½ΠΎΠ³ΠΎ Π²ΠΎΠ·Π±ΡΠ΄ΠΈΡΠ΅Π»Ρ Π²ΠΎΡΠΏΠ°Π»ΠΈΡΠ΅Π»ΡΠ½ΠΎΠ³ΠΎ ΠΏΡΠΎΡΠ΅ΡΡΠ°.

ΠΠΆΠ΅Π½ΠΈΠ΅, ΡΠ»Π΅Π·ΠΎΡΠ΅ΡΠ΅Π½ΠΈΠ΅, Π·ΡΠ΄, ΡΠ½ΠΈΠΆΠ΅Π½ΠΈΠ΅ ΠΎΡΡΡΠΎΡΡ Π·ΡΠ΅Π½ΠΈΡ Ρ
Π°ΡΠ°ΠΊΡΠ΅ΡΠ½Ρ Π΄Π»Ρ Π±ΠΎΠ»ΡΡΠΈΠ½ΡΡΠ²Π° ΠΎΡΡΠ°Π»ΡΠΌΠΎΠ»ΠΎΠ³ΠΈΡΠ΅ΡΠΊΠΈΡ
ΠΏΠ°ΡΠΎΠ»ΠΎΠ³ΠΈΠΉ. ΠΠΈ Π² ΠΊΠΎΠ΅ΠΌ ΡΠ»ΡΡΠ°Π΅ Π½Π΅Π»ΡΠ·Ρ Π·Π°Π½ΠΈΠΌΠ°ΡΡΡΡ ΡΠ°ΠΌΠΎΠ»Π΅ΡΠ΅Π½ΠΈΠ΅ΠΌ. Π’ΠΎΡΠ½ΠΎ ΠΏΠΎΡΡΠ°Π²ΠΈΡΡ Π΄ΠΈΠ°Π³Π½ΠΎΠ· ΠΡ ΡΠ°ΠΌΠΈ Π½Π΅ ΡΠΌΠΎΠΆΠ΅ΡΠ΅. ΠΠ΅ΡΠ²ΠΎΠ΅Π²ΡΠ΅ΠΌΠ΅Π½Π½ΠΎ Π½Π°ΡΠ°ΡΠΎΠ΅ Π»Π΅ΡΠ΅Π½ΠΈΠ΅ ΠΌΠΎΠΆΠ΅Ρ ΠΏΡΠΈΠ²Π΅ΡΡΠΈ ΠΊ ΡΠ°Π·Π²ΠΈΡΠΈΡ ΠΎΡΠ»ΠΎΠΆΠ½Π΅Π½ΠΈΠΉ. Π ΠΈΡ
ΡΠΈΡΠ»Π΅ β ΡΡ
ΡΠ΄ΡΠ΅Π½ΠΈΠ΅ Π·ΡΠ΅Π½ΠΈΡ, Π²ΠΎΡΠΏΠ°Π»Π΅Π½ΠΈΠ΅ ΡΠΎΠ³ΠΎΠ²ΠΈΡΡ ΠΈΠ»ΠΈ Π²ΡΠ΅Π³ΠΎ Π³Π»Π°Π·Π½ΠΎΠ³ΠΎ ΡΠ±Π»ΠΎΠΊΠ°, ΠΏΠ°Π½ΠΎΡΡΠ°Π»ΡΠΌΠΈΡ ΠΈ Π΄ΡΡΠ³ΠΈΠ΅ Π±ΠΎΠ»Π΅Π·Π½ΠΈ, ΠΈΠ·-Π·Π° ΠΊΠΎΡΠΎΡΡΡ
ΡΠ΅Π»ΠΎΠ²Π΅ΠΊ ΠΌΠΎΠΆΠ΅Ρ ΠΎΡΠ»Π΅ΠΏΠ½ΡΡΡ. Π Π΄Π΅ΡΡΠΊΠΎΠΌ Π²ΠΎΠ·ΡΠ°ΡΡΠ΅ ΠΊΠΎΠ½ΡΡΠ½ΠΊΡΠΈΠ²ΠΈΡ Π΅ΡΠ΅ Π±ΠΎΠ»Π΅Π΅ ΠΎΠΏΠ°ΡΠ΅Π½. ΠΠ»Π°Π·Π° Π΄Π΅ΡΠ΅ΠΉ Π½Π°Ρ
ΠΎΠ΄ΡΡΡΡ Π² ΡΡΠ°Π΄ΠΈΠΈ ΡΠΎΡΠΌΠΈΡΠΎΠ²Π°Π½ΠΈΡ. ΠΡΠ±ΠΎΠΉ ΠΏΠ°ΡΠΎΠ»ΠΎΠ³ΠΈΡΠ΅ΡΠΊΠΈΠΉ ΠΏΡΠΎΡΠ΅ΡΡ Π² ΠΎΡΠ³Π°Π½Π°Ρ
Π·ΡΠ΅Π½ΠΈΡ ΠΌΠΎΠΆΠ΅Ρ ΡΠΏΡΠΎΠ²ΠΎΡΠΈΡΠΎΠ²Π°ΡΡ ΠΏΡΠΎΠ³ΡΠ΅ΡΡΠΈΡΠΎΠ²Π°Π½ΠΈΠ΅ Π΄Π΅ΡΠ΅ΠΊΡΠ° ΡΠ΅ΡΡΠ°ΠΊΡΠΈΠΈ. ΠΡΠΈ ΠΏΠ΅ΡΠ²ΡΡ
ΠΆΠ΅ ΡΠΈΠΌΠΏΡΠΎΠΌΠ°Ρ
, ΠΎ ΠΊΠΎΡΠΎΡΡΡ
Π±ΡΠ»ΠΎ ΡΠ°ΡΡΠΊΠ°Π·Π°Π½ΠΎ Π² ΡΡΠ°ΡΡΠ΅, ΠΎΠ±ΡΠ·Π°ΡΠ΅Π»ΡΠ½ΠΎ Π·Π°ΠΏΠΈΡΠΈΡΠ΅ΡΡ Π½Π° ΠΏΡΠΈΠ΅ΠΌ ΠΊ ΠΎΡΡΠ°Π»ΡΠΌΠΎΠ»ΠΎΠ³Ρ.
Β
www.ochkov.net
Π§ΡΠΎ ΡΠ°ΠΊΠΎΠ΅ ΠΊΠΎΠ½ΡΡΠ½ΠΊΡΠΈΠ²ΠΈΡ: ΠΏΠ΅ΡΠ²ΡΠ΅ ΡΠΈΠΌΡΠΎΠΌΡ, Π²ΠΈΠ΄Ρ Π²ΠΎΡΠΏΠ°Π»Π΅Π½ΠΈΡ
ΠΡΠ²Π΅ΡΠ°Ρ Π½Π° Π²ΠΎΠΏΡΠΎΡ, ΡΡΠΎ ΡΠ°ΠΊΠΎΠ΅ ΠΊΠΎΠ½ΡΡΠ½ΠΊΡΠΈΠ²ΠΈΡ, ΠΏΡΠ΅ΠΆΠ΄Π΅ Π²ΡΠ΅Π³ΠΎ, ΡΠ»Π΅Π΄ΡΠ΅Ρ ΡΠΊΠ°Π·Π°ΡΡ, ΡΡΠΎ ΡΡΠΎ ΠΎΡΠ΅Π½Ρ Π½Π΅ΠΏΡΠΈΡΡΠ½ΠΎΠ΅ Π·Π°Π±ΠΎΠ»Π΅Π²Π°Π½ΠΈΠ΅. Π Π΅ΡΡ ΠΈΠ΄Π΅Ρ ΠΎ Π²ΠΎΡΠΏΠ°Π»Π΅Π½ΠΈΠΈ ΠΊΠΎΠ½ΡΡΠ½ΠΊΡΠΈΠ²Ρ β Π½Π°ΡΡΠΆΠ½ΠΎΠΉ Π³Π»Π°Π·Π½ΠΎΠΉ ΠΎΠ±ΠΎΠ»ΠΎΡΠΊΠΈ. ΠΠΎΠ»Π΅Π·Π½Ρ ΠΌΠΎΠΆΠ΅Ρ Π±ΡΡΡ Π²ΡΠ·Π²Π°Π½Π° ΠΌΠ½ΠΎΠ³ΠΈΠΌΠΈ ΡΠ°ΠΊΡΠΎΡΠ°ΠΌΠΈ, ΠΈ ΠΏΡΠΎΡΠ΅ΠΊΠ°ΡΡ Π² ΡΠΎΡΠΌΠ΅ Π½Π΅Π·Π½Π°ΡΠΈΡΠ΅Π»ΡΠ½ΠΎΠ³ΠΎ ΠΏΠΎΠΊΡΠ°ΡΠ½Π΅Π½ΠΈΡ ΠΈΠ»ΠΈ ΠΏΠ΅ΡΠ΅ΡΠ°ΡΡΠΈ Π² ΡΡΠΆΠ΅Π»ΠΎΠ΅ Π²ΠΎΡΠΏΠ°Π»Π΅Π½ΠΈΠ΅ Π³Π»Π°Π·Π°.

ΠΠΎΠ½ΡΡΠ½ΠΊΡΠΈΠ²Π°
ΠΠΎΠ½ΡΡΠ½ΠΊΡΠΈΠ²Π° (Π»Π°Ρ.: conjunctivae) β ΡΡΠΎ ΡΠ»ΠΈΠ·ΠΈΡΡΠ°Ρ ΠΎΠ±ΠΎΠ»ΠΎΡΠΊΠ°, ΠΏΠΎΠΊΡΡΠ²Π°ΡΡΠ°Ρ Π²Π½ΡΡΡΠ΅Π½Π½ΡΡ ΠΏΠΎΠ²Π΅ΡΡ Π½ΠΎΡΡΡ Π²Π΅ΠΊ ΠΈ ΡΠ°ΡΡΠΈΡΠ½ΠΎ Π²Π΅ΡΡ ΠΎΡΠ³Π°Π½Π° Π·ΡΠ΅Π½ΠΈΡ. ΠΡΠΎΡΡΡΠ°Π½ΡΡΠ²ΠΎ, ΡΠ°ΡΠΏΠΎΠ»ΠΎΠΆΠ΅Π½Π½ΠΎΠ΅ ΠΌΠ΅ΠΆΠ΄Ρ Π³Π»Π°Π·ΠΎΠΌ ΠΈ Π²Π΅ΠΊΠΎΠΌ, Π½Π°Π·ΡΠ²Π°Π΅ΡΡΡ Β«ΠΊΠΎΠ½ΡΡΠ½ΠΊΡΠΈΠ²Π°Π»ΡΠ½ΡΠΉ ΠΌΠ΅ΡΠΎΠΊΒ». ΠΠ»Π°Π³ΠΎΠ΄Π°ΡΡ ΡΠΎΠ½ΠΊΠΎΡΡΠΈ ΠΈ ΡΠ»Π°ΡΡΠΈΡΠ½ΠΎΡΡΠΈ, ΠΊΠΎΠ½ΡΡΠ½ΠΊΡΠΈΠ²Π° ΠΏΠΎΠ·Π²ΠΎΠ»ΡΠ΅Ρ Π³Π»Π°Π·Π°ΠΌ Π΄Π²ΠΈΠ³Π°ΡΡΡΡ. Π Π½Π΅ΠΉ ΡΠ°ΠΊ ΠΆΠ΅ ΡΠΎΠ΄Π΅ΡΠΆΠ°ΡΡΡ ΠΊΠ»Π΅ΡΠΊΠΈ ΠΈΠΌΠΌΡΠ½Π½ΠΎΠΉ β Π·Π°ΡΠΈΡΠ½ΠΎΠΉ β ΡΠΈΡΡΠ΅ΠΌΡ, ΠΏΠΎΡΡΠΎΠΌΡ ΠΎΠ½Π° ΡΠ»ΡΠΆΠΈΡ Π² ΠΊΠ°ΡΠ΅ΡΡΠ²Π΅ Π·Π°ΡΠΈΡΠ½ΠΎΠ³ΠΎ Π±Π°ΡΡΠ΅ΡΠ°, ΠΏΡΠ΅Π΄ΠΎΡΠ²ΡΠ°ΡΠ°ΡΡΠ΅Π³ΠΎ ΠΏΡΠΎΠ½ΠΈΠΊΠ½ΠΎΠ²Π΅Π½ΠΈΠ΅ Π²ΡΠ΅Π΄Π½ΡΡ Π²Π΅ΡΠ΅ΡΡΠ² Π² Π³Π»Π°Π·Π°. ΠΡΠΎΠΌΠ΅ ΡΠΎΠ³ΠΎ, Π² Π½Π΅ΠΉ ΡΠΎΡΠΌΠΈΡΡΠ΅ΡΡΡ ΡΠ»ΠΈΠ·Ρ, ΡΠ²Π»ΡΡΡΠ°ΡΡΡ ΡΠ°ΡΡΡΡ ΡΠ»Π΅Π·Π½ΠΎΠΉ ΠΏΠ»Π΅Π½ΠΊΠΈ.
ΠΠΎΠ½ΡΡΠ½ΠΊΡΠΈΠ²Π° Ρ ΠΎΡΠΎΡΠΎ ΠΎΡΠ½Π°ΡΠ΅Π½Π° ΠΊΡΠΎΡΠ΅ΡΠ½ΡΠΌΠΈ ΠΊΡΠΎΠ²Π΅Π½ΠΎΡΠ½ΡΠΌΠΈ ΡΠΎΡΡΠ΄Π°ΠΌΠΈ, ΡΠ΅Π°Π³ΠΈΡΡΡΡΠΈΠΌΠΈ Π½Π° Π»ΡΠ±ΠΎΠ΅ ΡΠ°Π·Π΄ΡΠ°ΠΆΠ΅Π½ΠΈΠ΅, ΡΡΠΎ, ΡΠ»Π΅Π΄ΠΎΠ²Π°ΡΠ΅Π»ΡΠ½ΠΎ, ΠΏΡΠΈΠ²ΠΎΠ΄ΠΈΡ ΠΊ Π΅Π΅ ΠΏΠΎΠΊΡΠ°ΡΠ½Π΅Π½ΠΈΡ. ΠΠ½Π° ΠΎΡΠ΅Π½Ρ ΡΡΠ²ΡΡΠ²ΠΈΡΠ΅Π»ΡΠ½Π°, ΠΏΠΎΡΠΊΠΎΠ»ΡΠΊΡ Π±ΠΎΠ³Π°ΡΠΎ ΠΈΠ½Π½Π΅ΡΠ²ΠΈΡΠΎΠ²Π°Π½Π°. ΠΠΎΡΡΠΎΠΌΡ ΠΈ Π»ΡΠ±ΠΎΠ΅ Π²ΠΎΡΠΏΠ°Π»Π΅Π½ΠΈΠ΅ ΠΈΠ»ΠΈ ΡΠ°Π·Π΄ΡΠ°ΠΆΠ΅Π½ΠΈΠ΅ ΠΏΡΠΎΡΠ²Π»ΡΠ΅ΡΡΡ ΠΎΡΠ΅Π½Ρ Π±ΠΎΠ»Π΅Π·Π½Π΅Π½Π½ΠΎ.
ΠΠ»ΠΈΠ½ΠΈΡΠ΅ΡΠΊΠ°Ρ ΠΊΠ°ΡΡΠΈΠ½Π° Π±ΠΎΠ»Π΅Π·Π½ΠΈ
ΠΠ»Ρ Π½Π΅ΡΠΏΠ΅ΡΠΈΠ°Π»ΠΈΡΡΠ° ΠΊΠ»ΠΈΠ½ΠΈΡΠ΅ΡΠΊΠ°Ρ ΠΊΠ°ΡΡΠΈΠ½Π° Π±ΠΎΠ»Π΅Π·Π½ΠΈ, Π½Π΅Π·Π°Π²ΠΈΡΠΈΠΌΠΎ ΠΎΡ ΡΠΈΠΏΠ° ΠΎΡΠ΅Π½Ρ ΠΏΠΎΡ
ΠΎΠΆΠ°. ΠΡΠ΅Π³Π΄Π° ΠΏΡΠΈΡΡΡΡΡΠ²ΡΠ΅Ρ ΠΏΠΎΠΊΡΠ°ΡΠ½Π΅Π½ΠΈΠ΅ Π³Π»Π°Π·, ΠΎΠ±ΡΡΠ»ΠΎΠ²Π»Π΅Π½Π½ΠΎΠ΅ ΡΠ°ΡΡΠΈΡΠ΅Π½ΠΈΠ΅ΠΌ ΠΊΡΠΎΠ²Π΅Π½ΠΎΡΠ½ΡΡ
ΡΠΎΡΡΠ΄ΠΎΠ² Π² ΠΊΠΎΠ½ΡΡΠ½ΠΊΡΠΈΠ²Π΅, ΠΊΠΎΡΠΎΡΠ°Ρ ΡΠ΅Π°Π³ΠΈΡΡΠ΅Ρ Π½Π° ΡΠ°Π·Π΄ΡΠ°ΠΆΠ΅Π½ΠΈΠ΅ Π²ΠΎΡΠΏΠ°Π»Π΅Π½ΠΈΠ΅ΠΌ. ΠΡΠΈ ΠΎΠΏΡΠ΅Π΄Π΅Π»Π΅Π½Π½ΡΡ
ΠΎΠ±ΡΡΠΎΡΡΠ΅Π»ΡΡΡΠ²Π°Ρ
Π²ΡΠ΄Π΅Π»ΡΡΡΡΡ Π±Π΅Π»ΡΠ΅, ΠΆΠ΅Π»ΡΡΠ΅ ΠΈΠ»ΠΈ ΠΏΠΎΠ»ΡΠΏΡΠΎΠ·ΡΠ°ΡΠ½ΡΠ΅ Π²ΡΠ΄Π΅Π»Π΅Π½ΠΈΡ.
Π‘ΡΠ±ΡΠ΅ΠΊΡΠΈΠ²Π½ΡΠ΅ ΠΎΡΡΡΠ΅Π½ΠΈΡ ΠΏΡΠ΅Π΄ΡΡΠ°Π²Π»Π΅Π½Ρ ΡΡΠ²ΡΡΠ²ΠΎΠΌ ΠΏΡΠΈΡΡΡΡΡΠ²ΠΈΡ ΠΈΠ½ΠΎΡΠΎΠ΄Π½ΠΎΠ³ΠΎ ΡΠ΅Π»Π° Π² Π³Π»Π°Π·Ρ, ΠΆΠΆΠ΅Π½ΠΈΠ΅ΠΌ, Π·ΡΠ΄ΠΎΠΌ ΠΈ ΡΠ»Π΅Π·ΠΎΡΠ΅ΡΠ΅Π½ΠΈΠ΅ΠΌ. ΠΠ΅ΡΠ΅Π΄ΠΊΠΎ ΠΏΠ»ΠΎΡ
ΠΎ ΠΏΠ΅ΡΠ΅Π½ΠΎΡΠΈΡΡΡ ΡΠΎΠ»Π½Π΅ΡΠ½ΡΠΉ ΡΠ²Π΅Ρ. Π£ΡΡΠΎΠΌ Π³Π»Π°Π·Π° ΡΡΠΆΠ΅Π»ΠΎ ΠΎΡΠΊΡΡΡΡ.
ΠΠ°ΠΆΠ½ΠΎ! ΠΡΠΈΡΠ΅Π»ΡΠ½ΡΠ΅ ΡΠ°ΡΡΡΡΠΎΠΉΡΡΠ²Π° ΠΏΡΠΈ ΠΊΠΎΠ½ΡΡΠ½ΠΊΡΠΈΠ²ΠΈΡΠ΅ ΠΎΡΡΡΡΡΡΠ²ΡΡΡ! ΠΡΠΈ ΡΠΈΠΌΠΏΡΠΎΠΌΡ ΡΠ²ΠΈΠ΄Π΅ΡΠ΅Π»ΡΡΡΠ²ΡΡΡ ΠΎ Π±ΠΎΠ»Π΅Π΅ ΡΠ΅ΡΡΠ΅Π·Π½ΡΡ ΠΎΡΡΠ°Π»ΡΠΌΠΎΠ»ΠΎΠ³ΠΈΡΠ΅ΡΠΊΠΈΡ Π·Π°Π±ΠΎΠ»Π΅Π²Π°Π½ΠΈΡΡ .
ΠΠΈΠ΄Ρ ΠΈ ΠΏΡΠΈΡΠΈΠ½Ρ Π²ΠΎΠ·Π½ΠΈΠΊΠ½ΠΎΠ²Π΅Π½ΠΈΡ
ΠΠΎΡΠΏΠ°Π»ΠΈΡΠ΅Π»ΡΠ½ΡΠ΅ Π·Π°Π±ΠΎΠ»Π΅Π²Π°Π½ΠΈΡ ΠΊΠΎΠ½ΡΡΠ½ΠΊΡΠΈΠ²Ρ ΠΌΠΎΠ³ΡΡ Π²ΠΎΠ·Π½ΠΈΠΊΠ°ΡΡ ΠΈΠ·-Π·Π° ΡΠΈΡΠΎΠΊΠΎΠ³ΠΎ ΡΡΠ΄Π° ΠΎΡΠ½ΠΎΠ²Π°Π½ΠΈΠΉ. ΠΠΌΠ΅Π½Π½ΠΎ Π² Π·Π°Π²ΠΈΡΠΈΠΌΠΎΡΡΠΈ ΠΎΡ ΠΏΡΠΈΡΠΈΠ½Ρ ΡΠ°Π·Π»ΠΈΡΠ°ΡΡΡΡ Π½Π΅ΡΠΊΠΎΠ»ΡΠΊΠΎ ΡΠΈΠΏΠΎΠ² Π·Π°Π±ΠΎΠ»Π΅Π²Π°Π½ΠΈΡ. ΠΠ»Ρ ΡΠΎΠ³ΠΎ, ΡΡΠΎΠ±Ρ Π² ΠΏΠΎΠ»Π½ΠΎΠΉ ΠΌΠ΅ΡΠ΅ ΠΏΠΎΠ»ΡΡΠΈΡΡ ΠΎΡΠ²Π΅Ρ Π½Π° Π²ΠΎΠΏΡΠΎΡ, ΡΡΠΎ β ΠΊΠΎΠ½ΡΡΠ½ΠΊΡΠΈΠ²ΠΈΡ, ΡΠ»Π΅Π΄ΡΠ΅Ρ Π·Π½Π°ΡΡ Π΅Π³ΠΎ ΠΏΡΠΈΡΠΈΠ½Ρ ΠΈ Π²ΠΎΠ·Π±ΡΠ΄ΠΈΡΠ΅Π»Ρ.
ΠΠΈΡΡΡΠ½ΡΠΉ ΠΊΠΎΠ½ΡΡΠ½ΠΊΡΠΈΠ²ΠΈΡ
Π‘Π°ΠΌΡΠΌ ΡΠ°ΡΠΏΡΠΎΡΡΡΠ°Π½Π΅Π½Π½ΡΠΌ Π²ΠΈΠ΄ΠΎΠΌ ΠΊΠΎΠ½ΡΡΠ½ΠΊΡΠΈΠ²ΠΈΡΠ°Β ΡΠ²Π»ΡΠ΅ΡΡΡ Π·Π°Π±ΠΎΠ»Π΅Π²Π°Π½ΠΈΠ΅ Π²ΠΈΡΡΡΠ½ΠΎΠΉ ΡΡΠΈΠΎΠ»ΠΎΠ³ΠΈΠΈ. ΠΡΠ° ΡΠΎΡΠΌΠ° Ρ Π°ΡΠ°ΠΊΡΠ΅ΡΠΈΠ·ΡΠ΅ΡΡΡ Π±ΡΡΡΡΡΠΌ Π½Π°ΡΠ°Π»ΠΎΠΌ, ΡΠ°ΡΡΠΎ β Β«ΠΈΠ· Π½ΠΈΡΠ΅Π³ΠΎΒ». Π‘ΠΈΠΌΠΏΡΠΎΠΌΠ°ΡΠΈΠΊΠ° ΠΎΡΠ΅Π½Ρ Π²ΡΡΠ°Π·ΠΈΡΠ΅Π»ΡΠ½Π°Ρ, ΠΎΡΠΎΠ±Π΅Π½Π½ΠΎ, ΡΡΠΊΠΎ ΠΏΡΠΎΡΠ²Π»ΡΠ΅ΡΡΡ Π±ΠΎΠ»Ρ, ΠΎΡΡΡΠ΅Π½ΠΈΠ΅ ΠΈΠ½ΠΎΡΠΎΠ΄Π½ΠΎΠ³ΠΎ ΡΠ΅Π»Π° Π² Π³Π»Π°Π·Ρ. ΠΠΎΠ»ΡΠ½ΡΠ΅ ΠΎΠΏΠΈΡΡΠ²Π°ΡΡ ΠΎΡΡΡΠ΅Π½ΠΈΠ΅ ΠΏΠ΅ΡΠΊΠ° ΠΏΠΎΠ΄ Π²Π΅ΠΊΠ°ΠΌΠΈ. Π Π±ΠΎΠ»ΡΡΠΈΠ½ΡΡΠ²Π΅ ΡΠ»ΡΡΠ°Π΅Π², Π³Π»Π°Π·Π° ΡΠ»Π΅Π·ΡΡΡΡ ΠΈΠ»ΠΈ Π²ΡΡΠ΅ΠΊΠ°ΡΡ ΠΏΡΠΎΠ·ΡΠ°ΡΠ½ΡΠ΅ Π²ΡΠ΄Π΅Π»Π΅Π½ΠΈΡ. ΠΠΎΠ½ΡΡΠ½ΠΊΡΠΈΠ²Π° β ΠΊΡΠ°ΡΠ½Π°Ρ, ΠΏΡΠΈΡΡΡΡΡΠ²ΡΠ΅Ρ ΠΎΠΏΡΡ Π°Π½ΠΈΠ΅ ΠΏΠΎ Π²ΡΠ΅ΠΌΡ Π²Π΅ΠΊΡ.
ΠΠ°ΠΈΠ±ΠΎΠ»Π΅Π΅ ΡΠ°ΡΠΏΡΠΎΡΡΡΠ°Π½Π΅Π½Π½ΠΎΠΉ ΠΏΡΠΈΡΠΈΠ½ΠΎΠΉ ΡΠ²Π»ΡΡΡΡΡ Π°Π΄Π΅Π½ΠΎΠ²ΠΈΡΡΡΡ. ΠΠ½ΠΈ ΠΎΡΠ΅Π½Ρ Π»Π΅Π³ΠΊΠΎ ΡΠ°ΡΠΏΡΠΎΡΡΡΠ°Π½ΡΡΡΡΡ ΡΡΠ΅Π΄ΠΈ ΠΏΠΎΠΏΡΠ»ΡΡΠΈΠΈ β ΡΠ΅ΡΠ΅Π· Π΄ΡΡ Π°ΡΠ΅Π»ΡΠ½ΡΠ΅ ΠΏΡΡΠΈ ΠΈΠ»ΠΈ Π²ΡΠ΄Π΅Π»Π΅Π½ΠΈΡ ΠΈΠ· Π³Π»Π°Π·, ΠΊΠΎΡΠΎΡΡΠ΅ ΠΌΠΎΠ³ΡΡ Π±ΡΡΡ ΠΏΠ΅ΡΠ΅Π΄Π°Π½Ρ, Π½Π°ΠΏΡΠΈΠΌΠ΅Ρ, ΡΠ΅ΡΠ΅Π· ΠΏΠΎΠ»ΠΎΡΠ΅Π½ΡΠ° ΠΈΠ»ΠΈ Π±Π»ΠΈΠ·ΠΊΠΈΠΉ ΡΠ΅Π»Π΅ΡΠ½ΡΠΉ ΠΊΠΎΠ½ΡΠ°ΠΊΡ. ΠΠ½ΡΠΈΡΠΈΡΠΎΠ²Π°Π½Π½ΡΠΉ ΡΠ΅Π»ΠΎΠ²Π΅ΠΊ ΠΌΠΎΠΆΠ΅Ρ ΠΏΠ΅ΡΠ΅Π΄Π°Π²Π°ΡΡ Π²ΠΈΡΡΡ Π΄ΡΡΠ³ΠΈΠΌ Π»ΡΠ΄ΡΠΌ Π² ΡΠ΅ΡΠ΅Π½ΠΈΠ΅ ΠΏΡΠΈΠ±Π»ΠΈΠ·ΠΈΡΠ΅Π»ΡΠ½ΠΎ 12 Π΄Π½Π΅ΠΉ. ΠΠΎΠ»Π΅Π·Π½Ρ ΠΌΠΎΠΆΠ΅Ρ ΠΏΡΠΎΠ΄ΠΎΠ»ΠΆΠ°ΡΡΡΡ Π½Π° ΠΏΡΠΎΡΡΠΆΠ΅Π½ΠΈΠΈ 6 Π½Π΅Π΄Π΅Π»Ρ. ΠΠ»Ρ ΡΡΠΎΠ³ΠΎ ΡΠΈΠΏΠ° Π²ΠΎΡΠΏΠ°Π»Π΅Π½ΠΈΡ Π½Π΅Ρ Π½ΠΈΠΊΠ°ΠΊΠΎΠ³ΠΎ ΡΠΏΠ΅ΡΠΈΡΠΈΡΠ΅ΡΠΊΠΎΠ³ΠΎ Π»Π΅ΡΠ΅Π½ΠΈΡ. ΠΡΡΠ°Π»ΡΠΌΠΎΠ»ΠΎΠ³ ΠΏΡΠΎΠ²ΠΎΠ΄ΠΈΡ ΠΏΠΎΠ»ΠΎΡΠΊΠ°Π½ΠΈΠ΅ ΠΊΠΎΠ½ΡΡΠ½ΠΊΡΠΈΠ²Π½ΠΎΠ³ΠΎ ΠΌΠ΅ΡΠΊΠ°.

ΠΠΎΠ»ΠΎΠΆΠΈΡΠ΅Π»ΡΠ½ΠΎΠ΅ Π΄Π΅ΠΉΡΡΠ²ΠΈΠ΅ ΠΎΠΊΠ°Π·ΡΠ²Π°ΡΡ ΠΊΠ°ΠΏΠ»ΠΈ Ρ ΠΏΡΠΎΡΠΈΠ²ΠΎΠ²ΠΎΡΠΏΠ°Π»ΠΈΡΠ΅Π»ΡΠ½ΡΠΌ ΡΡΡΠ΅ΠΊΡΠΎΠΌ. ΠΠΎΠΌΠ°Β ΠΌΠΎΠΆΠ½ΠΎ Π΄Π΅Π»Π°ΡΡ Ρ ΠΎΠ»ΠΎΠ΄Π½ΡΠ΅ ΠΊΠΎΠΌΠΏΡΠ΅ΡΡΡ Π΄Π»Ρ ΡΠΌΠ΅Π½ΡΡΠ΅Π½ΠΈΡ Π±ΠΎΠ»ΠΈ ΠΈ ΠΎΡΠ΅ΠΊΠ° Π²Π΅ΠΊΠ°.
Π£ΡΠΈΡΡΠ²Π°Ρ, ΡΡΠΎ Π°Π΄Π΅Π½ΠΎΠ²ΠΈΡΡΡΡ Π»Π΅Π³ΠΊΠΎ ΠΏΠ΅ΡΠ΅Π΄Π°ΡΡΡΡ, Π½Π΅ΠΎΠ±Ρ ΠΎΠ΄ΠΈΠΌΠΎ ΡΠΎΠ±Π»ΡΠ΄Π°ΡΡ ΠΎΠΏΡΠ΅Π΄Π΅Π»Π΅Π½Π½ΡΠ΅ ΠΏΡΠ°Π²ΠΈΠ»Π°. ΠΠ΅ ΡΠ»Π΅Π΄ΡΠ΅Ρ ΡΡΠΎΠ³Π°ΡΡ Π³Π»Π°Π·Π° ΠΏΠ°Π»ΡΡΠ°ΠΌΠΈ, Π½ΠΎ ΠΈΡΠΏΠΎΠ»ΡΠ·ΠΎΠ²Π°ΡΡ Π½ΠΎΡΠΎΠ²ΠΎΠΉ ΠΏΠ»Π°ΡΠΎΠΊ. Π ΡΠ»ΡΡΠ°Π΅ ΠΊΠΎΠ½ΡΠ°ΠΊΡΠ° ΡΡΠΊ Ρ Π³Π»Π°Π·Π°ΠΌΠΈ, Π½Π΅ΠΎΠ±Ρ ΠΎΠ΄ΠΈΠΌΠΎ Π²ΡΠΌΡΡΡ ΡΡΠΊΠΈ. ΠΠ»Ρ Π²ΡΡΠΈΡΠ°Π½ΠΈΡ ΡΠ΅Π»Π΅ΡΠΎΠΎΠ±ΡΠ°Π·Π½ΠΎ ΠΈΡΠΏΠΎΠ»ΡΠ·ΠΎΠ²Π°ΡΡ ΠΎΠ΄Π½ΠΎΡΠ°Π·ΠΎΠ²ΡΠ΅ ΠΏΠΎΠ»ΠΎΡΠ΅Π½ΡΠ°. ΠΠΎ Π²ΡΠ΅ΠΌΡ Π½Π°ΠΈΠ±ΠΎΠ»ΡΡΠ΅ΠΉ ΠΈΠ½ΡΠ΅ΠΊΡΠΈΠΎΠ½Π½ΠΎΠ³ΠΎ ΠΏΠ΅ΡΠΈΠΎΠ΄Π° Π½ΡΠΆΠ½ΠΎ ΠΈΠ·Π±Π΅Π³Π°ΡΡ ΡΠ΅ΡΠ½ΠΎΠ³ΠΎ ΠΊΠΎΠ½ΡΠ°ΠΊΡΠ° Ρ Π΄ΡΡΠ³ΠΈΠΌΠΈ Π»ΡΠ΄ΡΠΌΠΈ. Π ΡΡΠΎΡ ΠΌΠΎΠΌΠ΅Π½Ρ Π½Π΅Π»ΡΠ·Ρ Ρ ΠΎΠ΄ΠΈΡΡ Π² Π±Π°ΡΡΠ΅ΠΉΠ½, Π½Π΅ ΡΠΎΠ»ΡΠΊΠΎ ΠΈΠ·-Π·Π° ΡΠΈΡΠΊΠ° ΠΏΠ΅ΡΠ΅Π΄Π°ΡΠΈ ΠΈΠ½ΡΠ΅ΠΊΡΠΈΠΈ, Π½ΠΎ ΠΈ Π²Π²ΠΈΠ΄Ρ ΡΠΎΠ±ΡΡΠ²Π΅Π½Π½ΠΎΠ³ΠΎ Π»Π΅ΡΠ΅Π½ΠΈΡ.
ΠΠΎΠ½ΡΡΠ½ΠΊΡΠΈΠ²ΠΈΡ, Π²ΡΠ·Π²Π°Π½Π½ΡΠΉ Π²ΠΈΡΡΡΠΎΠΌ ΠΏΡΠΎΡΡΠΎΠ³ΠΎ Π³Π΅ΡΠΏΠ΅ΡΠ° (ΠΊΠ΅ΡΠ°ΡΠΎΠΊΠΎΠ½ΡΡΠ½ΠΊΡΠΈΠ²ΠΈΡ)
ΠΡΠΎ β ΡΠ°ΠΊΠΆΠ΅ Π²ΠΎΡΠΏΠ°Π»Π΅Π½ΠΈΠ΅ ΠΊΠΎΠ½ΡΡΠ½ΠΊΡΠΈΠ²Ρ, Π²ΡΠ·Π²Π°Π½Π½ΠΎΠ΅ Π²ΠΈΡΡΡΠ°ΠΌΠΈ. ΠΡΠΎΡ Π²ΠΈΡΡΡ ΠΎΠΏΠ°ΡΠ΅Π½ ΡΠ΅ΠΌ, ΡΡΠΎ ΠΎΠ½ ΠΌΠΎΠΆΠ΅Ρ ΡΠ°ΡΠΏΡΠΎΡΡΡΠ°Π½ΠΈΡΡΡΡ Π½Π° Π΄ΡΡΠ³ΠΈΠ΅ ΡΠ°ΡΡΠΈ Π³Π»Π°Π·Π°. ΠΠΎΠ»Π΅Π·Π½Ρ Π²ΠΎΠ·Π½ΠΈΠΊΠ°Π΅Ρ Π² ΠΎΡΠ½ΠΎΠ²Π½ΠΎΠΌ Ρ Π»ΡΠ΄Π΅ΠΉ, ΠΈΠΌΠ΅ΡΡΠΈΡ Π³Π΅ΡΠΏΠ΅ΡΠΈΡΠ΅ΡΠΊΠΈΠ΅ Π²ΡΡΡΠΏΠ°Π½ΠΈΡ Π½Π° Π³ΡΠ±Π°Ρ ΠΈΠ»ΠΈ Π² Π΄ΡΡΠ³ΠΎΠΌ ΠΌΠ΅ΡΡΠ΅ Π½Π° ΡΠ΅Π»Π΅.
ΠΡΠΈ ΡΡΠΎΠΉ ΠΈΠ½ΡΠ΅ΠΊΡΠΈΠΈ ΠΏΡΠΈΠΌΠ΅Π½ΡΠ΅ΡΡΡ ΡΠΏΠ΅ΡΠΈΡΠΈΡΠ΅ΡΠΊΠΎΠ΅ Π»Π΅ΡΠ΅Π½ΠΈΠ΅ Ρ ΠΈΡΠΏΠΎΠ»ΡΠ·ΠΎΠ²Π°Π½ΠΈΠ΅ΠΌ ΠΌΠ°Π·ΠΈ Ρ ΡΠΎΠ΄Π΅ΡΠΆΠ°Π½ΠΈΠ΅ΠΌ ΠΡΠΈΠΊΠ»ΠΎΠ²ΠΈΡΠ°, ΠΏΡΠ΅Π΄ΠΏΠΈΡΠ°Π½Π½ΠΎΠΉ Π²ΡΠ°ΡΠΎΠΌ.
ΠΡΠΎΡ ΡΠΈΠΏ Π·Π°Π±ΠΎΠ»Π΅Π²Π°Π½ΠΈΡ Ρ Π°ΡΠ°ΠΊΡΠ΅ΡΠ΅Π½ Π½Π΅Π±ΠΎΠ»ΡΡΠΈΠΌΠΈ Π²ΠΎΠ»Π΄ΡΡΡΠΌΠΈ Π½Π° ΠΏΠΎΠ²Π΅ΡΡ Π½ΠΎΡΡΠΈ Π³Π»Π°Π·Π°; ΠΏΡΠΈΡΡΡΡΡΠ²ΡΠ΅Ρ ΡΠΈΡΠΊ ΠΏΠΎΠ²ΡΠ΅ΠΆΠ΄Π΅Π½ΠΈΡ ΡΠΎΠ³ΠΎΠ²ΠΈΡΡ ΠΈ ΡΠ°ΡΡΠΈΡΠ½ΠΎΠΉ ΠΏΠΎΡΠ΅ΡΠΈ Π·ΡΠ΅Π½ΠΈΡ. ΠΠΎΡΡΠΎΠΌΡ ΠΊ Π±ΠΎΠ»Π΅Π·Π½ΠΈ ΡΠ»Π΅Π΄ΡΠ΅Ρ ΠΎΡΠ½Π΅ΡΡΠΈΡΡ ΠΌΠ°ΠΊΡΠΈΠΌΠ°Π»ΡΠ½ΠΎ ΡΠ΅ΡΡΠ΅Π·Π½ΠΎ, ΠΏΡΠΈ ΠΊΠ°ΠΆΠ΄ΠΎΠΌ ΠΏΠΎΡΠ²Π»Π΅Π½ΠΈΠΈ Π²Π΅Π·ΠΈΠΊΡΠ», Π² ΡΠΎΠΌ ΡΠΈΡΠ»Π΅ Π²Π½Π΅ Π³Π»Π°Π·Π°, ΠΏΡΠΎΡΠ²ΠΈΡΡ ΠΎΡΠΎΠ±ΡΡ ΠΎΡΡΠΎΡΠΎΠΆΠ½ΠΎΡΡΡ, ΠΆΠ΅Π»Π°ΡΠ΅Π»ΡΠ½ΠΎ ΠΏΠΎΡΠ΅ΡΠΈΡΡ Π²ΡΠ°ΡΠ°.
ΠΠ»Π»Π΅ΡΠ³ΠΈΡΠ΅ΡΠΊΠΈΠΉ ΠΊΠΎΠ½ΡΡΠ½ΠΊΡΠΈΠ²ΠΈΡ
ΠΠ²ΠΈΠ΄Ρ ΡΠ²ΠΎΠ΅Π³ΠΎ ΡΠ°ΡΠΏΠΎΠ»ΠΎΠΆΠ΅Π½ΠΈΡ, ΠΊΠΎΠ½ΡΡΠ½ΠΊΡΠΈΠ²Π° ΠΈ ΠΊΠΎΠ½ΡΡΠ½ΠΊΡΠΈΠ²Π½ΡΠΉ ΠΌΠ΅ΡΠΎΠΊ ΠΏΠΎΡΡΠΎΡΠ½Π½ΠΎ ΠΏΠΎΠ΄Π²Π΅ΡΠ³Π°ΡΡΡΡ Π²ΠΎΠ·Π΄Π΅ΠΉΡΡΠ²ΠΈΡ Π²Π½Π΅ΡΠ½Π΅ΠΉ ΡΡΠ΅Π΄Ρ. ΠΠ»Π»Π΅ΡΠ³ΠΈΡΠ΅ΡΠΊΠΈΠΉ ΠΊΠΎΠ½ΡΡΠ½ΠΊΡΠΈΠ²ΠΈΡ Ρ Π°ΡΠ°ΠΊΡΠ΅ΡΠΈΠ·ΡΠ΅ΡΡΡ Π·ΡΠ΄ΠΎΠΌ, ΠΆΠΆΠ΅Π½ΠΈΠ΅ΠΌ, Π»Π΅Π³ΠΊΠΈΠΌ ΠΏΠΎΠΊΡΠ°ΡΠ½Π΅Π½ΠΈΠ΅ΠΌ, Π·Π½Π°ΡΠΈΡΠ΅Π»ΡΠ½ΡΠΌ ΡΠ»Π΅Π·ΠΎΡΠ΅ΡΠ΅Π½ΠΈΠ΅ΠΌ, ΠΎΡΡΡΠ΅Π½ΠΈΠ΅ΠΌ ΠΈΠ½ΠΎΡΠΎΠ΄Π½ΠΎΠ³ΠΎ ΡΠ΅Π»Π° Π² Π³Π»Π°Π·Ρ ΠΈ Π½Π°Π±ΡΡ Π°Π½ΠΈΠ΅ΠΌ Π²Π΅ΠΊΠ°. ΠΠΎΠ»Π΅Π·Π½Ρ ΡΠ°ΡΡΠΎ ΡΠ²ΡΠ·Π°Π½Π° Ρ Π΄ΡΡΠ³ΠΈΠΌΠΈ Π·Π°Π±ΠΎΠ»Π΅Π²Π°Π½ΠΈΡΠΌΠΈ, ΠΎΡΠ½ΠΎΡΡΡΠΈΠΌΠΈΡΡ ΠΊ Π°Π»Π»Π΅ΡΠ³ΠΈΡΠ΅ΡΠΊΠΈΠΌ ΡΠ΅Π°ΠΊΡΠΈΡΠΌ, ΡΠ°ΠΊΠΈΠΌΠΈ, ΠΊΠ°ΠΊ ΡΠ΅Π½Π½Π°Ρ Π»ΠΈΡ ΠΎΡΠ°Π΄ΠΊΠ°, Π±ΡΠΎΠ½Ρ ΠΈΠ°Π»ΡΠ½Π°Ρ Π°ΡΡΠΌΠ° ΠΈΠ»ΠΈ Π΄Π°ΠΆΠ΅ ΡΠΊΠ·Π΅ΠΌΠ°.
ΠΠ»Π»Π΅ΡΠ³ΠΈΡΠ΅ΡΠΊΠΈΠΉ ΠΊΠΎΠ½ΡΡΠ½ΠΊΡΠΈΠ²ΠΈΡ ΠΌΠΎΠΆΠ΅Ρ Π²ΠΎΠ·Π½ΠΈΠΊΠ°ΡΡ ΡΠ΅Π·ΠΎΠ½Π½ΠΎ, ΠΊΠ°ΠΊ ΠΏΡΠ°Π²ΠΈΠ»ΠΎ, Π² Π²Π΅ΡΠ΅Π½Π½ΠΈΠ΅ ΠΈ Π»Π΅ΡΠ½ΠΈΠ΅ ΠΌΠ΅ΡΡΡΡ, ΠΎΠ±ΡΡΠ½ΠΎ, Π²ΡΠ·ΡΠ²Π°Π΅ΡΡΡ ΠΏΡΠ»ΡΡΠΎΠΉ. Π ΡΠ°ΠΊΠΆΠ΅ ΠΈΠ½ΠΎΠ³Π΄Π° ΠΏΡΠΈΡΡΡΡΡΠ²ΡΠ΅Ρ ΠΊΡΡΠ³Π»ΡΠΉ Π³ΠΎΠ΄; Π² ΡΠ°ΠΊΠΈΡ ΡΠ»ΡΡΠ°ΡΡ Π²ΠΎΠ·Π±ΡΠ΄ΠΈΡΠ΅Π»ΡΠΌΠΈ ΠΌΠΎΠ³ΡΡ Π±ΡΡΡ, Π½Π°ΠΏΡΠΈΠΌΠ΅Ρ, ΠΏΡΠ»Π΅Π²ΡΠ΅ ΠΊΠ»Π΅ΡΠΈ ΠΈΠ»ΠΈ Π΄Π°ΠΆΠ΅ ΡΠ΅ΡΡΡΡ Π΄ΠΎΠΌΠ°ΡΠ½ΠΈΡ ΠΆΠΈΠ²ΠΎΡΠ½ΡΡ .

ΠΡΠ΅Π³Π΄Π° Π½Π΅ΠΎΠ±Ρ ΠΎΠ΄ΠΈΠΌΠΎ Π² ΠΏΠ΅ΡΠ²ΡΡ ΠΎΡΠ΅ΡΠ΅Π΄Ρ ΠΎΠΏΡΠ΅Π΄Π΅Π»ΠΈΡΡ, ΡΡΠΎ ΠΈΠΌΠ΅Π½Π½ΠΎ Π²ΡΠ·ΡΠ²Π°Π΅Ρ ΠΏΡΠΎΠ±Π»Π΅ΠΌΡ. ΠΠ»Ρ ΡΡΠΎΠ³ΠΎ ΠΌΠΎΠΆΠ΅Ρ ΠΏΠΎΠ½Π°Π΄ΠΎΠ±ΠΈΡΡΡΡ ΡΠΎΡΡΡΠ΄Π½ΠΈΡΠ΅ΡΡΠ²ΠΎ ΠΎΡΡΠ°Π»ΡΠΌΠΎΠ»ΠΎΠ³Π° ΠΈ Π°Π»Π»Π΅ΡΠ³ΠΎΠ»ΠΎΠ³Π°, ΠΊΠΎΡΠΎΡΡΠ΅ Π²ΡΠΏΠΎΠ»Π½ΡΡ Π½Π΅ΠΎΠ±Ρ ΠΎΠ΄ΠΈΠΌΡΠ΅ ΡΠ΅ΡΡΡ Π΄Π»Ρ ΠΎΠΏΡΠ΅Π΄Π΅Π»Π΅Π½ΠΈΡ Π°Π»Π»Π΅ΡΠ³Π΅Π½Π°. ΠΠΎΡΠ»Π΅ Π΄ΠΈΠ°Π³Π½ΠΎΡΡΠΈΡΠΎΠ²Π°Π½ΠΈΡ ΠΏΡΠΈΡΠΈΠ½Ρ, Π²Π°ΠΆΠ½ΠΎ ΠΈΠ·Π±Π΅Π³Π°ΡΡ ΡΠ°Π·Π΄ΡΠ°ΠΆΠΈΡΠ΅Π»Ρ.
Π ΡΠ΅ΡΠ°ΠΏΠ΅Π²ΡΠΈΡΠ΅ΡΠΊΠΈΡ ΡΠ΅Π»ΡΡ ΠΈΡΠΏΠΎΠ»ΡΠ·ΡΡΡΡΡ Π°Π½ΡΠΈΠ³ΠΈΡΡΠ°ΠΌΠΈΠ½Π½ΡΠ΅ ΡΡΠ΅Π΄ΡΡΠ²Π°; ΠΎΠ½ΠΈ ΠΌΠΎΠ³ΡΡ ΠΏΡΠΈΠ½ΠΈΠΌΠ°ΡΡΡΡ ΠΊΠ°ΠΊ Π² Π²ΠΈΠ΄Π΅ ΡΠ°Π±Π»Π΅ΡΠΎΠΊ, ΡΠ°ΠΊ ΠΈ Π½Π΅ΠΏΠΎΡΡΠ΅Π΄ΡΡΠ²Π΅Π½Π½ΠΎ Π² Π³Π»Π°Π·.
ΠΠ°ΠΆΠ½ΠΎ! Π ΡΡΠΆΠ΅Π»ΡΡ ΡΠ»ΡΡΠ°ΡΡ , Π²ΠΎΠ·ΠΌΠΎΠΆΠ½ΠΎ Π»Π΅ΡΠ΅Π½ΠΈΠ΅ ΠΊΠΎΡΡΠΈΠΊΠΎΡΡΠ΅ΡΠΎΠΈΠ΄Π°ΠΌΠΈ, ΠΊΠΎΡΠΎΡΡΠ΅ ΠΎΡΠ΅Π½Ρ ΡΡΡΠ΅ΠΊΡΠΈΠ²Π½Ρ, Π½ΠΎ Π²ΠΌΠ΅ΡΡΠ΅ Ρ ΡΠ΅ΠΌ ΡΠ°ΠΊΠΆΠ΅ ΠΈΠΌΠ΅ΡΡ ΠΌΠ½ΠΎΠ³ΠΎ ΠΏΠΎΠ±ΠΎΡΠ½ΡΡ ΡΡΡΠ΅ΠΊΡΠΎΠ², ΡΠ°ΠΊΠΈΡ ΠΊΠ°ΠΊ ΡΠ°Π·Π²ΠΈΡΠΈΠ΅ Π³Π»Π°ΡΠΊΠΎΠΌΡ.
ΠΠΎΠ½ΡΡΠ½ΠΊΡΠΈΠ²ΠΈΡ, Π²ΡΠ·Π²Π°Π½Π½ΡΠΉ Π»Π΅ΠΊΠ°ΡΡΡΠ²Π΅Π½Π½ΡΠΌΠΈ ΡΡΠ΅Π΄ΡΡΠ²Π°ΠΌΠΈ
ΠΠΎΠ»Π΅Π·Π½Ρ ΠΊΠΎΠ½ΡΡΠ½ΠΊΡΠΈΠ²ΠΈΡ ΡΠ°ΠΊΠΆΠ΅ ΠΌΠΎΠΆΠ΅Ρ Π²ΠΎΠ·Π½ΠΈΠΊΠ½ΡΡΡ Π²ΡΠ»Π΅Π΄ΡΡΠ²ΠΈΠ΅ Π²ΠΎΠ·Π΄Π΅ΠΉΡΡΠ²ΠΈΡ Π»Π΅ΠΊΠ°ΡΡΡΠ²Π΅Π½Π½ΡΡ ΠΏΡΠ΅ΠΏΠ°ΡΠ°ΡΠΎΠ². ΠΠ΅Π΄ΠΈΠΊΠ°ΠΌΠ΅Π½ΡΡ ΠΌΠΎΠ³ΡΡ Π²ΠΊΠ»ΡΡΠ°ΡΡ Π² ΡΠ΅Π±Ρ Π½Π΅ΠΊΠΎΡΠΎΡΡΠ΅ Π°Π½ΡΠΈΠ±ΠΈΠΎΡΠΈΠΊΠΈ, ΠΏΡΠΈΠΌΠ΅Π½ΡΠ΅ΠΌΡΠ΅ Π² Π³Π»Π°Π·Π°, ΠΈΠ»ΠΈ Π΄Π°ΠΆΠ΅ ΠΊΠ°ΠΏΠ»ΠΈ Π΄Π»Ρ ΡΠ½ΠΈΠΆΠ΅Π½ΠΈΡ Π²Π½ΡΡΡΠΈΠ³Π»Π°Π·Π½ΠΎΠ³ΠΎ Π΄Π°Π²Π»Π΅Π½ΠΈΡ. Π ΡΠ°ΠΊΠΈΡ ΡΠ»ΡΡΠ°ΡΡ Π½Π΅ΠΎΠ±Ρ ΠΎΠ΄ΠΈΠΌΠΎ ΠΎΠ±ΡΠ°ΡΠΈΡΡΡΡ ΠΊ Π²ΡΠ°ΡΡ ΠΈ ΠΈΠ·ΠΌΠ΅Π½ΠΈΡΡ Π»Π΅ΡΠ΅Π½ΠΈΠ΅.
ΠΠΈΠ³Π°Π½ΡΠΎΠΏΠ°ΠΏΠΈΠ»Π»ΡΡΠ½ΡΠΉ ΠΊΠΎΠ½ΡΡΠ½ΠΊΡΠΈΠ²ΠΈΡ
ΠΡΠΎ ΠΎΡΠΎΠ±ΡΠΉ ΡΠΈΠΏ Π²ΠΎΡΠΏΠ°Π»Π΅Π½ΠΈΡ ΠΊΠΎΠ½ΡΡΠ½ΠΊΡΠΈΠ²Ρ, Π²ΠΎΠ·Π½ΠΈΠΊΠ°ΡΡΠΈΠΉ Ρ Π»ΡΠ΄Π΅ΠΉ, ΠΊΠΎΡΠΎΡΡΠ΅ Π½ΠΎΡΡΡ ΠΊΠΎΠ½ΡΠ°ΠΊΡΠ½ΡΠ΅ Π»ΠΈΠ½Π·Ρ. Π‘ΡΠΈΡΠ°Π΅ΡΡΡ, ΡΡΠΎ Ρ ΡΡΠΈΡ Π»ΠΈΡ ΠΏΡΠΈΡΡΡΡΡΠ²ΡΠ΅Ρ ΡΠΈΡΠΊ ΡΠ°ΡΠ°ΠΏΠΈΠ½ ΠΏΠΎΠ²Π΅ΡΡ Π½ΠΎΡΡΠΈ Π³Π»Π°Π·Π°; Π²ΠΎΠ·Π½ΠΈΠΊΠ½ΠΎΠ²Π΅Π½ΠΈΡ Π·Π°Π±ΠΎΠ»Π΅Π²Π°Π½ΠΈΡ ΠΌΠΎΠΆΠ΅Ρ ΡΠ°ΠΊΠΆΠ΅ ΡΠΏΠΎΡΠΎΠ±ΡΡΠ²ΠΎΠ²Π°ΡΡ Π°Π»Π»Π΅ΡΠ³ΠΈΡ Π½Π° ΠΌΠ°ΡΠ΅ΡΠΈΠ°Π», ΠΈΠ· ΠΊΠΎΡΠΎΡΠΎΠ³ΠΎ Π»ΠΈΠ½Π·Π° ΠΈΠ·Π³ΠΎΡΠΎΠ²Π»Π΅Π½Π°, ΠΈ Π·Π°Π³ΡΡΠ·Π½Π΅Π½ΠΈΡ, ΠΎΡΠ΅Π΄Π°ΡΡΠΈΠ΅ Π½Π° Π»ΠΈΠ½Π·Π΅ ΠΏΡΠΈ Π½ΠΎΡΠ΅Π½ΠΈΠΈ. ΠΠ°ΠΊ ΠΏΡΠ°Π²ΠΈΠ»ΠΎ, Π±ΠΎΠ»Π΅Π·Π½Ρ ΠΏΠΎΡΠ²Π»ΡΠ΅ΡΡΡ ΡΠ΅ΡΠ΅Π· Π½Π΅ΡΠΊΠΎΠ»ΡΠΊΠΎ ΠΌΠ΅ΡΡΡΠ΅Π² ΠΈΠ»ΠΈ Π»Π΅Ρ Π½ΠΎΡΠ΅Π½ΠΈΡ Π»ΠΈΠ½Π·. Π₯Π°ΡΠ°ΠΊΡΠ΅ΡΠ½ΡΠ΅ ΡΠΈΠΌΠΏΡΠΎΠΌΡ Π²ΠΎΠ·Π½ΠΈΠΊΠ°ΡΡ Π² ΠΎΡΠ½ΠΎΠ²Π½ΠΎΠΌ ΠΏΠΎΡΠ»Π΅ ΠΈΡ ΡΠ½ΡΡΠΈΡ, Π³Π»Π°Π·Π° ΠΊΡΠ°ΡΠ½Π΅ΡΡ ΠΈ Π·ΡΠ΄ΡΡ. Π£ΡΡΠΎΠΌ Π³Π»Π°Π·Π° ΠΊΠ°ΠΆΡΡΡΡ ΡΠΊΠ»Π΅Π΅Π½Π½ΡΠΌΠΈ ΡΠ»ΠΈΠ·ΡΡ. Π§Π°ΡΡΠΎ Π²ΠΎΠ·Π½ΠΈΠΊΠ°Π΅Ρ Π»Π΅Π³ΠΊΠ°Ρ ΡΠ²Π΅ΡΠΎΠ±ΠΎΡΠ·Π½Ρ.

ΠΡΠ΅Π³Π΄Π° Π½Π΅ΠΎΠ±Ρ ΠΎΠ΄ΠΈΠΌΠΎ ΠΏΠΎΡΠ΅ΡΠΈΡΡ ΠΎΡΡΠ°Π»ΡΠΌΠΎΠ»ΠΎΠ³Π°, ΠΊΠΎΡΠΎΡΡΠΉ Π²Π²Π΅Π΄Π΅Ρ Π»Π΅ΠΊΠ°ΡΡΡΠ²Π΅Π½Π½ΡΠΉ ΠΏΡΠ΅ΠΏΠ°ΡΠ°Ρ Π΄Π»Ρ ΠΎΠ±Π»Π΅Π³ΡΠ΅Π½ΠΈΡ ΠΏΡΠΎΡΠ²Π»Π΅Π½ΠΈΠΉ Π·Π°Π±ΠΎΠ»Π΅Π²Π°Π½ΠΈΡ, Π° ΡΠ°ΠΊΠΆΠ΅ ΠΎΠΏΡΠ΅Π΄Π΅Π»ΠΈΡ, ΠΌΠΎΠΆΠ½ΠΎ Π»ΠΈ ΠΏΡΠΎΠ΄ΠΎΠ»ΠΆΠ°ΡΡ Π½ΠΎΡΠΈΡΡ ΠΊΠΎΠ½ΡΠ°ΠΊΡΠ½ΡΠ΅ Π»ΠΈΠ½Π·Ρ ΠΈ, ΠΊΠ°ΠΊΠΈΠ΅ ΠΈΠΌΠ΅Π½Π½ΠΎ. Π Π΅Π΄ΠΊΠΎ ΡΠ°ΠΊΠΈΠ΅ ΠΏΡΠΎΠ±Π»Π΅ΠΌΡ Π²ΠΎΠ·Π½ΠΈΠΊΠ°ΡΡ ΠΏΡΠΈ ΠΈΡΠΏΠΎΠ»ΡΠ·ΠΎΠ²Π°Π½ΠΈΠΈ Π»ΠΈΠ½Π· Ρ Ρ ΠΎΡΠΎΡΠ΅ΠΉ Π²ΠΎΠ·Π΄ΡΡ ΠΎΠΏΡΠΎΠ½ΠΈΡΠ°Π΅ΠΌΠΎΡΡΡΡ. ΠΠ΄Π½Π°ΠΊΠΎ, Π΄Π°ΠΆΠ΅ Π² ΡΡΠΎΠΌ ΡΠ»ΡΡΠ°Π΅, ΠΈΡ ΠΈΡΠΏΠΎΠ»ΡΠ·ΠΎΠ²Π°Π½ΠΈΠ΅ Π΄ΠΎΠ»ΠΆΠ½ΠΎ Π±ΡΡΡ ΠΎΠ³ΡΠ°Π½ΠΈΡΠ΅Π½ΠΎ.
ΠΡΠΎΠΏΠΈΡΠ΅ΡΠΊΠΈΠΉ ΠΊΠΎΠ½ΡΡΠ½ΠΊΡΠΈΠ²ΠΈΡ
ΠΡΠΎΡ ΡΠΈΠΏ Π²ΠΎΡΠΏΠ°Π»Π΅Π½ΠΈΡ Ρ Π°ΡΠ°ΠΊΡΠ΅ΡΠ΅Π½ Π΄Π»Ρ Π»ΡΠ΄Π΅ΠΉ, ΡΡΡΠ°Π΄Π°ΡΡΠΈΡ Π°ΡΠΎΠΏΠΈΡΠ΅ΡΠΊΠΎΠΉ ΡΠΊΠ·Π΅ΠΌΠΎΠΉ. Π‘ ΠΏΡΠΎΡΠ²Π»Π΅Π½ΠΈΠ΅ΠΌ Π±ΠΎΠ»Π΅Π·Π½ΠΈ Π½Π° ΠΊΠΎΠΆΠ΅ ΠΏΡΠΎΠΈΡΡ ΠΎΠ΄ΠΈΡ ΠΈ Π°ΡΠΎΠΏΠΈΡΠ΅ΡΠΊΠΎΠ΅ Π·Π°Π±ΠΎΠ»Π΅Π²Π°Π½ΠΈΠ΅ ΠΊΠΎΠ½ΡΡΠ½ΠΊΡΠΈΠ²Ρ. ΠΡΠΎ Π΄ΠΎΠ»Π³ΠΎΡΡΠΎΡΠ½Π°Ρ Π±ΠΎΠ»Π΅Π·Π½Ρ, ΠΏΡΠΎΡΠ²Π»ΡΡΡΠ°ΡΡΡ ΡΡΠΎΠ»ΡΠ΅Π½ΠΈΠ΅ΠΌ Π²Π΅ΠΊ, ΠΊΠΎΡΠΎΡΡΠ΅ ΠΏΡΠΈΠΎΠ±ΡΠ΅ΡΠ°ΡΡ ΡΠ΅ΠΌΠ½ΠΎ-ΡΠΈΠΎΠ»Π΅ΡΠΎΠ²ΡΠΉ ΠΎΡΡΠ΅Π½ΠΎΠΊ, ΡΠ°ΡΡΠΎ β Ρ ΡΡΠ΅ΡΠΈΠ½ΠΊΠ°ΠΌΠΈ. ΠΠΏΠ°ΡΠ½ΠΎΡΡΡ, Π³Π»Π°Π²Π½ΡΠΌ ΠΎΠ±ΡΠ°Π·ΠΎΠΌ, Π·Π°ΠΊΠ»ΡΡΠ°Π΅ΡΡΡ Π² ΡΠΈΡΠΊΠ΅ ΡΠΎΡΠΌΠΈΡΠΎΠ²Π°Π½ΠΈΡ ΡΡΠ°ΠΌΠΎΠ². ΠΠΎΡΠΏΠ°Π»Π΅Π½ΠΈΠ΅ ΠΌΠΎΠΆΠ΅Ρ ΡΠ°ΠΊΠΆΠ΅ ΡΠ°ΡΠΏΡΠΎΡΡΡΠ°Π½ΡΡΡΡΡ Π½Π° ΡΠΎΠ³ΠΎΠ²ΠΈΡΡ, ΡΡΠΎ ΠΎΡΠ΅Π½Ρ ΠΎΠΏΠ°ΡΠ½ΠΎ, ΠΏΠΎΡΠΊΠΎΠ»ΡΠΊΡ Π² ΡΡΠΆΠ΅Π»ΡΡ ΡΠ»ΡΡΠ°ΡΡ ΠΌΠΎΠΆΠ΅Ρ Π΄ΠΎΠΉΡΠΈ ΠΊ ΠΏΠΎΠ»Π½ΠΎΠΉ ΠΏΠΎΡΠ΅ΡΠ΅ Π·ΡΠ΅Π½ΠΈΡ.
ΠΠΊΡΠΏΠΎΠ·ΠΈΡΠΈΠΎΠ½Π½ΡΠΉ ΠΊΠΎΠ½ΡΡΠ½ΠΊΡΠΈΠ²ΠΈΡ
Π Π΄Π°Π½Π½ΠΎΠΌ ΡΠ»ΡΡΠ°Π΅ ΡΠ΅ΡΡ Π½Π΅ ΠΈΠ΄Π΅Ρ ΠΎΠ± ΠΈΠ½ΡΠ΅ΠΊΡΠΈΠΎΠ½Π½ΠΎΠΌ Π²ΠΎΡΠΏΠ°Π»Π΅Π½ΠΈΠΈ ΠΊΠΎΠ½ΡΡΠ½ΠΊΡΠΈΠ²Ρ. ΠΠ½ΠΎ Π½Π΅ Π²ΡΠ·ΡΠ²Π°Π΅ΡΡΡ Π½ΠΈΠΊΠ°ΠΊΠΈΠΌΠΈ ΠΌΠΈΠΊΡΠΎΠΎΡΠ³Π°Π½ΠΈΠ·ΠΌΠ°ΠΌΠΈ. ΠΡΠΎ β ΡΠ°ΡΠΏΡΠΎΡΡΡΠ°Π½Π΅Π½Π½ΠΎΠ΅ Π·Π°Π±ΠΎΠ»Π΅Π²Π°Π½ΠΈΠ΅, ΠΏΡΠΈ ΠΊΠΎΡΠΎΡΠΎΠΌ ΠΊΠΎΠ½ΡΡΠ½ΠΊΡΠΈΠ²Π° ΡΠ°Π·Π΄ΡΠ°ΠΆΠ°Π΅ΡΡΡ Π² ΡΠ»Π΅Π΄ΡΡΠ²ΠΈΠΈ Π²ΠΎΠ·Π΄Π΅ΠΉΡΡΠ²ΠΈΡ ΡΠ°Π·Π»ΠΈΡΠ½ΡΡ ΡΠΈΠ·ΠΈΡΠ΅ΡΠΊΠΈΡ ΠΈ Ρ ΠΈΠΌΠΈΡΠ΅ΡΠΊΠΈΡ Π°Π³Π΅Π½ΡΠΎΠ². Π§Π°ΡΡΠΎ β ΡΡΠΎ ΠΏΡΠ»Ρ, ΡΠ°Π·Π»ΠΈΡΠ½ΡΠ΅ Ρ ΠΈΠΌΠΈΡΠ΅ΡΠΊΠΈΠ΅ Π²Π΅ΡΠ΅ΡΡΠ²Π° (ΡΠ°ΡΡΠ²ΠΎΡΠΈΡΠ΅Π»ΠΈ, ΠΊΠΈΡΠ»ΠΎΡΡ). ΠΠΊΡΠΏΠΎΠ·ΠΈΡΠΈΠΎΠ½Π½ΡΠΉ ΠΊΠΎΠ½ΡΡΠ½ΠΊΡΠΈΠ²ΠΈΡ ΠΈΠ½ΠΎΠ³Π΄Π° Π²ΠΎΠ·Π½ΠΈΠΊΠ°Π΅Ρ ΡΠ°ΠΊΠΆΠ΅ ΠΏΡΠΈ Π²ΠΎΠ·Π΄Π΅ΠΉΡΡΠ²ΠΈΠΈ Ρ ΠΎΠ»ΠΎΠ΄Π½ΠΎΠΉ, Π²Π΅ΡΡΠ΅Π½ΠΎΠΉ ΠΏΠΎΠ³ΠΎΠ΄Ρ ΠΈΠ»ΠΈ Π² Π³ΠΎΡΠ°Ρ , Π³Π΄Π΅ Π³Π»Π°Π· ΡΠ°Π·Π΄ΡΠ°ΠΆΠ°Π΅Ρ ΡΠΈΠ»ΡΠ½ΠΎΠ΅ ΠΎΡΡΠ°ΠΆΠ΅Π½ΠΈΠ΅ ΡΠΎΠ»Π½Π΅ΡΠ½ΡΡ Π»ΡΡΠ΅ΠΉ ΠΎΡ ΡΠ½Π΅Π³Π°. ΠΡΠΎΠΌΠ΅ ΡΠΎΠ³ΠΎ, Π·Π°Π±ΠΎΠ»Π΅Π²Π°Π½ΠΈΠ΅ ΠΌΠΎΠΆΠ΅Ρ ΡΠ°ΠΊΠΆΠ΅ Π²ΠΎΠ·Π½ΠΈΠΊΠ½ΡΡΡ Π² ΡΠ΅Π·ΡΠ»ΡΡΠ°ΡΠ΅ ΠΏΠΎΠΏΠ°Π΄Π°Π½ΠΈΡ ΡΠ°ΡΡΠΈΡΠ΅ΠΊ ΠΌΠ°ΠΊΠΈΡΠΆΠ° Π² Π³Π»Π°Π·. ΠΠ΅ΠΊΠΎΡΠΎΡΡΠ΅ Ρ ΡΠΎΠ½ΠΈΡΠ΅ΡΠΊΠΈΠ΅, Π΄Π»ΠΈΡΠ΅Π»ΡΠ½ΡΠ΅ Π²ΠΎΡΠΏΠ°Π»Π΅Π½ΠΈΡ ΠΌΠΎΠ³ΡΡ Π²ΠΎΠ·Π½ΠΈΠΊΠ½ΡΡΡ ΠΏΡΠΈ ΠΈΡΠΏΠΎΠ»ΡΠ·ΠΎΠ²Π°Π½ΠΈΠΈ ΡΠΈΠ»ΡΠ½ΡΡ ΠΎΡΡΠ°Π»ΡΠΌΠΎΠ»ΠΎΠ³ΠΈΡΠ΅ΡΠΊΠΈΡ ΠΊΠ°ΠΏΠ΅Π»Ρ Π΄ΠΎΠ»ΡΡΠ΅, ΡΠ΅ΠΌ ΡΠΊΠ°Π·Π°Π½ΠΎ Π»Π΅ΡΠ°ΡΠΈΠΌ Π²ΡΠ°ΡΠΎΠΌ.
ΠΠ΅ΡΠ΅Π½ΠΈΠ΅, ΠΏΡΠ΅ΠΆΠ΄Π΅ Π²ΡΠ΅Π³ΠΎ, ΠΏΡΠ΅Π΄ΠΏΠΎΠ»Π°Π³Π°Π΅Ρ ΡΡΡΡΠ°Π½Π΅Π½ΠΈΠ΅ ΠΏΡΠΈΡΠΈΠ½Ρ. ΠΡΠ»ΠΈ Π² ΠΊΠΎΠ½ΡΡΠ½ΠΊΡΠΈΠ²Π½ΡΠΉ ΠΌΠ΅ΡΠΎΠΊ ΠΏΡΠΎΠ½ΠΈΠΊΠ»ΠΎ Π·Π°Π³ΡΡΠ·Π½Π΅Π½ΠΈΠ΅ ΠΈΠ»ΠΈ ΠΈΠ½ΠΎΡΠΎΠ΄Π½ΠΎΠ΅ ΡΠ΅Π»ΠΎ, Π½Π΅ΠΎΠ±Ρ ΠΎΠ΄ΠΈΠΌΠΎ ΡΠ΄Π°Π»ΠΈΡΡ Π΅Π³ΠΎ ΠΈ ΠΏΡΠΎΠΌΡΡΡ. ΠΡΠΎΠΌΠ΅ ΡΠΎΠ³ΠΎ, ΡΠ΅Π»Π΅ΡΠΎΠΎΠ±ΡΠ°Π·Π½ΠΎ ΠΈΡΠΏΠΎΠ»ΡΠ·ΠΎΠ²Π°ΡΡ Π³Π»Π°Π·Π½ΡΠ΅ ΠΊΠ°ΠΏΠ»ΠΈ, Π΄ΠΎΡΡΡΠΏΠ½ΡΠ΅ Π±Π΅Π· ΡΠ΅ΡΠ΅ΠΏΡΠ° Π² Π°ΠΏΡΠ΅ΠΊΠ°Ρ . ΠΡΠΎΡ ΡΠΈΠΏ Π²ΠΎΡΠΏΠ°Π»Π΅Π½ΠΈΡ Π΄ΠΎΠ»ΠΆΠ΅Π½ ΠΈΠ·Π»Π΅ΡΠΈΡΡΡΡ ΠΎΡΠ½ΠΎΡΠΈΡΠ΅Π»ΡΠ½ΠΎ Π±ΡΡΡΡΠΎ. ΠΡΠ»ΠΈ Π²ΠΎΡΠΏΠ°Π»Π΅Π½ΠΈΠ΅ ΡΠΎΡ ΡΠ°Π½ΡΠ΅ΡΡΡ, Π½Π΅ΠΎΠ±Ρ ΠΎΠ΄ΠΈΠΌΠΎ ΠΎΠ±ΡΠ°ΡΠΈΡΡΡΡ ΠΊ Π²ΡΠ°ΡΡ. ΠΡΠ½ΠΎΠ²Π½ΡΡ ΠΏΡΠΈΡΠΈΠ½ ΡΡΠΎΠ³ΠΎ ΡΠΈΠΏΠ° Π·Π°Π±ΠΎΠ»Π΅Π²Π°Π½ΠΈΡ ΠΌΠ½ΠΎΠ³ΠΎ. ΠΠΎΡΡΠΎΠΌΡ, Π²Π°ΠΆΠ½ΠΎ ΠΎΠΏΡΠ΅Π΄Π΅Π»ΠΈΡΡ Π²ΠΎΠ·Π±ΡΠ΄ΠΈΡΠ΅Π»Ρ Π±ΠΎΠ»Π΅Π·Π½Ρ ΠΈ ΠΏΠΎΡΡΠ°ΡΠ°ΡΡΡΡ ΠΈΠ·Π±Π΅Π³Π°ΡΡ Π΅Π³ΠΎ. ΠΠ΅Π»Π°ΡΠ΅Π»ΡΠ½ΠΎ Π½Π΅ ΠΏΡΠ΅Π±ΡΠ²Π°ΡΡ Π΄ΠΎΠ»Π³ΠΎ Π² ΠΏΡΠ»ΡΠ½ΠΎΠΉ ΠΈ Π²Π΅ΡΡΠ΅Π½ΠΎΠΉ ΠΎΠΊΡΡΠΆΠ°ΡΡΠ΅ΠΉ ΡΡΠ΅Π΄Π΅. ΠΡΠΎΠΌΠ΅ ΡΠΎΠ³ΠΎ, ΡΠ»Π΅Π΄ΡΠ΅Ρ Π·Π°ΡΠΈΡΠ°ΡΡ Π³Π»Π°Π·Π° ΠΎΡ ΡΠΎΠ»Π½ΡΠ° ΠΏΡΠΈ ΠΏΠΎΠΌΠΎΡΠΈ ΠΎΡΠΊΠΎΠ² Ρ Π΄ΠΎΡΡΠ°ΡΠΎΡΠ½ΡΠΌ Π·Π°ΡΠΈΡΠ½ΡΠΌ ΡΠ°ΠΊΡΠΎΡΠΎΠΌ, ΠΎΡΠΎΠ±Π΅Π½Π½ΠΎ, Π²ΠΎ Π²ΡΠ΅ΠΌΡ ΠΏΡΠ΅Π±ΡΠ²Π°Π½ΠΈΡ Π½Π° Π±ΠΎΠ»ΡΡΠΈΡ Π²ΡΡΠΎΡΠ°Ρ .
ΠΠ°ΠΊΡΠ΅ΡΠΈΠ°Π»ΡΠ½ΡΠΉ ΠΊΠΎΠ½ΡΡΠ½ΠΊΡΠΈΠ²ΠΈΡ
ΠΠ΅ΡΠΌΠΎΡΡΡ Π½Π° ΡΠΎ, ΡΡΠΎ ΠΊΠΎΠ½ΡΡΠ½ΠΊΡΠΈΠ²Π° ΠΏΠΎΡΡΠΎΡΠ½Π½ΠΎ ΠΏΠΎΠ΄Π²Π΅ΡΠ³Π°Π΅ΡΡΡ Π²ΠΎΠ·Π΄Π΅ΠΉΡΡΠ²ΠΈΡ ΡΠ°Π·Π»ΠΈΡΠ½ΡΡ ΠΌΠΈΠΊΡΠΎΠΎΡΠ³Π°Π½ΠΈΠ·ΠΌΠΎΠ², Π±Π°ΠΊΡΠ΅ΡΠΈΠ°Π»ΡΠ½ΡΠ΅ ΠΊΠΎΠ½ΡΡΠ½ΠΊΡΠΈΠ²ΠΈΡΡΒ ΡΠΎΡΡΠ°Π²Π»ΡΡΡ Π»ΠΈΡΡ ΠΎΠΊΠΎΠ»ΠΎ 5-10% Π²ΡΠ΅Ρ ΡΠ»ΡΡΠ°Π΅Π² Π·Π°Π±ΠΎΠ»Π΅Π²Π°Π½ΠΈΡ. ΠΠΎ ΠΊΡΡΡΡ ΠΎΠ½ΠΈ Π΄Π΅Π»ΡΡΡΡ Π½Π° ΠΎΡΡΡΡΡ ΡΠΎΡΠΌΡ (Π±ΡΡΡΡΠΎΠ΅ Π½Π°ΡΠ°Π»ΠΎ) ΠΈ Ρ ΡΠΎΠ½ΠΈΡΠ΅ΡΠΊΡΡ (Ρ. Π΅. ΠΏΡΠΎΠ΄ΠΎΠ»ΠΆΠ°ΡΡΡΡΡΡ Π² Π΄ΠΎΠ»Π³ΠΎΡΡΠΎΡΠ½ΠΎΠΉ ΠΏΠ΅ΡΡΠΏΠ΅ΠΊΡΠΈΠ²Π΅).
ΠΡΠΎΡΠ²Π»Π΅Π½ΠΈΡ Π±Π°ΠΊΡΠ΅ΡΠΈΠ°Π»ΡΠ½ΠΎΠ³ΠΎ ΠΊΠΎΠ½ΡΡΠ½ΠΊΡΠΈΠ²ΠΈΡΠ°, ΠΎΠ±ΡΡΠ½ΠΎ, Π½Π°ΡΠΈΠ½Π°ΡΡΡΡ Ρ ΠΏΠΎΠΊΡΠ°ΡΠ½Π΅Π½ΠΈΡ Π³Π»Π°Π· ΠΈ ΠΎΠΏΡΡ Π°Π½ΠΈΡ Π²Π΅ΠΊ. Π’ΠΈΠΏΠΈΡΠ½Ρ Π³Π½ΠΎΠΉΠ½ΡΠ΅ Π²ΡΠ΄Π΅Π»Π΅Π½ΠΈΡ. ΠΠ°ΠΊ ΠΏΡΠ°Π²ΠΈΠ»ΠΎ, Π²ΠΎΡΠΏΠ°Π»Π΅Π½ΠΈΠ΅ ΡΠ°ΡΠΏΡΠΎΡΡΡΠ°Π½ΡΠ΅ΡΡΡ Π½Π° Π²ΡΠΎΡΠΎΠΉ Π³Π»Π°Π·. ΠΡΠΎ ΠΏΠΎΡΠ΅Π½ΡΠΈΠ°Π»ΡΠ½ΠΎ ΠΎΠΏΠ°ΡΠ½ΠΎΠ΅ Π·Π°Π±ΠΎΠ»Π΅Π²Π°Π½ΠΈΠ΅, ΠΏΠΎΡΠΊΠΎΠ»ΡΠΊΡ ΠΎΠ½ΠΎ ΠΌΠΎΠΆΠ΅Ρ ΡΠ°ΡΠΏΡΠΎΡΡΡΠ°Π½ΠΈΡΡΡΡ Π΄Π°Π»ΡΡΠ΅ ΠΈ ΠΏΡΠΈΠ²Π΅ΡΡΠΈ ΠΊ ΠΏΠΎΠ²ΡΠ΅ΠΆΠ΄Π΅Π½ΠΈΡ Π±ΠΎΠ»Π΅Π΅ Π³Π»ΡΠ±ΠΎΠΊΠΈΡ Π³Π»Π°Π·Π½ΡΡ ΡΡΡΡΠΊΡΡΡ. Π§Π°ΡΡΠΎ ΡΠ°ΠΊΠΆΠ΅ ΠΏΡΠΎΠΈΡΡ ΠΎΠ΄ΠΈΡ ΠΎΠΏΡΡ Π°Π½ΠΈΠ΅ Π»ΠΈΠΌΡΠΎΡΠ·Π»ΠΎΠ² Π² ΠΎΠ±Π»Π°ΡΡΠΈ ΡΠ΅ΠΈ ΠΈ Π»ΠΈΡΠ°.
ΠΠ°ΠΈΠ±ΠΎΠ»Π΅Π΅ ΡΠ°ΡΠΏΡΠΎΡΡΡΠ°Π½Π΅Π½Π½ΡΠΌΠΈ ΠΏΡΠΈΡΠΈΠ½Π°ΠΌΠΈ Π±Π°ΠΊΡΠ΅ΡΠΈΠ°Π»ΡΠ½ΠΎΠΉ ΡΠΎΡΠΌΡ Π·Π°Π±ΠΎΠ»Π΅Π²Π°Π½ΠΈΡ ΡΠ²Π»ΡΡΡΡΡ ΠΏΠ½Π΅Π²ΠΌΠΎΠΊΠΎΠΊΠΊΠΈ, ΡΡΠ°ΡΠΈΠ»ΠΎΠΊΠΎΠΊΠΊΠΈ ΠΈ ΡΡΡΠ΅ΠΏΡΠΎΠΊΠΎΠΊΠΊΠΈ.
ΠΡΠΈ ΠΎΡΡΡΠΎΠΌ Π±Π°ΠΊΡΠ΅ΡΠΈΠ°Π»ΡΠ½ΠΎΠΌ ΠΊΠΎΠ½ΡΡΠ½ΠΊΡΠΈΠ²ΠΈΡΠ΅ ΠΏΡΠΎΠ±Π»Π΅ΠΌΡ Π²ΠΎΠ·Π½ΠΈΠΊΠ°ΡΡ Π²Π½Π΅Π·Π°ΠΏΠ½ΠΎ, ΠΎΠ±ΡΡΠ½ΠΎ, ΡΡΡΠΎΠΌ ΠΏΠΎΡΠ»Π΅ ΠΏΡΠΎΠ±ΡΠΆΠ΄Π΅Π½ΠΈΡ β Π³Π»Π°Π·Π° Π±ΠΎΠ»ΡΡ, Π²Π΅ΠΊΠΈ ΡΠΊΠ»Π΅ΠΈΠ²Π°ΡΡΡΡ Π³Π½ΠΎΠΉΠ½ΡΠΌΠΈ Π²ΡΠ΄Π΅Π»Π΅Π½ΠΈΡΠΌΠΈ. ΠΡΠ΄ΠΈ ΡΠ°ΠΊΠΆΠ΅ ΠΎΠΏΠΈΡΡΠ²Π°ΡΡ ΠΆΠΆΠ΅Π½ΠΈΠ΅ ΠΈ ΡΠ°Π·Π΄ΡΠ°ΠΆΠ΅Π½ΠΈΠ΅.
ΠΠ°ΠΆΠ½ΠΎ Π·Π½Π°ΡΡ! ΠΡΠΈ Ρ ΡΠΎΠ½ΠΈΡΠ΅ΡΠΊΠΎΠΌ, Π΄Π»ΠΈΡΠ΅Π»ΡΠ½ΠΎΠΌ Π²ΠΎΡΠΏΠ°Π»Π΅Π½ΠΈΠΈ ΡΠΈΠΌΠΏΡΠΎΠΌΡ Π½Π΅ ΡΡΠΎΠ»Ρ Π²ΡΡΠ°ΠΆΠ΅Π½Ρ. Π§Π°ΡΡΠΎ ΠΎΠ½ΠΈ ΡΠ²ΡΠ·Π°Π½Ρ Ρ Π·Π°ΠΊΡΠΏΠΎΡΠΊΠΎΠΉ ΡΠ»Π΅Π·Π½ΠΎΠ³ΠΎ ΠΏΡΠΎΡΠΎΠΊΠ° ΠΈΠ»ΠΈ Π΄Π΅ΡΠ΅ΠΊΡΠΎΠΌ Π²Π΅ΠΊΠ°, Π½Π°ΠΏΡΠΈΠΌΠ΅Ρ, ΠΊΠΎΠ³Π΄Π° Π½ΠΈΠΆΠ½Π΅Π΅ Π²Π΅ΠΊΠΎ Π½Π΅ΠΏΠ»ΠΎΡΠ½ΠΎ ΠΏΡΠΈΠ»Π΅Π³Π°Π΅Ρ ΠΊ Π³Π»Π°Π·Ρ.
ΠΠΎΡΠΏΠ°Π»Π΅Π½ΠΈΠ΅, ΠΎΠ±ΡΡΠ½ΠΎ, ΠΏΡΠΎΡ ΠΎΠ΄ΠΈΡ ΡΠ°ΠΌΠΎΡΡΠΎΡΡΠ΅Π»ΡΠ½ΠΎ, Π½ΠΎ Π΄Π»Ρ ΡΡΠΊΠΎΡΠ΅Π½ΠΈΡ ΠΏΡΠΎΡΠ΅ΡΡΠ° Π·Π°ΠΆΠΈΠ²Π»Π΅Π½ΠΈΡ Π² Π°ΠΏΡΠ΅ΠΊΠ΅ ΠΌΠΎΠΆΠ½ΠΎ ΠΏΡΠΈΠΎΠ±ΡΠ΅ΡΡΠΈ Π΄Π΅Π·ΠΈΠ½ΡΠΈΡΠΈΡΡΡΡΠΈΠ΅ ΠΊΠ°ΠΏΠ»ΠΈ. ΠΡΠΈ Π±ΠΎΠ»Π΅Π΅ ΡΡΠΆΠ΅Π»ΡΡ Π·Π°Π±ΠΎΠ»Π΅Π²Π°Π½ΠΈΡΡ ΠΏΡΠΈΡΡΡΡΡΠ²ΡΠ΅Ρ Π½Π΅ΠΎΠ±Ρ ΠΎΠ΄ΠΈΠΌΠΎΡΡΡ Π² Π°Π½ΡΠΈΠ±Π°ΠΊΡΠ΅ΡΠΈΠ°Π»ΡΠ½ΠΎΠΉ ΡΠ΅ΡΠ°ΠΏΠΈΠΈ Π² Π²ΠΈΠ΄Π΅ ΠΊΠ°ΠΏΠ΅Π»Ρ ΠΈΠ»ΠΈ ΡΠ°Π±Π»Π΅ΡΠΎΠΊ.

Π₯Π»Π°ΠΌΠΈΠ΄ΠΈΠΉΠ½ΡΠΉ ΠΊΠΎΠ½ΡΡΠ½ΠΊΡΠΈΠ²ΠΈΡ
Π ΡΡΠΈΠΎΠ»ΠΎΠ³ΠΈΠΈ Ρ Π»Π°ΠΌΠΈΠ΄ΠΈΠΉΠ½ΠΎΠ³ΠΎ Π²ΠΎΡΠΏΠ°Π»Π΅Π½ΠΈΡ ΠΊΠΎΠ½ΡΡΠ½ΠΊΡΠΈΠ²Ρ ΡΠΎΠ»Ρ Π²ΠΎΠ·Π±ΡΠ΄ΠΈΡΠ΅Π»Ρ ΠΈΠ³ΡΠ°ΡΡ ΠΌΠΈΠΊΡΠΎΠΎΡΠ³Π°Π½ΠΈΠ·ΠΌΡ β Ρ Π»Π°ΠΌΠΈΠ΄ΠΈΠΈ, ΡΠ²Π»ΡΡΡΠΈΠ΅ΡΡ Π½Π°ΠΈΠ±ΠΎΠ»Π΅Π΅ ΡΠ°ΡΠΏΡΠΎΡΡΡΠ°Π½Π΅Π½Π½ΠΎΠΉ ΠΏΡΠΈΡΠΈΠ½ΠΎΠΉ ΠΊΠΎΠ½ΡΡΠ½ΠΊΡΠΈΠ²ΠΈΡΠ° Ρ Π½ΠΎΠ²ΠΎΡΠΎΠΆΠ΄Π΅Π½Π½ΡΡ . ΠΠΎΠ²Π°ΡΡΡΠ²ΠΎ Π·Π°Π±ΠΎΠ»Π΅Π²Π°Π½ΠΈΡ Π·Π°ΠΊΠ»ΡΡΠ°Π΅ΡΡΡ Π² ΡΠΎΠΌ, ΡΡΠΎ ΠΎΠ½ΠΎ, ΠΊΠ°ΠΊ ΠΏΡΠ°Π²ΠΈΠ»ΠΎ, ΠΏΠΎΠ·Π΄Π½ΠΎ Π΄ΠΈΠ°Π³Π½ΠΎΡΡΠΈΡΡΠ΅ΡΡΡ ΠΈ Π½Π΅ ΡΠ΅Π°Π³ΠΈΡΡΠ΅Ρ Π½Π° Π»Π΅ΡΠ΅Π½ΠΈΠ΅ Π°Π½ΡΠΈΠ±ΠΈΠΎΡΠΈΠΊΠ°ΠΌΠΈ. ΠΠΎΠ»Π΅Π·Π½Ρ ΠΌΠΎΠΆΠ΅Ρ ΠΏΡΠΈΡΠΈΠ½ΡΡΡ ΡΠ΅Π»ΠΎΠ²Π΅ΠΊΡ Π΄ΠΈΡΠΊΠΎΠΌΡΠΎΡΡ Π² ΡΠ΅ΡΠ΅Π½ΠΈΠ΅ Π½Π΅ΡΠΊΠΎΠ»ΡΠΊΠΈΡ ΠΌΠ΅ΡΡΡΠ΅Π². Π‘ΠΈΠΌΠΏΡΠΎΠΌΡ ΡΡ ΠΎΠΆΠΈ Ρ Π΄ΡΡΠ³ΠΈΠΌΠΈ ΡΠΈΠΏΠ°ΠΌΠΈ Π±Π°ΠΊΡΠ΅ΡΠΈΠ°Π»ΡΠ½ΠΎΠ³ΠΎ Π²ΠΎΡΠΏΠ°Π»Π΅Π½ΠΈΡ, ΠΈ ΠΏΡΠ΅Π΄ΡΡΠ°Π²Π»Π΅Π½Ρ ΡΠ°ΠΊΠΈΠΌΠΈ ΠΏΡΠΈΠ·Π½Π°ΠΊΠ°ΠΌΠΈ, ΠΊΠ°ΠΊ Π±ΠΎΠ»Ρ, ΠΏΠΎΠΊΡΠ°ΡΠ½Π΅Π½ΠΈΠ΅, Π³Π½ΠΎΠΉΠ½ΡΠ΅ Π²ΡΠ΄Π΅Π»Π΅Π½ΠΈΡ ΠΈ ΠΎΠΏΡΡ Π°Π½ΠΈΠ΅ ΠΆΠ΅Π»Π΅Π·.
Π₯Π»Π°ΠΌΠΈΠ΄ΠΈΠΈ ΡΠ°ΠΊΠΆΠ΅ Π²ΡΠ·ΡΠ²Π°ΡΡ Π³Π΅Π½ΠΈΡΠ°Π»ΡΠ½ΡΠ΅ ΠΈΠ½ΡΠ΅ΠΊΡΠΈΠΈ, ΠΏΠΎΡΡΠΎΠΌΡ Π·Π°Π±ΠΎΠ»Π΅Π²Π°Π½ΠΈΠ΅ ΡΠ°ΡΡΠΎ Π²ΡΡΡΠ΅ΡΠ°Π΅ΡΡΡ Ρ Π΄Π΅ΡΠ΅ΠΉ, ΠΊΠΎΡΠΎΡΡΠ΅ Π·Π°ΡΠ°Π·ΠΈΠ»ΠΈΡΡ Π²ΠΎ Π²ΡΠ΅ΠΌΡ ΡΠΎΠ΄ΠΎΠ², Π° ΡΠ°ΠΊΠΆΠ΅ Ρ ΠΌΠΎΠ»ΠΎΠ΄ΡΡ ΡΠ΅ΠΊΡΡΠ°Π»ΡΠ½ΠΎ Π°ΠΊΡΠΈΠ²Π½ΡΡ Π»ΡΠ΄Π΅ΠΉ. ΠΠ½ΡΠ΅ΠΊΡΠΈΡ ΠΌΠΎΠΆΠ΅Ρ ΠΏΠ΅ΡΠ΅Π΄Π°Π²Π°ΡΡΡΡ ΠΎΡ ΠΈΠ½ΡΠΈΡΠΈΡΠΎΠ²Π°Π½Π½ΡΡ Π»ΠΈΡ, Π½Π΅ ΠΈΠΌΠ΅ΡΡΠΈΡ ΡΠΈΠΏΠΈΡΠ½ΡΡ ΡΠΈΠΌΠΏΡΠΎΠΌΠΎΠ².
ΠΠ°ΠΆΠ½ΠΎ! ΠΡΠΈ Π΄ΠΈΠ°Π³Π½ΠΎΡΡΠΈΡΠΎΠ²Π°Π½ΠΈΠΈ Ρ Π»Π°ΠΌΠΈΠ΄ΠΈΠΉΠ½ΠΎΠ³ΠΎ Π²ΠΎΡΠΏΠ°Π»Π΅Π½ΠΈΡ ΠΊΠΎΠ½ΡΡΠ½ΠΊΡΠΈΠ²ΡΒ ΡΠ΅Π»Π΅ΡΠΎΠΎΠ±ΡΠ°Π·Π½ΠΎ Π»Π΅ΡΠ΅Π½ΠΈΠ΅ ΡΠ°ΠΊΠΆΠ΅ Π³Π΅Π½ΠΈΡΠ°Π»ΡΠ½ΠΎΠΉ ΠΈΠ½ΡΠ΅ΠΊΡΠΈΠΈ, Π° ΡΠ°ΠΊΠΆΠ΅ ΡΠ΅ΠΊΡΡΠ°Π»ΡΠ½ΠΎΠ³ΠΎ ΠΏΠ°ΡΡΠ½Π΅ΡΠ°.
ΠΠΎΠ½ΡΡΠ½ΠΊΡΠΈΠ²ΠΈΡ Ρ Π΄Π΅ΡΠ΅ΠΉ
ΠΠ°Π±ΠΎΠ»Π΅Π²Π°Π½ΠΈΠ΅ Ρ Π΄Π΅ΡΠ΅ΠΉ ΠΌΠΎΠΆΠ΅Ρ ΠΏΡΠΎΠΈΡΡ
ΠΎΠ΄ΠΈΡΡ ΡΠΆΠ΅ Π²ΠΎ Π²ΡΠ΅ΠΌΡ ΡΠΎΠ΄ΠΎΠ², ΠΊΠ°ΠΊ ΠΎΠΏΠΈΡΠ°Π½ΠΎ Π²ΡΡΠ΅. ΠΠΎ ΡΠ°ΡΡΠΎ Π²ΠΎΠ·Π½ΠΈΠΊΠ°Π΅Ρ ΠΏΠΎΠ·ΠΆΠ΅ Π² ΠΏΠ΅ΡΠ²ΡΠ΅ ΠΌΠ΅ΡΡΡΡ ΠΆΠΈΠ·Π½ΠΈ ΠΌΠ°Π»ΡΡΠ°. Π£ Π½ΠΎΠ²ΠΎΡΠΎΠΆΠ΄Π΅Π½Π½ΡΡ
Π½Π΅ ΠΏΠΎΠ»Π½ΠΎΡΡΡΡ ΡΠ°Π·Π²ΠΈΡΡ ΡΠ»Π΅Π·Π½ΡΠ΅ ΠΏΡΠΎΡΠΎΠΊΠΈ, ΡΠ°Π·Π²ΠΈΡΠΈΠ΅ ΠΊΠΎΡΠΎΡΡΡ
ΠΏΡΠΎΠ΄ΠΎΠ»ΠΆΠ°Π΅ΡΡΡ Π² ΡΠ΅ΡΠ΅Π½ΠΈΠ΅ 3 ΠΌΠ΅ΡΡΡΠ΅Π². ΠΠΌΠ΅Π½Π½ΠΎ ΡΠΎΡ ΡΠ°ΠΊΡ, ΡΡΠΎ ΠΊΠΎΠ½ΡΡΠ½ΠΊΡΠΈΠ²Π½ΡΠΉ ΠΌΠ΅ΡΠΎΠΊ Π½Π΅ ΠΎΡΠΈΡΠ°Π΅ΡΡΡ Π΄ΠΎΠ»ΠΆΠ½ΡΠΌ ΠΎΠ±ΡΠ°Π·ΠΎΠΌ, ΡΠΎΠ·Π΄Π°Π΅ΡΡΡ ΡΡΠ΅Π΄Π°, ΡΡΠ²ΡΡΠ²ΠΈΡΠ΅Π»ΡΠ½Π°Ρ ΠΊ ΡΠ°Π·Π»ΠΈΡΠ½ΡΠΌ ΠΈΠ½ΡΠ΅ΠΊΡΠΈΡΠΌ; ΡΡΠΎ ΠΈ ΡΠ²Π»ΡΠ΅ΡΡΡ ΡΠ°ΡΡΠΎΠΉ ΠΏΡΠΈΡΠΈΠ½ΠΎΠΉ ΡΠ΅ΡΠΈΠ΄ΠΈΠ²Π½ΡΡ
ΠΈΠ½ΡΠ΅ΠΊΡΠΈΠΉ ΠΊΠΎΠ½ΡΡΠ½ΠΊΡΠΈΠ²Ρ. Π ΡΠ°ΠΊΠΈΡ
ΡΠ»ΡΡΠ°ΡΡ
ΠΎΡΠ΄Π°Π΅ΡΡΡ ΠΏΡΠ΅Π΄ΠΏΠΎΡΡΠ΅Π½ΠΈΠ΅ ΠΌΠ΅ΡΡΠ½ΠΎΠΌΡ Π»Π΅ΡΠ΅Π½ΠΈΡ ΠΏΡΠΈ ΠΏΠΎΠΌΠΎΡΠΈ ΠΊΠ°ΠΏΠ΅Π»Ρ, Π² Π·Π°Π²ΠΈΡΠΈΠΌΠΎΡΡΠΈ ΠΎΡ ΡΠΈΠΏΠ° ΠΈΠ½ΡΠ΅ΠΊΡΠΈΠΈ.
ΠΠΈΠ°Π³Π½ΠΎΡΡΠΈΠΊΠ°
ΠΠ²ΠΈΠ΄Ρ ΡΡΠ΄Π° ΠΏΡΠΈΡΠΈΠ½ Π·Π°Π±ΠΎΠ»Π΅Π²Π°Π½ΠΈΡ, ΡΠ°ΡΡΠΎ Π΅Π³ΠΎ Π±ΡΠ²Π°Π΅Ρ ΠΎΡΠ΅Π½Ρ ΡΡΡΠ΄Π½ΠΎ Π΄ΠΈΠ°Π³Π½ΠΎΡΡΠΈΡΠΎΠ²Π°ΡΡ. ΠΡΠ»ΠΈ ΠΈΠΌΠ΅Π΅Ρ ΠΌΠ΅ΡΡΠΎ Π»ΠΈΡΡ Π»Π΅Π³ΠΊΠΎΠ΅ Π²ΠΎΡΠΏΠ°Π»Π΅Π½ΠΈΠ΅, ΠΎ Π²ΠΎΠ·Π±ΡΠ΄ΠΈΡΠ΅Π»Π΅, Π²ΡΠ·Π²Π°Π²ΡΠ΅ΠΌ Π±ΠΎΠ»Π΅Π·Π½Ρ, ΠΌΠΎΠΆΠ½ΠΎ ΡΠΎΠ»ΡΠΊΠΎ Π΄ΠΎΠ³Π°Π΄ΡΠ²Π°ΡΡΡΡ. ΠΡΠ»ΠΈ Π²ΡΠ°Ρ ΠΏΠΎΠ΄ΠΎΠ·ΡΠ΅Π²Π°Π΅Ρ Π±ΠΎΠ»Π΅Π΅ ΡΠ΅ΡΡΠ΅Π·Π½ΡΡ ΠΏΡΠΈΡΠΈΠ½Ρ (Π±Π°ΠΊΡΠ΅ΡΠΈΠ°Π»ΡΠ½ΠΎΠ΅ Π²ΠΎΡΠΏΠ°Π»Π΅Π½ΠΈΠ΅, Π²ΠΈΡΡΡ Π³Π΅ΡΠΏΠ΅ΡΠ°), ΠΏΡΠΎΠ²ΠΎΠ΄ΠΈΡΡΡ ΡΡΠ°ΡΠ΅Π»ΡΠ½ΠΎΠ΅ ΠΎΡΡΠ°Π»ΡΠΌΠΎΠ»ΠΎΠ³ΠΈΡΠ΅ΡΠΊΠΎΠ΅ ΠΎΠ±ΡΠ»Π΅Π΄ΠΎΠ²Π°Π½ΠΈΠ΅. ΠΠ»Π°Π· ΠΎΡΠΌΠ°ΡΡΠΈΠ²Π°Π΅ΡΡΡ ΡΠ½Π°ΡΡΠΆΠΈ, ΠΏΡΠΎΠ²Π΅ΡΡΠ΅ΡΡΡ ΡΠ΅Π°ΠΊΡΠΈΡ Π·ΡΠ°ΡΠΊΠ° ΠΈ ΠΊΠ°ΡΠ΅ΡΡΠ²ΠΎ Π·ΡΠ΅Π½ΠΈΡ. Π ΡΠ»ΡΡΠ°Π΅ Π³Π½ΠΎΠΉΠ½ΡΡ Π²ΡΠ΄Π΅Π»Π΅Π½ΠΈΠΉ, ΠΎΡΠ±ΠΈΡΠ°Π΅ΡΡΡ ΠΎΠ±ΡΠ°Π·Π΅Ρ Π΄Π»Ρ ΠΌΠΈΠΊΡΠΎΠ±ΠΈΠΎΠ»ΠΎΠ³ΠΈΡΠ΅ΡΠΊΠΎΠ³ΠΎ ΠΈΡΡΠ»Π΅Π΄ΠΎΠ²Π°Π½ΠΈΡ (ΡΠ΅ΡΡ Π½Π° ΠΏΡΠΈΡΡΡΡΡΠ²ΠΈΠ΅ Π±Π°ΠΊΡΠ΅ΡΠΈΠΉ). ΠΡΠΈΡΠΈΠ½Π° ΠΌΠΎΠΆΠ΅Ρ Π±ΡΡΡ ΠΎΠΏΡΠ΅Π΄Π΅Π»Π΅Π½Π° ΠΏΡΠΈ ΡΠΎΡΡΠ°Π²Π»Π΅Π½ΠΈΠΈ Π°Π½Π°ΠΌΠ½Π΅Π·Π°, Π½ΠΎΡΠ΅Π½ΠΈΠ΅ ΠΊΠΎΠ½ΡΠ°ΠΊΡΠ½ΡΡ Π»ΠΈΠ½Π·, ΡΡΠ°Π²ΠΌΡ Π³Π»Π°Π· ΠΈ ΠΈΠ½ΡΠ΅ΠΊΡΠΈΡ Π³Π΅ΡΠΏΠ΅ΡΠ°.
ΠΠΎΡΠ»Π΅Π΄ΡΡΠ²ΠΈΡ
ΠΠΎΠ»ΡΡΠΈΠ½ΡΡΠ²ΠΎ ΡΠΎΡΠΌ ΠΊΠΎΠ½ΡΡΠ½ΠΊΡΠΈΠ²ΠΈΡΠ° ΠΏΠΎΡΠ»Π΅ ΡΡΡΡΠ°Π½Π΅Π½ΠΈΡ ΠΏΡΠΈΡΠΈΠ½Ρ Π² ΡΠ΅ΡΠ΅Π½ΠΈΠ΅ Π½Π΅ΡΠΊΠΎΠ»ΡΠΊΠΈΡ Π΄Π½Π΅ΠΉ ΠΈΠ»ΠΈ Π½Π΅Π΄Π΅Π»Ρ ΠΏΡΠΎΡ ΠΎΠ΄ΡΡ ΡΠ°ΠΌΠΎΡΡΠΎΡΡΠ΅Π»ΡΠ½ΠΎ.
ΠΡΠΈΡΠΈΡΠ΅ΡΠΊΠΈΠΌ ΡΠ²Π»ΡΠ΅ΡΡΡ Π·Π°Π±ΠΎΠ»Π΅Π²Π°Π½ΠΈΠ΅ Ρ Π½ΠΎΠ²ΠΎΡΠΎΠΆΠ΄Π΅Π½Π½ΡΡ . ΠΡΠΈ Π³ΠΎΠ½ΠΎΠΊΠΎΠΊΠΊΠΎΠ²ΠΎΠΉ ΠΈΠ½ΡΠ΅ΠΊΡΠΈΠΈ, ΠΎΡΠ΅Π½Ρ ΡΠ΅Π΄ΠΊΠΎΠΉ Π² Π½Π°ΡΠ΅ Π²ΡΠ΅ΠΌΡ, Π±Π΅Π· Π»Π΅ΡΠ΅Π½ΠΈΡ ΠΌΠΎΠΆΠ΅Ρ Π±ΡΡΡ ΠΏΠΎΡΠ΅ΡΡΠ½ΠΎ Π·ΡΠ΅Π½ΠΈΠ΅ Π½ΠΎΠ²ΠΎΡΠΎΠΆΠ΄Π΅Π½Π½ΠΎΠ³ΠΎ.
ΠΠ°ΠΆΠ½ΠΎ! ΠΠΎΠ½ΡΡΠ½ΠΊΡΠΈΠ²ΠΈΡ, Π²ΡΠ·Π²Π°Π½Π½ΡΠΉ Ρ Π»Π°ΠΌΠΈΠ΄ΠΈΠ΅ΠΉ, Ρ Π°ΡΠ°ΠΊΡΠ΅ΡΠ΅Π½ ΠΎΡΠ΅Π½Ρ ΠΌΠ΅Π΄Π»Π΅Π½Π½ΡΠΌ ΠΏΡΠΎΠ³ΡΠ΅ΡΡΠΎΠΌ. Π ΡΠ»ΡΡΠ°Π΅ ΠΎΡΡΡΡΡΡΠ²ΠΈΡ Π»Π΅ΡΠ΅Π½ΠΈΡ, ΠΌΠΎΠ³ΡΡ Π²ΠΎΠ·Π½ΠΈΠΊΠ½ΡΡΡ Π΄Π»ΠΈΡΠ΅Π»ΡΠ½ΡΠ΅ ΠΏΠΎΡΠ»Π΅Π΄ΡΡΠ²ΠΈΡ Π½Π° ΡΠΎΠ³ΠΎΠ²ΠΈΡΠ΅ ΠΈ Π²Π½ΡΡΡΠ΅Π½Π½Π΅ΠΉ ΡΡΠΎΡΠΎΠ½Π΅ Π²Π΅ΡΡ Π½Π΅Π³ΠΎ Π²Π΅ΠΊΠ°.
ΠΠΈΠ°Π³Π½ΠΎΡΡΠΈΠΊΠ° ΠΊΠΎΠ½ΡΡΠ½ΠΊΡΠΈΠ²ΠΈΡΠ°, ΠΎΡΠ½ΠΎΠ²Π°Π½Π½Π°Ρ Π»ΠΈΡΡ Π½Π° ΠΏΠΎΠΊΡΠ°ΡΠ½Π΅Π½ΠΈΠΈ Π³Π»Π°Π·, ΠΌΠΎΠΆΠ΅Ρ Π±ΡΡΡ ΠΎΡΠΈΠ±ΠΎΡΠ½ΠΎΠΉ: ΠΎΡΠ½ΠΎΠ²Π½ΠΎΠΉ ΠΏΡΠΈΡΠΈΠ½ΠΎΠΉ ΠΌΠΎΠ³ΡΡ Π±ΡΡΡ Π²ΠΎΡΠΏΠ°Π»Π΅Π½ΠΈΡ Π΄ΡΡΠ³ΠΈΡ ΡΠ°ΡΡΠ΅ΠΉ Π³Π»Π°Π· (ΡΠ°Π΄ΡΠΆΠ½ΠΎΠΉ ΠΎΠ±ΠΎΠ»ΠΎΡΠΊΠΈ, ΡΠΎΠ³ΠΎΠ²ΠΈΡΡ, Π³Π»Π°Π·Π½ΡΡ ΠΌΡΡΡ, Π²Π΅ΠΊ ΠΈ Ρ. Π΄.). ΠΠΎΠΊΡΠ°ΡΠ½Π΅Π½ΠΈΠ΅ Π²ΠΎΠ·Π½ΠΈΠΊΠ°Π΅Ρ ΡΠ°ΠΊΠΆΠ΅ Π²ΡΠ»Π΅Π΄ΡΡΠ²ΠΈΠ΅ ΡΡΠ°Π²ΠΌΡ ΡΠΎΠ³ΠΎΠ²ΠΈΡΡ.
Π ΡΠ»ΡΡΠ°Π΅ ΠΎΡΡΡΠΎΠ³ΠΎ Π½Π°ΡΠ°Π»Π° Π³Π»Π°ΡΠΊΠΎΠΌΡ, Π²ΡΠ»Π΅Π΄ΡΡΠ²ΠΈΠ΅ Π²Π½Π΅Π·Π°ΠΏΠ½ΠΎΠ³ΠΎ ΡΠ²Π΅Π»ΠΈΡΠ΅Π½ΠΈΡ Π΄Π°Π²Π»Π΅Π½ΠΈΡ Π²Π½ΡΡΡΠΈ Π³Π»Π°Π·Π°, Π²ΠΎΠ·Π½ΠΈΠΊΠ°Π΅Ρ ΠΏΠΎΠΊΡΠ°ΡΠ½Π΅Π½ΠΈΠ΅, ΡΠΎΠΏΡΠΎΠ²ΠΎΠΆΠ΄Π°ΡΡΠ΅Π΅ΡΡ Π±ΠΎΠ»ΡΡ, Π½Π°ΡΡΡΠ΅Π½ΠΈΠ΅ΠΌ Π·ΡΠ΅Π½ΠΈΡ, ΡΠΎΡΠ½ΠΎΡΠΎΠΉ ΠΈ ΡΠ²ΠΎΡΠΎΠΉ. ΠΡΠΈΠ±ΠΎΡΠ½ΡΠΉ Π΄ΠΈΠ°Π³Π½ΠΎΠ· ΠΌΠΎΠΆΠ΅Ρ Π±ΡΡΡ ΡΠ°ΡΠ°Π»ΡΠ½ΡΠΌ: ΠΏΡΠΈ ΠΎΡΡΡΡΡΡΠ²ΠΈΠΈ ΡΡΠΎΡΠ½ΡΡ ΡΠ΅ΡΠ°ΠΏΠ΅Π²ΡΠΈΡΠ΅ΡΠΊΠΈΡ ΠΌΠ΅Ρ, Π² ΡΠ΅ΡΠ΅Π½ΠΈΠ΅ Π½Π΅ΡΠΊΠΎΠ»ΡΠΊΠΈΡ ΡΠ°ΡΠΎΠ² ΠΌΠΎΠΆΠ΅Ρ ΡΠ°Π·Π²ΠΈΡΡΡΡ ΡΠ»Π΅ΠΏΠΎΡΠ°.
ΠΡΠΎΡΠΈΠ»Π°ΠΊΡΠΈΠΊΠ°
ΠΡΡΡΠ΅ΠΉ Π·Π°ΡΠΈΡΠΎΠΉ ΠΎΡ ΠΈΠ½ΡΠ΅ΠΊΡΠΈΠΎΠ½Π½ΠΎΠ³ΠΎ ΠΊΠΎΠ½ΡΡΠ½ΠΊΡΠΈΠ²ΠΈΡΠ°Β ΡΠ²Π»ΡΠ΅ΡΡΡ ΡΡΠ°ΡΠ΅Π»ΡΠ½Π°Ρ Π³ΠΈΠ³ΠΈΠ΅Π½Π°. ΠΠ²ΠΈΠ΄Ρ Π²ΡΡΠΎΠΊΠΎΠ³ΠΎ ΡΠΈΡΠΊΠ° Π·Π°ΡΠ°ΠΆΠ΅Π½ΠΈΡ, Π²ΡΠ·Π²Π°Π½Π½ΠΎΠ³ΠΎ Π°Π΄Π΅Π½ΠΎΠ²ΠΈΡΡΡΠ°ΠΌΠΈ, Π±ΠΎΠ»ΡΠ½ΠΎΠΉ Π½Π΅ ΠΌΠΎΠΆΠ΅Ρ ΠΏΠΎΡΠ΅ΡΠ°ΡΡ Π΄Π΅ΡΡΠΊΠΈΠΉ ΡΠ°Π΄/ΡΠΊΠΎΠ»Ρ Π΄ΠΎ ΡΠ΅Ρ ΠΏΠΎΡ, ΠΏΠΎΠΊΠ° ΡΡΠΎ Π½Π΅ ΠΏΠΎΠ·Π²ΠΎΠ»ΠΈΡ Π»Π΅ΡΠ°ΡΠΈΠΉ Π²ΡΠ°Ρ.

ΠΠ΅ΠΊΠ°ΡΡΡΠ²Π΅Π½Π½ΡΠΉ ΠΏΡΠ΅ΠΏΠ°ΡΠ°Ρ, ΠΏΡΠ΅Π΄ΠΏΠΈΡΠ°Π½Π½ΡΠΉ ΡΠΏΠ΅ΡΠΈΠ°Π»ΠΈΡΡΠΎΠΌ, Π½Π΅ ΡΠ»Π΅Π΄ΡΠ΅Ρ ΠΈΡΠΏΠΎΠ»ΡΠ·ΠΎΠ²Π°ΡΡ Π² ΠΊΠΎΠΌΠ±ΠΈΠ½Π°ΡΠΈΠΈ Ρ Π΄ΡΡΠ³ΠΈΠΌ ΡΠ°ΡΠΌΠ°ΡΠ΅Π²ΡΠΈΡΠ΅ΡΠΊΠΈΠΌ ΡΡΠ΅Π΄ΡΡΠ²ΠΎΠΌ. ΠΠ»Π°Π·Π½ΡΠ΅ ΠΊΠ°ΠΏΠ»ΠΈ ΠΈ ΠΌΠ°Π·ΠΈ Π½Π΅ ΠΌΠΎΠ³ΡΡ ΠΈΡΠΏΠΎΠ»ΡΠ·ΠΎΠ²Π°ΡΡΡΡ Π² ΡΠ΅ΡΠ΅Π½ΠΈΠ΅ Π±ΠΎΠ»Π΅Π΅ ΠΏΡΠΎΠ΄ΠΎΠ»ΠΆΠΈΡΠ΅Π»ΡΠ½ΠΎΠ³ΠΎ Π²ΡΠ΅ΠΌΠ΅Π½ΠΈ, ΡΠ΅ΠΌ Π±ΡΠ»ΠΎ ΠΏΡΠ΅Π΄ΠΏΠΈΡΠ°Π½ΠΎ.
ΠΡΠΈ Π°Π»Π»Π΅ΡΠ³ΠΈΡΠ΅ΡΠΊΠΎΠΌ Π²ΠΎΡΠΏΠ°Π»Π΅Π½ΠΈΠΈ ΠΏΡΠ΅Π²Π΅Π½ΡΠΈΡ Π·Π°ΠΊΠ»ΡΡΠ°Π΅ΡΡΡ Π² ΠΈΠ·Π±Π΅Π³Π°Π½ΠΈΠΈ ΠΊΠΎΠ½ΡΠ°ΠΊΡΠ° Ρ ΡΠ°Π·Π΄ΡΠ°ΠΆΠΈΡΠ΅Π»Π΅ΠΌ (Π½Π°ΠΏΡΠΈΠΌΠ΅Ρ, Π²ΠΎΠ΄ΠΈΡΠ΅Π»Ρ ΠΌΠΎΠΆΠ΅Ρ ΠΈΠ·Π±Π΅ΠΆΠ°ΡΡ ΠΊΠΎΠ½ΡΡΠ½ΠΊΡΠΈΠ²ΠΈΡΠ°, ΠΎΠ±ΡΠ°ΡΠ°Ρ Π²Π½ΠΈΠΌΠ°Π½ΠΈΠ΅ Π½Π° ΡΠΎ, ΡΡΠΎΠ±Ρ Π΅Π³ΠΎ Π³ΠΎΠ»ΠΎΠ²Π° Π½Π΅ Π½Π°Ρ ΠΎΠ΄ΠΈΠ»Π°ΡΡ Π½Π΅ΠΏΠΎΡΡΠ΅Π΄ΡΡΠ²Π΅Π½Π½ΠΎ Π² ΠΏΠΎΡΠΎΠΊΠ΅ Π²ΠΎΠ·Π΄ΡΡ Π° ΠΈΠ· ΠΎΠΊΠ½Π° Π°Π²ΡΠΎΠΌΠΎΠ±ΠΈΠ»Ρ).
ΠΡΠ΄ΠΈ, ΠΊΠΎΡΠΎΡΡΠ΅ Π½ΠΎΡΡΡ ΠΊΠΎΠ½ΡΠ°ΠΊΡΠ½ΡΠ΅ Π»ΠΈΠ½Π·Ρ, Π΄ΠΎΠ»ΠΆΠ½Ρ ΡΠ΄Π΅Π»ΠΈΡΡ ΠΎΡΠΎΠ±ΠΎΠ΅ Π²Π½ΠΈΠΌΠ°Π½ΠΈΠ΅ ΠΈΡ ΠΎΡΠΈΡΠ΅Π½ΠΈΡ.
Π Π³ΠΎΡΠ°Ρ , Π³Π΄Π΅ Π΅ΡΡΡ ΡΠ½Π΅Π³ ΠΈ ΡΡΠΊΠΎΠ΅ ΡΠΎΠ»Π½ΡΠ΅, Π³Π»Π°Π·Π° Π΄ΠΎΠ»ΠΆΠ½Ρ Π±ΡΡΡ Π·Π°ΡΠΈΡΠ΅Π½Ρ ΡΠΎΠ»Π½ΡΠ΅Π·Π°ΡΠΈΡΠ½ΡΠΌΠΈ ΠΎΡΠΊΠ°ΠΌΠΈ.
ΠΠ»Π°Π·Π° Π½Π΅ Π΄ΠΎΠ»ΠΆΠ½Ρ ΠΏΠ΅ΡΠ΅Π½Π°ΠΏΡΡΠ³Π°ΡΡΡΡ. ΠΡΠΎ ΠΎΡΠΎΠ±Π΅Π½Π½ΠΎ Π°ΠΊΡΡΠ°Π»ΡΠ½ΠΎ Π΄Π»Ρ Π»ΡΠ΄Π΅ΠΉ, ΡΠ°Π±ΠΎΡΠ°ΡΡΠΈΡ Π·Π° ΠΊΠΎΠΌΠΏΡΡΡΠ΅ΡΠΎΠΌ.
Π§Π°ΡΡΠΎ Π·Π°Π΄Π°Π²Π°Π΅ΠΌΡΠ΅ Π²ΠΎΠΏΡΠΎΡΡ
ΠΠ°ΠΊ ΡΠ°ΡΠΏΠΎΠ·Π½Π°ΡΡ ΠΈΠ½ΡΠ΅ΠΊΡΠΈΠΎΠ½Π½ΡΠΉ ΠΊΠΎΠ½ΡΡΠ½ΠΊΡΠΈΠ²ΠΈΡ?
ΠΠ°ΡΠ°ΠΆΠ΅Π½ΠΈΠ΅ Π±Π°ΠΊΡΠ΅ΡΠΈΡΠΌΠΈ ΠΏΡΠΎΡΠ²Π»ΡΠ΅ΡΡΡ ΡΠ»ΠΈΠ·ΠΈΡΡΡΠΌΠΈ, Π³Π½ΠΎΠΉΠ½ΡΠΌΠΈ Π²ΡΠ΄Π΅Π»Π΅Π½ΠΈΡΠΌΠΈ, ΡΠΊΠ»Π΅ΠΈΠ²Π°ΡΡΠΈΠΌΠΈ Π²Π΅ΠΊΠΈ. ΠΠ±ΡΡΠ½ΠΎ, ΠΎΠ±Π° Π³Π»Π°Π·Π° ΠΏΠΎΡΠ°ΠΆΠ°ΡΡΡΡ ΠΎΠ΄Π½ΠΎΠ²ΡΠ΅ΠΌΠ΅Π½Π½ΠΎ. ΠΠ΅ΠΎΠ±Ρ ΠΎΠ΄ΠΈΠΌΠ° ΠΊΠΎΠ½ΡΡΠ»ΡΡΠ°ΡΠΈΡ Ρ Π²ΡΠ°ΡΠΎΠΌ, ΠΊΠΎΡΠΎΡΡΠΉ ΡΡΡΠ°Π½ΠΎΠ²ΠΈΡ ΡΠΎΡΠ½ΡΠΉ Π΄ΠΈΠ°Π³Π½ΠΎΠ·.
ΠΠΎΠΆΠ½ΠΎ Π»ΠΈ ΡΠ°ΠΌΠΎΡΡΠΎΡΡΠ΅Π»ΡΠ½ΠΎ Π»Π΅ΡΠΈΡΡ Π²ΠΎΡΠΏΠ°Π»Π΅Π½ΠΈΠ΅ Π³Π»Π°Π·Π°?
ΠΠ΅Ρ. ΠΠΎΡΠΊΠΎΠ»ΡΠΊΡ ΡΡΡΠ΅ΡΡΠ²ΡΠ΅Ρ ΠΌΠ½ΠΎΠ³ΠΎ ΡΠ°Π·Π»ΠΈΡΠ½ΡΡ ΠΏΡΠΈΡΠΈΠ½ Π·Π°Π±ΠΎΠ»Π΅Π²Π°Π½ΠΈΡ, Π½Π΅ΠΎΠ±Ρ ΠΎΠ΄ΠΈΠΌΠΎ ΠΏΠΎΡΡΠ°Π²ΠΈΡΡ ΡΠΎΡΠ½ΡΠΉ Π΄ΠΈΠ°Π³Π½ΠΎΠ·, ΡΡΠΎ ΠΌΠΎΠΆΠ΅Ρ ΡΠ΄Π΅Π»Π°ΡΡ ΡΠΎΠ»ΡΠΊΠΎ ΠΎΡΡΠ°Π»ΡΠΌΠΎΠ»ΠΎΠ³. ΠΠ°ΠΆΠ΄ΡΠΉ ΠΏΡΠ΅ΠΏΠ°ΡΠ°Ρ, Π½Π΅ΡΠΌΠΎΡΡΡ Π½Π° Π΅Π³ΠΎ Π΄ΠΎΡΡΡΠΏΠ½ΠΎΡΡΡ Π±Π΅Π· ΡΠ΅ΡΠ΅ΠΏΡΠ°, Π² ΡΠ»ΡΡΠ°Π΅ Π½Π΅ΠΏΡΠ°Π²ΠΈΠ»ΡΠ½ΠΎΠ³ΠΎ ΠΈΡΠΏΠΎΠ»ΡΠ·ΠΎΠ²Π°Π½ΠΈΡ, ΠΌΠΎΠΆΠ΅Ρ Π½Π°Π½Π΅ΡΡΠΈ Π±ΠΎΠ»ΡΡΠΎΠΉ ΡΡΠ΅ΡΠ±.
ΠΠ°ΠΆΠ½ΠΎ! Π‘ΠΏΠ΅ΡΠΈΠ°Π»ΡΠ½ΠΎΠ΅ ΠΏΡΠ΅Π΄ΡΠΏΡΠ΅ΠΆΠ΄Π΅Π½ΠΈΠ΅ ΠΎΡΠ½ΠΎΡΠΈΡΡΡ ΠΊ ΠΈΡΠΏΠΎΠ»ΡΠ·ΠΎΠ²Π°Π½ΠΈΡ ΠΊΠΎΠΌΠΏΡΠ΅ΡΡΠ° ΠΈΠ· ΡΠΎΠΌΠ°ΡΠΊΠΈ: Ρ ΡΡΠ΄Π° Π»ΡΠ΄Π΅ΠΉ ΠΎΠ½ ΠΌΠΎΠΆΠ΅Ρ Π²ΡΠ·Π²Π°ΡΡ Π°Π»Π»Π΅ΡΠ³ΠΈΡΠ΅ΡΠΊΠΈΠ΅ ΡΠ΅Π°ΠΊΡΠΈΠΈ!
Π§ΡΠΎ ΠΌΠΎΠΆΠ½ΠΎ ΡΠ΄Π΅Π»Π°ΡΡ ΠΏΡΠΈ ΡΡΡ ΠΎΡΡΠΈ Π³Π»Π°Π·?
ΠΠ΅ ΡΡΡΠ΅ΡΡΠ²ΡΠ΅Ρ Π»Π΅ΡΠ΅Π½ΠΈΡ, ΠΊΠΎΡΠΎΡΠΎΠ΅ Π±Ρ ΠΏΠΎΠ΄Ρ ΠΎΠ΄ΠΈΠ»ΠΎ Π΄Π»Ρ Π²ΡΠ΅Ρ . ΠΠΈΠ·ΠΈΡ ΠΊ Π²ΡΠ°ΡΡ Π½Π΅ΠΈΠ·Π±Π΅ΠΆΠ΅Π½. Π‘ΡΠ΅ΠΏΠ΅Π½Ρ ΠΏΠΎΠ²ΡΠ΅ΠΆΠ΄Π΅Π½ΠΈΡ ΡΠ»Π΅Π·Π½ΠΎΠΉ ΠΏΠ»Π΅Π½ΠΊΠΈ ΡΠΏΠ΅ΡΠΈΠ°Π»ΠΈΡΡ ΠΌΠΎΠΆΠ΅Ρ ΡΠΎΡΠ½ΠΎ ΠΎΠΏΡΠ΅Π΄Π΅Π»ΠΈΡΡ Ρ ΠΏΠΎΠΌΠΎΡΡΡ ΡΠ΅ΡΡΠΎΠ² ΠΈ ΠΈΡΡΠ»Π΅Π΄ΠΎΠ²Π°Π½ΠΈΠΉ; ΡΠΎΠ»ΡΠΊΠΎ Π² ΡΠΎΠΎΡΠ²Π΅ΡΡΡΠ²ΠΈΠΈ Ρ ΠΈΡ ΡΠ΅Π·ΡΠ»ΡΡΠ°ΡΠ°ΠΌΠΈ Π²ΡΠ±ΠΈΡΠ°Π΅ΡΡΡ ΡΠΎΠΎΡΠ²Π΅ΡΡΡΠ²ΡΡΡΠΈΠΉ ΠΏΡΠ΅ΠΏΠ°ΡΠ°Ρ, Π·Π°ΠΌΠ΅Π½ΡΡΡΠΈΠΉ ΡΠ»Π΅Π·Π½ΡΡ ΠΏΠ»Π΅Π½ΠΊΡ.

ΠΠΎΠ½ΡΡΠ½ΠΊΡΠΈΠ²ΠΈΡ ΠΌΠΎΠΆΠ΅Ρ Π²ΠΎΠ·Π½ΠΈΠΊΠ°ΡΡ ΠΏΡΠΈ ΠΌΠ½ΠΎΠ³ΠΈΡ Π·Π°Π±ΠΎΠ»Π΅Π²Π°Π½ΠΈΡΡ . ΠΠ½ ΡΠ°ΡΡΠΎ ΡΠ²Π»ΡΠ΅ΡΡΡ Π²ΡΠΎΡΠΈΡΠ½ΡΠΌ ΡΠΈΠΌΠΏΡΠΎΠΌΠΎΠΌ ΡΠ°Π·Π΄ΡΠ°ΠΆΠ΅Π½ΠΈΡ ΠΈΠ½ΠΎΡΠΎΠ΄Π½ΡΠΌ ΡΠ΅Π»ΠΎΠΌ, Π½ΠΎ ΡΠ°ΠΊΠΆΠ΅ ΠΌΠΎΠΆΠ΅Ρ ΡΠΎΠΏΡΠΎΠ²ΠΎΠΆΠ΄Π°ΡΡ ΡΠ°ΠΌΡΠ΅ ΡΡΠΆΠ΅Π»ΡΠ΅ Π±ΠΎΠ»Π΅Π·Π½ΠΈ, ΡΠ°ΠΊΠΈΠ΅ ΠΊΠ°ΠΊ Π³Π»Π°ΡΠΊΠΎΠΌΠ°. ΠΠΎΡΡΠΎΠΌΡ Π² ΡΠ»ΡΡΠ°Π΅ ΠΏΠΎΡΠ²Π»Π΅Π½ΠΈΡ ΠΏΡΠΈΠ·Π½Π°ΠΊΠΎΠ² Π²ΠΎΡΠΏΠ°Π»Π΅Π½ΠΈΡ, ΡΠ»Π΅Π΄ΡΠ΅Ρ ΠΏΡΠΎΠΊΠΎΠ½ΡΡΠ»ΡΡΠΈΡΠΎΠ²Π°ΡΡΡΡ Ρ ΠΎΡΡΠ°Π»ΡΠΌΠΎΠ»ΠΎΠ³ΠΎΠΌ.
bolvglazah.ru
ΠΠΎΠ½ΡΡΠ½ΠΊΡΠΈΠ²ΠΈΡ βΊ ΠΠΎΠ»Π΅Π·Π½ΠΈ βΊ ΠΠΎΠΊΡΠΎΡΠΠΈΡΠ΅Ρ.ΡΡ
ΠΠΎΠ½ΡΡΠ½ΠΊΡΠΈΠ²ΠΈΡ (conjunctivitis; Π°Π½Π°Ρ. [tunica] conjunctiva ΡΠΎΠ΅Π΄ΠΈΠ½ΠΈΡΠ΅Π»ΡΠ½Π°Ρ ΠΎΠ±ΠΎΠ»ΠΎΡΠΊΠ° Π³Π»Π°Π·Π° + -itis)Β β Π²ΠΎΡΠΏΠ°Π»Π΅Π½ΠΈΠ΅ ΠΊΠΎΠ½ΡΡΠ½ΠΊΡΠΈΠ²Ρ, ΡΠ°ΡΠ΅ ΠΈΠ½ΡΠ΅ΠΊΡΠΈΠΎΠ½Π½ΠΎΠΉ ΠΏΡΠΈΡΠΎΠ΄Ρ. ΠΠΎΠ·Π±ΡΠ΄ΠΈΡΠ΅Π»ΠΈ ΠΈΠ½ΡΠ΅ΠΊΡΠΈΠΉ ΠΎΠ±ΡΡΠ½ΠΎ ΠΏΠΎΠΏΠ°Π΄Π°ΡΡ Π² Π³Π»Π°Π· ΡΠΊΠ·ΠΎΠ³Π΅Π½Π½ΡΠΌ, ΡΠ΅ΠΆΠ΅ ΡΠ½Π΄ΠΎΠ³Π΅Π½Π½ΡΠΌ ΠΏΡΡΠ΅ΠΌ, Π Π·Π°Π²ΠΈΡΠΈΠΌΠΎΡΡΠΈ ΠΎΡ Π²ΠΎΠ·Π±ΡΠ΄ΠΈΡΠ΅Π»Ρ ΡΠ°Π·Π»ΠΈΡΠ°ΡΡ Π±Π°ΠΊΡΠ΅ΡΠΈΠ°Π»ΡΠ½ΡΠ΅, Π²ΠΈΡΡΡΠ½ΡΠ΅, Ρ Π»Π°ΠΌΠΈΠ΄ΠΈΠΉΠ½ΡΠ΅, Π³ΡΠΈΠ±ΠΊΠΎΠ²ΡΠ΅ ΠΊΠΎΠ½ΡΡΠΊΡΠΈΠ²ΠΈΡΡ.
ΠΡΠΈΠ·Π½Π°ΠΊΠΈ
ΠΠ»ΠΈΠ½ΠΈΡΠ΅ΡΠΊΠ°Ρ ΠΊΠ°ΡΡΠΈΠ½Π° Π·Π°Π²ΠΈΡΠΈΡ ΠΎΡ ΠΏΡΠΈΡΠΈΠ½Ρ ΠΊΠΎΠ½ΡΡΠ½ΠΊΡΠΈΠ²ΠΈΡΠ°, ΠΎΠ΄Π½Π°ΠΊΠΎ Π²ΡΠ΅ ΡΡΠΈΠΎΠ»ΠΎΠ³ΠΈΡΠ΅ΡΠΊΠΈΠ΅ ΡΠΎΡΠΌΡ Π·Π°Π±ΠΎΠ»Π΅Π²Π°Π½ΠΈΡ Ρ Π°ΡΠ°ΠΊΡΠ΅ΡΠΈΠ·ΡΡΡΡΡ ΡΡΠ΄ΠΎΠΌ ΠΎΠ±ΡΠΈΡ ΠΏΡΠΈΠ·Π½Π°ΠΊΠΎΠ²Β β ΠΎΡΠ΅ΠΊΠΎΠΌ ΠΈ Π³ΠΈΠΏΠ΅ΡΠ΅ΠΌΠΈΠ΅ΠΉ ΠΊΠΎΠ½ΡΡΠ½ΠΊΡΠΈΠ²Ρ Π³Π»Π°Π²Π½ΡΠΌ ΠΎΠ±ΡΠ°Π·ΠΎΠΌ Π²Π΅ΠΊ ΠΈ ΠΏΠ΅ΡΠ΅Ρ ΠΎΠ΄Π½ΡΡ ΡΠΊΠ»Π°Π΄ΠΎΠΊ, Π½Π°Π»ΠΈΡΠΈΠ΅ΠΌ ΡΠ»ΠΈΠ·ΠΈΡΡΠΎΠ³ΠΎ (ΠΊΠ°ΡΠ°ΡΠ°Π»ΡΠ½ΡΠΉ ΠΊΠ°ΡΠ°ΡΠ°Π»ΡΠ½ΡΠΉ ΠΊΠΎΠ½ΡΡΠΊΡΠΈΠ²ΠΈΡ) ΠΈΠ»ΠΈ Π³Π½ΠΎΠΉΠ½ΠΎΠ³ΠΎ (Π³Π½ΠΎΠΉΠ½ΡΠΉ ΠΊΠΎΠ½ΡΡΠΊΡΠΈΠ²ΠΈΡ) ΠΎΡΠ΄Π΅Π»ΡΠ΅ΠΌΠΎΠ³ΠΎ.
Π£ Π΄Π΅ΡΠ΅ΠΉ Π½Π΅ΡΠ΅Π΄ΠΊΠΎ Π²ΠΎΠ·Π½ΠΈΠΊΠ°Π΅Ρ ΠΏΠ»Π΅Π½ΡΠ°ΡΠ°Ρ ΡΠΎΡΠΌΠ° ΠΊΠΎΠ½ΡΡΠ½ΠΊΡΠΈΠ²ΠΈΡΠ°, Ρ Π°ΡΠ°ΠΊΡΠ΅ΡΠΈΠ·ΡΡΡΠ°ΡΡΡ ΡΠΌΠ΅ΡΠ΅Π½Π½ΡΠΌ ΠΎΡΠ΅ΠΊΠΎΠΌ Π²Π΅ΠΊ, ΡΡΠΊΠΎΠΉ Π³ΠΈΠΏΠ΅ΡΠ΅ΠΌΠΈΠ΅ΠΉ ΠΈΡ ΠΊΠΎΠ½ΡΡΠ½ΠΊΡΠΈΠ²Ρ, Π½Π°Π»ΠΈΡΠΈΠ΅ΠΌ ΠΌΠ΅Π»ΠΊΠΈΡ Π³Π΅ΠΌΠΎΡΡΠ°Π³ΠΈΠΉ ΠΈ ΡΠ»ΠΈΠ·ΠΈΡΡΠΎ-Π³Π½ΠΎΠΉΠ½ΠΎΠΉ ΠΏΠ»Π΅Π½ΠΊΠΈ, Π»Π΅Π³ΠΊΠΎ ΡΠ½ΠΈΠΌΠ°ΡΡΠ΅ΠΉΡΡ Π²Π°ΡΠ½ΡΠΌ ΡΠ°ΠΌΠΏΠΎΠ½ΠΎΠΌ. ΠΠ°ΠΈΠ±ΠΎΠ»Π΅Π΅ ΡΡΠΆΠ΅Π»Π°Ρ ΡΠΎΡΠΌΠ° ΠΏΠ»Π΅Π½ΡΠ°ΡΠΎΠ³ΠΎ ΠΊΠΎΠ½ΡΡΠΊΡΠΈΠ²ΠΈΡΠ° ΡΠ°Π·Π²ΠΈΠ²Π°Π΅ΡΡΡ ΠΏΡΠΈ Π΄ΠΈΡΡΠ΅ΡΠΈΠΈ.
Π§Π°ΡΡΠΎ, Π½Π°ΠΏΡΠΈΠΌΠ΅Ρ ΠΏΡΠΈ Π°Π΄Π΅Π½ΠΎΠ²ΠΈΡΡΡΠ½ΡΡ ΠΈ Ρ Π»Π°ΠΌΠΈΠ΄ΠΈΠΉΠ½ΡΡ ΠΏΠΎΡΠ°ΠΆΠ΅Π½ΠΈΡΡ , Π½Π°Π±Π»ΡΠ΄Π°Π΅ΡΡΡ ΡΠ°ΠΊ Π½Π°Π·ΡΠ²Π°Π΅ΠΌΡΠΉ ΡΠΎΠ»Π»ΠΈΠΊΡΠ»ΡΡΠ½ΡΠΉ ΠΊΠΎΠ½ΡΡΠΊΡΠΈΠ²ΠΈΡ, ΠΏΡΠΎΡΠ΅ΠΊΠ°ΡΡΠΈΠΉ Ρ ΠΏΠΎΡΠ²Π»Π΅Π½ΠΈΠ΅ΠΌ Π½Π° ΠΊΠΎΠ½ΡΡΠ½ΠΊΡΠΈΠ²Π΅ ΠΏΠ΅ΡΠ΅Ρ ΠΎΠ΄Π½ΡΡ ΡΠΊΠ»Π°Π΄ΠΎΠΊ ΠΌΠ΅Π»ΠΊΠΈΡ ΠΏΠΎΠ»ΡΠΏΡΠΎΠ·ΡΠ°ΡΠ½ΡΡ ΠΎΠ±ΡΠ°Π·ΠΎΠ²Π°Π½ΠΈΠΉ Π±Π»Π΅Π΄Π½ΠΎ-ΡΠΎΠ·ΠΎΠ²ΠΎΠ³ΠΎ ΡΠ²Π΅ΡΠ°Β β ΡΠΎΠ»Π»ΠΈΠΊΡΠ»ΠΎΠ². ΠΠ½Π°Π»ΠΎΠ³ΠΈΡΠ½ΡΠ΅ ΠΈΠ·ΠΌΠ΅Π½Π΅Π½ΠΈΡ ΠΌΠΎΠ³ΡΡ ΠΎΡΠΌΠ΅ΡΠ°ΡΡΡΡ ΠΈ Ρ Π΄Π΅ΡΠ΅ΠΉ ΠΏΡΠΈ ΡΠΎΠ»Π»ΠΈΠΊΡΠ»Π΅Π·Π΅ (ΠΎΠ΄Π½ΠΎΠ²ΡΠ΅ΠΌΠ΅Π½Π½ΠΎ ΠΎΠ±Π½Π°ΡΡΠΆΠΈΠ²Π°ΡΡΡΡ ΡΠΎΠ»Π»ΠΈΠΊΡΠ»Ρ Π½Π° ΠΌΠΈΠ½Π΄Π°Π»ΠΈΠ½Π°Ρ , Π·Π°Π΄Π½Π΅ΠΉ ΡΡΠ΅Π½ΠΊΠ΅ Π³Π»ΠΎΡΠΊΠΈ), ΠΊΠΎΡΠΎΡΡΠ΅ Π² ΠΎΡΠ»ΠΈΡΠΈΠ΅ ΠΎΡ ΡΠΎΠ»Π»ΠΈΠΊΡΠ»ΡΡΠ½ΠΎΠ³ΠΎ ΠΊΠΎΠ½ΡΡΠΊΡΠΈΠ²ΠΈΡΠ° Π½Π΅ ΡΡΠ΅Π±ΡΡΡ Π»Π΅ΡΠ΅Π½ΠΈΡ.
ΠΠΎ Ρ Π°ΡΠ°ΠΊΡΠ΅ΡΡ ΡΠ΅ΡΠ΅Π½ΠΈΡ ΡΠ°Π·Π»ΠΈΡΠ°ΡΡ ΠΎΡΡΡΡΠΉ, ΠΏΠΎΠ΄ΠΎΡΡΡΡΠΉ ΠΈ Ρ ΡΠΎΠ½ΠΈΡΠ΅ΡΠΊΠΈΠΉ ΠΊΠΎΠ½ΡΡΠ½ΠΊΡΠΈΠ²ΠΈΡΡ. ΠΡΡΡΡΠΉ ΠΊΠΎΠ½ΡΡΠ½ΠΊΡΠΈΠ²ΠΈΡ Π½Π°ΡΠΈΠ½Π°Π΅ΡΡΡ Π²Π½Π΅Π·Π°ΠΏΠ½ΠΎ Ρ ΡΠ΅Π·ΠΈ ΠΈΠ»ΠΈ Π±ΠΎΠ»ΠΈ, ΡΠ½Π°ΡΠ°Π»Π° Π½Π° ΠΎΠ΄Π½ΠΎΠΌ, Π·Π°ΡΠ΅ΠΌ Π½Π° Π΄ΡΡΠ³ΠΎΠΌ Π³Π»Π°Π·Ρ. ΠΠ° ΡΠΎΠ½Π΅ Π²ΡΡΠ°ΠΆΠ΅Π½Π½ΠΎΠΉ Π³ΠΈΠΏΠ΅ΡΠ΅ΠΌΠΈΠΈ Π½Π΅ΡΠ΅Π΄ΠΊΠΎ Π½Π°Π±Π»ΡΠ΄Π°ΡΡΡΡ Π³Π΅ΠΌΠΎΡΡΠ°Π³ΠΈΠΈ. Π Π°Π·Π²ΠΈΠ²Π°ΡΡΡΡ ΠΊΠΎΠ½ΡΡΠ½ΠΊΡΠΈΠ²Π°Π»ΡΠ½Π°Ρ ΠΈΠ½ΡΠ΅ΠΊΡΠΈΡ Π³Π»Π°Π·Π½ΠΎΠ³ΠΎ ΡΠ±Π»ΠΎΠΊΠ°, ΠΎΡΠ΅ΠΊ ΠΊΠΎΠ½ΡΡΠ½ΠΊΡΠΈΠ²Ρ. ΠΠ½ΠΎΠ³Π΄Π° ΠΎΡΠ΅ΠΊ ΠΊΠΎΠ½ΡΡΠ½ΠΊΡΠΈΠ²Ρ Π³Π»Π°Π·Π½ΠΎΠ³ΠΎ ΡΠ±Π»ΠΎΠΊΠ° Π΄ΠΎΡΡΠΈΠ³Π°Π΅Ρ Π·Π½Π°ΡΠΈΡΠ΅Π»ΡΠ½ΡΡ ΡΠ°Π·ΠΌΠ΅ΡΠΎΠ², Π² ΡΠ΅Π·ΡΠ»ΡΡΠ°ΡΠ΅ ΡΠ΅Π³ΠΎ ΠΎΠ½Π° ΡΡΠ΅ΠΌΠ»ΡΠ΅ΡΡΡ Π² Π³Π»Π°Π·Π½ΠΎΠΉ ΡΠ΅Π»ΠΈ (Ρ Π΅ΠΌΠΎΠ· ΠΊΠΎΠ½ΡΡΠ½ΠΊΡΠΈΠ²Ρ). ΠΠΎΡΠ²Π»ΡΠ΅ΡΡΡ ΠΎΠ±ΠΈΠ»ΡΠ½ΠΎΠ΅ (ΡΠ»ΠΈΠ·ΠΈΡΡΠΎΠ΅, ΡΠ»ΠΈΠ·ΠΈΡΡΠΎ-Π³Π½ΠΎΠΉΠ½ΠΎΠ΅ ΠΈ Π³Π½ΠΎΠΉΠ½ΠΎΠ΅) ΠΎΡΠ΄Π΅Π»ΡΠ΅ΠΌΠΎΠ΅. ΠΡΡΡΡΠΉ ΠΊΠΎΠ½ΡΡΠ½ΠΊΡΠΈΠ²ΠΈΡ ΠΌΠΎΠΆΠ΅Ρ ΡΠΎΠΏΡΠΎΠ²ΠΎΠΆΠ΄Π°ΡΡΡΡ ΠΎΠ±ΡΠΈΠΌ Π½Π΅Π΄ΠΎΠΌΠΎΠ³Π°Π½ΠΈΠ΅ΠΌ, ΠΏΠΎΠ²ΡΡΠ΅Π½ΠΈΠ΅ΠΌ ΡΠ΅ΠΌΠΏΠ΅ΡΠ°ΡΡΡΡ ΡΠ΅Π»Π° ΠΈ Π³ΠΎΠ»ΠΎΠ²Π½ΠΎΠΉ Π±ΠΎΠ»ΡΡ. ΠΠ»ΠΈΡΠ΅Π»ΡΠ½ΠΎΡΡΡ ΠΎΡΡΡΠΎΠ³ΠΎ ΠΊΠΎΠ½ΡΡΠΊΡΠΈΠ²ΠΈΡΠ° ΠΊΠΎΠ»Π΅Π±Π»Π΅ΡΡΡ ΠΎΡ 5β6Β Π΄Π½Π΅ΠΉ Π΄ΠΎ 2β3Β Π½Π΅Π΄Π΅Π»Ρ.
ΠΡΠΈ ΠΏΠΎΠ΄ΠΎΡΡΡΠΎΠΌ ΠΊΠΎΠ½ΡΡΠ½ΠΊΡΠΈΠ²ΠΈΡΠ΅ Π² ΠΎΡΠ»ΠΈΡΠΈΠ΅ ΠΎΡ ΠΎΡΡΡΠΎΠ³ΠΎ ΠΊΠ»ΠΈΠ½ΠΈΡΠ΅ΡΠΊΠ°Ρ ΡΠΈΠΌΠΏΡΠΎΠΌΠ°ΡΠΈΠΊΠ° Π²ΡΡΠ°ΠΆΠ΅Π½Π° ΡΠ»Π°Π±Π΅Π΅.
Π₯ΡΠΎΠ½ΠΈΡΠ΅ΡΠΊΠΈΠΉ ΠΊΠΎΠ½ΡΡΠ½ΠΊΡΠΈΠ²ΠΈΡ ΡΠ°Π·Π²ΠΈΠ²Π°Π΅ΡΡΡ ΠΏΠΎΡΡΠ΅ΠΏΠ΅Π½Π½ΠΎ, Ρ Π°ΡΠ°ΠΊΡΠ΅ΡΠΈΠ·ΡΠ΅ΡΡΡ ΡΠΏΠΎΡΠ½ΡΠΌ ΠΈ Π΄Π»ΠΈΡΠ΅Π»ΡΠ½ΡΠΌ ΡΠ΅ΡΠ΅Π½ΠΈΠ΅ΠΌ. ΠΠΎΠ»ΡΠ½ΡΠ΅ ΠΆΠ°Π»ΡΡΡΡΡ Π½Π° Π½Π΅ΠΏΡΠΈΡΡΠ½ΡΠ΅ ΠΎΡΡΡΠ΅Π½ΠΈΡ, ΡΡΠ²ΡΡΠ²ΠΎ ΠΈΠ½ΠΎΡΠΎΠ΄Π½ΠΎΠ³ΠΎ ΡΠ΅Π»Π° Π² Π³Π»Π°Π·Ρ. ΠΠΎΠ½ΡΡΠ½ΠΊΡΠΈΠ²Π° Π²Π΅ΠΊ ΠΈ ΠΏΠ΅ΡΠ΅Ρ ΠΎΠ΄Π½ΡΡ ΡΠΊΠ»Π°Π΄ΠΎΠΊ ΡΠ»Π΅Π³ΠΊΠ° Π³ΠΈΠΏΠ΅ΡΠ΅ΠΌΠΈΡΠΎΠ²Π°Π½Π°, ΡΠ°Π·ΡΡΡ Π»Π΅Π½Π°, ΠΏΠΎΠ²Π΅ΡΡ Π½ΠΎΡΡΡ Π΅Π΅ ΠΈΠΌΠ΅Π΅Ρ Π½Π΅ΡΠΎΠ²Π½ΡΠΉ Π±Π°ΡΡ Π°ΡΠΈΡΡΡΠΉ Π²ΠΈΠ΄. ΠΡΠ»ΠΎΠΆΠ½Π΅Π½ΠΈΠ΅ΠΌ Ρ ΡΠΎΠ½ΠΈΡΠ΅ΡΠΊΠΎΠ³ΠΎ ΠΊΠΎΠ½ΡΡΠΊΡΠΈΠ²ΠΈΡΠ° ΠΌΠΎΠΆΠ΅Ρ ΡΡΠ°ΡΡ ΠΏΠΎΡΠ°ΠΆΠ΅Π½ΠΈΠ΅ ΡΠΎΠ³ΠΎΠ²ΠΈΡΡ Ρ ΡΠ°Π·Π²ΠΈΡΠΈΠ΅ΠΌ ΠΊΠ΅ΡΠ°ΡΠΈΡΠ°.
ΠΠΏΠΈΡΠ°Π½ΠΈΠ΅
ΠΠΎΠ·Π±ΡΠ΄ΠΈΡΠ΅Π»ΠΈ Π±Π°ΠΊΡΠ΅ΡΠΈΠ°Π»ΡΠ½ΡΡ ΠΊΠΎΠ½ΡΡΠ½ΠΊΡΠΈΠ²ΠΈΡΠΎΠ²Β β ΡΡΠ°ΡΠΈΠ»ΠΎΠΊΠΎΠΊΠΊΠΈ, ΠΏΠ½Π΅Π²ΠΌΠΎΠΊΠΎΠΊΠΊΠΈ, ΡΡΡΠ΅ΠΏΡΠΎΠΊΠΎΠΊΠΊΠΈ, ΠΊΠΈΡΠ΅ΡΠ½Π°Ρ ΠΏΠ°Π»ΠΎΡΠΊΠ°, Π³ΠΎΠ½ΠΎΠΊΠΎΠΊΠΊΠΈ, ΠΏΠ°Π»ΠΎΡΠΊΠΈ Π΄ΠΈΡΡΠ΅ΡΠΈΠΈ ΠΈ ΠΠΎΡ Π°Β β Π£ΠΈΠΊΡΠ°, Π΄ΠΈΠΏΠ»ΠΎΠ±Π°ΡΠΈΠ»Π»Π° ΠΠΎΡΠ°ΠΊΡΠ°Β β ΠΠΊΡΠ΅Π½ΡΠ΅Π»ΡΠ΄Π° ΠΈ Π΄Ρ. Π‘ΡΠ΅Π΄ΠΈ Π²ΠΈΡΡΡΠ½ΡΡ Π½Π°ΠΈΠ±ΠΎΠ»Π΅Π΅ ΡΠ°ΡΠΏΡΠΎΡΡΡΠ°Π½Π΅Π½ Π°Π΄Π΅Π½ΠΎΠ²ΠΈΡΡΡΠ½ΡΠΉ ΠΊΠΎΠ½ΡΡΠ½ΠΊΡΠΈΠ²ΠΈΡ (Π°Π΄Π΅Π½ΠΎΡΠ°ΡΠΈΠ½Π³ΠΎΠΊΠΎΠ½ΡΡΠ½ΠΊΡΠΈΠ²Π°Π»ΡΠ½Π°Ρ Π»ΠΈΡ ΠΎΡΠ°Π΄ΠΊΠ°), Π²ΡΠ·ΡΠ²Π°Π΅ΠΌΡΠΉ Π°Π΄Π΅Π½ΠΎΠ²ΠΈΡΡΡΠ°ΠΌΠΈ ΡΠ°Π·Π»ΠΈΡΠ½ΡΡ ΡΠΈΠΏΠΎΠ²; Π²ΡΡΡΠ΅ΡΠ°Π΅ΡΡΡ Π² Π»ΡΠ±ΠΎΠ΅ Π²ΡΠ΅ΠΌΡ Π³ΠΎΠ΄Π° Π² Π²ΠΈΠ΄Π΅ ΡΠΏΠΎΡΠ°Π΄ΠΈΡΠ΅ΡΠΊΠΈΡ ΡΠ»ΡΡΠ°Π΅Π² ΠΈΠ»ΠΈ ΡΠΏΠΈΠ΄Π΅ΠΌΠΈΡΠ΅ΡΠΊΠΈΡ Π²ΡΠΏΡΡΠ΅ΠΊ ΡΡΠ΅Π΄ΠΈ Π²ΡΠ΅Ρ Π²ΠΎΠ·ΡΠ°ΡΡΠ½ΡΡ Π³ΡΡΠΏΠΏ Π½Π°ΡΠ΅Π»Π΅Π½ΠΈΡ. Π Π²ΠΈΡΡΡΠ½ΡΠΌ ΠΊΠΎΠ½ΡΡΠ½ΠΊΡΠΈΠ²ΠΈΡΠ°ΠΌ ΠΎΡΠ½ΠΎΡΡΡΡΡ ΡΠ°ΠΊΠΆΠ΅ ΡΠΏΠΈΠ΄Π΅ΠΌΠΈΡΠ΅ΡΠΊΠΈΠΉ Π°Π΄Π΅Π½ΠΎΠ²ΠΈΡΡΡΠ½ΡΠΉ ΠΊΠ΅ΡΠ°ΡΠΎΠΊΠΎΠ½ΡΡΠ½ΠΊΡΠΈΠ²ΠΈΡ, ΡΠΏΠΈΠ΄Π΅ΠΌΠΈΡΠ΅ΡΠΊΠΈΠΉ Π³Π΅ΠΌΠΎΡΡΠ°Π³ΠΈΡΠ΅ΡΠΊΠΈΠΉ ΠΊΠΎΠ½ΡΡΠ½ΠΊΡΠΈΠ²ΠΈΡ, Π³Π΅ΡΠΏΠ΅ΡΠΈΡΠ΅ΡΠΊΠΈΠΉ ΠΈ ΠΊΠΎΡΠ΅Π²ΠΎΠΉ ΠΊΠΎΠ½ΡΡΠ½ΠΊΡΠΈΠ²ΠΈΡΡ ΠΈ Π΄Ρ. Π Ρ Π»Π°ΠΌΠΈΠ΄ΠΈΠΉΠ½ΡΠΌ ΠΎΡΠ½ΠΎΡΡΡΡΡ ΡΡΠ°Ρ ΠΎΠΌΠ½ΡΠΉ ΠΈ ΠΏΠ°ΡΠ°ΡΡΠ°Ρ ΠΎΠΌΠ½ΡΠΉ (ΠΊΠΎΠ½ΡΡΠ½ΠΊΡΠΈΠ²ΠΈΡ Ρ Π²ΠΊΠ»ΡΡΠ΅Π½ΠΈΡΠΌΠΈ) ΠΊΠΎΠ½ΡΡΠ½ΠΊΡΠΈΠ²ΠΈΡΡ.
Π‘ΡΠ΅Π΄ΠΈ ΠΊΠΎΠ½ΡΡΠ½ΠΊΡΠΈΠ²ΠΈΡΠΎΠ² Π½Π΅ΠΈΠ½ΡΠ΅ΠΊΡΠΈΠΎΠ½Π½ΠΎΠΉ ΠΏΡΠΈΡΠΎΠ΄Ρ Π·Π½Π°ΡΠΈΡΠ΅Π»ΡΠ½ΠΎ Π²ΠΎΠ·ΡΠΎΡΠ»ΠΎ ΡΠΈΡΠ»ΠΎ Π°Π»Π»Π΅ΡΠ³ΠΈΡΠ΅ΡΠΊΠΈΡ ΠΊΠΎΠ½ΡΡΠΊΡΠΈΠ²ΠΈΡΠΎΠ².
Π Π°Π·Π²ΠΈΡΠΈΠ΅ ΠΊΠΎΠ½ΡΡΠ½ΠΊΡΠΈΠ²ΠΈΡΠ° ΠΌΠΎΠΆΠ΅Ρ Π±ΡΡΡ ΡΠ²ΡΠ·Π°Π½ΠΎ Ρ Ρ ΡΠΎΠ½ΠΈΡΠ΅ΡΠΊΠΈΠΌΠΈ Π·Π°Π±ΠΎΠ»Π΅Π²Π°Π½ΠΈΡΠΌΠΈΒ β Π²ΠΎΡΠΏΠ°Π»Π΅Π½ΠΈΠ΅ΠΌ ΠΏΡΠΈΠ΄Π°ΡΠΎΡΠ½ΡΡ ΠΏΠ°Π·ΡΡ Π½ΠΎΡΠ°, ΠΏΠ°ΡΠΎΠ»ΠΎΠ³ΠΈΠ΅ΠΉ ΠΆΠ΅Π»ΡΠ΄ΠΎΡΠ½ΠΎ-ΠΊΠΈΡΠ΅ΡΠ½ΠΎΠ³ΠΎ ΡΡΠ°ΠΊΡΠ°, Π³Π»ΠΈΡΡΠ½ΠΎΠΉ ΠΈΠ½Π²Π°Π·ΠΈΠ΅ΠΉ ΠΈ Π΄Ρ. ΠΠ½Π°ΡΠΈΡΠ΅Π»ΡΠ½ΡΡ ΡΠΎΠ»Ρ Π² Π²ΠΎΠ·Π½ΠΈΠΊΠ½ΠΎΠ²Π΅Π½ΠΈΠΈ Π·Π°Π±ΠΎΠ»Π΅Π²Π°Π½ΠΈΡ ΠΈΠ³ΡΠ°Π΅Ρ ΡΠ΅Π°ΠΊΡΠΈΠ²Π½ΠΎΡΡΡ ΠΎΡΠ³Π°Π½ΠΈΠ·ΠΌΠ°, ΠΊΠΎΡΠΎΡΠ°Ρ ΠΎΠΏΡΠ΅Π΄Π΅Π»ΡΠ΅Ρ Ρ Π°ΡΠ°ΠΊΡΠ΅Ρ ΡΠ΅ΡΠ΅Π½ΠΈΡ ΠΈ ΠΎΡΠΎΠ±Π΅Π½Π½ΠΎΡΡΠΈ ΠΊΠ»ΠΈΠ½ΠΈΡΠ΅ΡΠΊΠΎΠ³ΠΎ ΠΏΡΠΎΡΠ²Π»Π΅Π½ΠΈΡ ΠΊΠΎΠ½ΡΡΠ½ΠΊΡΠΈΠ²ΠΈΡΠ°.
ΠΡΡΡΡΠΉ Π±Π°ΠΊΡΠ΅ΡΠΈΠ°Π»ΡΠ½ΡΠΉ ΠΊΠΎΠ½ΡΡΠ½ΠΊΡΠΈΠ²ΠΈΡ (Π² Π΄Π΅ΡΡΠΊΠΈΡ ΡΡΡΠ΅ΠΆΠ΄Π΅Π½ΠΈΡΡ ΠΌΠΎΠΆΠ΅Ρ Π½ΠΎΡΠΈΡΡ ΡΠΏΠΈΠ΄Π΅ΠΌΠΈΡΠ΅ΡΠΊΠΈΠΉ Ρ Π°ΡΠ°ΠΊΡΠ΅Ρ) Ρ Π°ΡΠ°ΠΊΡΠ΅ΡΠΈΠ·ΡΠ΅ΡΡΡ Π²ΡΡΠ°ΠΆΠ΅Π½Π½ΠΎΠΉ ΡΠ²Π΅ΡΠΎΠ±ΠΎΡΠ·Π½ΡΡ, ΡΠ»Π΅Π·ΠΎΡΠ΅ΡΠ΅Π½ΠΈΠ΅ΠΌ. ΠΠΎΠ½ΡΡΠ½ΠΊΡΠΈΠ²Π° Π³ΠΈΠΏΠ΅ΡΠ΅ΠΌΠΈΡΠΎΠ²Π°Π½Π°, ΠΎΡΠ΅ΡΠ½Π°, Ρ ΡΠΎΡΠ΅ΡΠ½ΡΠΌΠΈ ΠΊΡΠΎΠ²ΠΎΠΈΠ·Π»ΠΈΡΠ½ΠΈΡΠΌΠΈ. Π£ Π΄Π΅ΡΠ΅ΠΉ ΡΠ°ΡΡΠΎ ΠΏΡΠΎΡΠ΅ΠΊΠ°Π΅Ρ Π² ΡΠΎΡΠΌΠ΅ ΠΏΠ»Π΅Π½ΡΠ°ΡΠΎΠ³ΠΎ ΠΊΠΎΠ½ΡΡΠ½ΠΊΡΠΈΠ²ΠΈΡΠ°. Π ΠΏΠΎΠ²Π΅ΡΡ Π½ΠΎΡΡΠ½ΡΡ ΡΠ»ΠΎΡΡ ΡΠΎΠ³ΠΎΠ²ΠΈΡΡ ΠΈΠ½ΠΎΠ³Π΄Π° ΠΏΠΎΡΠ²Π»ΡΡΡΡΡ ΠΌΠ΅Π»ΠΊΠΈΠ΅ ΠΈΠ½ΡΠΈΠ»ΡΡΡΠ°ΡΡ.
Π ΡΠ΄ΠΎΠΌ ΠΎΡΠΎΠ±Π΅Π½Π½ΠΎΡΡΠ΅ΠΉ ΠΎΠ±Π»Π°Π΄Π°ΡΡ ΠΊΠΎΠ½ΡΡΠ½ΠΊΡΠΈΠ²ΠΈΡΡ, Π²ΡΠ·Π²Π°Π½Π½ΡΠ΅ ΠΏΠ°Π»ΠΎΡΠΊΠΎΠΉ ΠΠΎΡ Π°Β β Π£ΠΈΠΊΡΠ° ΠΈ Π΄ΠΈΠΏΠ»ΠΎΠ±Π°ΡΠΈΠ»Π»ΠΎΠΉ ΠΠΎΡΠ°ΠΊΡΠ°Β β ΠΠΊΡΠ΅Π½ΡΠ΅Π»ΡΠ΄Π°. ΠΡΡΡΡΠΉ ΡΠΏΠΈΠ΄Π΅ΠΌΠΈΡΠ΅ΡΠΊΠΈΠΉ ΠΊΠΎΠ½ΡΡΠ½ΠΊΡΠΈΠ²ΠΈΡ ΠΠΎΡ Π°Β β Π£ΠΈΠΊΡΠ° ΠΎΠ±ΡΡΠ½ΠΎ Π²ΡΡΡΠ΅ΡΠ°Π΅ΡΡΡ Π² Π²ΠΈΠ΄Π΅ ΡΠΏΠΈΠ΄Π΅ΠΌΠΈΡΠ΅ΡΠΊΠΈΡ Π²ΡΠΏΡΡΠ΅ΠΊ Π² Π΄Π΅ΡΡΠΊΠΈΡ ΠΊΠΎΠ»Π»Π΅ΠΊΡΠΈΠ²Π°Ρ Π² Π»Π΅ΡΠ½Π΅-ΠΎΡΠ΅Π½Π½ΠΈΠΉ ΠΏΠ΅ΡΠΈΠΎΠ΄. ΠΡΠ»ΠΈΡΠ°Π΅ΡΡΡ Π²ΡΡΠΎΠΊΠΎΠΉ ΠΊΠΎΠ½ΡΠ°Π³ΠΈΠΎΠ·Π½ΠΎΡΡΡΡ. ΠΠ½ΠΊΡΠ±Π°ΡΠΈΠΎΠ½Π½ΡΠΉ ΠΏΠ΅ΡΠΈΠΎΠ΄ ΠΎΡ Π½Π΅ΡΠΊΠΎΠ»ΡΠΊΠΈΡ ΡΠ°ΡΠΎΠ² Π΄ΠΎ 1β2Β ΡΡΡΠΎΠΊ. ΠΠ½Π°ΡΠ°Π»Π΅ ΠΏΠΎΡΠ°ΠΆΠ°Π΅ΡΡΡ ΠΎΠ΄ΠΈΠ½ Π³Π»Π°Π·, Π·Π°ΡΠ΅ΠΌ Π΄ΡΡΠ³ΠΎΠΉ. Π’ΠΈΠΏΠΈΡΠ½ΡΠΌΠΈ ΠΏΡΠΈΠ·Π½Π°ΠΊΠ°ΠΌΠΈ ΡΠ²Π»ΡΡΡΡΡ Π²ΡΡΠ°ΠΆΠ΅Π½Π½Π°Ρ Π³ΠΈΠΏΠ΅ΡΠ΅ΠΌΠΈΡ ΠΈ ΠΎΡΠ΅ΠΊ ΠΊΠΎΠ½ΡΡΠ½ΠΊΡΠΈΠ²Ρ, ΠΎΠ±ΠΈΠ»ΡΠ½ΠΎΠ΅ ΡΠ»ΠΈΠ·ΠΈΡΡΠΎ-Π³Π½ΠΎΠΉΠ½ΠΎΠ΅ ΠΎΡΠ΄Π΅Π»ΡΠ΅ΠΌΠΎΠ΅. ΠΠ΅ΡΠ΅Π΄ΠΊΠΎ ΠΏΡΠΎΡΠ΅ΡΡ ΡΠΎΠΏΡΠΎΠ²ΠΎΠΆΠ΄Π°Π΅ΡΡΡ Π½Π΅Π΄ΠΎΠΌΠΎΠ³Π°Π½ΠΈΠ΅ΠΌ, ΠΏΠΎΠ²ΡΡΠ΅Π½ΠΈΠ΅ΠΌ ΡΠ΅ΠΌΠΏΠ΅ΡΠ°ΡΡΡΡ ΡΠ΅Π»Π°, Π³ΠΎΠ»ΠΎΠ²Π½ΠΎΠΉ Π±ΠΎΠ»ΡΡ. ΠΠ»ΠΈΡΡΡ Π² ΡΡΠ΅Π΄Π½Π΅ΠΌ 2β3Β Π½Π΅Π΄Π΅Π»ΠΈ.
ΠΠΎΠ½ΡΡΠ½ΠΊΡΠΈΠ²ΠΈΡ ΠΠΎΡΠ°ΠΊΡΠ°Β β ΠΠΊΡΠ΅Π½ΡΠ΅Π»ΡΠ΄Π° ΠΏΡΠΎΡΠ΅ΠΊΠ°Π΅Ρ Ρ ΠΏΡΠ΅ΠΈΠΌΡΡΠ΅ΡΡΠ²Π΅Π½Π½ΡΠΌ ΠΏΠΎΡΠ°ΠΆΠ΅Π½ΠΈΠ΅ΠΌ ΠΊΡΠ°Π΅Π² Π²Π΅ΠΊ, ΠΎΡΠΎΠ±Π΅Π½Π½ΠΎ Π² ΡΠ³Π»Π°Ρ Π³Π»Π°Π·Π½ΠΎΠΉ ΡΠ΅Π»ΠΈ. ΠΡΠΎΡΠ²Π»ΡΠ΅ΡΡΡ ΡΠΌΠ΅ΡΠ΅Π½Π½ΠΎΠΉ Π³ΠΈΠΏΠ΅ΡΠ΅ΠΌΠΈΠ΅ΠΉ ΠΊΠΎΠ½ΡΡΠ½ΠΊΡΠΈΠ²Ρ, Π½Π΅Π±ΠΎΠ»ΡΡΠΈΠΌ ΡΠ»ΠΈΠ·ΠΈΡΡΡΠΌ ΠΎΡΠ΄Π΅Π»ΡΠ΅ΠΌΡΠΌ, Π° ΡΠ°ΠΊΠΆΠ΅ ΠΏΠΎΠΊΡΠ°ΡΠ½Π΅Π½ΠΈΠ΅ΠΌ ΠΊΠΎΠΆΠΈ Π²Π΅ΠΊ Π² ΠΎΠ±Π»Π°ΡΡΠΈ ΠΌΠ΅Π΄ΠΈΠ°Π»ΡΠ½ΠΎΠΉ ΠΈ Π»Π°ΡΠ΅ΡΠ°Π»ΡΠ½ΠΎΠΉ ΡΠΏΠ°Π΅ΠΊ. Π₯Π°ΡΠ°ΠΊΡΠ΅ΡΠΈΠ·ΡΠ΅ΡΡΡ ΠΏΠΎΠ΄ΠΎΡΡΡΡΠΌ, ΡΠ°ΡΠ΅ Ρ ΡΠΎΠ½ΠΈΡΠ΅ΡΠΊΠΈΠΌ ΡΠ΅ΡΠ΅Π½ΠΈΠ΅ΠΌ.
ΠΠΈΡΡΡΠ½ΡΠ΅ ΠΊΠΎΠ½ΡΡΠ½ΠΊΡΠΈΠ²ΠΈΡΡ. ΠΠ΄Π΅Π½ΠΎΠ²ΠΈΡΡΡΠ½ΡΠΉ ΠΊΠΎΠ½ΡΡΠ½ΠΊΡΠΈΠ²ΠΈΡ ΠΏΡΠ΅Π΄ΡΠ΅ΡΡΠ²ΡΠ΅Ρ ΠΈΠ»ΠΈ ΡΠΎΠΏΡΡΡΡΠ²ΡΠ΅Ρ ΠΏΠΎΡΠ°ΠΆΠ΅Π½ΠΈΡ Π²Π΅ΡΡ Π½ΠΈΡ Π΄ΡΡ Π°ΡΠ΅Π»ΡΠ½ΡΡ ΠΏΡΡΠ΅ΠΉ. ΠΠ½ΠΊΡΠ±Π°ΡΠΈΠΎΠ½Π½ΡΠΉ ΠΏΠ΅ΡΠΈΠΎΠ΄ 4β8Β Π΄Π½Π΅ΠΉ. ΠΠ°ΡΠΈΠ½Π°Π΅ΡΡΡ ΠΎΡΡΡΠΎ, ΠΎΡΠΌΠ΅ΡΠ°ΡΡΡΡ ΡΠ»Π΅Π·ΠΎΡΠ΅ΡΠ΅Π½ΠΈΠ΅, Π³ΠΈΠΏΠ΅ΡΠ΅ΠΌΠΈΡ ΠΈ ΠΎΡΠ΅ΠΊ ΠΊΠΎΠ½ΡΡΠ½ΠΊΡΠΈΠ²Ρ, ΠΈΠ½ΠΎΠ³Π΄Π° ΠΏΠΎΡΠ²Π»ΡΡΡΡΡ ΡΠΎΡΠ΅ΡΠ½ΡΠ΅ ΠΊΡΠΎΠ²ΠΎΠΈΠ·Π»ΠΈΡΠ½ΠΈΡ. ΠΡΠ΄Π΅Π»ΡΠ΅ΠΌΠΎΠ΅ ΡΠΊΡΠ΄Π½ΠΎΠ΅, ΡΠ»ΠΈΠ·ΠΈΡΡΠΎΠ³ΠΎ Ρ Π°ΡΠ°ΠΊΡΠ΅ΡΠ°. ΠΠ±Π½Π°ΡΡΠΆΠΈΠ²Π°ΡΡΡΡ Π²ΡΡΡΠΏΠ°Π½ΠΈΡ ΠΌΠ΅Π»ΠΊΠΈΡ ΡΠΎΠ»Π»ΠΈΠΊΡΠ»ΠΎΠ² Π½Π° Π½ΠΈΠΆΠ½Π΅ΠΉ ΠΏΠ΅ΡΠ΅Ρ ΠΎΠ΄Π½ΠΎΠΉ ΡΠΊΠ»Π°Π΄ΠΊΠ΅ ΠΊΠΎΠ½ΡΡΠ½ΠΊΡΠΈΠ²Ρ. ΠΠΎΠ½ΡΡΠΊΡΠΈΠ²ΠΈΡ ΠΎΠ±ΡΡΠ½ΠΎ Π²ΠΎΠ·Π½ΠΈΠΊΠ°Π΅Ρ Π½Π° ΠΎΠ΄Π½ΠΎΠΌ Π³Π»Π°Π·Ρ ΠΈ ΡΠ΅ΡΠ΅Π· 1β3Β Π΄Π½Ρ ΠΏΠ΅ΡΠ΅Ρ ΠΎΠ΄ΠΈΡ Π½Π° Π²ΡΠΎΡΠΎΠΉ, ΠΏΡΠΈΡΠ΅ΠΌ ΠΏΡΠΎΡΠ΅ΡΡ Π½Π° Π²ΡΠΎΡΠΎΠΌ Π³Π»Π°Π·Ρ ΠΏΡΠΎΡΠ΅ΠΊΠ°Π΅Ρ Π² Π±ΠΎΠ»Π΅Π΅ Π»Π΅Π³ΠΊΠΎΠΉ ΡΠΎΡΠΌΠ΅.
ΠΠ΄Π΅Π½ΠΎΠ²ΠΈΡΡΡΠ½ΡΠΉ ΡΠΏΠΈΠ΄Π΅ΠΌΠΈΡΠ΅ΡΠΊΠΈΠΉ ΠΊΠ΅ΡΠ°ΡΠΎΠΊΠΎΠ½ΡΡΠ½ΠΊΡΠΈΠ²ΠΈΡ Ρ Π°ΡΠ°ΠΊΡΠ΅ΡΠΈΠ·ΡΠ΅ΡΡΡ ΠΏΠΎΡΠ°ΠΆΠ΅Π½ΠΈΠ΅ΠΌ ΠΊΠΎΠ½ΡΡΠ½ΠΊΡΠΈΠ²Ρ ΠΈ ΡΠΎΠ³ΠΎΠ²ΠΈΡΡ, Π½Π° ΠΏΠ΅ΡΠΈΡΠ΅ΡΠΈΠΈ ΠΏΠΎΡΠ»Π΅Π΄Π½Π΅ΠΉ Π² ΠΏΠ΅ΡΠ²ΡΠ΅ Π΄Π²Π° Π΄Π½Ρ ΠΏΠΎΡΠ²Π»ΡΡΡΡΡ ΠΌΠ΅Π»ΠΊΠΈΠ΅ ΠΏΠΎΠ΄ΡΠΏΠΈΡΠ΅Π»ΠΈΠ°Π»ΡΠ½ΡΠ΅ ΠΈΠ½ΡΠΈΠ»ΡΡΡΠ°ΡΡ. ΠΡΠΎΡΠ΅ΡΡ ΡΠ΅Π³ΡΠ΅ΡΡΠΈΡΡΠ΅Ρ ΠΌΠ΅Π΄Π»Π΅Π½Π½ΠΎ, Π² ΡΠ΅ΡΠ΅Π½ΠΈΠ΅ Π΄Π»ΠΈΡΠ΅Π»ΡΠ½ΠΎΠ³ΠΎ Π²ΡΠ΅ΠΌΠ΅Π½ΠΈ ΠΎΡΡΠ°Π΅ΡΡΡ ΠΏΠΎΠΌΡΡΠ½Π΅Π½ΠΈΠ΅ ΡΠΎΠ³ΠΎΠ²ΠΈΡΡ.
ΠΠΏΠΈΠ΄Π΅ΠΌΠΈΡΠ΅ΡΠΊΠΈΠΉ Π³Π΅ΠΌΠΎΡΡΠ°Π³ΠΈΡΠ΅ΡΠΊΠΈΠΉ ΠΊΠΎΠ½ΡΡΠ½ΠΊΡΠΈΠ²ΠΈΡ ΠΏΡΠΎΡΠ²Π»ΡΠ΅ΡΡΡ ΠΊΡΠΎΠ²ΠΎΠΈΠ·Π»ΠΈΡΠ½ΠΈΡΠΌΠΈ Π½Π° ΠΊΠΎΠ½ΡΡΠ½ΠΊΡΠΈΠ²Π΅ Π²Π΅ΠΊ ΠΈ Π³Π»Π°Π·Π½ΠΎΠ³ΠΎ ΡΠ±Π»ΠΎΠΊΠ°, ΠΊΠΎΡΠΎΡΡΠ΅ ΡΠ°ΡΡΠ°ΡΡΠ²Π°ΡΡΡΡ Π² ΡΠ°Π·Π½ΡΠ΅ ΡΡΠΎΠΊΠΈ Π² Π·Π°Π²ΠΈΡΠΈΠΌΠΎΡΡΠΈ ΠΎΡ ΠΈΡ Π²Π΅Π»ΠΈΡΠΈΠ½Ρ (ΡΠΎΡΠ΅ΡΠ½ΡΠ΅Β β ΡΠ΅ΡΠ΅Π· 3β6Β Π΄Π½Π΅ΠΉ, ΠΎΠ±ΡΠΈΡΠ½ΡΠ΅Β β ΡΠ΅ΡΠ΅Π· 2β3Β Π½Π΅Π΄Π΅Π»ΠΈ).
ΠΠ°ΡΠ°ΡΡΠ°Ρ ΠΎΠΌΠ½ΡΠΉ ΠΊΠΎΠ½ΡΡΠ½ΠΊΡΠΈΠ²ΠΈΡ ΡΠ°ΡΠ΅ ΡΠ°Π·Π²ΠΈΠ²Π°Π΅ΡΡΡ Ρ Π½ΠΎΠ²ΠΎΡΠΎΠΆΠ΄Π΅Π½Π½ΡΡ . ΠΠ½ΡΠΈΡΠΈΡΠΎΠ²Π°Π½ΠΈΠ΅ ΠΏΡΠΎΠΈΡΡ ΠΎΠ΄ΠΈΡ Π²ΠΎ Π²ΡΠ΅ΠΌΡ ΠΏΡΠΎΡ ΠΎΠΆΠ΄Π΅Π½ΠΈΡ ΠΏΠ»ΠΎΠ΄Π° ΡΠ΅ΡΠ΅Π· ΠΏΠΎΠ»ΠΎΠ²ΡΠ΅ ΠΏΡΡΠΈ ΡΠΎΠΆΠ΅Π½ΠΈΡΡ, Π²ΠΎΠ·ΠΌΠΎΠΆΠ½ΠΎ Π·Π°ΡΠ°ΠΆΠ΅Π½ΠΈΠ΅ ΡΠ΅ΡΠ΅Π· Π²ΠΎΠ΄Ρ, Π±Π΅Π»ΡΠ΅, ΠΏΡΠ΅Π΄ΠΌΠ΅ΡΡ ΡΡΠ°Π»Π΅ΡΠ° ΠΈ Π΄Ρ. ΠΠ°Π±ΠΎΠ»Π΅Π²Π°Π½ΠΈΠ΅ Π½Π°ΡΠΈΠ½Π°Π΅ΡΡΡ ΠΎΡΡΡΠΎ, ΡΠ΅ΡΠ΅Π· 1β2Β Π½Π΅Π΄Π΅Π»ΠΈ ΠΏΠΎΡΠ»Π΅ Π·Π°ΡΠ°ΠΆΠ΅Π½ΠΈΡ Ρ Π°ΡΠ°ΠΊΡΠ΅ΡΠ½Ρ Π²ΡΡΠ°ΠΆΠ΅Π½Π½Π°Ρ ΡΠ²Π΅ΡΠΎΠ±ΠΎΡΠ·Π½Ρ, ΠΎΡΠ΅ΠΊ ΠΈ ΠΏΠΎΠΊΡΠ°ΡΠ½Π΅Π½ΠΈΠ΅ ΠΊΠΎΠΆΠΈ Π²Π΅ΠΊ ΠΈ ΠΊΠΎΠ½ΡΡΠ½ΠΊΡΠΈΠ²Ρ, Π½Π°Π»ΠΈΡΠΈΠ΅ ΡΠ»ΠΈΠ·ΠΈΡΡΠΎ-Π³Π½ΠΎΠΉΠ½ΠΎΠ³ΠΎ ΠΎΡΠ΄Π΅Π»ΡΠ΅ΠΌΠΎΠ³ΠΎ, ΠΎΠ±ΡΠ°Π·ΡΡΡΠ΅Π³ΠΎ ΠΆΠ΅Π»ΡΡΠ΅ ΠΊΠΎΡΠΎΡΠΊΠΈ, ΡΠΎΠ»Π»ΠΈΠΊΡΠ»Ρ. ΠΠ΄Π½ΠΎΠ²ΡΠ΅ΠΌΠ΅Π½Π½ΠΎ ΠΏΠΎΡΠ°ΠΆΠ°ΡΡΡΡ ΠΎΡΠ³Π°Π½Ρ ΠΌΠΎΡΠ΅ΠΏΠΎΠ»ΠΎΠ²ΠΎΠΉ ΡΠΈΡΡΠ΅ΠΌΡ, Π½ΠΎΡ, Π³Π»ΠΎΡΠΊΠ° ΠΈ Π΄Ρ.
ΠΡΠΈΠ±ΠΊΠΎΠ²ΡΠ΅ ΠΊΠΎΠ½ΡΡΠ½ΠΊΡΠΈΠ²ΠΈΡΡ Π²ΡΠ·ΡΠ²Π°ΡΡΡΡ ΡΠ°Π·Π»ΠΈΡΠ½ΡΠΌΠΈ Π²ΠΈΠ΄Π°ΠΌΠΈ Π³ΡΠΈΠ±ΠΊΠΎΠ² (Π°ΠΊΡΠΈΠ½ΠΎΠΌΠΈΡΠ΅ΡΡ, ΠΏΠ»Π΅ΡΠ½Π΅Π²ΡΠ΅, Π΄ΡΠΎΠΆΠΆΠ΅ΠΏΠΎΠ΄ΠΎΠ±Π½ΡΠ΅ ΠΈ Π΄Ρ.). ΠΡΡΠΎΡΠ½ΠΈΠΊΠΎΠΌ Π²ΠΎΠ·Π±ΡΠ΄ΠΈΡΠ΅Π»Π΅ΠΉ ΠΈΠ½ΡΠ΅ΠΊΡΠΈΠΈ ΡΠ²Π»ΡΠ΅ΡΡΡ ΠΏΠΎΡΠ²Π°, Π½Π΅ΠΊΠΎΡΠΎΡΡΠ΅ ΡΡΠ°Π²Ρ, ΠΎΠ²ΠΎΡΠΈ, ΡΡΡΠΊΡΡ, Π° ΡΠ°ΠΊΠΆΠ΅ Π±ΠΎΠ»ΡΠ½ΠΎΠΉ ΡΠ΅Π»ΠΎΠ²Π΅ΠΊ ΠΈ ΠΆΠΈΠ²ΠΎΡΠ½ΡΠ΅. ΠΡΠΎΠ±Π΅Π½Π½ΠΎΡΡΠΈ ΠΊΠ»ΠΈΠ½ΠΈΡΠ΅ΡΠΊΠΈΡ ΠΏΡΠΎΡΠ²Π»Π΅Π½ΠΈΠΉ ΠΎΠΏΡΠ΅Π΄Π΅Π»ΡΡΡΡΡ Π²ΠΈΠ΄ΠΎΠΌ Π³ΡΠΈΠ±ΠΊΠ°. Π’Π°ΠΊ, Π°ΠΊΡΠΈΠ½ΠΎΠΌΠΈΠΊΠΎΠ· ΠΏΡΠΎΡΠ²Π»ΡΠ΅ΡΡΡ ΠΊΠ°ΡΠ°ΡΠ°Π»ΡΠ½ΡΠΌ ΠΈΠ»ΠΈ Π³Π½ΠΎΠΉΠ½ΡΠΌ ΠΊΠΎΠ½ΡΡΠ½ΠΊΡΠΈΠ²ΠΈΡΠΎΠΌ, Π΄Π»Ρ Π±Π»Π°ΡΡΠΎΠΌΠΈΠΊΠΎΠ·Π° Ρ Π°ΡΠ°ΠΊΡΠ΅ΡΠ½ΠΎ ΠΎΠ±ΡΠ°Π·ΠΎΠ²Π°Π½ΠΈΠ΅ ΡΠ΅ΡΠΎΠ²Π°ΡΡΡ ΠΈΠ»ΠΈ ΠΆΠ΅Π»ΡΠΎΠ²Π°ΡΡΡ Π»Π΅Π³ΠΊΠΎΡΠ½ΠΈΠΌΠ°ΡΡΠΈΡ ΡΡ ΠΏΠ»Π΅Π½ΠΎΠΊ, ΠΊΠ°Π½Π΄ΠΈΠ΄Π°ΠΌΠΈΠΊΠΎΠ· ΠΏΡΠΎΡΠ΅ΠΊΠ°Π΅Ρ Ρ ΠΎΠ±ΡΠ°Π·ΠΎΠ²Π°Π½ΠΈΠ΅ΠΌ ΡΠ·Π΅Π»ΠΊΠΎΠ²ΡΡ ΠΈΠ½ΡΠΈΠ»ΡΡΡΠ°ΡΠΎΠ², ΡΠΎΡΡΠΎΡΡΠΈΡ Π³Π»Π°Π²Π½ΡΠΌ ΠΎΠ±ΡΠ°Π·ΠΎΠΌ ΠΈΠ· Π»ΠΈΠΌΡΠΎΠΈΠ΄Π½ΡΡ ΠΈ ΡΠΏΠΈΡΠ΅Π»ΠΈΠΎΠΈΠ΄Π½ΡΡ ΠΊΠ»Π΅ΡΠΎΠΊ, ΠΏΡΠΈ Π°ΡΠΏΠ΅ΡΠ³ΠΈΠ»Π»Π΅Π·Π΅ Π³ΠΈΠΏΠ΅ΡΠ΅ΠΌΠΈΡ ΠΊΠΎΠ½ΡΡΠ½ΠΊΡΠΈΠ²Ρ ΡΠΎΡΠ΅ΡΠ°Π΅ΡΡΡ Ρ ΠΏΠΎΡΠ°ΠΆΠ΅Π½ΠΈΠ΅ΠΌ ΡΠΎΠ³ΠΎΠ²ΠΈΡΡ.
ΠΠΈΠ°Π³Π½ΠΎΡΡΠΈΠΊΠ°
ΠΠΈΠ°Π³Π½ΠΎΠ· ΡΡΡΠ°Π½Π°Π²Π»ΠΈΠ²Π°ΡΡ Π½Π° ΠΎΡΠ½ΠΎΠ²Π°Π½ΠΈΠΈ Ρ Π°ΡΠ°ΠΊΡΠ΅ΡΠ½ΠΎΠΉ ΠΊΠ»ΠΈΠ½ΠΈΡΠ΅ΡΠΊΠΎΠΉ ΠΊΠ°ΡΡΠΈΠ½Ρ. ΠΠ»Ρ ΠΎΠΏΡΠ΅Π΄Π΅Π»Π΅Π½ΠΈΡ ΡΡΠΈΠΎΠ»ΠΎΠ³ΠΈΠΈ ΠΊΠΎΠ½ΡΡΠ½ΠΊΡΠΈΠ²ΠΈΡΠ° ΠΈΠΌΠ΅ΡΡ Π·Π½Π°ΡΠ΅Π½ΠΈΠ΅ Π΄Π°Π½Π½ΡΠ΅ Π°Π½Π°ΠΌΠ½Π΅Π·Π° (Π½Π°ΠΏΡΠΈΠΌΠ΅Ρ, ΠΊΠΎΠ½ΡΠ°ΠΊΡ Ρ Π°Π»Π»Π΅ΡΠ³Π΅Π½ΠΎΠΌ, Π·Π°Π²ΠΈΡΠΈΠΌΠΎΡΡΡ ΠΎΡ ΡΠΎΠ»Π½Π΅ΡΠ½ΠΎΠ³ΠΎ ΡΠ²Π΅ΡΠ°), ΠΎΡΠΎΠ±Π΅Π½Π½ΠΎΡΡΠΈ ΡΠ΅ΡΠ΅Π½ΠΈΡ (Π½Π°ΠΏΡΠΈΠΌΠ΅Ρ, ΡΠ΅Π·ΠΎΠ½Π½ΠΎΡΡΡ, Π½Π°Π»ΠΈΡΠΈΠ΅ ΠΏΡΠΈΠ·Π½Π°ΠΊΠΎΠ² ΠΎΠ±ΡΠ΅ΠΉ ΠΈΠ½ΡΠΎΠΊΡΠΈΠΊΠ°ΡΠΈΠΈ). ΠΡΠΈ Π²ΠΎΠ·Π½ΠΈΠΊΠ½ΠΎΠ²Π΅Π½ΠΈΠΈ Π²ΡΠΏΡΡΠ΅ΠΊ ΠΊΠΎΠ½ΡΡΠ½ΠΊΡΠΈΠ²ΠΈΡΠ° Π² Π΄Π΅ΡΡΠΊΠΈΡ ΠΊΠΎΠ»Π»Π΅ΠΊΡΠΈΠ²Π°Ρ ΠΈΠ»ΠΈ Π»Π΅ΡΠ΅Π±Π½ΡΡ ΡΡΡΠ΅ΠΆΠ΄Π΅Π½ΠΈΡΡ ΠΏΡΠΎΠ²ΠΎΠ΄ΡΡ Π»Π°Π±ΠΎΡΠ°ΡΠΎΡΠ½ΡΠ΅ ΠΈΡΡΠ»Π΅Π΄ΠΎΠ²Π°Π½ΠΈΡ. ΠΠ°ΠΈΠ±ΠΎΠ»Π΅Π΅ ΠΈΠ½ΡΠΎΡΠΌΠ°ΡΠΈΠ²Π½Ρ Π±Π°ΠΊΡΠ΅ΡΠΈΠΎΡΠΊΠΎΠΏΠΈΡΠ΅ΡΠΊΠΎΠ΅ ΠΈ Π±Π°ΠΊΡΠ΅ΡΠΈΠΎΠ»ΠΎΠ³ΠΈΡΠ΅ΡΠΊΠΎΠ΅ ΠΈΡΡΠ»Π΅Π΄ΠΎΠ²Π°Π½ΠΈΡ ΠΌΠ°Π·ΠΊΠΎΠ² ΠΈ ΠΎΡΠ΄Π΅Π»ΡΠ΅ΠΌΠΎΠ³ΠΎ ΠΊΠΎΠ½ΡΡΠ½ΠΊΡΠΈΠ²Ρ Ρ ΠΎΠΏΡΠ΅Π΄Π΅Π»Π΅Π½ΠΈΠ΅ΠΌ ΡΡΠ²ΡΡΠ²ΠΈΡΠ΅Π»ΡΠ½ΠΎΡΡΠΈ Π²ΠΎΠ·Π±ΡΠ΄ΠΈΡΠ΅Π»Ρ ΠΊ Π°Π½ΡΠΈΠ±ΠΈΠΎΡΠΈΠΊΠ°ΠΌ, Π° ΡΠ°ΠΊΠΆΠ΅ ΡΠΈΡΠΎΠ»ΠΎΠ³ΠΈΡΠ΅ΡΠΊΠΎΠ΅ ΠΈΡΡΠ»Π΅Π΄ΠΎΠ²Π°Π½ΠΈΠ΅ ΡΠΎΡΠΊΠΎΠ±ΠΎΠ² Ρ ΠΊΠΎΠ½ΡΡΠ½ΠΊΡΠΈΠ²Ρ. ΠΡΠΈ Π±Π°ΠΊΡΠ΅ΡΠΈΠ°Π»ΡΠ½ΡΡ ΠΊΠΎΠ½ΡΡΠ½ΠΊΡΠΈΠ²ΠΈΡΠ°Ρ Π² ΠΏΠΎΠ»ΡΡΠ΅Π½Π½ΠΎΠΌ ΠΌΠ°ΡΠ΅ΡΠΈΠ°Π»Π΅ ΠΏΠΎΠΌΠΈΠΌΠΎ Π±Π°ΠΊΡΠ΅ΡΠΈΠΉ ΠΎΠ±ΡΡΠ½ΠΎ ΠΎΠ±Π½Π°ΡΡΠΆΠΈΠ²Π°ΡΡ Π±ΠΎΠ»ΡΡΠΎΠ΅ ΠΊΠΎΠ»ΠΈΡΠ΅ΡΡΠ²ΠΎ Π½Π΅ΠΉΡΡΠΎΡΠΈΠ»ΠΎΠ²; ΠΈΠ·ΠΌΠ΅Π½Π΅Π½ΠΈΡ Π² ΡΠΏΠΈΡΠ΅Π»ΠΈΠ°Π»ΡΠ½ΡΡ ΠΊΠ»Π΅ΡΠΊΠ°Ρ ΠΎΡΡΡΡΡΡΠ²ΡΡΡ. ΠΡΠΈ Π²ΠΈΡΡΡΠ½ΡΡ ΠΊΠΎΠ½ΡΡΠ½ΠΊΡΠΈΠ²ΠΈΡΠ°Ρ Π½Π°Π±Π»ΡΠ΄Π°ΡΡΡΡ Π΄ΠΈΡΡΡΠΎΡΠΈΡΠ΅ΡΠΊΠΈΠ΅ ΠΈΠ·ΠΌΠ΅Π½Π΅Π½ΠΈΡ ΡΠΏΠΈΡΠ΅Π»ΠΈΡ, Π²ΡΡΡΠ΅ΡΠ°ΡΡΡΡ Π»ΠΈΠΌΡΠΎΡΠΈΡΡ, ΠΌΠΎΠ½ΠΎΡΠΈΡΡ ΠΈ Π³ΠΈΡΡΠΎΡΠΈΡΡ; ΠΏΡΠΈ Π³ΡΠΈΠ±ΠΊΠΎΠ²ΠΎΠΌ ΠΊΠΎΠ½ΡΡΠ½ΠΊΡΠΈΠ²ΠΈΡΠ΅Β β Π³ΡΠΈΠ±ΠΊΠΈ, Π½Π΅ΡΠ΅Π΄ΠΊΠΎ ΡΠ°Π³ΠΎΡΠΈΡΠΈΡΡΠ΅ΠΌΡΠ΅ Π½Π΅ΠΉΡΡΠΎΡΠΈΠ»Π°ΠΌΠΈ ΠΈ Π³ΠΈΡΡΠΈΠΎΡΠΈΡΠ°ΠΌΠΈ; ΠΏΡΠΈ Π°Π»Π»Π΅ΡΠ³ΠΈΡΠ΅ΡΠΊΠΈΡ ΠΊΠΎΠ½ΡΡΠ½ΠΊΡΠΈΠ²ΠΈΡΠ°Ρ Π² ΡΠΈΡΠΎΠ³ΡΠ°ΠΌΠΌΠ΅ ΠΏΡΠ΅ΠΎΠ±Π»Π°Π΄Π°ΡΡ ΡΠΎΠ·ΠΈΠ½ΠΎΡΠΈΠ»Ρ ΠΈ Π±Π°Π·ΠΎΡΠΈΠ»Ρ, Π΄Π»Ρ ΠΎΠΏΡΠ΅Π΄Π΅Π»Π΅Π½ΠΈΡ Π°Π½ΡΠΈΠ³Π΅Π½ΠΎΠ² Π²ΠΈΡΡΡΠΎΠ² ΠΏΡΠΈΠΌΠ΅Π½ΡΡΡ ΠΈΠΌΠΌΡΠ½ΠΎΡΠ»ΡΠΎΡΠ΅ΡΡΠ΅Π½ΡΠ½ΡΠ΅ ΠΌΠ΅ΡΠΎΠ΄Ρ ΠΈΡΡΠ»Π΅Π΄ΠΎΠ²Π°Π½ΠΈΡ, ΠΈΡΠΏΠΎΠ»ΡΠ·ΡΡΡ ΡΠ°ΠΊΠΆΠ΅ ΠΈΠΌΠΌΡΠ½ΠΎΠ»ΠΎΠ³ΠΈΡΠ΅ΡΠΊΠΈΠ΅ ΠΈ ΡΠ΅ΡΠΎΠ»ΠΎΠ³ΠΈΡΠ΅ΡΠΊΠΈΠ΅ ΠΌΠ΅ΡΠΎΠ΄Ρ.
ΠΠ΅ΡΠ΅Π½ΠΈΠ΅
ΠΠ΅ΡΠ΅Π½ΠΈΠ΅ ΠΏΡΠΎΠ²ΠΎΠ΄ΠΈΡΡΡ ΠΎΡΡΠ°Π»ΡΠΌΠΎΠ»ΠΎΠ³ΠΎΠΌ. ΠΡΠΈ ΠΎΡΡΡΡΡ Π±Π°ΠΊΡΠ΅ΡΠΈΠ°Π»ΡΠ½ΡΡ ΠΊΠΎΠ½ΡΡΠ½ΠΊΡΠΈΠ²ΠΈΡΠ°Ρ Π½Π°Π·Π½Π°ΡΠ°ΡΡ Π°Π½ΡΠΈΠ±ΠΈΠΎΡΠΈΠΊΠΈ ΠΈ ΡΡΠ»ΡΡΠ°Π½ΠΈΠ»Π°ΠΌΠΈΠ΄Π½ΡΠ΅ ΠΏΡΠ΅ΠΏΠ°ΡΠ°ΡΡ Π² Π²ΠΈΠ΄Π΅ ΠΊΠ°ΠΏΠ΅Π»Ρ. ΠΡΠΈ Π½Π°Π»ΠΈΡΠΈΠΈ ΠΎΠ±ΠΈΠ»ΡΠ½ΠΎΠ³ΠΎ ΠΎΡΠ΄Π΅Π»ΡΠ΅ΠΌΠΎΠ³ΠΎ ΠΊΠΎΠ½ΡΡΠ½ΠΊΡΠΈΠ²Π°Π»ΡΠ½ΡΠΉ ΠΌΠ΅ΡΠΎΠΊ ΠΏΡΠΎΠΌΡΠ²Π°ΡΡ ΡΠ°ΡΡΠ²ΠΎΡΠ°ΠΌΠΈ ΡΡΡΠ°ΡΠΈΠ»ΠΈΠ½Π°, ΠΏΠ΅ΡΠΌΠ°Π½Π³Π°Π½Π°ΡΠ° ΠΊΠ°Π»ΠΈΡ. ΠΡΠΏΠΎΠ»ΡΠ·ΡΡΡ ΡΠ°ΠΊΠΆΠ΅ Π»Π΅ΠΊΠ°ΡΡΡΠ²Π΅Π½Π½ΡΠ΅ ΠΏΠ»Π΅Π½ΠΊΠΈ Ρ ΡΡΠ»ΡΡΠ°Π½ΠΈΠ»Π°ΠΌΠΈΠ΄Π½ΡΠΌΠΈ ΠΏΡΠ΅ΠΏΠ°ΡΠ°ΡΠ°ΠΌΠΈ ΠΈ Π°Π½ΡΠΈΠ±ΠΈΠΎΡΠΈΠΊΠ°ΠΌΠΈ.
ΠΡΠΈ Π²ΠΈΡΡΡΠ½ΡΡ ΠΊΠΎΠ½ΡΡΠ½ΠΊΡΠΈΠ²ΠΈΡΠ°Ρ Π½Π°Π·Π½Π°ΡΠ°ΡΡ ΡΠ΅Π»ΠΎΠ²Π΅ΡΠ΅ΡΠΊΠΈΠΉ Π»Π΅ΠΉΠΊΠΎΡΠΈΡΠ°ΡΠ½ΡΠΉ ΠΈΠ½ΡΠ΅ΡΡΠ΅ΡΠΎΠ½ ΠΈΠ»ΠΈ ΠΈΠ½ΡΠ΅ΡΡΠ΅ΡΠΎΠ½ΠΎΠ³Π΅Π½Ρ Π² Π²ΠΈΠ΄Π΅ ΠΈΠ½ΡΡΠΈΠ»Π»ΡΡΠΈΠΉ Π² ΠΊΠΎΠ½ΡΡΠ½ΠΊΡΠΈΠ²Π°Π»ΡΠ½ΡΠΉ ΠΌΠ΅ΡΠΎΠΊ. ΠΡΠΈ Π³ΡΠΈΠ±ΠΊΠΎΠ²ΡΡ ΠΊΠΎΠ½ΡΡΠ½ΠΊΡΠΈΠ²ΠΈΡΠ°Ρ ΠΌΠ΅ΡΡΠ½ΠΎ Π² ΠΈΠ½ΡΡΠΈΠ»Π»ΡΡΠΈΡΡ Π² Π·Π°Π²ΠΈΡΠΈΠΌΠΎΡΡΠΈ ΠΎΡ Π²ΠΈΠ΄Π° Π³ΡΠΈΠ±ΠΊΠ° Π½Π°Π·Π½Π°ΡΠ°ΡΡ ΠΏΡΠΎΡΠΈΠ²ΠΎΠ³ΡΠΈΠ±ΠΊΠΎΠ²ΡΠ΅ ΠΌΠ°Π·ΠΈ.
ΠΡΠΎΠ³Π½ΠΎΠ· ΠΏΡΠΈ ΠΊΠΎΠ½ΡΡΠ½ΠΊΡΠΈΠ²ΠΈΡΠ°Ρ Π±Π»Π°Π³ΠΎΠΏΡΠΈΡΡΠ½ΡΠΉ; ΠΏΡΠΈ Π²ΠΎΠ²Π»Π΅ΡΠ΅Π½ΠΈΠΈ Π² ΠΏΡΠΎΡΠ΅ΡΡ ΡΠΎΠ³ΠΎΠ²ΠΈΡΡ Π²ΠΎΠ·ΠΌΠΎΠΆΠ½ΠΎ ΡΠ½ΠΈΠΆΠ΅Π½ΠΈΠ΅ Π·ΡΠ΅Π½ΠΈΡ.
ΠΡΠΎΡΠΈΠ»Π°ΠΊΡΠΈΠΊΠ°
ΠΡΠΎΡΠΈΠ»Π°ΠΊΡΠΈΠΊΠ° Π²ΠΊΠ»ΡΡΠ°Π΅Ρ ΡΠΎΠ±Π»ΡΠ΄Π΅Π½ΠΈΠ΅ ΠΏΡΠ°Π²ΠΈΠ» Π»ΠΈΡΠ½ΠΎΠΉ Π³ΠΈΠ³ΠΈΠ΅Π½Ρ ΠΈ ΡΠ°Π½ΠΈΡΠ°ΡΠ½ΠΎ-Π³ΠΈΠ³ΠΈΠ΅Π½ΠΈΡΠ΅ΡΠΊΠΈΡ ΡΡΠ΅Π±ΠΎΠ²Π°Π½ΠΈΠΉ Π² Π»Π΅ΡΠ΅Π±Π½ΡΡ ΡΡΡΠ΅ΠΆΠ΄Π΅Π½ΠΈΡΡ , Π° ΡΠ°ΠΊΠΆΠ΅ ΠΊΠΎΠΌΠΏΠ»Π΅ΠΊΡ ΠΌΠ΅ΡΠΎΠΏΡΠΈΡΡΠΈΠΉ, Π½Π°ΠΏΡΠ°Π²Π»Π΅Π½Π½ΡΡ Π½Π° ΠΏΡΠ΅Π΄ΠΎΡΠ²ΡΠ°ΡΠ΅Π½ΠΈΠ΅ ΡΠ°ΡΠΏΡΠΎΡΡΡΠ°Π½Π΅Π½ΠΈΡ ΠΈΠ½ΡΠ΅ΠΊΡΠΈΠΈ. ΠΡΠΎΡΠΈΠ»Π°ΠΊΡΠΈΠΊΠ° Ρ Π»Π°ΠΌΠΈΠ΄ΠΈΠΉΠ½ΡΡ ΠΊΠΎΠ½ΡΡΠΊΡΠΈΠ²ΠΈΡΠΎΠ² Ρ Π½ΠΎΠ²ΠΎΡΠΎΠΆΠ΄Π΅Π½Π½ΡΡ ΠΏΡΠ΅Π΄ΡΡΠΌΠ°ΡΡΠΈΠ²Π°Π΅Ρ ΡΠ²ΠΎΠ΅Π²ΡΠ΅ΠΌΠ΅Π½Π½ΠΎΠ΅ Π»Π΅ΡΠ΅Π½ΠΈΠ΅ Ρ Π»Π°ΠΌΠΈΠ΄ΠΈΠΉΠ½ΠΎΠΉ ΠΈΠ½ΡΠ΅ΠΊΡΠΈΠΈ Ρ Π±Π΅ΡΠ΅ΠΌΠ΅Π½Π½ΡΡ . ΠΡΠΈ Π°Π΄Π΅Π½ΠΎΠ²ΠΈΡΡΡΠ½ΡΡ ΠΊΠΎΠ½ΡΡΠ½ΠΊΡΠΈΠ²ΠΈΡΠ°Ρ Π½Π΅ΠΎΠ±Ρ ΠΎΠ΄ΠΈΠΌΡ ΡΠ°Π½Π½Π΅Π΅ Π²ΡΡΠ²Π»Π΅Π½ΠΈΠ΅ ΠΈ ΠΈΠ·ΠΎΠ»ΡΡΠΈΡ Π±ΠΎΠ»ΡΠ½ΡΡ , ΠΏΡΠΎΠ²Π΅Π΄Π΅Π½ΠΈΠ΅ Π² ΡΡΡΠ΅ΠΆΠ΄Π΅Π½ΠΈΠΈ ΠΏΡΠΎΡΠΈΠ²ΠΎΡΠΏΠΈΠ΄Π΅ΠΌΠΈΡΠ΅ΡΠΊΠΈΡ ΠΌΠ΅ΡΠΎΠΏΡΠΈΡΡΠΈΠΉ, Π° ΡΠ°ΠΊΠΆΠ΅ ΠΈΠ½Π΄ΠΈΠ²ΠΈΠ΄ΡΠ°Π»ΡΠ½Π°Ρ ΠΏΡΠΎΡΠΈΠ»Π°ΠΊΡΠΈΠΊΠ°.
Β© ΠΠ΅Π΄ΠΈΡΠΈΠ½ΡΠΊΠ°Ρ ΡΠ½ΡΠΈΠΊΠ»ΠΎΠΏΠ΅Π΄ΠΈΡ Π ΠΠΠ
doctorpiter.ru
ΠΠΎΠ½ΡΡΠ½ΠΊΡΠΈΠ²ΠΈΡ: Π»Π΅ΡΠ΅Π½ΠΈΠ΅, ΡΠΈΠΌΠΏΡΠΎΠΌΡ, ΠΏΡΠΈΡΠΈΠ½Ρ, Π²ΠΈΠ΄Ρ
ΠΠΎΠ½ΡΡΠ½ΠΊΡΠΈΠ²ΠΈΡ ΡΠ²Π»ΡΠ΅ΡΡΡ Π΄ΠΎΠ²ΠΎΠ»ΡΠ½ΠΎ ΡΠ°ΡΠΏΡΠΎΡΡΡΠ°Π½Π΅Π½Π½ΡΠΌ Π·Π°Π±ΠΎΠ»Π΅Π²Π°Π½ΠΈΠ΅ΠΌ Π·ΡΠΈΡΠ΅Π»ΡΠ½ΡΡ ΠΎΡΠ³Π°Π½ΠΎΠ². Π₯Π°ΡΠ°ΠΊΡΠ΅ΡΠΈΠ·ΡΠ΅ΡΡΡ Π²ΠΎΡΠΏΠ°Π»ΠΈΡΠ΅Π»ΡΠ½ΡΠΌΠΈ ΠΏΡΠΎΡΠ΅ΡΡΠ°ΠΌΠΈ Π² ΡΠΎΠ½ΠΊΠΎΠΉ ΠΏΡΠΎΠ·ΡΠ°ΡΠ½ΠΎΠΉ ΠΎΠ±ΠΎΠ»ΠΎΡΠΊΠ΅, ΠΊΠΎΡΠΎΡΠ°Ρ ΠΏΠΎΠΊΡΡΠ²Π°Π΅Ρ Π²Π΅ΠΊΠΈ ΠΈ Π³Π»Π°Π·Π½ΠΎΠ΅ ΡΠ±Π»ΠΎΠΊΠΎ. ΠΠ°Π·ΡΠ²Π°Π΅ΡΡΡ ΠΎΠ½Π° ΠΊΠΎΠ½ΡΡΠ½ΠΊΡΠΈΠ²Π°. ΠΠ½Π° ΠΎΡΠ²Π΅ΡΠ°Π΅Ρ Π·Π° Π²ΡΡΠ°Π±ΠΎΡΠΊΡ ΠΈ Π²ΡΠ΄Π΅Π»Π΅Π½ΠΈΠ΅ ΡΠ»Π΅Π·Π½ΠΎΠΉ ΠΆΠΈΠ΄ΠΊΠΎΡΡΠΈ, Π·Π°ΡΠΈΡΠ°Π΅Ρ Π³Π»Π°Π·Π° ΠΎΡ ΠΌΠΈΠΊΡΠΎΠ±ΠΎΠ², ΡΠ²Π»Π°ΠΆΠ½ΡΠ΅Ρ ΠΈ Π²ΡΠ²ΠΎΠ΄ΠΈΡ ΠΈΠ½ΠΎΡΠΎΠ΄Π½ΡΠ΅ ΡΠ΅Π»Π°. ΠΡΠΎ Π²ΡΠ΅Π³ΠΎ Π»ΠΈΡΡ ΡΠΎΠ»ΠΈΠΊΠ° ΡΠΎΠ³ΠΎ, Π·Π° ΡΡΠΎ ΠΎΡΠ²Π΅ΡΠ°Π΅Ρ ΠΊΠΎΠ½ΡΡΠ½ΠΊΡΠΈΠ²Π°. ΠΠ½Π° ΡΠΎΡΡΠΎΠΈΡ ΠΈΠ· Π½Π΅ΡΠΊΠΎΠ»ΡΠΊΠΈΡ ΡΠ»Π΅ΠΌΠ΅Π½ΡΠΎΠ². ΠΠΎΠ½ΡΡΠ½ΠΊΡΠΈΠ²ΠΈΡ β ΡΠΎΡΠΎ:
ΠΡΠΈΡΠΈΠ½Ρ ΠΈ Π²ΠΈΠ΄Ρ ΠΊΠΎΠ½ΡΡΠ½ΠΊΡΠΈΠ²ΠΈΡΠ°
ΠΠΎΠ½ΡΡΠ½ΠΊΡΠΈΠ²ΠΈΡ Π³Π»Π°Π· Π²ΠΎΠ·Π½ΠΈΠΊΠ°Π΅Ρ ΠΏΠΎ ΠΌΠ½ΠΎΠΆΠ΅ΡΡΠ²Π΅Π½Π½ΡΠΌ ΠΏΡΠΈΡΠΈΠ½Π°ΠΌ, ΠΈΡΡ ΠΎΠ΄Ρ ΠΈΠ· ΡΠ΅Π³ΠΎ, Π΄Π΅Π»ΠΈΡΡΡ Π½Π° ΡΠ»Π΅Π΄ΡΡΡΠΈΠ΅ Π²ΠΈΠ΄Ρ:
- ΠΠ΄Π΅Π½ΠΎΠ²ΠΈΡΡΡΠ½ΡΠΉ ΡΠΈΠΏ Π²ΠΎΠ·Π½ΠΈΠΊΠ°Π΅Ρ Π½Π° ΡΠΎΠ½Π΅ ΠΈΠ½ΡΠΈΡΠΈΡΠΎΠ²Π°Π½ΠΈΡ Π²ΠΎΠ·Π±ΡΠ΄ΠΈΡΠ΅Π»Π΅ΠΌ ΠΏΠΎΠ΄ Π½Π°Π·Π²Π°Π½ΠΈΠ΅ΠΌ Π°Π΄Π΅Π½ΠΎΠ²ΠΈΡΡΡ. ΠΠ΅ΡΠ΅Π΄Π°Π΅ΡΡΡ ΠΊΠ°ΠΏΠ΅Π»ΡΠ½ΠΎ-Π²ΠΎΠ·Π΄ΡΡΠ½ΡΠΌ ΠΏΡΡΠ΅ΠΌ, ΠΏΠΎΡΡΠΎΠΌΡ ΠΎΠ±Π½Π°ΡΡΠΆΠΈΠ²Π°Π΅ΡΡΡ Π΄ΠΎΠ²ΠΎΠ»ΡΠ½ΠΎ ΡΠ°ΡΡΠΎ.
- ΠΠ»Π»Π΅ΡΠ³ΠΈΡΠ΅ΡΠΊΠΈΠΉ ΡΠΈΠΏ ΡΠ°Π·Π²ΠΈΠ²Π°Π΅ΡΡΡ ΠΏΡΠΈ ΠΊΠΎΠ½ΡΠ°ΠΊΡΠΈΡΠΎΠ²Π°Π½ΠΈΠΈ Ρ Π°Π»Π»Π΅ΡΠ³Π΅Π½Π°ΠΌΠΈ Π»ΡΠ±ΠΎΠΉ ΡΡΠΈΠΎΠ»ΠΎΠ³ΠΈΠΈ.
- ΠΠ°ΠΊΡΠ΅ΡΠΈΠ°Π»ΡΠ½ΡΠΉ ΡΠΈΠΏ ΠΏΡΠΎΠ²ΠΎΡΠΈΡΡΠ΅ΡΡΡ Π·Π°ΡΠ°ΠΆΠ΅Π½ΠΈΠ΅ΠΌ Π±Π°ΠΊΡΠ΅ΡΠΈΡΠΌΠΈ: ΡΡΡΠ΅ΠΏΡΠΎΠΊΠΎΠΊΠΊ, Π³ΠΎΠ½ΠΎΠΊΠΎΠΊΠΊ, ΡΡΠ°ΡΠΈΠ»ΠΎΠΊΠΎΠΊΠΊ, Π΄ΠΈΡΡΠ΅ΡΠΈΡ, ΠΏΠ½Π΅Π²ΠΌΠΎΠΊΠΎΠΊΠΊ ΠΈ ΠΏΡΠΎΡΠ΅Π΅.
- Π₯Π»Π°ΠΌΠΈΠ΄ΠΈΠΉΠ½ΡΠΉ ΡΠΈΠΏ Π²ΠΎΠ·Π½ΠΈΠΊΠ°Π΅Ρ ΠΈΠ·-Π·Π° ΠΈΠ½ΡΠΈΡΠΈΡΠΎΠ²Π°Π½ΠΈΡ Ρ Π»Π°ΠΌΠΈΠ΄ΠΈΡΠΌΠΈ.
- ΠΠ½Π³ΡΠ»ΡΡΠ½ΡΠΉ ΡΠΈΠΏ ΡΠ°Π·Π²ΠΈΠ²Π°Π΅ΡΡΡ Π½Π° ΡΠΎΠ½Π΅ Π·Π°ΡΠ°ΠΆΠ΅Π½ΠΈΡ Π΄ΠΈΠΏΠ»ΠΎΠ±Π°ΡΠΈΠ»Π»Π°ΠΌΠΈ Β«ΠΠΎΡΠ°ΠΊΡ-ΠΠΊΡΠ΅Π½ΡΠ΅Π»ΡΠ΄Π°Β».
- ΠΠΈΡΡΡΠ½ΡΠΉ ΡΠΈΠΏ Ρ Π°ΡΠ°ΠΊΡΠ΅ΡΠΈΠ·ΡΠ΅ΡΡΡ ΠΏΠΎΠΏΠ°Π΄Π°Π½ΠΈΠ΅ΠΌ Π² ΠΎΡΠ³Π°Π½ΠΈΠ·ΠΌ ΡΠ°Π·Π»ΠΈΡΠ½ΡΡ Π²ΠΈΡΡΡΠΎΠ² β Π³Π΅ΡΠΏΠ΅Ρ ΠΈ ΠΏΡ.
- ΠΡΠΈΠ±ΠΊΠΎΠ²ΡΠΉ ΡΠΈΠΏ. Π ΡΡΠΎΠΌ ΡΠ»ΡΡΠ°Π΅ Π²ΠΎΡΠΏΠ°Π»ΡΠ΅ΡΡΡ ΡΠ»ΠΈΠ·ΠΈΡΡΠ°Ρ ΠΎΠ±ΠΎΠ»ΠΎΡΠΊΠ° ΠΈΠ·-Π·Π° Π³ΡΠΈΠ±ΠΊΠΎΠ² ΡΠ°Π·Π»ΠΈΡΠ½ΠΎΠΉ ΠΏΡΠΈΡΠΎΠ΄Ρ: ΠΊΠ°Π½Π΄ΠΈΠ΄Π°ΠΌΠΈΠΊΠΎΠ·, Π°ΠΊΡΠΈΠ½ΠΎΠΌΠΈΠΊΠΎΠ·, ΡΠΏΠΈΡΠΎΡΡΠΈΡ Π΅Π»Π΅Π· ΠΈ ΠΌΠ½ΠΎΠ³ΠΎΠ΅ Π΄ΡΡΠ³ΠΎΠ΅.
- ΠΠΈΡΡΡΠΎΡΠΈΡΠ΅ΡΠΊΠΈΠΉ ΡΠΈΠΏ ΡΠ°Π·Π²ΠΈΠ²Π°Π΅ΡΡΡ ΠΊΠ°ΠΊ ΡΠ΅Π°ΠΊΡΠΈΡ Π½Π° ΠΊΠΎΠ½ΡΠ°ΠΊΡΠΈΡΠΎΠ²Π°Π½ΠΈΠ΅ Ρ Π»Π°ΠΊΠΎΠΊΡΠ°ΡΡΡΠΈΠΌΠΈ Π²Π΅ΡΠ΅ΡΡΠ²Π°ΠΌΠΈ, ΡΠ΅Π°ΠΊΡΠΈΠ²Π°ΠΌΠΈ, Π³Π°Π·ΠΎΠΌ, Ρ ΠΈΠΌΠΈΠΊΠ°ΡΠ°ΠΌΠΈ ΠΈ Ρ. Π΄.
- ΠΠΏΠΈΠ΄Π΅ΠΌΠΈΡΠ΅ΡΠΊΠΈΠΉ ΡΠΈΠΏ. ΠΡΠΈΡΠΈΠ½Π° β ΠΏΠ°Π»ΠΎΡΠΊΠ° ΠΠΎΡ Π°-Π£ΠΈΠΊΡΠ°.
- ΠΠ½ΠΎΠΉΠ½ΡΠΉ ΡΠΈΠΏ Π²ΡΠ·Π²Π°Π½ Π±Π°ΠΊΡΠ΅ΡΠΈΡΠΌΠΈ. ΠΠΎ Π² ΡΡΠΎΠΌ ΡΠ»ΡΡΠ°Π΅ ΠΎΠ±ΠΈΠ»ΡΠ½ΠΎ Π²ΡΠ΄Π΅Π»ΡΠ΅ΡΡΡ Π³Π½ΠΎΠΉΠ½Π°Ρ ΠΆΠΈΠ΄ΠΊΠΎΡΡΡ.

Π‘ΠΈΠΌΠΏΡΠΎΠΌΠ°ΡΠΈΠΊΠ° ΠΊΠΎΠ½ΡΡΠ½ΠΊΡΠΈΠ²ΠΈΡΠ°
ΠΠΎΠ½ΡΡΠ½ΠΊΡΠΈΠ²ΠΈΡ ΠΏΡΠΎΡΠ²Π»ΡΠ΅Ρ ΠΏΡΠΈΠ·Π½Π°ΠΊΠΈ Π² Π·Π°Π²ΠΈΡΠΈΠΌΠΎΡΡΠΈ ΠΎΡ Π²ΠΈΠ΄Π° ΠΈ ΡΠΎΡΠΌΡ Π·Π°Π±ΠΎΠ»Π΅Π²Π°Π½ΠΈΡ, ΠΎΠ΄Π½Π°ΠΊΠΎ ΡΡΡΠ΅ΡΡΠ²ΡΡΡ ΠΈ ΠΎΡΠ½ΠΎΠ²Π½ΡΠ΅ ΡΠΈΠΌΠΏΡΠΎΠΌΡ ΠΊΠΎΠ½ΡΡΠ½ΠΊΡΠΈΠ²ΠΈΡΠ°. ΠΡΠΎ ΠΏΠΎΠ²ΡΡΠ΅Π½Π½ΠΎΠ΅ ΡΠ»Π΅Π·ΠΎΡΠ΅ΡΠ΅Π½ΠΈΠ΅ ΠΈ Π±ΠΎΡΠ·Π½Ρ ΡΠ²Π΅ΡΠ°. ΠΡΡΡΠ½ΠΎΡΡΡ Π²Π΅ΠΊ ΠΈ Π½Π΅ΠΏΠΎΡΡΠ΅Π΄ΡΡΠ²Π΅Π½Π½ΠΎ ΠΊΠΎΠ½ΡΡΠ½ΠΊΡΠΈΠ²Ρ. ΠΠΎΠΊΡΠ°ΡΠ½Π΅Π½ΠΈΠ΅ ΠΈ ΠΆΠΆΠ΅Π½ΠΈΠ΅. Π Π·Π°Π²ΠΈΡΠΈΠΌΠΎΡΡΠΈ ΠΎΡ Π²ΠΈΠ΄Π° ΠΏΡΠΈΠ·Π½Π°ΠΊΠΈ ΠΌΠΎΠ³ΡΡ Π±ΡΡΡ ΡΠ°ΠΊΠΈΠΌΠΈ:
- ΠΠΎΠ½ΡΡΠ½ΠΊΡΠΈΠ²ΠΈΡ Π°Π»Π»Π΅ΡΠ³ΠΈΡΠ΅ΡΠΊΠΈΠΉ: ΡΠ°Π·Π΄ΡΠ°ΠΆΠ΅Π½ΠΈΠ΅, Π·ΡΠ΄, Π±ΠΎΠ»Ρ, ΠΎΡΡΡΠ½ΠΎΡΡΡ.
- ΠΠΈΡΡΡΠ½Π°Ρ ΡΠΎΡΠΌΠ° β ΡΠ»Π΅Π·ΠΎΡΠ΅ΡΠ΅Π½ΠΈΠ΅ ΠΈ Π·ΡΠ΄, Π±ΠΎΠ»Π΅Π²ΠΎΠΉ ΡΠΈΠ½Π΄ΡΠΎΠΌ Π½Π΅ ΡΠΎΠ»ΡΠΊΠΎ Π² Π·ΡΠΈΡΠ΅Π»ΡΠ½ΠΎΠΌ ΠΎΡΠ³Π°Π½Π΅, Π½ΠΎ ΠΈ Π΄ΡΡ Π°ΡΠ΅Π»ΡΠ½ΡΡ ΠΏΡΡΡΡ , ΠΏΠΎΠ²ΡΡΠ΅Π½ΠΈΠ΅ ΡΠ΅ΠΌΠΏΠ΅ΡΠ°ΡΡΡΡ ΡΠ΅Π»Π°, ΡΠ²Π΅Π»ΠΈΡΠ΅Π½ΠΈΠ΅ Π»ΠΈΠΌΡΠΎΡΠ·Π»ΠΎΠ². Π ΡΠ°ΠΊΠΆΠ΅ Π½Π΅Π²ΠΎΠ·ΠΌΠΎΠΆΠ½ΠΎΡΡΡ ΡΠΎΠΌΠΊΠ½ΡΡΡ Π²Π΅ΠΊΠΈ, Π½Π΅Π±ΠΎΠ»ΡΡΠΈΠ΅ Π²ΡΠ΄Π΅Π»Π΅Π½ΠΈΡ ΠΈΠ· Π³Π»Π°Π·, Π½ΠΎ Π±Π΅Π· Π³Π½ΠΎΡ.
- ΠΠ°ΠΊΡΠ΅ΡΠΈΠ°Π»ΡΠ½Π°Ρ ΡΠΎΡΠΌΠ° β ΡΠ΅ΡΡΠ΅, ΠΆΠ΅Π»ΡΡΠ΅, Π½Π΅ΠΏΡΠΎΠ·ΡΠ°ΡΠ½ΡΠ΅ ΠΈ Π²ΡΠ·ΠΊΠΈ Π²ΡΠ΄Π΅Π»Π΅Π½ΠΈΡ, ΡΠ»ΠΈΠΏΠ°Π½ΠΈΠ΅ Π²Π΅ΠΊ ΠΈ ΠΏΠΎΠ²ΡΡΠ΅Π½Π½Π°Ρ ΡΡΡ ΠΎΡΡΡ Π³Π»Π°Π·.
- ΠΠΈΡΡΡΠΎΡΠΈΡΠ΅ΡΠΊΠΈΠΉ (ΡΠΎΠΊΡΠΈΡΠ΅ΡΠΊΠΈΠΉ) ΡΠΈΠΏ: Π½Π΅Π²ΠΎΠ·ΠΌΠΎΠΆΠ½ΠΎΡΡΡ ΠΏΠΎΠ΄Π½ΡΡΡ Π³Π»Π°Π·Π° Π²Π²Π΅ΡΡ ΠΈΠ·-Π·Π° Π±ΠΎΠ»Π΅Π²ΠΎΠ³ΠΎ ΡΠΈΠ½Π΄ΡΠΎΠΌΠ°, ΡΠ°Π·Π΄ΡΠ°ΠΆΠ΅Π½ΠΈΠ΅.
- ΠΠΏΠΈΠ΄Π΅ΠΌΠΈΡΠ΅ΡΠΊΠΈΠΉ ΡΠΈΠΏ β ΠΌΠ΅Π»ΠΊΠΈΠ΅ ΠΊΡΠΎΠ²ΠΎΠΈΠ·Π»ΠΈΡΠ½ΠΈΡ, ΠΎΡΡΡΠ½ΠΎΡΡΡ. ΠΠΎ Π²Π½Π΅ΡΠ½Π΅ΠΌΡ Π²ΠΈΠ΄Ρ Π³Π»Π°Π·Π½Π°Ρ ΡΠ΅Π»Ρ ΠΏΡΠΈΠΎΠ±ΡΠ΅ΡΠ°Π΅Ρ ΡΡΠ΅ΡΠ³ΠΎΠ»ΡΠ½ΡΡ ΡΠΎΡΠΌΡ.
- ΠΠ½Π³ΡΠ»ΡΡΠ½ΡΠΉ ΡΠΈΠΏ β Π²ΡΠ΄Π΅Π»Π΅Π½ΠΈΡ ΠΈΡΠΊΠ»ΡΡΠΈΡΠ΅Π»ΡΠ½ΠΎ Π² ΡΠ³ΠΎΠ»ΠΊΠ°Ρ Π³Π»Π°Π·.
ΠΠ°ΠΊ Π»Π΅ΡΠΈΡΡ ΠΊΠΎΠ½ΡΡΠ½ΠΊΡΠΈΠ²ΠΈΡ
ΠΠΠΠΠΠΠΠ! Π ΡΠΎΠΌ, ΠΊΠ°ΠΊ Π»Π΅ΡΠΈΡΡ ΠΊΠΎΠ½ΡΡΠ½ΠΊΡΠΈΠ²ΠΈΡ, ΠΌΠΎΠΆΠ½ΠΎ Π³ΠΎΠ²ΠΎΡΠΈΡΡ Π΄ΠΎ Π±Π΅ΡΠΊΠΎΠ½Π΅ΡΠ½ΠΎΡΡΠΈ, ΠΏΠΎΡΠΎΠΌΡ ΡΡΠΎ ΡΠ΅Π³ΠΎΠ΄Π½Ρ ΡΡΡΠ΅ΡΡΠ²ΡΠ΅Ρ ΠΌΠ½ΠΎΠΆΠ΅ΡΡΠ²ΠΎ ΠΏΡΠ΅ΠΏΠ°ΡΠ°ΡΠΎΠ² Π΄Π»Ρ ΡΡΠΎΠ³ΠΎ. ΠΠ΄Π½Π°ΠΊΠΎ Π½ΡΠΆΠ½ΠΎ Π·Π½Π°ΡΡ, ΡΡΠΎ Π²ΡΠ±ΠΎΡ ΠΌΠ΅Π΄ΠΈΠΊΠ°ΠΌΠ΅Π½ΡΠΎΠ² Π΄ΠΎΠ»ΠΆΠ΅Π½ ΠΎΡΠ½ΠΎΠ²ΡΠ²Π°ΡΡΡΡ ΠΈΡΠΊΠ»ΡΡΠΈΡΠ΅Π»ΡΠ½ΠΎ Π½Π° Π΄Π°Π½Π½ΡΡ ΠΎΠ±ΡΠ»Π΅Π΄ΠΎΠ²Π°Π½ΠΈΡ. ΠΠ΅Π΄Ρ ΡΡΡΠ΅ΡΡΠ²ΡΠ΅Ρ Π³ΡΠΎΠΌΠ°Π΄Π½ΠΎΠ΅ ΠΊΠΎΠ»ΠΈΡΠ΅ΡΡΠ²ΠΎ Π²ΠΈΠ΄ΠΎΠ² ΠΈ ΡΠΎΡΠΌ Π·Π°Π±ΠΎΠ»Π΅Π²Π°Π½ΠΈΡ. ΠΡΠ»ΠΈ, Π½Π°ΠΏΡΠΈΠΌΠ΅Ρ, Π»Π΅ΡΠΈΡΡ Π³ΡΠΈΠ±ΠΊΠΎΠ²ΡΠΉ Π²ΠΈΠ΄ ΠΏΡΠΎΡΠΈΠ²ΠΎΠ²ΠΈΡΡΡΠ½ΡΠΌΠΈ ΠΏΡΠ΅ΠΏΠ°ΡΠ°ΡΠ°ΠΌΠΈ, ΡΠΎ ΠΏΠΎΠ»ΠΎΠΆΠΈΡΠ΅Π»ΡΠ½ΠΎΠ³ΠΎ ΡΡΡΠ΅ΠΊΡΠ° Π²Ρ Π½Π΅ ΠΏΠΎΠ»ΡΡΠΈΡΠ΅. ΠΠ°ΠΎΠ±ΠΎΡΠΎΡ, Π³Π»Π°Π·Π°ΠΌ ΠΌΠΎΠΆΠ½ΠΎ Π½Π°Π½Π΅ΡΡΠΈ Π²ΡΠ΅Π΄. ΠΠΌΠ΅Π½Π½ΠΎ ΠΏΠΎ ΡΡΠΈΠΌ ΠΏΡΠΈΡΠΈΠ½Π°ΠΌ ΠΊΠ°ΡΠ΅Π³ΠΎΡΠΈΡΠ΅ΡΠΊΠΈ Π·Π°ΠΏΡΠ΅ΡΠ΅Π½ΠΎ Π·Π°Π½ΠΈΠΌΠ°ΡΡΡΡ ΡΠ°ΠΌΠΎΠ»Π΅ΡΠ΅Π½ΠΈΠ΅ΠΌ. ΠΠ°ΠΏΠΎΠΌΠ½ΠΈΡΠ΅, ΠΏΡΠΈ Π»ΡΠ±ΡΡ ΠΏΠ°ΡΠΎΠ»ΠΎΠ³ΠΈΡΠ΅ΡΠΊΠΈΡ ΠΎΡΠΊΠ»ΠΎΠ½Π΅Π½ΠΈΡΡ Π½Π΅Π·Π°ΠΌΠ΅Π΄Π»ΠΈΡΠ΅Π»ΡΠ½ΠΎ ΠΎΠ±ΡΠ°ΡΠ°ΠΉΡΠ΅ΡΡ ΠΊ ΠΎΡΡΠ°Π»ΡΠΌΠΎΠ»ΠΎΠ³Ρ. Π’ΠΎΠ»ΡΠΊΠΎ ΠΎΠ½ ΠΌΠΎΠΆΠ΅Ρ ΠΏΠΎΡΡΠ°Π²ΠΈΡΡ ΡΠΎΡΠ½ΡΠΉ Π΄ΠΈΠ°Π³Π½ΠΎΠ·!

ΠΡΠ½ΠΎΠ²Π½ΡΠΌΠΈ ΠΏΡΠΈΠ½ΡΠΈΠΏΠ°ΠΌΠΈ Π»Π΅ΡΠ΅Π½ΠΈΡ ΠΊΠΎΠ½ΡΡΠ½ΠΊΡΠΈΠ²ΠΈΡΠ° Π³Π»Π°Π· ΡΠ²Π»ΡΠ΅ΡΡΡ ΡΡΡΡΠ°Π½Π΅Π½ΠΈΠ΅ ΡΠΈΠΌΠΏΡΠΎΠΌΠ°ΡΠΈΠΊΠΈ ΠΈ ΠΏΡΠΈΡΠΈΠ½Ρ Π²ΠΎΠ·Π½ΠΈΠΊΠ½ΠΎΠ²Π΅Π½ΠΈΡ:
- Π§ΡΠΎΠ±Ρ ΡΠ½ΠΈΠ·ΠΈΡΡ Π²ΠΎΡΠΏΠ°Π»ΠΈΡΠ΅Π»ΡΠ½ΡΠΉ ΠΏΡΠΎΡΠ΅ΡΡ ΠΈΡΠΏΠΎΠ»ΡΠ·ΡΡΡΡΡ ΠΏΡΠ΅ΠΏΠ°ΡΠ°ΡΡ ΠΌΠ΅ΡΡΠ½ΠΎΠ³ΠΎ Π½Π°Π·Π½Π°ΡΠ΅Π½ΠΈΡ, ΡΠΎ Π΅ΡΡΡ ΠΊΠ°ΠΏΠ»ΠΈ ΠΈ ΠΌΠ°Π·ΠΈ. ΠΠ½ΠΈ ΡΠΏΠΎΡΠΎΠ±ΡΡΠ²ΡΡΡ Π½Π΅ΠΉΡΡΠ°Π»ΠΈΠ·Π°ΡΠΈΠΈ ΡΠΈΠΌΠΏΡΠΎΠΌΠΎΠ². ΠΠ΅ΡΠ²ΠΎΠΉ Π·Π°Π΄Π°ΡΠ΅ΠΉ ΡΡΠΈΡΠ°Π΅ΡΡΡ ΠΊΡΠΏΠΈΡΠΎΠ²Π°Π½ΠΈΠ΅ Π±ΠΎΠ»Π΅Π²ΠΎΠ³ΠΎ ΡΠΈΠ½Π΄ΡΠΎΠΌΠ°. ΠΠ»Ρ ΡΡΠΎΠ³ΠΎ ΠΈΡΠΏΠΎΠ»ΡΠ·ΡΡΡΡΡ Π³Π»Π°Π·Π½ΡΠ΅ Π°Π½Π΅ΡΡΠ΅ΡΠΈΡΠ΅ΡΠΊΠΈΠ΅ ΠΊΠ°ΠΏΠ»ΠΈ, ΠΊΠΎΡΠΎΡΡΠ΅ Π²Π²ΠΎΠ΄ΡΡΡΡ Π² Π³Π»Π°Π·Π½ΠΎΠΉ ΠΌΠ΅ΡΠΎΠΊ. ΠΡΠΎ ΠΌΠΎΠΆΠ΅Ρ Π±ΡΡΡ Β«Π’ΡΠΈΠΌΠ΅ΠΊΠ°ΠΈΠ½Β» ΠΈΠ»ΠΈ Β«ΠΠΈΡΠΎΠΌΠ΅ΠΊΠ°ΠΈΠ½Β».
- Π‘Π»Π΅Π΄ΡΡΡΠΈΠΌ ΡΠ°Π³ΠΎΠΌ ΡΡΠΈΡΠ°Π΅ΡΡΡ ΠΎΠ±ΡΠ°Π±ΠΎΡΠΊΠ° Π²Π΅ΠΊΠ° ΠΈ ΡΠ»ΠΈΠ·ΠΈΡΡΡΡ ΠΎΠ±ΠΎΠ»ΠΎΡΠ΅ΠΊ. ΠΠ»Ρ ΡΡΠΎΠ³ΠΎ ΡΡΡΠ΅ΡΡΠ²ΡΡΡ Π°Π½ΡΠΈΡΠ΅ΠΏΡΠΈΡΠ΅ΡΠΊΠΈΠ΅ ΡΠ°ΡΡΠ²ΠΎΡΡ. Π Π·Π°Π²ΠΈΡΠΈΠΌΠΎΡΡΠΈ ΠΎΡ Π²ΠΈΠ΄Π° Π·Π°Π±ΠΎΠ»Π΅Π²Π°Π½ΠΈΡ ΠΌΠΎΠΆΠ΅Ρ Π±ΡΡΡ Π½Π°Π·Π½Π°ΡΠ΅Π½ Β«Π€ΡΡΠ°ΡΠΈΠ»ΠΈΠ½Β», Β«ΠΠΊΡΠΈΡΠΈΠ°Π½Π°ΡΒ», Β«ΠΡΠΈΠ»Π»ΠΈΠ°Π½ΡΠΎΠ²Π°Ρ Π·Π΅Π»Π΅Π½ΡΒ», Β«ΠΠΈΠΌΠ΅ΠΊΡΠΈΠ΄Β», Β«ΠΠ΅ΡΠΌΠ°Π½Π³Π°Π½Π°Ρ ΠΊΠ°Π»ΠΈΡΒ».
- Π’Π΅ΠΏΠ΅ΡΡ ΠΏΡΠΈΡΠ»ΠΎ Π²ΡΠ΅ΠΌΡ Π½Π΅ΠΉΡΡΠ°Π»ΠΈΠ·Π°ΡΠΈΠΈ Π²ΠΎΠ·Π±ΡΠ΄ΠΈΡΠ΅Π»Ρ. ΠΡΠΎ ΠΌΠΎΠ³ΡΡ Π±ΡΡΡ ΠΏΡΠΎΡΠΈΠ²ΠΎΠ²ΠΈΡΡΡΠ½ΡΠ΅, Π°Π½ΡΠΈΠ±Π°ΠΊΡΠ΅ΡΠΈΠ°Π»ΡΠ½ΡΠ΅, Π°Π½ΡΠΈΠ³ΠΈΡΡΠ°ΠΌΠΈΠ½Π½ΡΠ΅ ΠΏΡΠ΅ΠΏΠ°ΡΠ°ΡΡ. ΠΡΠΏΠΎΠ»ΡΠ·ΡΡΡΡΡ ΡΡΠ»ΡΡΠ°Π½ΠΈΠ»Π°ΠΌΠΈΠ΄Ρ, Π°Π½ΡΠΈΠ±ΠΈΠΎΡΠΈΠΊΠΈ ΠΈ ΠΏΡΠΎΡΠ΅Π΅. ΠΠ°ΠΏΡΠΈΠΌΠ΅Ρ. ΠΡΠ»ΠΈ ΠΊΠΎΠ½ΡΡΠ½ΠΊΡΠΈΠ²ΠΈΡ Π±Π°ΠΊΡΠ΅ΡΠΈΠ°Π»ΡΠ½ΡΠΉ, ΡΠΎΠ³Π΄Π° ΠΏΡΠΈΠΌΠ΅Π½ΡΡΡΡΡ Π°Π½ΡΠΈΠ±ΠΈΠΎΡΠΈΠΊΠΈ. ΠΠ°ΠΏΡΠΈΠΌΠ΅Ρ, Β«Π€Π»ΠΎΠΊΡΠ°Π»Β», ΠΊΠΎΡΠΎΡΡΠΉ ΠΎΠ±Π»Π°Π΄Π°Π΅Ρ ΠΌΠΎΡΠ½ΡΠΌ Π°Π½ΡΠΈΠΌΠΈΠΊΡΠΎΠ±Π½ΡΠΌ Π΄Π΅ΠΉΡΡΠ²ΠΈΠ΅ΠΌ. ΠΡΠ΅Π½Ρ Π²Π°ΠΆΠ½ΠΎ ΠΏΡΠΈ ΡΡΠΎΠΌ ΡΠ»Π΅Π΄ΠΎΠ²Π°ΡΡ ΡΠ΅ΠΊΠΎΠΌΠ΅Π½Π΄Π°ΡΠΈΡΠΌ ΠΎΡΡΠ°Π»ΡΠΌΠΎΠ»ΠΎΠ³Π°, ΡΠ°ΠΊ ΠΊΠ°ΠΊ ΠΏΠ°ΡΠΎΠ³Π΅Π½Π½ΡΠ΅ Π±Π°ΠΊΡΠ΅ΡΠΈΠΈ Π΄ΠΎΠ²ΠΎΠ»ΡΠ½ΠΎ Π±ΡΡΡΡΠΎ Π°Π΄Π°ΠΏΡΠΈΡΡΡΡΡΡ ΠΊ ΡΠ°Π·Π»ΠΈΡΠ½ΡΠΌ ΡΡΠ΅Π΄ΡΡΠ²Π°ΠΌ, Π² ΡΠ΅Π·ΡΠ»ΡΡΠ°ΡΠ΅ ΡΠ΅Π³ΠΎ Π½Π΅Π»ΡΠ·Ρ ΠΊΠ°ΠΏΠ°ΡΡ Π³Π»Π°Π·Π° Π±ΠΎΠ»Π΅Π΅ Π½Π΅Π΄Π΅Π»ΠΈ. ΠΡΠΈ Π²ΠΈΡΡΡΠ½ΠΎΠΌ ΡΠΈΠΏΠ΅ Π·Π°Π±ΠΎΠ»Π΅Π²Π°Π½ΠΈΡ ΡΠ΅ΠΊΠΎΠΌΠ΅Π½Π΄ΠΎΠ²Π°Π½Ρ ΠΏΡΠΎΡΠΈΠ²ΠΎΠ²ΠΈΡΡΡΠ½ΡΠ΅ ΡΡΠ΅Π΄ΡΡΠ²Π°. ΠΠ°ΠΏΡΠΈΠΌΠ΅Ρ, Β«Π€Π»ΠΎΡΠ΅Π½Π°Π»ΡΒ», Β«ΠΠ΅ΡΠ΅ΡΠΈΠ΄Β», Β«ΠΠ½ΡΠ΅ΡΡΠ΅ΡΠΎΠ½Β». ΠΡΠ»ΠΈ ΡΡΠΎ Π°Π»Π»Π΅ΡΠ³ΠΈΡΠ΅ΡΠΊΠΈΠΉ ΡΠΈΠΏ, ΡΠΎΠ³Π΄Π° ΠΏΠΎΡΡΠ΅Π±ΡΡΡΡΡ ΠΏΡΠ΅ΠΏΠ°ΡΠ°ΡΡ Ρ Π°Π½ΡΠΈΠ³ΠΈΡΡΠ°ΠΌΠΈΠ½Π½ΡΠΌΠΈ ΡΠ²ΠΎΠΉΡΡΠ²Π°ΠΌΠΈ: Β«ΠΠΈΠ±Π°Π·ΠΎΠ»Β», Β«ΠΠΈΠΌΠ΅Π΄ΡΠΎΠ»Β» ΠΈ ΠΏΡΠΎΡΠ΅Π΅. Π’Π°ΠΊΠΆΠ΅ ΡΡΠΎ ΠΌΠΎΠ³ΡΡ Π±ΡΡΡ ΠΊΠ°ΠΏΠ»ΠΈ ΠΊΠΎΡΡΠΈΠΊΠΎΡΡΠ΅ΡΠΎΠΈΠ΄Π½ΠΎΠ³ΠΎ Π½Π°ΠΏΡΠ°Π²Π»Π΅Π½ΠΈΡ.
- ΠΠ°ΡΠΈΠ΅Π½Ρ ΠΎΠ±ΡΠ·Π°Π½ Π²ΠΎ Π²ΡΠ΅ΠΌΡ Π»Π΅ΡΠ΅Π½ΠΈΡ ΠΊΠΎΠ½ΡΡΠ½ΠΊΡΠΈΠ²ΠΈΡΠ° ΡΠΎΠ±Π»ΡΠ΄Π°ΡΡ ΠΏΡΠΎΡΡΡΠ΅ ΠΏΡΠ°Π²ΠΈΠ»Π°. ΠΡΠΎ ΡΠΎΠ±Π»ΡΠ΄Π΅Π½ΠΈΠ΅ ΠΏΡΠ°Π²ΠΈΠ» Π³ΠΈΠ³ΠΈΠ΅Π½Ρ: ΠΏΠΎΠ»ΡΠ·ΠΎΠ²Π°ΡΡΡΡ ΠΈΠ½Π΄ΠΈΠ²ΠΈΠ΄ΡΠ°Π»ΡΠ½ΡΠΌ ΠΏΠΎΠ»ΠΎΡΠ΅Π½ΡΠ΅ΠΌ, ΠΏΠΎΡΡΠΎΡΠ½Π½ΠΎ ΠΌΡΡΡ ΡΡΠΊΠΈ ΠΈ ΠΎΠ±ΡΠ°Π±Π°ΡΡΠ²Π°ΡΡ Π³Π»Π°Π·Π°. ΠΠ°ΡΠ΅Π³ΠΎΡΠΈΡΠ΅ΡΠΊΠΈ Π·Π°ΠΏΡΠ΅ΡΠ΅Π½ΠΎ Π΄ΠΎΡΡΠ°Π³ΠΈΠ²Π°ΡΡΡΡ Π΄ΠΎ ΠΏΠΎΡΠ°ΠΆΠ΅Π½Π½ΡΡ ΠΎΡΠ³Π°Π½ΠΎΠ² Π½Π΅ΡΡΠ΅ΡΠΈΠ»ΡΠ½ΡΠΌΠΈ ΠΏΡΠ΅Π΄ΠΌΠ΅ΡΠ°ΠΌΠΈ ΠΈ ΡΡΠΊΠ°ΠΌΠΈ.
Π‘Π°ΠΌΡΠ΅ ΠΏΠΎΠΏΡΠ»ΡΡΠ½ΡΠ΅ Π³Π»Π°Π·Π½ΡΠ΅ ΠΊΠ°ΠΏΠ»ΠΈ ΠΏΡΠΈ ΠΊΠΎΠ½ΡΡΠ½ΠΊΡΠΈΠ²ΠΈΡΠ΅
Π¨ΠΈΡΠΎΠΊΠΈΠΉ Π°ΡΡΠΎΡΡΠΈΠΌΠ΅Π½Ρ ΠΏΡΠ΅ΠΏΠ°ΡΠ°ΡΠΎΠ² Π²ΠΎΠ²ΡΠ΅ Π½Π΅ Π³ΠΎΠ²ΠΎΡΠΈΡ ΠΎ ΡΠΎΠΌ, ΡΡΠΎ ΡΠ΅Π»ΠΎΠ²Π΅ΠΊ ΠΌΠΎΠΆΠ΅Ρ Π²ΡΠ±ΡΠ°ΡΡ Π»ΡΠ±ΠΎΠΉ. Π Π΄Π΅ΠΉΡΡΠ²ΠΈΡΠ΅Π»ΡΠ½ΠΎΡΡΠΈ ΠΏΠΎΠ΄Π±ΠΎΡ ΠΎΡΡΡΠ΅ΡΡΠ²Π»ΡΠ΅ΡΡΡ ΠΈ, ΠΈΡΡ ΠΎΠ΄Ρ ΠΈΠ· ΠΎΡΠΎΠ±Π΅Π½Π½ΠΎΡΡΠ΅ΠΉ ΠΎΡΠ³Π°Π½ΠΈΠ·ΠΌΠ°. ΠΡΠΎΠ±Π΅Π½Π½ΠΎ ΡΡΠΎ ΠΊΠ°ΡΠ°Π΅ΡΡΡ Π°Π½ΡΠΈΠ±ΠΈΠΎΡΠΈΠΊΠΎΠ², Π²Π΅Π΄Ρ ΠΈΡ ΡΡΡΠ΅ΡΡΠ²ΡΠ΅Ρ ΠΎΠ³ΡΠΎΠΌΠ½ΠΎΠ΅ ΠΊΠΎΠ»ΠΈΡΠ΅ΡΡΠ²ΠΎ. ΠΠ΅ ΠΌΠΎΠΆΠ΅Ρ ΠΎΠ΄ΠΈΠ½ ΠΈ ΡΠΎΡ ΠΆΠ΅ Π°Π½ΡΠΈΠ±ΠΈΠΎΡΠΈΠΊ ΠΈΠ΄Π΅Π°Π»ΡΠ½ΠΎ ΠΏΠΎΠ΄Ρ ΠΎΠ΄ΠΈΡΡ ΡΠΎΠ²Π΅ΡΡΠ΅Π½Π½ΠΎ Π²ΡΠ΅ΠΌ. ΠΠΎΡΡΠΎΠΌΡ Π²ΠΎ ΠΌΠ½ΠΎΠ³ΠΈΡ ΡΠ»ΡΡΠ°ΡΡ ΠΏΠΎΠ΄Π±ΠΎΡ ΠΎΡΡΡΠ΅ΡΡΠ²Π»ΡΠ΅ΡΡΡ Π½Π° ΠΎΡΠ½ΠΎΠ²Π°Π½ΠΈΠΈ ΠΎΡΠ½ΠΎΠ²Π½ΡΡ ΠΊΠΎΠΌΠΏΠΎΠ½Π΅Π½ΡΠΎΠ² ΠΏΡΠ΅ΠΏΠ°ΡΠ°ΡΠΎΠ². Π‘Π°ΠΌΡΠ΅ ΠΏΠΎΠΏΡΠ»ΡΡΠ½ΡΠ΅ Π³Π»Π°Π·Π½ΡΠ΅ ΠΊΠ°ΠΏΠ»ΠΈ:
- ΠΠ»Π°Π·Π½ΡΠ΅ ΠΊΠ°ΠΏΠ»ΠΈ Β«Π’ΠΎΠ±ΡΠ΅ΠΊΡΒ» ΡΠΎΠ΄Π΅ΡΠΆΠ°Ρ ΡΠΎΠ±ΡΠ°ΠΌΠΈΡΠΈΠ½ (Π°Π½ΡΠΈΠ±ΠΈΠΎΡΠΈΠΊ).
- Β«Π¦ΠΈΠΏΡΠΎΠΌΠ΅Π΄Β» ΠΈΠΌΠ΅Π΅Ρ Π² ΡΠΎΡΡΠ°Π²Π΅ Π°Π½ΡΠΈΠ±ΠΈΠΎΡΠΈΠΊ ΡΠΈΠΏΡΠΎΡΠ»ΠΎΠΊΡΠ°ΡΠΈΠ½. ΠΡΠΈΠΌΠ΅Π½ΡΠ΅ΡΡΡ Π΄Π»Ρ ΠΌΠ½ΠΎΠ³ΠΈΡ Π²ΠΈΠ΄ΠΎΠ² ΠΊΠΎΠ½ΡΡΠ½ΠΊΡΠΈΠ²ΠΈΡΠ°.
- Β«ΠΠ΅Π²ΠΎΠΌΠΈΡΠ΅ΡΠΈΠ½Β» ΡΠΎΡΡΠΎΠΈΡ ΠΈΠ· Ρ Π»ΠΎΡΠ°ΠΌΡΠ΅Π½ΠΈΠΊΠΎΠ»Π°.
- Β«ΠΠ»ΡΠ±ΡΡΠΈΠ΄Β». Π Π΅Π³ΠΎ ΡΠΎΡΡΠ°Π²Π΅ ΡΡΠ»ΡΡΠ°ΡΠ΅ΡΠ°ΠΌΠΈΠ΄.
- Β«ΠΡΡΠ°ΠΊΠ²ΠΈΠΊΡΒ» ΠΈΠΌΠ΅Π΅Ρ Π°Π½ΡΠΈΠ±ΠΈΠΎΡΠΈΠΊ Π»Π΅Π²ΠΎΡΠ»ΠΎΠΊΡΠ°ΡΠΈΠ½.
- Β«ΠΠΎΡΠΌΠ°ΠΊΡΒ» ΡΠΎΡΡΠΎΠΈΡ ΠΈΠ· Π½ΠΎΡΡΠ»ΠΎΠΊΡΠ°ΡΠΈΠ½Π°.
- Β«Π€Π»ΠΎΠΊΡΠ°Π»Β» ΠΈΠΌΠ΅Π΅Ρ Π² ΡΠΎΡΡΠ°Π²Π΅ ΠΎΡΠ»ΠΎΠΊΡΠ°ΡΠΈΠ½.
- Β«ΠΡΡΠ°Π»ΡΠΌΠΎΡΠ΅ΡΠΎΠ½Β» ΡΠ²Π»ΡΠ΅ΡΡΡ ΠΏΡΠΎΡΠΈΠ²ΠΎΠ²ΠΈΡΡΡΠ½ΡΠΌ ΠΏΡΠ΅ΠΏΠ°ΡΠ°ΡΠΎΠΌ, ΡΠΎΠ΄Π΅ΡΠΆΠ°ΡΠΈΠΌ ΠΠΈΠΌΠ΅Π΄ΡΠΎΠ» ΠΈ ΠΈΠ½ΡΠ΅ΡΡΠ΅ΡΠΎΠ½.
- Β«ΠΠΊΡΠΈΠΏΠΎΠ»Β» ΡΠ°ΠΊ ΠΆΠ΅ ΠΏΡΠΎΡΠΈΠ²ΠΎΠ²ΠΎΡΠΏΠ°Π»ΠΈΡΠ΅Π»ΡΠ½ΠΎΠ΅ ΡΡΠ΅Π΄ΡΡΠ²ΠΎ. Π‘ΠΎΠ΄Π΅ΡΠΆΠΈΡ ΠΏΠ°ΡΠ°-Π°ΠΌΠΈΠ½ΠΎΠ±Π΅Π½Π·ΠΎΠΉΠ½ΡΡ ΠΊΠΈΡΠ»ΠΎΡΡ.
- Β«ΠΠΎΠ»ΡΠ΄Π°Π½Β» ΠΈΠΌΠ΅Π΅Ρ Π² ΡΠΎΡΡΠ°Π²Π΅ ΠΏΠΎΠ»ΠΈΡΠΈΠ±ΠΎΠ°Π΄Π΅Π½ΠΈΠ»ΠΎΠ²ΡΡ ΠΊΠΈΡΠ»ΠΎΡΡ.
- Β«ΠΠΏΠ°ΡΠ°Π½ΠΎΠ»Β» ΠΎΡΠ½ΠΎΡΠΈΡΡΡ ΠΊ Π³ΡΡΠΏΠΏΠ΅ ΠΏΡΠΎΡΠΈΠ²ΠΎΠ°Π»Π»Π΅ΡΠ³ΠΈΡΠ΅ΡΠΊΠΈΡ Π³Π»Π°Π·Π½ΡΡ ΠΊΠ°ΠΏΠ΅Π»Ρ. Π‘ΠΎΠ΄Π΅ΡΠΆΠΈΡ ΠΎΡΠ½ΠΎΠ²Π½ΠΎΠ΅ Π²Π΅ΡΠ΅ΡΡΠ²ΠΎ ΠΎΠ»ΠΎΠΏΠ°ΡΠ°Π΄ΠΈΠ½.
- Β«ΠΠ»Π»Π΅ΡΠ³ΠΎΠ΄ΠΈΠ»Β» ΡΠΎΡΡΠΎΠΈΡ ΠΈΠ· Π°Π·Π΅Π»Π°ΡΡΠΈΠ½Π°.
- Β«ΠΡΠΎΠΌΠΎΠ³Π΅ΠΊΡΠ°Π»Β» ΡΠΎΠΆΠ΅ ΠΎΡΠ½ΠΎΡΠΈΡΡΡ ΠΊ ΠΏΡΠΎΡΠΈΠ²ΠΎΠ°Π»Π»Π΅ΡΠ³ΠΈΡΠ΅ΡΠΊΠΎΠΉ Π³ΡΡΠΏΠΏΠ΅. Π ΠΎΡΠ½ΠΎΠ²Π΅ ΠΊΠ°ΠΏΠ΅Π»Ρ Π»Π΅ΠΆΠΈΡ ΠΊΡΠΎΠΌΠΎΠ³Π»ΠΈΡΠΈΠ»ΠΈΠ΅Π²Π°Ρ ΠΊΠΈΡΠ»ΠΎΡΠ°.
- ΠΡΠ΅ ΠΎΠ΄Π½ΠΎ ΠΏΡΠΎΡΠΈΠ²ΠΎΠ°Π»Π»Π΅ΡΠ³ΠΈΡΠ΅ΡΠΊΠΎΠ΅ ΡΡΠ΅Π΄ΡΡΠ²ΠΎ Β«ΠΠ΅ΠΊΡΠΎΠ»ΠΈΠ½Β» Ρ ΡΠ°ΠΊΠΎΠΉ ΠΆΠ΅ ΠΊΠΈΡΠ»ΠΎΡΠΎΠΉ.
ΠΠΊΠΎΠ½ΡΠ°ΠΊΡΠ΅
ΠΠ΄Π½ΠΎΠΊΠ»Π°ΡΡΠ½ΠΈΠΊΠΈ
Google+
Π’Π°ΠΊ ΠΆΠ΅ ΠΏΡΠ΅Π΄Π»Π°Π³Π°Π΅ΠΌ ΠΎΠ·Π½Π°ΠΊΠΎΠΌΠΈΡΡΡΡ:
glaznoy-doctor.ru
ΠΠΎΠ½ΡΡΠ½ΠΊΡΠΈΠ²ΠΈΡ ΠΈ Π΅Π³ΠΎ Π²ΠΈΠ΄Ρ. ΠΡΠ½ΠΎΠ²Π½ΡΠ΅ ΠΏΡΠΈΡΠΈΠ½Ρ ΠΊΠΎΠ½ΡΡΠ½ΠΊΡΠΈΠ²ΠΈΡΠ°
ΠΠΎΠ½ΡΡΠ½ΠΊΡΠΈΠ²ΠΈΡ Β - ΡΡΠΎ Β Π²ΠΎΡΠΏΠ°Π»Π΅Π½ΠΈΠ΅ ΡΠ»ΠΈΠ·ΠΈΡΡΠΎΠΉ ΠΎΠ±ΠΎΠ»ΠΎΡΠΊΠΈ Π³Π»Π°Π·Π°. ΠΠ° ΡΠ΅Π³ΠΎΠ΄Π½ΡΡΠ½ΠΈΠΉ Π΄Π΅Π½Ρ ΠΊΠΎΠ½ΡΡΠ½ΠΊΡΠΈΠ²ΠΈΡ Π΄ΠΎΠ²ΠΎΠ»ΡΠ½ΠΎ ΡΠ°ΡΠΏΡΠΎΡΡΡΠ°Π½Π΅Π½Π½ΠΎΠ΅ Π·Π°Π±ΠΎΠ»Π΅Π²Π°Π½ΠΈΠ΅. ΠΡΠΈΡΠΈΠ½Ρ Π½Π°ΡΡΡΠΏΠ»Π΅Π½ΠΈΡ ΠΌΠΎΠ³ΡΡ Π±ΡΡΡ ΡΠ°ΠΌΡΠΌΠΈ ΡΠ°Π·Π½ΡΠΌΠΈ. ΠΠΎΡΠΏΠ°Π»ΠΈΡΠ΅Π»ΡΠ½ΡΠΉ ΠΏΡΠΎΡΠ΅ΡΡ ΠΌΠΎΠΆΠ΅Ρ ΡΠΏΡΠΎΠ²ΠΎΡΠΈΡΠΎΠ²Π°ΡΡ Π±Π°Π½Π°Π»ΡΠ½ΠΎΠ΅ ΠΏΠΎΠΏΠ°Π΄Π°Π½ΠΈΠ΅ Π² Π³Π»Π°Π·Π° ΠΏΡΠ»ΠΈ ΠΈΠ»ΠΈ Π±ΡΡΠΎΠ²ΠΎΠΉ Ρ ΠΈΠΌΠΈΠΈ; ΠΏΡΠΎΡΠ΅ΠΊΠ°ΡΡΠΈΠ΅ Π·Π°Π±ΠΎΠ»Π΅Π²Π°Π½ΠΈΡ Π² Π½ΠΎΡΡ ΠΈ Π² Π³Π°ΠΉΠΌΠΎΡΠΎΠ²ΡΡ ΠΏΠ°Π·ΡΡ Π°Ρ ; Π½Π΅Π΄ΠΎΡΡΠ°ΡΠΎΠΊ Π²ΠΈΡΠ°ΠΌΠΈΠ½ΠΎΠ²; Π½Π°ΡΡΡΠ΅Π½ΠΈΠ΅ ΠΎΠ±ΠΌΠ΅Π½Π½ΡΡ ΠΏΡΠΎΡΠ΅ΡΡΠΎΠ². ΠΡΠ·ΡΠ²Π°ΡΡ ΠΊΠΎΠ½ΡΡΠ½ΠΊΡΠΈΠ²ΠΈΡΡ ΠΈ Π·Π°Π±ΠΎΠ»Π΅Π²Π°Π½ΠΈΡ Π²Π΅ΠΊ.
Π‘ΡΡΠ΅ΡΡΠ²ΡΠ΅Ρ ΡΡΠ΄ ΡΠΈΠΌΠΏΡΠΎΠΌΠΎΠ², ΠΏΠΎ ΠΊΠΎΡΠΎΡΡΠΌ ΠΌΠΎΠΆΠ½ΠΎ ΡΠ°ΠΌΠΎΡΡΠΎΡΡΠ΅Π»ΡΠ½ΠΎ ΡΠ°ΡΠΏΠΎΠ·Π½Π°ΡΡ Π·Π°Π±ΠΎΠ»Π΅Π²Π°Π½ΠΈΠ΅. ΠΠΎΠ»ΡΠ½ΠΎΠΉ ΠΎΡΡΡΠ°Π΅Ρ ΡΠ΅Π·ΠΈ, ΠΆΠΆΠ΅Π½ΠΈΡ, Π·Π°ΠΏΠΎΡΠΎΡΠ΅Π½Π½ΠΎΡΡΡ. ΠΡΠΌΠ΅ΡΠ°Π΅ΡΡΡ Π±ΡΡΡΡΠ°Ρ ΡΡΠΎΠΌΠ»ΡΠ΅ΠΌΠΎΡΡΡ Π³Π»Π°Π·. ΠΠ΅ΠΊΠΈ ΠΎΡΠ΅ΠΊΠ°ΡΡ, ΠΊΡΠ°ΡΠ½Π΅ΡΡ, ΠΏΠΎΡΠ²Π»ΡΠ΅ΡΡΡ Π·ΡΠ΄, Π³Π»Π°Π·Π° ΡΠ»Π΅Π·ΡΡΡΡ, Π±Π΅Π»ΠΊΠΈ ΠΊΡΠ°ΡΠ½Π΅ΡΡ Π·Π° ΡΡΠ΅Ρ Π²ΠΎΡΠΏΠ°Π»Π΅Π½Π½ΡΡ ΠΊΠ°ΠΏΠΈΠ»Π»ΡΡΠΎΠ². Π§Π΅ΡΠ΅Π· ΡΡΡΠΊΠΈ ΠΌΠΎΠ³ΡΡ ΠΏΠΎΡΠ²ΠΈΡΡΡΡ Π²ΡΠ΄Π΅Π»Π΅Π½ΠΈΡ Π±Π΅Π»ΠΎ-ΠΆΠ΅Π»ΡΠΎΠ³ΠΎ ΡΠ²Π΅ΡΠ°.
ΠΠ΅ΡΠΈ ΡΠ°ΡΠ΅ Π²Π·ΡΠΎΡΠ»ΡΡ ΡΡΡΠ°Π΄Π°ΡΡ ΠΊΠΎΠ½ΡΡΠ½ΠΊΡΠΈΠ²ΠΈΡΠΎΠΌ, ΠΏΡΠΈΡΠΈΠ½Π° β Π³ΡΡΠ·Π½ΡΠ΅ ΡΡΠΊΠΈ. ΠΠ΅ΡΠΈΡΠΊΠΈ ΠΌΠ½ΠΎΠ³ΠΎ Π²ΡΠ΅ΠΌΠ΅Π½ΠΈ ΠΏΡΠΎΠ²ΠΎΠ΄ΡΡ Π² ΠΈΠ³ΡΠ°Ρ , Π»Π°Π·Π°ΡΡ ΠΏΠΎ ΠΏΠΎΠ»Ρ, ΠΏΠΎΠ΄Π½ΠΈΠΌΠ°ΡΡ ΠΏΠΎΡΡΠΎΡΠΎΠ½Π½ΠΈΠ΅ ΠΏΡΠ΅Π΄ΠΌΠ΅ΡΡ Π²ΠΎ Π²ΡΠ΅ΠΌΡ ΠΏΡΠΎΠ³ΡΠ»ΠΊΠΈ, Π·Π°ΡΠ΅ΠΌ ΡΡΡΡ Π½Π΅ΡΠΈΡΡΡΠΌΠΈ ΡΡΠΊΠ°ΠΌΠΈ Π³Π»Π°Π·Π°. ΠΠΎΠ½ΡΡΠ½ΠΊΡΠΈΠ²ΠΈΡ ΡΠ°ΡΡΠΎ ΡΠΎΠΏΡΠΎΠ²ΠΎΠΆΠ΄Π°Π΅Ρ ΠΏΡΠΎΡΡΡΠ΄Ρ, Π±Π΅Π· Π΄ΠΎΠΏΠΎΠ»Π½ΠΈΡΠ΅Π»ΡΠ½ΠΎΠ³ΠΎ Π»Π΅ΡΠ΅Π½ΠΈΡ ΠΏΡΠΎΡ ΠΎΠ΄ΠΈΡ Π² ΡΠ΅ΡΠ΅Π½ΠΈΠ΅ Π½Π΅Π΄Π΅Π»ΠΈ.
Β
Π€ΠΎΡΠΌΡ ΠΊΠΎΠ½ΡΡΠ½ΠΊΡΠΈΠ²ΠΈΡΠ°
Β
ΠΠ΅ΡΠ²Π°Ρ ΡΠΎΡΠΌΠ° β Π²ΠΈΡΡΡΠ½ΡΠΉ ΠΊΠΎΠ½ΡΡΠ½ΠΊΡΠΈΠ²ΠΈΡ. ΠΠΈΡΡΡΠ½ΡΠ΅ ΠΊΠΎΠ½ΡΡΠ½ΠΊΡΠΈΠ²ΠΈΡΡ ΠΌΠΎΠ³ΡΡ Π½ΠΎΡΠΈΡΡ ΡΠΏΠΈΠ΄Π΅ΠΌΠΈΡΠ΅ΡΠΊΠΈΠΉ Ρ Π°ΡΠ°ΠΊΡΠ΅Ρ. ΠΠ°ΡΠ°ΠΆΠ΅Π½ΠΈΠ΅ ΡΡΠΎΠΉ ΡΠΎΡΠΌΠΎΠΉ ΠΏΡΠΎΠΈΡΡ ΠΎΠ΄ΠΈΡ ΠΊΠΎΠ½ΡΠ°ΠΊΡΠ½ΡΠΌ ΠΏΡΡΠ΅ΠΌ Π½Π° ΡΠ΅ΡΡΠΈΡΠΎΡΠΈΠΈ ΠΌΠ΅Π΄ΠΈΡΠΈΠ½ΡΠΊΠΈΡ ΡΡΡΠ΅ΠΆΠ΄Π΅Π½ΠΈΠΉ. ΠΠ΅ΡΠ²ΡΠ΅ ΡΠΈΠΌΠΏΡΠΎΠΌΡ Π²ΠΈΡΡΡΠ½ΠΎΠ³ΠΎ ΠΊΠΎΠ½ΡΡΠ½ΠΊΡΠΈΠ²ΠΈΡΠ° β ΡΠ΅Π·Ρ Π² Π³Π»Π°Π·Π°Ρ , ΠΎΠ±ΠΈΠ»ΡΠ½ΠΎΠ΅ ΡΠ»Π΅Π·ΠΎΡΠ΅ΡΠ΅Π½ΠΈΠ΅. Π‘Π½Π°ΡΠ°Π»Π° Π²ΠΎΡΠΏΠ°Π»ΡΠ΅ΡΡΡ ΠΎΠ΄ΠΈΠ½ Π³Π»Π°Π·, ΡΠ΅ΡΠ΅Π· Π½Π΅ΡΠΊΠΎΠ»ΡΠΊΠΎ Π΄Π½Π΅ΠΉ Π½Π°ΡΠΈΠ½Π°Π΅ΡΡΡ Π²ΠΎΡΠΏΠ°Π»ΠΈΡΠ΅Π»ΡΠ½ΡΠΉ ΠΏΡΠΎΡΠ΅ΡΡ Π²ΠΎ Π²ΡΠΎΡΠΎΠΌ. ΠΠΎΠ»Π΅Π·Π½Ρ ΠΏΡΠΎΠ³ΡΠ΅ΡΡΠΈΡΡΠ΅Ρ 3-4 Π½Π΅Π΄Π΅Π»ΠΈ, Π·Π° ΡΡΠΎΡ ΠΏΠ΅ΡΠΈΠΎΠ΄ ΠΌΠΎΠΆΠ΅Ρ Π½Π°ΡΡΡΠΈΡΡΡΡ Π½ΠΎΡΠΌΠ°Π»ΡΠ½Π°Ρ Π²ΡΡΠ°Π±ΠΎΡΠΊΠ° ΡΠ»Π΅Π·Π½ΠΎΠΉ ΠΆΠΈΠ΄ΠΊΠΎΡΡΠΈ ΠΈ ΡΠ°Π·Π²ΠΈΡΡΡΡ ΡΠΈΠ½Π΄ΡΠΎΠΌ ΡΡΡ ΠΎΠ³ΠΎ Π³Π»Π°Π·Π°.ΠΠΎΠ½ΡΡΠ½ΠΊΡΠΈΠ²ΠΈΡ Π°Π΄Π΅Π½ΠΎΠ²ΠΈΡΡΡΠ½ΡΠΉ ΠΏΠ΅ΡΠ΅Π΄Π°Π΅ΡΡΡ Π²ΠΎΠ·Π΄ΡΡΠ½ΠΎ-ΠΊΠ°ΠΏΠ΅Π»ΡΠ½ΡΠΌ ΠΏΡΡΠ΅ΠΌ, Π½Π°ΠΈΠ±ΠΎΠ»Π΅Π΅ ΡΠ°ΡΠΏΡΠΎΡΡΡΠ°Π½ΡΠ½Π½ΡΠΌ ΠΌΠ΅ΡΡΠΎΠΌ Π·Π°ΡΠ°ΠΆΠ΅Π½ΠΈΡ ΡΠ²Π»ΡΡΡΡΡ Π΄Π΅ΡΡΠΊΠΈΠ΅ ΡΡΡΠ΅ΠΆΠ΄Π΅Π½ΠΈΡ: ΡΠ°Π΄ΠΈΠΊΠΈ, ΡΠΊΠΎΠ»Ρ, ΡΠΏΠΎΡΡΠΈΠ²Π½ΡΠ΅ ΡΠ΅ΠΊΡΠΈΠΈ. ΠΠ°Π±ΠΎΠ»Π΅Π²Π°Π½ΠΈΠ΅ ΠΏΡΠΎΡΠ΅ΠΊΠ°Π΅Ρ ΠΎΡΡΡΠΎ, Π½Π°ΡΠΈΠ½Π°Π΅ΡΡΡ Ρ ΠΏΠΎΠ²ΡΡΠ΅Π½ΠΈΡ ΡΠ΅ΠΌΠΏΠ΅ΡΠ°ΡΡΡΡ, ΠΏΠΎΠΊΡΠ°ΡΠ½Π΅Π½ΠΈΡ Π³ΠΎΡΠ»Π°, Π²ΡΠ΄Π΅Π»Π΅Π½ΠΈΠΉ ΠΈΠ· Π½ΠΎΡΠ°, ΡΠ²Π΅Π»ΠΈΡΠ΅Π½ΠΈΡ Π»ΠΈΠΌΡΠΎΡΠ·Π»ΠΎΠ². ΠΠ»Π°Π·Π° Π±ΠΎΠ»Π΅Π·Π½Π΅Π½Π½ΠΎ ΡΠ΅Π°Π³ΠΈΡΡΡΡ Π½Π° ΡΡΠΊΠΎΠ΅ ΠΎΡΠ²Π΅ΡΠ΅Π½ΠΈΠ΅, Π²Π΅ΠΊΠΈ ΠΏΡΠΈΠΏΡΡ Π°ΡΡ ΠΈ ΠΊΡΠ°ΡΠ½Π΅ΡΡ. Π§Π΅ΡΠ΅Π· ΡΡΡΠΊΠΈ ΠΌΠΎΠ³ΡΡ ΠΏΠΎΡΠ²ΠΈΡΡΡΡ Π½Π΅Π±ΠΎΠ»ΡΡΠΈΠ΅ Π²ΡΠ΄Π΅Π»Π΅Π½ΠΈΡ ΠΈΠ· Π³Π»Π°Π·. ΠΡΠΎΡΠΈΠ»Π°ΠΊΡΠΈΡΠ΅ΡΠΊΠΈΠ΅ ΠΌΠ΅ΡΡ β ΡΠ²ΠΎΠ΅Π²ΡΠ΅ΠΌΠ΅Π½Π½Π°Ρ ΠΈΠ·ΠΎΠ»ΡΡΠΈΡ Π±ΠΎΠ»ΡΠ½ΠΎΠ³ΠΎ, ΠΎΠ±ΡΠ°Π±ΠΎΡΠΊΠ° ΠΏΡΠ΅Π΄ΠΌΠ΅ΡΠΎΠ² ΠΎΠ±ΡΠ΅Π³ΠΎ ΠΏΠΎΠ»ΡΠ·ΠΎΠ²Π°Π½ΠΈΡ, Π·Π°ΠΌΠ΅Π½Π° ΠΏΠΎΠ»ΠΎΡΠ΅Π½Π΅Ρ ΠΈ ΠΏΠΎΡΡΠ΅Π»ΡΠ½ΠΎΠ³ΠΎ Π±Π΅Π»ΡΡ, ΡΠΎΠ±Π»ΡΠ΄Π΅Π½ΠΈΠ΅ ΡΠ»Π΅ΠΌΠ΅Π½ΡΠ°ΡΠ½ΡΡ ΠΏΡΠ°Π²ΠΈΠ» Π»ΠΈΡΠ½ΠΎΠΉ Π³ΠΈΠ³ΠΈΠ΅Π½Ρ.
ΠΡΡΡΡΠΉ ΠΊΠΎΠ½ΡΡΠ½ΠΊΡΠΈΠ²ΠΈΡ, Π²ΠΎΠ·Π±ΡΠ΄ΠΈΡΠ΅Π»ΡΠΌΠΈ ΡΠ²Π»ΡΡΡΡΡ ΠΏΠ½Π΅Π²ΠΌΠΎΠΊΠΎΠΊΠΊΠΈ, Π³ΠΎΠ½ΠΎΠΊΠΎΠΊΠΊΠΈ, ΡΡΠ°ΡΠΈΠ»ΠΎΠΊΠΎΠΊΠΊΠΈ, Π½Π΅ΠΊΠΎΡΠΎΡΡΠ΅ Π²ΠΈΠ΄Ρ ΠΏΠ°Π»ΠΎΡΠ΅ΠΊ. ΠΠΎΠΊΠΊΠΈ ΠΌΠΎΠ³ΡΡ Π½Π΅ ΠΏΡΠΎΡΠ²Π»ΡΡΡ ΡΠ΅Π±Ρ Π½Π° ΠΏΡΠΎΡΡΠΆΠ΅Π½ΠΈΠΈ Π΄Π»ΠΈΡΠ΅Π»ΡΠ½ΠΎΠ³ΠΎ ΠΏΠ΅ΡΠΈΠΎΠ΄Π° Π²ΡΠ΅ΠΌΠ΅Π½ΠΈ, Π½ΠΎ ΡΡΠΎΠΈΡ ΠΎΡΠ³Π°Π½ΠΈΠ·ΠΌΡ ΠΎΡΠ»Π°Π±ΠΈΡΡΡΡ, ΡΠΈΠ»ΡΠ½ΠΎ ΠΏΠ΅ΡΠ΅Π³ΡΠ΅ΡΡΡΡ ΠΈΠ»ΠΈ ΠΏΠ΅ΡΠ΅ΠΎΡ Π»Π°Π΄ΠΈΡΡΡΡ, ΠΈ ΡΠ΅Π»ΠΎΠ²Π΅ΠΊ ΡΡΠ°Π½ΠΎΠ²ΠΈΡΡΡ ΡΡΠ·Π²ΠΈΠΌΡΠΌ ΠΊ ΡΠ°Π·Π½ΡΠΌ ΠΈΠ½ΡΠ΅ΠΊΡΠΈΡΠΌ, Π² ΡΠΎΠΌ ΡΠΈΡΠ»Π΅ ΠΈ ΠΊ ΠΊΠΎΠ½ΡΡΠ½ΠΊΡΠΈΠ²ΠΈΡΠ°ΠΌ. ΠΠ°ΡΠ°Π»ΡΠ½Π°Ρ ΡΡΠ°Π΄ΠΈΡ Π·Π°Π±ΠΎΠ»Π΅Π²Π°Π½ΠΈΡ ΡΠΎΠΏΡΠΎΠ²ΠΎΠΆΠ΄Π°Π΅ΡΡΡ ΡΠ»Π΅Π·ΠΎΡΠ΅ΡΠ΅Π½ΠΈΠ΅ΠΌ, ΡΠ΅Π·ΡΡ Π² Π³Π»Π°Π·Π°Ρ , ΠΎΡΡΠ΅ΠΊΠ°ΠΌΠΈ Π²Π΅ΠΊ. Π§Π΅ΡΠ΅Π· Π½Π΅ΡΠΊΠΎΠ»ΡΠΊΠΎ Π΄Π½Π΅ΠΉ ΠΏΡΠΈΡΠΎΠ΅Π΄ΠΈΠ½ΡΡΡΡΡ Π³Π½ΠΎΠΉΠ½ΡΠ΅ Π²ΡΠ΄Π΅Π»Π΅Π½ΠΈΡ.
ΠΡΠΎΡΠ°Ρ ΡΠΎΡΠΌΠ° - Π±Π°ΠΊΡΠ΅ΡΠΈΠ°Π»ΡΠ½ΡΠΉ ΠΊΠΎΠ½ΡΡΠ½ΠΊΡΠΈΠ²ΠΈΡ. ΠΠΎΡΠ°ΠΆΠ°ΡΡΡΡ ΡΡΠ°Π·Ρ ΠΎΠ±Π° Π³Π»Π°Π·Π°, ΡΠΆΠ΅ Π½Π° ΠΏΠ΅ΡΠ²ΠΎΠΉ ΡΡΠ°Π΄ΠΈΠΈ Π±ΠΎΠ»Π΅Π·Π½Ρ ΡΠΎΠΏΡΠΎΠ²ΠΎΠΆΠ΄Π°ΡΡ ΠΎΠ±ΠΈΠ»ΡΠ½ΡΠ΅ Π³Π½ΠΎΠΉΠ½ΡΠ΅ Π²ΡΠ΄Π΅Π»Π΅Π½ΠΈΡ.
Π’ΡΠ΅ΡΡΡ ΡΠΎΡΠΌΠ° - Π°Π»Π»Π΅ΡΠ³ΠΈΡΠ΅ΡΠΊΠΈΠΉ ΠΊΠΎΠ½ΡΡΠ½ΠΊΡΠΈΠ²ΠΈΡ. Β ΠΡΠΈΡΠΈΠ½Π° ΠΏΠΎΡΠ²Π»Π΅Π½ΠΈΡ β Π°Π»Π»Π΅ΡΠ³ΠΈΡΠ΅ΡΠΊΠ°Ρ ΡΠ΅Π°ΠΊΡΠΈΡ Π½Π° ΠΏΠΎΡΡΠΎΡΠΎΠ½Π½ΠΈΠ΅ ΡΠ°Π·Π΄ΡΠ°ΠΆΠΈΡΠ΅Π»ΠΈ. ΠΡΠΎ ΠΌΠΎΠ³ΡΡ Π±ΡΡΡ ΠΊΠΎΠ½ΡΠ°ΠΊΡΡ Ρ Ρ ΠΈΠΌΠΈΠ΅ΠΉ, Π½Π΅ΠΏΠ΅ΡΠ΅Π½ΠΎΡΠΈΠΌΠΎΡΡΡ ΠΏΡΠ»ΠΈ, ΡΠ΅ΡΡΡΠΈ ΠΆΠΈΠ²ΠΎΡΠ½ΡΡ , ΠΎΠΏΡΠ΅Π΄Π΅Π»Π΅Π½Π½ΡΡ Π·Π°ΠΏΠ°Ρ ΠΎΠ². ΠΡΠΈ Π΄Π°Π½Π½ΠΎΠΉ ΡΠΎΡΠΌΠ΅ ΠΊΠΎΠ½ΡΡΠ½ΠΊΡΠΈΠ²ΠΈΡ ΠΏΡΠΎΡΠ²Π»ΡΠ΅ΡΡΡ ΠΎΡΡΡΠΎΠΉ ΡΠ΅Π·ΡΡ, ΠΎΡΠ΅ΠΊΠ°ΠΌΠΈ, ΠΏΠΎΠΊΡΠ°ΡΠ½Π΅Π½ΠΈΡΠΌΠΈ ΠΈ Π³Π½ΠΎΠΉΠ½ΡΠΌΠΈ Π²ΡΠ΄Π΅Π»Π΅Π½ΠΈΡΠΌΠΈ ΠΈΠ· Π³Π»Π°Π·.
ΠΠΎΠ½ΡΡΠ½ΠΊΡΠΈΠ²ΠΈΡ ΠΌΠΎΠΆΠ΅Ρ Π½ΠΎΡΠΈΡΡ Ρ ΡΠΎΠ½ΠΈΡΠ΅ΡΠΊΠΈΠΉ Ρ Π°ΡΠ°ΠΊΡΠ΅Ρ. ΠΠ»ΠΈΡΠ΅Π»ΡΠ½ΠΎΠ΅ ΠΏΡΠ΅Π±ΡΠ²Π°Π½ΠΈΠ΅ Π² Π·Π°Π΄ΡΠΌΠ»Π΅Π½Π½ΡΡ ΠΏΠΎΠΌΠ΅ΡΠ΅Π½ΠΈΡΡ ΠΈ Π² ΠΌΠ΅ΡΡΠ°Ρ Ρ ΡΠ΅Π·ΠΊΠΈΠΌΠΈ Π·Π°ΠΏΠ°Ρ Π°ΠΌΠΈ, ΠΏΡΠΈ Ρ ΡΠΎΠ½ΠΈΡΠ΅ΡΠΊΠΈΡ Π·Π°Π±ΠΎΠ»Π΅Π²Π°Π½ΠΈΡΡ Π½ΠΎΡΠ°, Π½Π°ΡΡΡΠ΅Π½Π½ΠΎΠΉ ΡΠ°Π±ΠΎΡΠ΅ ΡΠ»Π΅Π·Π½ΡΡ ΠΏΡΡΠ΅ΠΉ β Β«ΠΏΠ»ΠΎΠ΄ΠΎΡΠΎΠ΄Π½Π°Ρ ΠΏΠΎΡΠ²Π°Β» Π΄Π»Ρ Β Ρ ΡΠΎΠ½ΠΈΡΠ΅ΡΠΊΠΈΡ ΠΊΠΎΠ½ΡΡΠ½ΠΊΡΠΈΠ²ΠΈΡΠΎΠ².
Β
Β
ΠΡΠ»ΠΈ Π²Ρ Ρ ΠΎΡΠΈΡΠ΅ ΡΠ±Π΅ΡΠ΅ΡΡΡΡ ΠΎΡ ΠΊΠΎΠ½ΡΡΠ½ΠΊΡΠΈΠ²ΠΈΡΠΎΠ², ΠΈΠ·Π±Π΅Π³Π°ΠΉΡΠ΅ ΠΊΠΎΠ½ΡΠ°ΠΊΡΠ° Ρ Π±ΠΎΠ»ΡΠ½ΡΠΌΠΈ Π»ΡΠ΄ΡΠΌΠΈ, ΡΠΎΠ±Π»ΡΠ΄Π°ΠΉΡΠ΅ ΠΏΡΠ°Π²ΠΈΠ»Π° Π³ΠΈΠ³ΠΈΠ΅Π½Ρ. ΠΡΠ΄ΡΡΠ΅ Π²Π½ΠΈΠΌΠ°ΡΠ΅Π»ΡΠ½Ρ ΠΊ ΡΠ²ΠΎΠ΅ΠΌΡ Π·Π΄ΠΎΡΠΎΠ²ΡΡ, ΠΏΡΠΈ ΠΏΠ΅ΡΠ²ΡΡ ΠΏΡΠΈΠ·Π½Π°ΠΊΠ°Ρ Π·Π°Π±ΠΎΠ»Π΅Π²Π°Π½ΠΈΡ ΡΠΏΠ΅ΡΠΈΡΠ΅ Π·Π° ΠΏΠΎΠΌΠΎΡΡΡ ΠΊ ΡΠΏΠ΅ΡΠΈΠ°Π»ΠΈΡΡΡ, Π²ΡΠ°Ρ ΠΏΠΎΡΡΠ°Π²ΠΈΡ Π΄ΠΈΠ°Π³Π½ΠΎΠ· ΠΈ Π΄Π°ΡΡ Π½Π΅ΠΎΠ±Ρ ΠΎΠ΄ΠΈΠΌΡΠ΅ ΡΠ΅ΠΊΠΎΠΌΠ΅Π½Π΄Π°ΡΠΈΠΈ. ΠΡΠ΄ΡΡΠ΅ Π·Π΄ΠΎΡΠΎΠ²Ρ!
Β
mamapedia.com.ua
ΠΠΎΠ½ΡΡΠ½ΠΊΡΠΈΠ²ΠΈΡ. Π‘ΠΈΠΌΠΏΡΠΎΠΌΡ ΠΈ Π»Π΅ΡΠ΅Π½ΠΈΠ΅. ΠΠ΅ΡΡΠΊΠΈΠΉ ΠΊΠΎΠ½ΡΡΠ½ΠΊΡΠΈΠ²ΠΈΡ.
ΠΠΎΠ½ΡΡΠ½ΠΊΡΠΈΠ²ΠΈΡ ΡΠ²Π»ΡΠ΅ΡΡΡ Π·Π°Π±ΠΎΠ»Π΅Π²Π°Π½ΠΈΠ΅ΠΌ, ΠΊΠΎΡΠΎΡΠΎΠ΅ ΡΡΠ΅Π·Π²ΡΡΠ°ΠΉΠ½ΠΎ ΡΠ°ΡΠΏΡΠΎΡΡΡΠ°Π½Π΅Π½ΠΎ. Π‘Π»ΠΈΠ·ΠΈΡΡΠ°Ρ ΠΎΠ±ΠΎΠ»ΠΎΡΠΊΠ° Π³Π»Π°Π·Π°, ΠΏΠΎΠΊΡΡΠ²Π°ΡΡΠ°Ρ ΡΠΊΠ»Π΅ΡΡ ΠΈ Π²Π½ΡΡΡΠ΅Π½Π½ΡΡ ΠΏΠΎΠ²Π΅ΡΡ Π½ΠΎΡΡΡ Π²Π΅ΠΊΠ°, ΠΈΠ½ΠΎΠ³Π΄Π° Π²ΠΎΡΠΏΠ°Π»ΡΠ΅ΡΡΡ. Π ΡΠ²ΡΠ·ΠΈ Ρ ΡΡΠΈΠΌ Π²ΠΎΠ·Π½ΠΈΠΊΠ°Π΅Ρ ΡΠ»Π΅Π·ΠΎΡΠΎΡΠΈΠ²ΠΎΡΡΡ, ΠΎΠ±ΡΠ°Π·ΡΠ΅ΡΡΡ ΠΏΠΎΠΊΡΠ°ΡΠ½Π΅Π½ΠΈΠ΅, ΡΡΠ²ΡΡΠ²ΠΎ Π·ΡΠ΄Π°. Π§Π°ΡΠ΅ Π²ΡΠ΅Π³ΠΎ Π·Π°Π±ΠΎΠ»Π΅Π²Π°Π½ΠΈΠ΅ Π²ΡΠ·ΡΠ²Π°Π΅ΡΡΡ Π±Π°ΠΊΡΠ΅ΡΠΈΠ°Π»ΡΠ½ΠΎΠΉ ΠΈ Π²ΠΈΡΡΡΠ½ΠΎΠΉ ΠΈΠ½ΡΠ΅ΠΊΡΠΈΠ΅ΠΉ, Π°Π»Π»Π΅ΡΠ³ΠΈΡΠ΅ΡΠΊΠΎΠΉ ΡΠ΅Π°ΠΊΡΠΈΠ΅ΠΉ, Π½ΠΎ ΡΡΡΠ΅ΡΡΠ²ΡΡΡ ΠΈ Π΄ΡΡΠ³ΠΈΠ΅ ΠΏΡΠΈΡΠΈΠ½Ρ.
Π‘ΠΈΠΌΠΏΡΠΎΠΌΡ ΠΎΡΡΡΠΎΠ³ΠΎ ΠΊΠΎΠ½ΡΡΠ½ΠΊΡΠΈΠ²ΠΈΡΠ°
ΠΡΡΡΡΠΉ ΠΊΠΎΠ½ΡΡΠ½ΠΊΡΠΈΠ²ΠΈΡ Π²ΠΎΠ·Π½ΠΈΠΊΠ°Π΅Ρ Π½Π΅ΠΎΠΆΠΈΠ΄Π°Π½Π½ΠΎ, ΠΈ ΡΠ΅Π»ΠΎΠ²Π΅ΠΊ ΠΎΡΡΡΠ°Π΅Ρ Π±ΠΎΠ»Ρ Π² ΠΎΠ±Π»Π°ΡΡΠΈ ΠΎΠ΄Π½ΠΎΠ³ΠΎ ΠΈΠ»ΠΈ ΠΎΠ±ΠΎΠΈΡ Π³Π»Π°Π·. ΠΠ°ΠΌΠ΅ΡΠ½ΠΎ Π²ΡΡΠ°ΠΆΠ΅Π½Π½ΠΎΠ΅ ΠΏΠΎΠΊΡΠ°ΡΠ½Π΅Π½ΠΈΠ΅, ΠΈ Π² Π½Π΅ΠΊΠΎΡΠΎΡΡΡ ΡΠ»ΡΡΠ°ΡΡ Π½Π΅ ΠΈΡΠΊΠ»ΡΡΠ΅Π½ΠΎ Π²ΠΎΠ·Π½ΠΈΠΊΠ½ΠΎΠ²Π΅Π½ΠΈΠ΅ ΡΠΎΡΠ΅ΡΠ½ΠΎΠ³ΠΎ ΠΊΡΠΎΠ²ΠΎΠΈΠ·Π»ΠΈΡΠ½ΠΈΡ. ΠΠ° ΡΠ»Π΅Π΄ΡΡΡΠ΅ΠΌ ΡΡΠ°ΠΏΠ΅ Π²ΠΎΡΠΏΠ°Π»Π΅Π½ΠΈΡ Π½Π°Π±Π»ΡΠ΄Π°Π΅ΡΡΡ ΠΎΡΠ΄Π΅Π»Π΅Π½ΠΈΠ΅ ΡΠ»ΠΈΠ·ΠΈ, ΠΈΠΌΠ΅ΡΡΠ΅ΠΉ Π² ΡΠ²ΠΎΠ΅ΠΌ ΡΠΎΡΡΠ°Π²Π΅ Π³Π½ΠΎΠΉ. ΠΡΡΡΠΎΠΌΡ ΠΊΠΎΠ½ΡΡΠ½ΠΊΡΠΈΠ²ΠΈΡΡ ΡΠ²ΠΎΠΉΡΡΠ²Π΅Π½Π½ΠΎ ΡΠΎΡΡΠΎΡΠ½ΠΈΠ΅ ΠΎΠ±ΡΠ΅Π³ΠΎ Π½Π΅Π΄ΠΎΠΌΠΎΠ³Π°Π½ΠΈΡ, Π±ΠΎΠ»ΡΠ½ΠΎΠΉ ΠΆΠ°Π»ΡΠ΅ΡΡΡ Π½Π° Π³ΠΎΠ»ΠΎΠ²Π½ΡΡ Π±ΠΎΠ»Ρ, ΡΠ΅ΠΌΠΏΠ΅ΡΠ°ΡΡΡΠ° ΡΠ΅Π»Π° ΠΏΠΎΠ²ΡΡΠ°Π΅ΡΡΡ. ΠΠ»ΠΈΡΠ΅Π»ΡΠ½ΠΎΡΡΡ Π·Π°Π±ΠΎΠ»Π΅Π²Π°Π½ΠΈΡ Π² ΠΎΡΡΡΠΎΠΉ ΡΠΎΡΠΌΠ΅ ΡΠΎΡΡΠ°Π²Π»ΡΠ΅Ρ ΠΎΡ Π½Π΅ΡΠΊΠΎΠ»ΡΠΊΠΈΡ Π΄Π½Π΅ΠΉ Π΄ΠΎ Π½Π΅ΡΠΊΠΎΠ»ΡΠΊΠΈΡ Π½Π΅Π΄Π΅Π»Ρ.
ΠΡΠ½ΠΎΠ²Π½ΡΠ΅ ΡΠΈΠΌΠΏΡΠΎΠΌΡ ΠΊΠΎΠ½ΡΡΠ½ΠΊΡΠΈΠ²ΠΈΡΠ°, ΠΏΡΠΎΡΠ΅ΠΊΠ°ΡΡΠ΅Π³ΠΎ Π² ΠΎΡΡΡΠΎΠΉ ΡΠΎΡΠΌΠ΅:
- ΠΡΠ°ΡΠ½ΡΠΉ ΡΠ²Π΅Ρ ΠΊΠΎΠ½ΡΡΠ½ΠΊΡΠΈΠ²Ρ
- ΠΡΡΡΠ΅Π½ΠΈΠ΅, ΡΡΠΎ Π² Π³Π»Π°Π·Π°Ρ Π½Π°Ρ ΠΎΠ΄ΠΈΡΡΡ ΠΏΠΎΡΡΠΎΡΠΎΠ½Π½ΠΈΠΉ ΠΏΡΠ΅Π΄ΠΌΠ΅Ρ, ΡΠΎΡΠΈΠ½ΠΊΠ°
- ΠΠΆΠ΅Π½ΠΈΠ΅, ΠΏΠΎΡΡΠΎΡΠ½Π½ΡΠΉ Π·ΡΠ΄, ΡΠ΅Π·Ρ
- ΠΠΎΠ²ΡΡΠ΅Π½Π½Π°Ρ ΡΡΠΎΠΌΠ»ΡΠ΅ΠΌΠΎΡΡΡ Π³Π»Π°Π·
- ΠΠ±ΠΈΠ»ΡΠ½ΠΎΠ΅ ΠΎΡΠ΄Π΅Π»Π΅Π½ΠΈΠ΅ Π³Π½ΠΎΠΉΠ½ΠΎΠΉ ΡΠ»ΠΈΠ·ΠΈ
- ΠΠΎΡΡΠΎΡΠ½Π½ΠΎΠ΅ ΡΠ»Π΅Π·ΠΎΡΠ΅ΡΠ΅Π½ΠΈΠ΅
- ΠΠ»ΠΎΡ Π°Ρ ΠΏΠ΅ΡΠ΅Π½ΠΎΡΠΈΠΌΠΎΡΡΡ ΡΡΠΊΠΎΠ³ΠΎ ΡΠ²Π΅ΡΠ°
ΠΡΠ»ΠΈ ΠΈΠΌΠ΅Π΅Ρ ΠΌΠ΅ΡΡΠΎ Π±Π°ΠΊΡΠ΅ΡΠΈΠ°Π»ΡΠ½ΡΠΉ ΠΊΠΎΠ½ΡΡΠ½ΠΊΡΠΈΠ²ΠΈΡ Π² ΠΎΡΡΡΠΎΠΉ ΡΠΎΡΠΌΠ΅, ΡΠΎ ΠΏΠ°ΡΠΈΠ΅Π½ΡΡ ΠΏΠΎΠ΄ΡΠ΅ΡΠΊΠΈΠ²Π°ΡΡ Π²ΡΡΠ°ΠΆΠ΅Π½Π½ΡΡ ΡΠ²Π΅ΡΠΎΠ±ΠΎΡΠ·Π½Ρ, ΠΎΠ±ΠΈΠ»ΡΠ½ΠΎΠ΅ ΡΠ»Π΅Π·ΠΎΡΠ΅ΡΠ΅Π½ΠΈΠ΅.Β ΠΠΎΠ½ΡΡΠ½ΠΊΡΠΈΠ²Π° Π½Π΅ ΡΠΎΠ»ΡΠΊΠΎ Π²ΡΠ³Π»ΡΠ΄ΠΈΡ ΠΏΠΎΠΊΡΠ°ΡΠ½Π΅Π²ΡΠ΅ΠΉ, Π½ΠΎ ΠΈ ΠΎΡΠ΅ΡΠ½ΠΎΠΉ, Ρ ΠΌΠ½ΠΎΠΆΠ΅ΡΡΠ²Π΅Π½Π½ΡΠΌΠΈ ΠΊΡΠΎΠ²ΠΎΠΈΠ·Π»ΠΈΡΠ½ΠΈΡΠΌΠΈ ΡΠΎΡΠ΅ΡΠ½ΠΎΠ³ΠΎ Ρ Π°ΡΠ°ΠΊΡΠ΅ΡΠ°.
Π‘ΠΈΠΌΠΏΡΠΎΠΌΡ Ρ ΡΠΎΠ½ΠΈΡΠ΅ΡΠΊΠΎΠ³ΠΎ ΠΊΠΎΠ½ΡΡΠ½ΠΊΡΠΈΠ²ΠΈΡΠ°
ΠΡΠ»ΠΈ Π·Π°Π±ΠΎΠ»Π΅Π²Π°Π½ΠΈΠ΅ ΠΏΡΠΎΡΠ΅ΠΊΠ°Π΅Ρ Π² Ρ ΡΠΎΠ½ΠΈΡΠ΅ΡΠΊΠΎΠΉ ΡΠΎΡΠΌΠ΅, ΡΠΎ ΠΊΠΎΠ½ΡΡΠ½ΠΊΡΠΈΠ²ΠΈΡ ΡΠ°Π·Π²ΠΈΠ²Π°Π΅ΡΡΡ Π±ΠΎΠ»Π΅Π΅ ΠΌΠ΅Π΄Π»Π΅Π½Π½ΠΎ. ΠΠ»Ρ Π½Π΅Π³ΠΎ Ρ Π°ΡΠ°ΠΊΡΠ΅ΡΠ½ΠΎ Π΄Π»ΠΈΡΠ΅Π»ΡΠ½ΠΎΠ΅ ΠΈ ΡΠΏΠΎΡΠ½ΠΎΠ΅ ΡΠ΅ΡΠ΅Π½ΠΈΠ΅. ΠΠ°ΡΠΈΠ΅Π½ΡΡ ΠΆΠ°Π»ΡΡΡΡΡ Π½Π° ΠΎΡΡΡΠ΅Π½ΠΈΠ΅ Π² Π³Π»Π°Π·Ρ ΠΈΠ½ΠΎΡΠΎΠ΄Π½ΠΎΠ³ΠΎ ΡΠ΅Π»Π°, Π² ΡΠ²ΡΠ·ΠΈ Ρ ΡΡΠΈΠΌ ΠΏΡΠΈΡΡΡΡΡΠ²ΡΠ΅Ρ ΠΏΠΎΡΡΠΎΡΠ½Π½ΡΠΉ Π΄ΠΈΡΠΊΠΎΠΌΡΠΎΡΡ.Β ΠΠ΅ΠΊΠΈ Π²ΡΠ³Π»ΡΠ΄ΡΡ ΡΡΡΠ°Π²ΡΠΈΠΌΠΈ ΠΈ Π½Π΅ΠΌΠ½ΠΎΠ³ΠΎ ΠΏΠΎΠΊΡΠ°ΡΠ½Π΅Π²ΡΠΈΠΌΠΈ. ΠΠΎΠΆΠ΅Ρ Π½Π°Π±Π»ΡΠ΄Π°ΡΡΡΡ Π½Π΅Π·Π½Π°ΡΠΈΡΠ΅Π»ΡΠ½Π°Ρ ΠΏΡΠΈΠΏΡΡ Π»ΠΎΡΡΡ Π²Π΅ΠΊ.
ΠΡΠΈΡΠΈΠ½Ρ Π²ΠΎΠ·Π½ΠΈΠΊΠ½ΠΎΠ²Π΅Π½ΠΈΡ ΠΊΠΎΠ½ΡΡΠ½ΠΊΡΠΈΠ²ΠΈΡΠ°
Π‘ΠΏΠ΅ΡΠΈΠ°Π»ΠΈΡΡΡ Π½Π°Π·ΡΠ²Π°ΡΡ Π½Π΅ΡΠΊΠΎΠ»ΡΠΊΠΎ ΠΏΡΠΈΡΠΈΠ½, Π²ΡΠ·ΡΠ²Π°ΡΡΠΈΡ ΠΊΠΎΠ½ΡΡΠ½ΠΊΡΠΈΠ²ΠΈΡ. ΠΠ»Π°Π²Π½ΡΠΌ Π²ΠΈΠ½ΠΎΠ²Π½ΠΈΠΊΠΎΠΌ Π·Π°Π±ΠΎΠ»Π΅Π²Π°Π½ΠΈΡ ΡΠ²Π»ΡΡΡΡΡ Π±Π°ΠΊΡΠ΅ΡΠΈΠΈ, ΠΈ Π½Π°ΠΈΠ±ΠΎΠ»Π΅Π΅ ΡΠ°ΡΡΠΎ β Ρ Π»Π°ΠΌΠΈΠ΄ΠΈΠΈ.Β Π’Π°ΠΊΠΆΠ΅ ΠΊΠΎΠ½ΡΡΠ½ΠΊΡΠΈΠ²ΠΈΡ ΠΎΠ±ΡΡΠ»ΠΎΠ²Π»Π΅Π½ ΠΈ Π½Π°Π»ΠΈΡΠΈΠ΅ΠΌ Π΄ΡΡΠ³ΠΈΡ Π²ΠΈΡΡΡΠΎΠ², Π½Π°ΠΏΡΠΈΠΌΠ΅Ρ ΡΠ΅ΠΌΠΈ, ΠΊΠΎΡΠΎΡΡΠ΅ Π²ΡΠ·ΡΠ²Π°ΡΡ Π°Π½Π³ΠΈΠ½Ρ. ΠΡΠ»ΠΈ ΡΠ΅ΡΡ ΠΈΠ΄Π΅Ρ ΠΎ Π΄Π΅ΡΡΡ , ΡΠΎ Π² ΡΡΠΎΠΌ ΡΠ»ΡΡΠ°Π΅ Π·Π°Π±ΠΎΠ»Π΅Π²Π°Π½ΠΈΠ΅ ΡΠ°ΡΡΠΎ ΡΠΎΠΏΡΡΡΡΠ²ΡΠ΅Ρ ΠΏΡΠΎΡΡΡΠ΄Π½ΡΠΌ Π·Π°Π±ΠΎΠ»Π΅Π²Π°Π½ΠΈΡΠΌ, ΠΈ Π΄ΠΎΠ²ΠΎΠ»ΡΠ½ΠΎ ΡΠ΅Π΄ΠΊΠΎ ΠΏΠ΅ΡΠ΅Ρ ΠΎΠ΄ΠΈΡ Π² Ρ ΡΠΎΠ½ΠΈΡΠ΅ΡΠΊΡΡ ΡΠΎΡΠΌΡ. Π§Π°ΡΠ΅ Π²ΡΠ΅Π³ΠΎ ΠΎΠ½ ΠΈΡΡΠ΅Π·Π°Π΅Ρ Π·Π° Π½Π΅Π΄Π΅Π»Ρ.
Π§ΡΠΎΠ±Ρ ΠΏΠΎΠ½ΡΡΡ, ΠΎΡΡΠ΅Π³ΠΎ Π²ΠΎΠ·Π½ΠΈΠΊΠ°Π΅Ρ ΠΊΠΎΠ½ΡΡΠ½ΠΊΡΠΈΠ²ΠΈΡ, ΡΠ»Π΅Π΄ΡΠ΅Ρ Π·Π½Π°ΡΡ, ΡΡΠΎ Π±ΠΎΠ»Π΅Π·Π½Ρ ΠΌΠΎΠΆΠ΅Ρ Π±ΡΡΡ Π°Π»Π»Π΅ΡΠ³ΠΈΡΠ΅ΡΠΊΠΎΠΉ, Π±Π°ΠΊΡΠ΅ΡΠΈΠ°Π»ΡΠ½ΠΎΠΉ, ΠΈΠ»ΠΈ Π²ΠΈΡΡΡΠ½ΠΎΠΉ.Β ΠΠ°Π»ΠΈΡΠΈΠ΅ Π°Π»Π»Π΅ΡΠ³ΠΈΡΠ΅ΡΠΊΠΎΠ³ΠΎ ΠΊΠΎΠ½ΡΡΠ½ΠΊΡΠΈΠ²ΠΈΡΠ°Β ΡΠ²ΡΠ·Π°Π½ΠΎ Ρ ΠΏΡΠΈΡΡΡΡΡΠ²ΠΈΠ΅ΠΌ ΠΎΠΏΡΠ΅Π΄Π΅Π»Π΅Π½Π½ΡΡ ΡΠ°Π·Π΄ΡΠ°ΠΆΠΈΡΠ΅Π»Π΅ΠΉ. Π‘Π°ΠΌΠΎΠΉ ΡΠ°ΡΠΏΡΠΎΡΡΡΠ°Π½Π΅Π½Π½Π°Ρ ΠΏΡΠΈΡΠΈΠ½Π° ΠΊΠΎΠ½ΡΡΠ½ΠΊΡΠΈΠ²ΠΈΡΠ° β ΡΡΠΎ ΠΏΡΠ»ΡΡΠ° ΡΠ°ΡΡΠ΅Π½ΠΈΠΉ, Π° ΡΠ°ΠΊΠΆΠ΅ ΠΎΠ±ΡΡΠ½Π°Ρ ΠΏΡΠ»Ρ. ΠΡΠΎ ΡΠΎΡΡΠΎΡΠ½ΠΈΠ΅ Ρ Π°ΡΠ°ΠΊΡΠ΅ΡΠΈΠ·ΡΠ΅ΡΡΡ ΠΏΠΎΠΊΡΠ°ΡΠ½Π΅Π½ΠΈΠ΅ΠΌ Π²Π΅ΠΊ, ΠΈ Π²ΡΠ΄Π΅Π»Π΅Π½ΠΈΠ΅ΠΌ Π²ΡΠ·ΠΊΠΎΠ³ΠΎ Π³Π½ΠΎΡ, ΠΏΡΠΈΡΡΡΡΡΠ²ΡΠ΅Ρ ΠΏΠΎΡΡΠΎΡΠ½Π½ΠΎΠ΅ ΡΡΠ²ΡΡΠ²ΠΎ Π·ΡΠ΄Π°.
Π₯ΡΠΎΠ½ΠΈΡΠ΅ΡΠΊΠΈΠΉ ΠΊΠΎΠ½ΡΡΠ½ΠΊΡΠΈΠ²ΠΈΡ ΡΠ²Π»ΡΠ΅ΡΡΡ ΠΎΡΠΎΠ±Π΅Π½Π½ΠΎ ΡΡΠΆΠ΅Π»ΡΠΌ, ΠΎΠ½ Π²ΡΡΡΠ΅ΡΠ°Π΅ΡΡΡ Ρ Π²Π·ΡΠΎΡΠ»ΡΡ ΠΏΠ°ΡΠΈΠ΅Π½ΡΠΎΠ². ΠΡΠΈΡΠΈΠ½ΠΎΠΉ Π΅Π³ΠΎ Π²ΠΎΠ·Π½ΠΈΠΊΠ½ΠΎΠ²Π΅Π½ΠΈΡ ΠΌΠΎΠ³ΡΡ ΡΠ°Π·Π΄ΡΠ°ΠΆΠΈΡΠ΅Π»ΠΈ, ΠΊΠΎΡΠΎΡΡΠ΅ Π²ΡΠ΅Π³Π΄Π° ΠΈΠΌΠ΅ΡΡΡΡ Π² ΠΎΠΊΡΡΠΆΠ°ΡΡΠ΅ΠΉ ΡΡΠ΅Π΄Π΅. ΠΠ°ΠΏΡΠΈΠΌΠ΅Ρ, Π²ΡΡ Π»ΠΎΠΏΠ½ΠΎΠΉ Π³Π°Π·, Π΄ΡΠΌ ΠΊΠΎΡΡΡΠ°.Β ΠΡΠΎΠΌΠ΅ ΡΠΎΠ³ΠΎ, Ρ ΡΠΎΠ½ΠΈΡΠ΅ΡΠΊΠΎΠ΅ Π·Π°Π±ΠΎΠ»Π΅Π²Π°Π½ΠΈΠ΅ ΠΌΠΎΠΆΠ΅Ρ Π²ΠΎΠ·Π½ΠΈΠΊΠ½ΡΡΡ ΠΏΠΎ ΠΏΡΠΈΡΠΈΠ½Π΅ Π½Π΅ΠΏΡΠ°Π²ΠΈΠ»ΡΠ½ΠΎΠ³ΠΎ ΠΏΡΠΎΡΠ΅ΡΡΠ° ΠΎΠ±ΠΌΠ΅Π½Π° Π²Π΅ΡΠ΅ΡΡΠ² Π² ΡΠ»ΡΡΠ°Π΅ Π°Π²ΠΈΡΠ°ΠΌΠΈΠ½ΠΎΠ·Π°. Π ΡΡΠΎΠΌ ΡΠ»ΡΡΠ°Π΅ ΡΠ°ΠΊΠΆΠ΅ ΠΈΠΌΠ΅Π΅ΡΡΡ Π·Π½Π°ΡΠΈΡΠ΅Π»ΡΠ½ΠΎΠ΅ ΠΆΠΆΠ΅Π½ΠΈΠ΅ ΠΈ Π·ΡΠ΄, ΡΠ»ΠΎΠ²Π½ΠΎ Π² Π³Π»Π°Π·Π° ΠΏΠΎΠΏΠ°Π» ΠΏΠ΅ΡΠΎΠΊ.
ΠΡΠ°ΠΊ, Π½Π°ΠΈΠ±ΠΎΠ»Π΅Π΅ ΡΠ°ΡΡΠΎΠΉ ΠΏΡΠΈΡΠΈΠ½ΠΎΠΉ Π²ΠΎΠ·Π½ΠΈΠΊΠ½ΠΎΠ²Π΅Π½ΠΈΡ Π΄Π°Π½Π½ΠΎΠ³ΠΎ Π·Π°Π±ΠΎΠ»Π΅Π²Π°Π½ΠΈΡ ΠΌΠΎΠΆΠ½ΠΎ Π½Π°Π·Π²Π°ΡΡ ΡΠ»Π΅Π΄ΡΡΡΠ΅Π΅:
- ΠΠ°Ρ ΠΎΠΆΠ΄Π΅Π½ΠΈΠ΅ Π² ΠΏΠΎΠΌΠ΅ΡΠ΅Π½ΠΈΠΈ, Π³Π΄Π΅ ΠΈΡΠΏΠΎΠ»ΡΠ·ΡΡΡΡΡ ΡΠ°Π·Π»ΠΈΡΠ½ΡΠ΅ Π°ΡΡΠΎΠ·ΠΎΠ»ΠΈ ΠΈ Π΄ΡΡΠ³ΠΈΠ΅ Π²Π΅ΡΠ΅ΡΡΠ²Π° Ρ ΠΈΠΌΠΈΡΠ΅ΡΠΊΠΎΠ³ΠΎ ΠΏΡΠΎΠΈΡΡ ΠΎΠΆΠ΄Π΅Π½ΠΈΡ
- ΠΠ»ΠΈΡΠ΅Π»ΡΠ½ΠΎΠ΅ ΠΏΡΠ΅Π±ΡΠ²Π°Π½ΠΈΠ΅ Π² Π·ΠΎΠ½Π΅ ΠΏΠΎΠ²ΡΡΠ΅Π½Π½ΠΎΠΉ Π·Π°Π³ΡΡΠ·Π½Π΅Π½Π½ΠΎΡΡΠΈ
- ΠΠ°ΡΡΡΠ΅Π½Π½ΡΠΉ ΠΎΠ±ΠΌΠ΅Π½ Π²Π΅ΡΠ΅ΡΡΠ² Π² ΠΎΡΠ³Π°Π½ΠΈΠ·ΠΌΠ΅
- Π’Π°ΠΊΠΈΠ΅ Π·Π°Π±ΠΎΠ»Π΅Π²Π°Π½ΠΈΡ, ΠΊΠ°ΠΊ ΠΌΠ΅ΠΉΠ±ΠΎΠΌΠΈΡ, Π±Π»Π΅ΡΠ°ΡΠΈΡ
- ΠΠ²ΠΈΡΠ°ΠΌΠΈΠ½ΠΎΠ·
- ΠΠ°ΡΡΡΠ΅Π½Π½Π°Ρ ΡΠ΅ΡΡΠ°ΠΊΡΠΈΡ β Π±Π»ΠΈΠ·ΠΎΡΡΠΊΠΎΡΡΡ, Π΄Π°Π»ΡΠ½ΠΎΠ·ΠΎΡΠΊΠΎΡΡΡ, Π°ΡΡΠΈΠ³ΠΌΠ°ΡΠΈΠ·ΠΌ
- ΠΠΎΡΠΏΠ°Π»Π΅Π½ΠΈΠ΅ Π² ΠΏΠ°Π·ΡΡ Π°Ρ Π½ΠΎΡΠ°
- Π‘Π»ΠΈΡΠΊΠΎΠΌ ΡΡΠΊΠΎΠ΅ ΡΠΎΠ»Π½ΡΠ΅, Π²Π΅ΡΠ΅Ρ, ΠΈΠ·Π»ΠΈΡΠ½Π΅ ΡΡΡ ΠΎΠΉ Π²ΠΎΠ·Π΄ΡΡ
ΠΠΈΠ΄Ρ ΠΊΠΎΠ½ΡΡΠ½ΠΊΡΠΈΠ²ΠΈΡΠ°
ΠΠ°Π½Π½ΠΎΠ΅ Π·Π°Π±ΠΎΠ»Π΅Π²Π°Π½ΠΈΠ΅ ΠΏΠΎΠ΄ΡΠ°Π·Π΄Π΅Π»ΡΠ΅ΡΡΡ Π½Π΅ ΡΠΎΠ»ΡΠΊΠΎ Π½Π° ΠΎΡΡΡΡΡ ΠΈ Ρ ΡΠΎΠ½ΠΈΡΠ΅ΡΠΊΡΡ ΡΠΎΡΠΌΡ. ΠΠΌΠ΅Π΅ΡΡΡ Π½Π΅ΡΠΊΠΎΠ»ΡΠΊΠΎ Π²ΠΈΠ΄ΠΎΠ² ΠΊΠΎΠ½ΡΡΠ½ΠΊΡΠΈΠ²ΠΈΡΠ°.
ΠΠΈΡΡΡΠ½ΡΠΉ ΠΊΠΎΠ½ΡΡΠ½ΠΊΡΠΈΠ²ΠΈΡ
ΠΠΈΡΡΡΠ½ΡΠΉ ΠΊΠΎΠ½ΡΡΠ½ΠΊΡΠΈΠ²ΠΈΡ Π½Π°ΡΡΠΈΡΡΠ²Π°Π΅Ρ ΠΎΠΊΠΎΠ»ΠΎ ΡΡΠΈΠ΄ΡΠ°ΡΠΈ ΡΠ΅ΡΠΎΠ»ΠΎΠ³ΠΈΡΠ΅ΡΠΊΠΈΡ ΡΠΈΠΏΠΎΠ² Π΄Π°Π½Π½ΡΡ Π²ΠΈΡΡΡΠΎΠ². ΠΠ½ΠΈ ΡΠ²Π»ΡΡΡΡΡ ΠΏΡΠΈΡΠΈΠ½ΠΎΠΉ Π²ΠΎΠ·Π½ΠΈΠΊΠ½ΠΎΠ²Π΅Π½ΠΈΡ ΡΠ°ΠΊΠΈΡ ΡΠ΅ΡΠΏΠΈΡΠ°ΡΠΎΡΠ½ΡΡ Π·Π°Π±ΠΎΠ»Π΅Π²Π°Π½ΠΈΠΉ, ΠΊΠ°ΠΊ ΠΏΠ½Π΅Π²ΠΌΠΎΠ½ΠΈΠΈ, ΡΠΎΠ½Π·ΠΈΠ»Π»ΠΈΡΡ, ΠΈ ΡΠ°Π·Π»ΠΈΡΠ½ΡΠ΅ Π·Π°Π±ΠΎΠ»Π΅Π²Π°Π½ΠΈΡ Π³Π»Π°Π·. ΠΠ΅ΡΠ΅Π΄ΠΊΠΎ Π²ΠΎΠ·Π½ΠΈΠΊΠ½ΠΎΠ²Π΅Π½ΠΈΠ΅ ΠΎΡΡΡΠΎΠΉ ΡΠΎΡΠΌΡ ΠΊΠΎΠ½ΡΡΠ½ΠΊΡΠΈΠ²ΠΈΡΠ° ΠΎΠ±ΡΡΠ»ΠΎΠ²Π»Π΅Π½ΠΎ Π½Π°Π»ΠΈΡΠΈΠ΅ΠΌ Π°Π΄Π΅Π½ΠΎΠ²ΠΈΡΡΡΠΎΠ².
ΠΠ»Π»Π΅ΡΠ³ΠΈΡΠ΅ΡΠΊΠΈΠΉ ΠΊΠΎΠ½ΡΡΠ½ΠΊΡΠΈΠ²ΠΈΡ
ΠΡΠΈ Π°Π»Π»Π΅ΡΠ³ΠΈΡΠ΅ΡΠΊΠΎΠΌ ΠΊΠΎΠ½ΡΡΠ½ΠΊΡΠΈΠ²ΠΈΡΠ΅ Π²ΠΎΡΠΏΠ°Π»ΡΠ΅ΡΡΡ ΡΠΎΠ΅Π΄ΠΈΠ½ΠΈΡΠ΅Π»ΡΠ½Π°Ρ ΠΎΠ±ΠΎΠ»ΠΎΡΠΊΠ° Π³Π»Π°Π·. ΠΡΠ½ΠΎΠ²Π½ΡΠΌΠΈ ΡΠΈΠΌΠΏΡΠΎΠΌΠ°ΠΌΠΈ ΡΠ²Π»ΡΠ΅ΡΡΡ ΠΏΡΠΈΠΏΡΡ Π»ΠΎΡΡΡ ΠΈ ΠΊΡΠ°ΡΠ½ΠΎΡΠ°, ΡΡΠΈΠ»Π΅Π½Π½ΠΎΠ΅ ΡΠ»Π΅Π·ΠΎΡΠ΅ΡΠ΅Π½ΠΈΠ΅. ΠΠΎΡΠ»Π΅ ΡΠ½Π° Π²Π΅ΠΊΠΈ ΡΠΊΠ»Π΅ΠΈΠ²Π°ΡΡΡΡ, ΠΈ ΠΏΠΎΡΡΠΎΡΠ½Π½ΠΎ Π²ΠΎΠ·Π½ΠΈΠΊΠ°Π΅Ρ ΠΆΠ΅Π»Π°Π½ΠΈΠ΅ ΡΠ΅ΡΠ΅ΡΡ Π³Π»Π°Π·Π° ΡΡΠΊΠ°ΠΌΠΈ, ΡΡΠΎΠ±Ρ ΠΈΠ·Π±Π°Π²ΠΈΡΡΡΡ ΠΎΡ Π·ΡΠ΄Π°. ΠΠΎΠ³Π΄Π° ΡΡΡΡΠ°Π½ΡΠ΅ΡΡΡ Π°Π»Π»Π΅ΡΠ³Π΅Π½, ΡΠΈΠΌΠΏΡΠΎΠΌΡ ΠΏΠΎΡΡΠ΅ΠΏΠ΅Π½Π½ΠΎ ΡΠΌΠ΅Π½ΡΡΠ°ΡΡΡΡ, Π° ΠΏΠΎΡΠΎΠΌ Π²ΠΎΠ²ΡΠ΅ ΠΈΡΡΠ΅Π·Π°ΡΡ.
ΠΠ»Π»Π΅ΡΠ³ΠΈΡΠ΅ΡΠΊΠΈΠΉ ΠΊΠΎΠ½ΡΡΠ½ΠΊΡΠΈΠ²ΠΈΡΒ ΠΈΠΌΠ΅Π΅Ρ ΡΡΠΈ Π²ΠΈΠ΄Π° β ΡΠ΅Π·ΠΎΠ½Π½ΡΠΉ, ΠΏΡΠΎΡΠ΅ΡΡΠΈΠΎΠ½Π°Π»ΡΠ½ΡΠΉ, ΠΈ ΠΊΡΡΠ³Π»ΠΎΠ³ΠΎΠ΄ΠΈΡΠ½ΡΠΉ. ΠΠ»Ρ ΡΠ΅Π·ΠΎΠ½Π½ΠΎΠ³ΠΎ Π°Π»Π»Π΅ΡΠ³ΠΈΡΠ΅ΡΠΊΠΎΠ³ΠΎ ΠΊΠΎΠ½ΡΡΠ½ΠΊΡΠΈΠ²ΠΈΡΠ° Ρ Π°ΡΠ°ΠΊΡΠ΅ΡΠ½Π° ΡΠ΅ΡΠΊΠ°Ρ ΡΠ²ΡΠ·Ρ Ρ ΠΏΡΠΈΡΡΡΡΡΠ²ΠΈΠ΅ΠΌ Π² Π²ΠΎΠ·Π΄ΡΡ Π΅ ΡΠ°Π·Π΄ΡΠ°ΠΆΠ°ΡΡΠ΅ΠΉ ΠΏΡΠ»ΡΡΡ ΡΠ°ΡΡΠ΅Π½ΠΈΠΉ-Π°Π»Π»Π΅ΡΠ³Π΅Π½ΠΎΠ².
ΠΡΠΈ ΠΊΡΡΠ³Π»ΠΎΠ³ΠΎΠ΄ΠΈΡΠ½ΠΎΠΌ (Ρ ΡΠΎΠ½ΠΈΡΠ΅ΡΠΊΠΎΠΌ) Π°Π»Π»Π΅ΡΠ³ΠΈΡΠ΅ΡΠΊΠΎΠΌ Π·Π°Π±ΠΎΠ»Π΅Π²Π°Π½ΠΈΠΈ Π³Π»Π°Π· ΡΠΈΠΌΠΏΡΠΎΠΌΡ ΠΏΡΠΈΡΡΡΡΡΠ²ΡΡΡ ΠΏΠΎΡΡΠΎΡΠ½Π½ΠΎ, Π½ΠΎ ΠΎΠ½ΠΈ Π²ΡΡΠ°ΠΆΠ΅Π½Ρ Π² ΠΌΠ΅Π½ΡΡΠ΅ΠΉ ΡΡΠ΅ΠΏΠ΅Π½ΠΈ. ΠΠ΅ΡΠ΅Π΄ΠΊΠΎ Π°Π»Π»Π΅ΡΠ³ΠΈΡΠ΅ΡΠΊΠΎΠ΅ Π²ΠΎΡΠΏΠ°Π»Π΅Π½ΠΈΠ΅ Π³Π»Π°Π· ΠΌΠΎΠΆΠ΅Ρ ΡΠΎΠΏΡΠΎΠ²ΠΎΠΆΠ΄Π°ΡΡΡΡ Π½Π°ΡΠΌΠΎΡΠΊΠΎΠΌ Ρ ΡΠΎΠ½ΠΈΡΠ΅ΡΠΊΠΎΠ³ΠΎ ΠΏΡΠΎΠΈΡΡ ΠΎΠΆΠ΄Π΅Π½ΠΈΡ, ΠΈΠ»ΠΈ Π±ΡΠΎΠ½Ρ ΠΈΠ°Π»ΡΠ½ΠΎΠΉ Π°ΡΡΠΌΠΎΠΉ Π°Π»Π»Π΅ΡΠ³ΠΈΡΠ΅ΡΠΊΠΎΠ³ΠΎ ΡΠΈΠΏΠ°.
Π₯Π»Π°ΠΌΠΈΠ΄ΠΈΠΉΠ½ΡΠΉ ΠΊΠΎΠ½ΡΡΠ½ΠΊΡΠΈΠ²ΠΈΡ
Π₯Π»Π°ΠΌΠΈΠ΄ΠΈΠΉΠ½ΡΠΉ ΠΊΠΎΠ½ΡΡΠ½ΠΊΡΠΈΠ²ΠΈΡ ΠΌΠ΅Π΄ΠΈΠΊΠΈ Π½Π°Π·ΡΠ²Π°ΡΡ ΠΎΡΡΠ°Π»ΡΠΌΠΎΡ Π»Π°ΠΌΠΈΠ΄ΠΈΠΎΠ·ΠΎΠΌ. Π’ΠΎ Π΅ΡΡΡ, Ρ Π»Π°ΠΌΠΈΠ΄ΠΈΠΎΠ· Π³Π»Π°Π·Β β ΡΡΠΎ ΠΏΠΎΡΠ°ΠΆΠ΅Π½ΠΈΠ΅ ΡΠ»ΠΈΠ·ΠΈΡΡΠΎΠΉ Ρ Π»Π°ΠΌΠΈΠ΄ΠΈΡΠΌΠΈ. Π‘ΡΠ°ΡΠΈΡΡΠΈΠΊΠ° ΠΏΠΎΠ΄ΡΠ²Π΅ΡΠΆΠ΄Π°Π΅Ρ, ΡΡΠΎ Π΄ΠΎ ΡΡΠΈΠ΄ΡΠ°ΡΠΈ ΠΏΡΠΎΡΠ΅Π½ΡΠΎΠ² Π²ΡΠ΅Ρ ΠΊΠΎΠ½ΡΡΠ½ΠΊΡΠΈΠ²ΠΈΡΠΎΠ² ΠΎΠ±ΡΡΠ»ΠΎΠ²Π»Π΅Π½Ρ ΠΈΠΌΠ΅Π½Π½ΠΎ Π½Π°Π»ΠΈΡΠΈΠ΅ΠΌ Ρ Π»Π°ΠΌΠΈΠ΄ΠΈΠΉ. Π₯Π»Π°ΠΌΠΈΠ΄ΠΈΠΉΠ½ΡΠΌ ΠΊΠΎΠ½ΡΡΠ½ΠΊΡΠΈΠ²ΠΈΡΠΎΠΌΒ ΡΡΡΠ°Π΄Π°ΡΡ Π²Π·ΡΠΎΡΠ»ΡΠ΅ ΠΏΠ°ΡΠΈΠ΅Π½ΡΡ ΠΎΠ±ΠΎΠ΅Π³ΠΎ ΠΏΠΎΠ»Π°. ΠΠ°Π±ΠΎΠ»Π΅Π²Π°Π½ΠΈΠ΅ ΠΏΡΠ΅Π΄ΡΡΠ°Π²Π»ΡΠ΅Ρ ΡΠΎΠ±ΠΎΠΉ ΡΠ»Π΅Π΄ΡΡΡΠΈΠ΅ ΡΠΎΡΠΌΡ:
- ΠΠ°ΡΠ°ΡΡΠ°Ρ ΠΎΠΌΠ°
- Π’ΡΠ°Ρ ΠΎΠΌΠ°
- Π₯Π»Π°ΠΌΠΈΠ΄ΠΈΠΉΠ½ΡΠΉ ΡΠ²Π΅ΠΈΡ (Π²ΠΎΡΠΏΠ°Π»Π΅Π½Π½Π°Ρ ΡΠΎΡΡΠ΄ΠΈΡΡΠ°Ρ ΠΎΠ±ΠΎΠ»ΠΎΡΠΊΠ° Π³Π»Π°Π·Π°)
- ΠΠ°ΡΡΠ΅ΠΉΠ½ΠΎΠ²ΡΠΉ ΠΊΠΎΠ½ΡΡΠ½ΠΊΡΠΈΠ²ΠΈΡ
- Π₯Π»Π°ΠΌΠΈΠ΄ΠΈΠΉΠ½ΡΠΉ ΡΠΏΠΈΡΠΊΠ»Π΅ΡΠΈΡ (Π²ΠΎΡΠΏΠ°Π»Π΅Π½Π½Π°Ρ ΡΠΎΠ΅Π΄ΠΈΠ½ΠΈΡΠ΅Π»ΡΠ½Π°Ρ ΡΠΊΠ°Π½Ρ ΠΌΠ΅ΠΆΠ΄Ρ ΡΠΊΠ»Π΅ΡΠΎΠΉ ΠΈ ΠΊΠΎΠ½ΡΡΠ½ΠΊΡΠΈΠ²ΠΎΠΉ)
- Π₯Π»Π°ΠΌΠΈΠ΄ΠΈΠΉΠ½ΡΠΉ ΠΌΠ΅ΠΉΠ±ΠΎΠ»ΠΈΡ (Π²ΠΎΡΠΏΠ°Π»Π΅Π½Π½ΡΠ΅ ΠΌΠ΅ΠΉΠ±ΠΎΠ»ΠΈΠ΅Π²ΡΠ΅ ΠΆΠ΅Π»Π΅Π·Ρ)
ΠΠ΅ΡΠ΅Π΄ΠΊΠΎ ΠΎΡΡΠ°Π»ΡΠΌΠΎΡ Π»Π°ΠΌΠΈΠ΄ΠΈΠΎΠ· ΡΠ²Π»ΡΠ΅ΡΡΡ ΡΠΎΠΏΡΡΡΡΠ²ΡΡΡΠΈΠΌ ΡΠ°ΠΊΡΠΎΡΠΎΠΌ ΠΏΡΠΈ Π½Π°Π»ΠΈΡΠΈΠΈ ΠΎΡΠ½ΠΎΠ²Π½ΠΎΠ³ΠΎ Ρ Π»Π°ΠΌΠΈΠ΄ΠΈΠΎΠ·Π°. ΠΡΠΎ Π·Π½Π°ΡΠΈΡ, ΡΡΠΎ Π½Π΅ ΠΌΠ΅Π½Π΅Π΅ ΠΏΡΡΠΈΠ΄Π΅ΡΡΡΠΈ ΠΏΡΠΎΡΠ΅Π½ΡΠΎΠ² ΠΏΠ°ΡΠΈΠ΅Π½ΡΠΎΠ², ΡΡΡΠ°Π΄Π°ΡΡΠΈΡ Ρ Π»Π°ΠΌΠΈΠ΄ΠΈΠΉΠ½ΡΠΌ ΠΊΠΎΠ½ΡΡΠ½ΠΊΡΠΈΠ²ΠΈΡΠΎΠΌ, ΠΈΠΌΠ΅ΡΡ Ρ Π»Π°ΠΌΠΈΠ΄ΠΈΠΉΠ½ΡΡ ΠΈΠ½ΡΠ΅ΠΊΡΠΈΡ ΠΏΠΎΠ»ΠΎΠ²ΠΎΠΉ ΡΡΠ΅ΡΡ.
ΠΠ°ΠΊ ΠΏΡΠΎΡΠ΅ΠΊΠ°Π΅Ρ ΠΎΡΡΡΡΠΉ ΠΊΠΎΠ½ΡΡΠ½ΠΊΡΠΈΠ²ΠΈΡ
ΠΠ°ΡΠ°Π»ΠΎ Π·Π°Π±ΠΎΠ»Π΅Π²Π°Π½ΠΈΡ Π²ΠΏΠΎΠ»Π½Π΅ Π±Π΅Π·ΠΎΠ±ΠΈΠ΄Π½ΠΎ, ΠΈ, ΠΊΠ°ΠΆΠ΅ΡΡΡ, ΡΡΠΎ Π²ΡΠ΅Π³ΠΎ Π»ΠΈΡΡ ΠΏΠΎΠΏΠ°Π»Π° ΡΠΎΡΠΈΠ½ΠΊΠ°. ΠΠ°Π±ΠΎΠ»Π΅Π²Π°Π½ΠΈΠ΅ ΡΠ°Π·Π²ΠΈΠ²Π°Π΅ΡΡΡ Π½Π° ΠΎΠ΄Π½ΠΎΠΌ Π³Π»Π°Π·Ρ, ΠΈ ΡΠΎΠ»ΡΠΊΠΎ ΡΠΏΡΡΡΡ ΠΎΠΏΡΠ΅Π΄Π΅Π»Π΅Π½Π½ΠΎΠ΅ Π²ΡΠ΅ΠΌΡ ΡΠ°ΡΠΏΡΠΎΡΡΡΠ°Π½ΡΠ΅ΡΡΡ Π½Π° Π΄ΡΡΠ³ΠΎΠΉ.Β Π₯Π°ΡΠ°ΠΊΡΠ΅ΡΠ½ΠΎ ΠΏΠΎΠΊΡΠ°ΡΠ½Π΅Π½ΠΈΠ΅ Π³Π»Π°Π·Π°, ΠΎΡΠ΄Π΅Π»Π΅Π½ΠΈΠ΅ Π³Π½ΠΎΠΉΠ½ΠΎΠΉ ΡΠ»ΠΈΠ·ΠΈ, ΠΈΠ· Π³Π»Π°Π· ΠΏΠΎΡΡΠΎΡΠ½Π½ΠΎ ΡΠ΅ΠΊΡΡ ΡΠ»Π΅Π·Ρ.
ΠΠΎ Π²ΡΠ΅ΠΌΡ ΠΏΡΠΎΠ²Π΅Π΄Π΅Π½ΠΈΡ ΠΎΡΠΌΠΎΡΡΠ° Π²ΡΡΠ²Π»ΡΠ΅ΡΡΡ Π³ΠΈΠΏΠ΅ΡΠ΅ΠΌΠΈΡΠΎΠ²Π°Π½ΠΈΠ΅ ΡΠ»ΠΈΠ·ΠΈΡΡΠΎΠΉ, ΠΎΠ½Π° ΠΏΡΠΈΠΎΠ±ΡΠ΅ΡΠ°Π΅Ρ ΡΡΠΊΠΎ-ΠΊΡΠ°ΡΠ½ΡΡ ΠΎΠΊΡΠ°ΡΠΊΡ, Π²ΡΠ³Π»ΡΠ΄ΠΈΡ Π½Π°Π±ΡΡ ΡΠ΅ΠΉ ΠΈ ΡΡΡ Π»ΠΎΠΉ. Π’Π°ΠΊ ΠΊΠ°ΠΊ ΠΈΠΌΠ΅Π΅ΡΡΡ ΠΎΡΠ΅ΡΠ½ΠΎΡΡΡ ΠΈ Π³ΠΈΠΏΠ΅ΡΠ΅ΠΌΠΈΡ, Π½Π΅ Π²ΠΈΠ΄Π΅Π½ ΡΠΈΡΡΠ½ΠΎΠΊ ΠΏΠΎΠ²Π΅ΡΡ Π½ΠΎΡΡΠΈ ΠΌΠ΅ΠΉΠ±ΠΎΠΌΠΈΠ΅Π²ΠΎΠΉ ΠΆΠ΅Π»Π΅Π·Ρ. Β ΠΠΎΠ·ΠΌΠΎΠΆΠ½ΠΎ Π²ΠΎΠ·Π½ΠΈΠΊΠ½ΠΎΠ²Π΅Π½ΠΈΠ΅ ΡΠΎΠ»Π»ΠΈΠΊΡΠ»ΠΎΠ² ΠΈ ΡΠΎΡΠΎΡΠΊΠΎΠ². ΠΠ°Π±Π»ΡΠ΄Π°Π΅ΡΡΡ ΡΠΊΠΎΠΏΠ»Π΅Π½ΠΈΠ΅ Π³Π½ΠΎΠ΅ΡΠΎΠ΄Π΅ΡΠΆΠ°ΡΠ΅ΠΉ ΡΠ»ΠΈΠ·ΠΈ. Π‘Π°ΠΌΠΎ Π³Π»Π°Π·Π½ΠΎΠ΅ ΡΠ±Π»ΠΎΠΊΠΎ ΡΠ°ΠΊΠΆΠ΅ Π²ΡΠ³Π»ΡΠ΄ΠΈΡ ΠΏΠΎΠΊΡΠ°ΡΠ½Π΅Π²ΡΠΈΠΌ.
ΠΠ°ΠΊ ΠΏΡΠΎΡΠ΅ΠΊΠ°Π΅Ρ Ρ ΡΠΎΠ½ΠΈΡΠ΅ΡΠΊΠΈΠΉ ΠΊΠΎΠ½ΡΡΠ½ΠΊΡΠΈΠ²ΠΈΡ
ΠΠΎΠ·Π½ΠΈΠΊΠ½ΠΎΠ²Π΅Π½ΠΈΠ΅ Ρ ΡΠΎΠ½ΠΈΡΠ΅ΡΠΊΠΎΠ³ΠΎ Π·Π°Π±ΠΎΠ»Π΅Π²Π°Π½ΠΈΡ Π½Π΅ΡΠ΅Π΄ΠΊΠΎ Π²ΡΠ·Π²Π°Π½ΠΎ ΡΠ°ΠΊΠΈΠΌ ΡΠ°ΠΊΡΠΎΡΠΎΠΌ, ΠΊΠ°ΠΊ Π½Π°ΠΏΡΡΠΆΠ΅Π½Π½Π°Ρ Π·ΡΠΈΡΠ΅Π»ΡΠ½Π°Ρ ΡΠ°Π±ΠΎΡΠ° Π² ΡΡΠ»ΠΎΠ²ΠΈΡΡ ΠΏΠ»ΠΎΡ ΠΎΠΉ ΠΎΡΠ²Π΅ΡΠ΅Π½Π½ΠΎΡΡΠΈ ΠΏΠΎΠΌΠ΅ΡΠ΅Π½ΠΈΡ. ΠΠ°ΡΠΈΠ΅Π½ΡΡ ΠΆΠ°Π»ΡΡΡΡΡ Π½Π° ΡΡΠΈΠ»Π΅Π½Π½ΠΎΠ΅ ΡΠ»Π΅Π·ΠΎΡΠ΅ΡΠ΅Π½ΠΈΠ΅, ΠΆΠΆΠ΅Π½ΠΈΠ΅ Π² ΠΎΠ±Π»Π°ΡΡΠΈ Π³Π»Π°Π·. ΠΠ΅ΠΊΠΈ ΡΡΠ°Π½ΠΎΠ²ΡΡΡΡ ΡΡΠΆΠ΅Π»ΡΠΌΠΈ ΠΈ ΠΏΡΠΈΠΏΡΡ ΡΠΈΠΌΠΈ. ΠΡΠΎΠ±Π΅Π½Π½ΠΎ Π²ΡΠ΅ ΡΡΠΈ ΠΏΡΠΈΠ·Π½Π°ΠΊΠΈ ΡΡΠΈΠ»ΠΈΠ²Π°ΡΡΡΡ Π² Π²Π΅ΡΠ΅ΡΠ½Π΅Π΅ Π²ΡΠ΅ΠΌΡ ΡΡΡΠΎΠΊ. ΠΠΎΡΠ»Π΅ ΡΠ½Π° Π² ΡΠ³ΠΎΠ»ΠΊΠ΅ Π³Π»Π°Π· Ρ Π²Π½ΡΡΡΠ΅Π½Π½Π΅ΠΉ ΡΡΠΎΡΠΎΠ½Ρ ΡΠΎΠ±ΠΈΡΠ°ΡΡΡΡ ΠΊΠΎΠΌΠΎΡΠΊΠΈ ΡΠ»ΠΈΠ·ΠΈ.
ΠΡΠΌΠΎΡΡ ΠΏΠΎΠΊΠ°Π·ΡΠ²Π°Π΅Ρ, ΡΡΠΎ ΠΈΠΌΠ΅Π΅Ρ ΠΌΠ΅ΡΡΠΎ ΡΠ°Π·ΡΡΡ Π»Π΅Π½ΠΈΠ΅ ΠΊΠΎΠ½ΡΡΠ½ΠΊΡΠΈΠ²Ρ Π²Π΅ΠΊ, ΠΎΠ½Π° Π³ΠΈΠΏΠ΅ΡΠ΅ΠΌΠΈΡΠΎΠ²Π°Π½Π°. Β Π Π½Π΅ΠΊΠΎΡΠΎΡΡΡ ΡΠ»ΡΡΠ°ΡΡ , ΠΏΡΠΈ Ρ ΡΠΎΠ½ΠΈΡΠ΅ΡΠΊΠΎΠΌ ΡΠ΅ΡΠ΅Π½ΠΈΠΈ Π±ΠΎΠ»Π΅Π·Π½ΠΈ ΡΠΈΠΌΠΏΡΠΎΠΌΡ ΠΎΡΠ΅Π½Ρ ΡΠ΅Π·ΠΊΠΎ Π²ΡΡΠ°ΠΆΠ΅Π½Ρ, ΠΈ Π² ΡΠΎ ΠΆΠ΅ Π²ΡΠ΅ΠΌΡ Π½Π°Π±Π»ΡΠ΄Π°Π΅ΡΡΡ ΠΎΡΡΡΡΡΡΠ²ΠΈΠ΅ ΠΎΠ±ΡΠ΅ΠΊΡΠΈΠ²Π½ΡΡ ΠΈΠ·ΠΌΠ΅Π½Π΅Π½ΠΈΠΉ.
ΠΠΎΠ½ΡΡΠ½ΠΊΡΠΈΠ²ΠΈΡ Ρ Π΄Π΅ΡΠ΅ΠΉ
ΠΠ΅ΡΠΈ Π΄ΠΎΠ²ΠΎΠ»ΡΠ½ΠΎ ΡΠ°ΡΡΠΎ Π±ΠΎΠ»Π΅ΡΡ ΠΊΠΎΠ½ΡΡΠ½ΠΊΡΠΈΠ²ΠΈΡΠΎΠΌ. ΠΡΠΎΠ±Π΅Π½Π½ΠΎ Π·Π°Π±ΠΎΠ»Π΅Π²Π°Π½ΠΈΡ ΠΏΠΎΠ΄Π²Π΅ΡΠΆΠ΅Π½Ρ ΠΌΠ»Π°Π΄Π΅Π½ΡΡ, ΠΈ Π² ΡΡΠΎΠΌ ΡΠ»ΡΡΠ°Π΅ Π½Π΅ΡΠ΅Π΄ΠΊΠΎ Π²ΠΎΠ·Π½ΠΈΠΊΠ°ΡΡ ΠΎΡΠ»ΠΎΠΆΠ½Π΅Π½ΠΈΡ.Β ΠΠ°Π»ΡΡΠΈ Π±ΠΎΠ»Π΅ΡΡ ΡΡΠ΅ΠΌΡ Π²ΠΈΠ΄Π°ΠΌΠΈ Π΄Π°Π½Π½ΠΎΠ³ΠΎ Π·Π°Π±ΠΎΠ»Π΅Π²Π°Π½ΠΈΡ. Π£ Π½ΠΈΡ Π²ΡΡΡΠ΅ΡΠ°Π΅ΡΡΡ Π²ΠΈΡΡΡΠ½ΡΠΉ, Π°Π»Π»Π΅ΡΠ³ΠΈΡΠ΅ΡΠΊΠΈΠΉ, Π±Π°ΠΊΡΠ΅ΡΠΈΠ°Π»ΡΠ½ΡΠΉ ΠΊΠΎΠ½ΡΡΠ½ΠΊΡΠΈΠ²ΠΈΡ. Π ΠΊΠ°ΠΆΠ΄ΠΎΠΌ ΡΠ»ΡΡΠ°Π΅ ΠΈΠΌΠ΅ΡΡΡΡ ΡΠ²ΠΎΠΈ ΠΏΡΠΈΠ·Π½Π°ΠΊΠΈ, ΠΈ ΡΠΏΠ΅ΡΠΈΠ°Π»ΡΠ½ΡΠ΅ ΠΌΠ΅ΡΠΎΠ΄Ρ Π»Π΅ΡΠ΅Π½ΠΈΡ.
ΠΠΈΡΡΡΠ½ΡΠΉ ΠΊΠΎΠ½ΡΡΠ½ΠΊΡΠΈΠ²ΠΈΡ Π²ΡΠ·Π²Π°Π½ Π²ΠΎΠ·Π±ΡΠ΄ΠΈΡΠ΅Π»ΡΠΌΠΈ, ΠΊΠΎΡΠΎΡΡΠ΅ ΡΠ²Π»ΡΡΡΡΡ ΠΏΡΠΈΡΠΈΠ½ΠΎΠΉ ΡΠ΅ΡΠΏΠΈΡΠ°ΡΠΎΡΠ½ΡΡ Π·Π°Π±ΠΎΠ»Π΅Π²Π°Π½ΠΈΠΉ, ΠΈ ΠΏΡΠΎΡΠ΅ΠΊΠ°Π΅Ρ ΠΊΠ°ΠΊ ΡΠΎΠΏΡΡΡΡΠ²ΡΡΡΠ΅Π΅ Π·Π°Π±ΠΎΠ»Π΅Π²Π°Π½ΠΈΠ΅ ΠΏΡΠΈ ΠΠ Π.Β ΠΠΎΠΏΠ°Π² Π½Π° ΡΠ»ΠΈΠ·ΠΈΡΡΡΡ ΠΎΠ±ΠΎΠ»ΠΎΡΠΊΡ Π³Π»Π°Π·Π° ΠΌΠ»Π°Π΄Π΅Π½ΡΠ°, Π²ΠΈΡΡΡ Π²ΡΠ·ΡΠ²Π°Π΅Ρ Π²ΠΎΡΠΏΠ°Π»ΠΈΡΠ΅Π»ΡΠ½ΡΠΉ ΠΏΡΠΎΡΠ΅ΡΡ. ΠΠ½ Π²ΡΡΡΠ΅ΡΠ°Π΅ΡΡΡ Π½Π΅ ΠΎΡΠ΅Π½Ρ ΡΠ°ΡΡΠΎ.
ΠΠ»Π»Π΅ΡΠ³ΠΈΡΠ΅ΡΠΊΠΈΠΉ ΠΊΠΎΠ½ΡΡΠ½ΠΊΡΠΈΠ²ΠΈΡ β ΡΡΠΎ ΡΠ»Π΅Π΄ΡΡΠ²ΠΈΠ΅ Π°Π»Π»Π΅ΡΠ³ΠΈΡΠ΅ΡΠΊΠΎΠΉ ΡΠ΅Π°ΠΊΡΠΈΠΈ Π² ΠΎΡΡΡΠΎΠΉ ΡΠΎΡΠΌΠ΅. ΠΠ°ΠΊ ΠΏΡΠ°Π²ΠΈΠ»ΠΎ, Π°Π»Π»Π΅ΡΠ³Π΅Π½Ρ Π½ΠΎΠΌΠ΅Ρ ΠΎΠ΄ΠΈΠ½ β ΡΡΠΎ ΡΠ²Π΅ΡΡΡΠΈΠ΅ ΡΠ°ΡΡΠ΅Π½ΠΈΡ, ΡΠ΅ΡΡΡΡ Π΄ΠΎΠΌΠ°ΡΠ½ΠΈΡ ΠΏΠΈΡΠΎΠΌΡΠ΅Π², Π½Π΅ΠΊΠΎΡΠΎΡΡΠ΅ ΠΏΡΠΎΠ΄ΡΠΊΡΡ, Π»Π΅ΠΊΠ°ΡΡΡΠ²Π°, Π΄ΠΎΠΌΠ°ΡΠ½ΡΡ ΠΏΡΠ»Ρ. ΠΡΠΈ Π°Π»Π»Π΅ΡΠ³ΠΈΡΠ΅ΡΠΊΠΎΠΌ ΠΊΠΎΠ½ΡΡΠ½ΠΊΡΠΈΠ²ΠΈΡΠ΅ ΠΌΠΎΠΆΠ΅Ρ Π±ΡΡΡ ΡΠ΅Π½Π½Π°Ρ Π»ΠΈΡ ΠΎΡΠ°Π΄ΠΊΠ°.
ΠΠ°ΠΊΡΠ΅ΡΠΈΠ°Π»ΡΠ½ΡΠΉ ΠΊΠΎΠ½ΡΡΠ½ΠΊΡΠΈΠ²ΠΈΡΒ ΠΈΠΌΠ΅Π΅Ρ ΡΠ°ΠΌΠΎΠ΅ Π±ΠΎΠ»ΡΡΠΎΠ΅ ΡΠ°ΡΠΏΡΠΎΡΡΡΠ°Π½Π΅Π½ΠΈΠ΅ Π² ΡΠ»ΡΡΠ°Π΅ Π·Π°Π±ΠΎΠ»Π΅Π²Π°Π½ΠΈΡ Π΄Π΅ΡΠ΅ΠΉ. ΠΠΎΠ·Π±ΡΠ΄ΠΈΡΠ΅Π»ΡΠΌΠΈ ΡΠ²Π»ΡΡΡΡΡ ΡΠ°ΠΊΠΈΠ΅ Π±Π°ΠΊΡΠ΅ΡΠΈΠΈ, ΠΊΠ°ΠΊ ΡΡΠ°ΡΠΈΠ»ΠΎΠΊΠΎΠΊΠΊΠΈ, ΠΏΠ½Π΅Π²ΠΌΠΎΠΊΠΎΠΊΠΊΠΈ.Β ΠΠΎΠ·Π±ΡΠ΄ΠΈΡΠ΅Π»ΠΈ Π»Π΅Π³ΠΊΠΎ ΠΎΠΊΠ°Π·ΡΠ²Π°ΡΡΡΡ Π½Π° ΡΠ»ΠΈΠ·ΠΈΡΡΠΎΠΉ ΠΎΠ±ΠΎΠ»ΠΎΡΠΊΠ΅, ΠΊΠΎΠ³Π΄Π° ΠΌΠ°Π»ΡΡ ΡΡΠ΅Ρ Π³Π»Π°Π·Π° Π½Π΅ ΠΎΡΠ΅Π½Ρ ΡΠΈΡΡΡΠΌΠΈ ΡΡΡΠΊΠ°ΠΌΠΈ.
ΠΠΎΠ½ΡΡΠ½ΠΊΡΠΈΠ²ΠΈΡ Ρ Β Π½ΠΎΠ²ΠΎΡΠΎΠΆΠ΄Π΅Π½Π½ΡΡ ΠΎΠ±ΡΡΡΠ½ΡΠ΅ΡΡΡ ΡΠ΅ΠΌ, ΡΡΠΎ Π±Π°ΠΊΡΠ΅ΡΠΈΠΈ ΠΏΠΎΠΏΠ°Π΄Π°ΡΡ Π½Π° ΡΠ»ΠΈΠ·ΠΈΡΡΡΡ ΠΈΠ· ΡΠΎΠ΄ΠΎΠ²ΡΡ ΠΏΡΡΠ΅ΠΉ. ΠΠΏΡΠ΅Π΄Π΅Π»Π΅Π½Π½ΠΎΠ΅ Π²ΡΠ΅ΠΌΡ Π½Π°Π»ΠΈΡΠΈΠ΅ Π² ΠΎΡΠ³Π°Π½ΠΈΠ·ΠΌΠ΅ ΡΠ΅Π±Π΅Π½ΠΊΠ° Π±Π°ΠΊΡΠ΅ΡΠΈΠΉ ΠΌΠΎΠΆΠ΅Ρ Π½ΠΈΠΊΠ°ΠΊ Π½Π΅ ΠΏΡΠΎΡΠ²Π»ΡΡΡΡΡ, ΠΈ Π»ΠΈΡΡ Π² ΠΌΠΎΠΌΠ΅Π½Ρ ΠΎΡΠ»Π°Π±Π»Π΅Π½ΠΈΡ ΠΈΠΌΠΌΡΠ½Π½ΠΎΠΉ ΡΠΈΡΡΠ΅ΠΌΡ ΠΎΡΠ³Π°Π½ΠΈΠ·ΠΌΠ° ΠΌΠΎΠ³ΡΡ ΡΠΏΡΠΎΠ²ΠΎΡΠΈΡΠΎΠ²Π°ΡΡ Π²ΠΎΡΠΏΠ°Π»Π΅Π½ΠΈΠ΅. Π‘ΡΠ΅ΠΏΠ΅Π½Ρ Π²ΠΎΡΠΏΠ°Π»Π΅Π½ΠΈΡ Π·Π°Π²ΠΈΡΠΈΡ ΠΎΡ ΡΠΎΠ³ΠΎ, ΠΊΠ°ΠΊΠΈΠΌ ΠΈΠΌΠ΅Π½Π½ΠΎ Π²ΠΎΠ·Π±ΡΠ΄ΠΈΡΠ΅Π»Π΅ΠΌ ΠΎΠ½ΠΎ Π²ΡΠ·Π²Π°Π½ΠΎ.
Π‘ΠΈΠΌΠΏΡΠΎΠΌΡ Π΄Π΅ΡΡΠΊΠΎΠ³ΠΎ ΠΊΠΎΠ½ΡΡΠ½ΠΊΡΠΈΠ²ΠΈΡΠ°
ΠΠΌΠ΅Π΅ΡΡΡ ΠΏΡΠΈΠ·Π½Π°ΠΊ, Ρ Π°ΡΠ°ΠΊΡΠ΅ΡΠ½ΡΠΉ Π΄Π»Ρ Π»ΡΠ±ΠΎΠ³ΠΎ Π²ΠΈΠ΄Π° ΡΡΠΎΠ³ΠΎ Π·Π°Π±ΠΎΠ»Π΅Π²Π°Π½ΠΈΡ Ρ Π΄Π΅ΡΠ΅ΠΉ.Β ΠΠ±ΠΈΠ»ΡΠ½ΠΎΠ΅ ΡΠ΅ΡΠ΅Π½ΠΈΠ΅ ΡΠ»Π΅Π·, ΡΠ²Π΅ΡΠΎΠ±ΠΎΡΠ·Π½Ρ, ΠΈ ΠΏΠΎΠΊΡΠ°ΡΠ½Π΅Π½ΠΈΠ΅ Π³Π»Π°Π·. ΠΡΠΈ Π±Π°ΠΊΡΠ΅ΡΠΈΠ°Π»ΡΠ½ΠΎΠΉ ΡΠΎΡΠΌΠ΅ Π½Π°Π±Π»ΡΠ΄Π°Π΅ΡΡΡ Π²ΠΎΡΠΏΠ°Π»Π΅Π½ΠΈΠ΅ ΠΎΠ΄Π½ΠΎΠ²ΡΠ΅ΠΌΠ΅Π½Π½ΠΎ ΠΎΠ±ΠΎΠΈΡ Π³Π»Π°Π·, Π½ΠΎ Π±ΡΠ²Π°Π΅Ρ, ΡΡΠΎ Π²Π½Π°ΡΠ°Π»Π΅ ΠΏΠΎΡΠ°ΠΆΠ΅Π½ Π»ΠΈΡΡ ΠΎΠ΄ΠΈΠ½ Π³Π»Π°Π·, ΠΈ ΡΠ΅ΡΠ΅Π· Π½Π΅ΠΊΠΎΡΠΎΡΠΎΠ΅ Π²ΡΠ΅ΠΌΡ ΠΈΠ½ΡΠ΅ΠΊΡΠΈΡ ΠΏΠ΅ΡΠ΅Ρ ΠΎΠ΄ΠΈΡ ΠΈ Π½Π° Π΄ΡΡΠ³ΠΎΠΉ. ΠΡΠ΅ΠΊΠ°Π΅Ρ Π½ΠΈΠΆΠ½Π΅Π΅ ΠΈ Π²Π΅ΡΡ Π½Π΅Π΅ Π²Π΅ΠΊΠΎ, ΠΈΠ· Π³Π»Π°Π·Π° Π²ΡΠ΄Π΅Π»ΡΠ΅ΡΡΡ ΡΠ»ΠΈΠ·Ρ Ρ ΡΠΎΠ΄Π΅ΡΠΆΠ°Π½ΠΈΠ΅ΠΌ Π³Π½ΠΎΡ. ΠΡΠΎΠ±Π΅Π½Π½ΠΎ Π·Π°Π±ΠΎΠ»Π΅Π²Π°Π½ΠΈΠ΅ ΠΏΡΠΎΡΠ²Π»ΡΠ΅ΡΡΡ Π² ΡΡΡΠ΅Π½Π½Π΅Π΅ Π²ΡΠ΅ΠΌΡ, ΠΊΠΎΠ³Π΄Π° Π³Π½ΠΎΠΉ ΠΏΠΎΠ΄ΡΡΡ Π°Π΅Ρ, ΠΈ ΡΠ΅Π±Π΅Π½ΠΎΠΊ Π½Π΅ Π² ΡΠΎΡΡΠΎΡΠ½ΠΈΠΈ ΡΠ°ΠΌΠΎΡΡΠΎΡΡΠ΅Π»ΡΠ½ΠΎ ΠΎΡΠΊΡΡΡΡ Π³Π»Π°Π·ΠΊΠΈ.
ΠΡΠ»ΠΈ Ρ ΠΌΠ°Π»ΡΡΠ° Π°Π»Π»Π΅ΡΠ³ΠΈΡΠ΅ΡΠΊΠ°Ρ ΡΠΎΡΠΌΠ° Π·Π°Π±ΠΎΠ»Π΅Π²Π°Π½ΠΈΡ, ΡΠΎ Π² Π²ΠΎΡΠΏΠ°Π»ΠΈΡΠ΅Π»ΡΠ½ΡΠΉ ΠΏΡΠΎΡΠ΅ΡΡ Π±ΡΠ²Π°ΡΡ Π²ΠΎΠ²Π»Π΅ΡΠ΅Π½Ρ ΡΡΠ°Π·Ρ ΠΎΠ±Π° Π³Π»Π°Π·Π°. ΠΠ΅ΠΊΠΈ Π² ΡΡΠΎΠΌ ΡΠ»ΡΡΠ°Π΅ ΠΎΠΏΡΡ ΡΠΈΠ΅, ΡΠ΅Π±Π΅Π½ΠΎΠΊ ΠΎΡΡΡΠ°Π΅Ρ ΡΠΈΠ»ΡΠ½ΡΠΉ Π·ΡΠ΄, ΠΈ ΠΏΠΎΡΡΠΎΡΠ½Π½ΠΎ ΠΏΡΡΠ°Π΅ΡΡΡ ΡΠ΅ΡΠ΅ΡΡ Π³Π»Π°Π·Π°. ΠΠ½ΠΎΠΉΠ½ΡΠ΅ Π²ΡΠ΄Π΅Π»Π΅Π½ΠΈΡ Π½Π°Π±Π»ΡΠ΄Π°ΡΡΡΡ ΡΠ΅Π΄ΠΊΠΎ.
ΠΡΠΈ Π²ΠΈΡΡΡΠ½ΠΎΠΉ ΡΠΎΡΠΌΠ΅ Π΄Π΅ΡΡΠΊΠΎΠ³ΠΎ ΠΊΠΎΠ½ΡΡΠ½ΠΊΡΠΈΠ²ΠΈΡΠ° Π²ΠΎΡΠΏΠ°Π»Π΅Π½ΠΈΠ΅ Π½Π°ΡΠΈΠ½Π°Π΅ΡΡΡ Ρ ΠΎΠ΄Π½ΠΎΠ³ΠΎ Π³Π»Π°Π·Π°, ΠΈ ΠΏΠ΅ΡΠ΅Ρ ΠΎΠ΄ΠΈΡ Π½Π° Π²ΡΠΎΡΠΎΠΉ Π»ΠΈΡΡ Π² ΡΠΎΠΌ ΡΠ»ΡΡΠ°Π΅, Π΅ΡΠ»ΠΈ ΠΎΡΡΡΡΡΡΠ²ΡΠ΅Ρ ΡΠ²ΠΎΠ΅Π²ΡΠ΅ΠΌΠ΅Π½Π½ΠΎΠ΅ Π»Π΅ΡΠ΅Π½ΠΈΠ΅.Β ΠΠ½ΠΎΠΉΠ½ΡΠ΅ Π²ΡΠ΄Π΅Π»Π΅Π½ΠΈΡ Π±ΡΠ²Π°ΡΡ ΠΏΡΠΈ Π΄ΠΎΠ±Π°Π²Π»Π΅Π½ΠΈΠΈ Π±Π°ΠΊΡΠ΅ΡΠΈΠ°Π»ΡΠ½ΠΎΠΉ ΠΈΠ½ΡΠ΅ΠΊΡΠΈΠΈ.
ΠΠ΅ΡΠ΅Π½ΠΈΠ΅ ΠΊΠΎΠ½ΡΡΠ½ΠΊΡΠΈΠ²ΠΈΡΠ° Ρ Π΄Π΅ΡΠ΅ΠΉ
ΠΠ°Π½Π½ΠΎΠ΅ Π·Π°Π±ΠΎΠ»Π΅Π²Π°Π½ΠΈΠ΅ ΡΠ²Π»ΡΠ΅ΡΡΡ Π΄ΠΎΡΡΠ°ΡΠΎΡΠ½ΠΎ ΡΠ΅ΡΡΠ΅Π·Π½ΡΠΌ, ΠΈ ΠΏΠΎΡΡΠΎΠΌΡ Π»ΡΠ±ΡΠ΅ Π΄Π΅ΠΉΡΡΠ²ΠΈΡ Π½Π΅ΠΎΠ±Ρ ΠΎΠ΄ΠΈΠΌΠΎ ΡΠΎΠ³Π»Π°ΡΠΎΠ²ΡΠ²Π°ΡΡ Ρ Π»Π΅ΡΠ°ΡΠΈΠΌ Π²ΡΠ°ΡΠΎΠΌ. ΠΠ»Ρ Π»Π΅ΡΠ΅Π½ΠΈΡ Π²ΠΈΡΡΡΠ½ΠΎΠ³ΠΎ ΠΊΠΎΠ½ΡΡΠ½ΠΊΡΠΈΠ²ΠΈΡΠ° ΠΏΡΠΈΠΌΠ΅Π½ΡΡΡΡΡ ΠΏΡΠΎΡΠΈΠ²ΠΎΠ²ΠΈΡΡΡΠ½ΡΠ΅ ΠΊΠ°ΠΏΠ»ΠΈ. Π§ΡΠΎΠ±Ρ ΡΠ»ΡΡΡΠΈΡΡ ΡΠ°ΠΌΠΎΡΡΠ²ΡΡΠ²ΠΈΠ΅ ΡΠ΅Π±Π΅Π½ΠΊΠ°, ΠΏΡΠΈΠΌΠ΅Π½ΡΡΡΡΡ Ρ ΠΎΠ»ΠΎΠ΄Π½ΡΠ΅ ΠΊΠΎΠΌΠΏΡΠ΅ΡΡΡ, ΠΈ ΠΏΡΠ΅ΠΏΠ°ΡΠ°Ρ Β«ΠΈΡΠΊΡΡΡΡΠ²Π΅Π½Π½Π°Ρ ΡΠ»Π΅Π·Π°Β». ΠΡΠΎΡ Π²ΠΈΠ΄ Π·Π°Π±ΠΎΠ»Π΅Π²Π°Π½ΠΈΡ ΠΏΡΠΎΡ ΠΎΠ΄ΠΈΡ ΡΠ°ΠΌΠΎΡΡΠΎΡΡΠ΅Π»ΡΠ½ΠΎ, Π΄Π»Ρ Π²ΡΠ·Π΄ΠΎΡΠΎΠ²Π»Π΅Π½ΠΈΡ ΡΠ΅Π±Π΅Π½ΠΊΠ° ΡΡΠ΅Π±ΡΠ΅ΡΡΡ Π½Π΅ΡΠΊΠΎΠ»ΡΠΊΠΎ Π½Π΅Π΄Π΅Π»Ρ.
ΠΠ»Ρ Π»Π΅ΡΠ΅Π½ΠΈΡ Π°Π»Π»Π΅ΡΠ³ΠΈΡΠ΅ΡΠΊΠΎΠΉ ΡΠΎΡΠΌΡ ΠΈΡΠΏΠΎΠ»ΡΠ·ΡΡΡΡΡ Π°Π½ΡΠΈΠ³ΠΈΡΡΠ°ΠΌΠΈΠ½Π½ΡΠ΅ ΠΏΡΠ΅ΠΏΠ°ΡΠ°ΡΡ, Π½ΠΎ Π³Π»Π°Π²Π½ΠΎΠ΅ Π² ΡΡΠΎΠΌ ΡΠ»ΡΡΠ°Π΅ β ΡΡΡΡΠ°Π½Π΅Π½ΠΈΠ΅ Π°Π»Π»Π΅ΡΠ³Π΅Π½Π°.
Π§ΡΠΎΠ±Ρ ΠΈΠ·Π±Π°Π²ΠΈΡΡ ΡΠ΅Π±Π΅Π½ΠΊΠ° ΠΎΡ Π±Π°ΠΊΡΠ΅ΡΠΈΠ°Π»ΡΠ½ΠΎΠ³ΠΎ ΠΊΠΎΠ½ΡΡΠ½ΠΊΡΠΈΠ²ΠΈΡΠ°, ΠΏΠ΅Π΄ΠΈΠ°ΡΡ Π½Π°Π·Π½Π°ΡΠ°Π΅Ρ ΠΏΡΠΈΠ΅ΠΌ ΡΠΏΠ΅ΡΠΈΠ°Π»ΡΠ½ΡΡ ΠΊΠ°ΠΏΠ΅Π»Ρ ΠΈ ΠΌΠ°Π·Π΅ΠΉ, ΠΎΡΠ½ΠΎΠ²ΠΎΠΉ ΠΊΠΎΡΠΎΡΡΡ ΡΠ²Π»ΡΡΡΡΡ Π°Π½ΡΠΈΠ±ΠΈΠΎΡΠΈΠΊΠΈ ΡΠΈΡΠΎΠΊΠΎΠ³ΠΎ ΠΏΡΠΈΠΌΠ΅Π½Π΅Π½ΠΈΡ. ΠΡΠΎΠ±Π΅Π½Π½ΠΎΡΡΡ Π² ΡΠΎΠΌ, ΡΡΠΎ Π΄ΠΎΠ·Π° Π²Π΅ΡΠ΅ΡΡΠ²Π° ΠΌΠΈΠ½ΠΈΠΌΠ°Π»ΡΠ½Π°, ΠΈ Π½Π΅ ΠΎΠΊΠ°Π·ΡΠ²Π°Π΅Ρ Π½Π΅Π³Π°ΡΠΈΠ²Π½ΠΎΠ΅ Π²Π»ΠΈΡΠ½ΠΈΠ΅ Π½Π° ΠΎΡΠ³Π°Π½ΠΈΠ·ΠΌ ΡΠ΅Π±Π΅Π½ΠΊΠ°, Π½ΠΎ Π² ΡΠΎ ΠΆΠ΅ Π²ΡΠ΅ΠΌΡ ΡΡΡΡΠ°Π½ΡΠ΅Ρ ΠΌΠ΅ΡΡΠ½ΡΠΉ Π²ΠΎΡΠΏΠ°Π»ΠΈΡΠ΅Π»ΡΠ½ΡΠΉ ΠΏΡΠΎΡΠ΅ΡΡ.
Π§ΡΠΎΠ±Ρ ΡΠΌΠ΅Π½ΡΡΠΈΡΡ Π²ΠΎΡΠΏΠ°Π»ΠΈΡΠ΅Π»ΡΠ½ΡΠΉ ΠΏΡΠΎΡΠ΅ΡΡ, ΠΈ ΡΡΠΊΠΎΡΠΈΡΡ Π²ΡΠ·Π΄ΠΎΡΠ°Π²Π»ΠΈΠ²Π°Π½ΠΈΠ΅, Π½ΡΠΆΠ½ΠΎ Π΄Π΅Π»Π°ΡΡ ΠΏΡΠΎΡΠΈΡΠ°Π½ΠΈΡ Π³Π»Π°Π· ΠΌΠ»Π°Π΄Π΅Π½ΡΠ° ΠΎΡΠ²Π°ΡΠ°ΠΌΠΈ ΡΠ΅Π»Π΅Π±Π½ΡΡ ΡΡΠ°Π². ΠΠ»Ρ ΡΡΠΎΠ³ΠΎ Π²Π°ΠΌ ΠΏΠΎΡΡΠ΅Π±ΡΠ΅ΡΡΡ ΠΌΠ°ΡΠ»Π΅Π²ΡΠΉ ΡΠ°ΠΌΠΏΠΎΠ½ ΠΈ Π°ΠΏΡΠ΅ΡΠ½ΡΠ΅ ΡΡΠ°Π²Ρ β ΡΠΎΠΌΠ°ΡΠΊΠ°, ΡΠ°Π»ΡΠ΅ΠΉ, ΠΊΡΠ°ΠΏΠΈΠ²Π°. ΠΠ»Ρ ΠΊΠ°ΠΆΠ΄ΠΎΠΉ ΠΏΡΠΎΡΠ΅Π΄ΡΡΡ ΡΠ»Π΅Π΄ΡΠ΅Ρ ΠΏΡΠΈΠ³ΠΎΡΠΎΠ²ΠΈΡΡ ΠΎΡΠ΄Π΅Π»ΡΠ½ΡΡ ΠΏΠΎΡΡΠΈΡ.Β ΠΡΠΎΡΠΈΡΠ°Π½ΠΈΠ΅ ΠΏΡΠΎΠΈΠ·Π²ΠΎΠ΄ΠΈΡΡΡΒ ΠΊΠ°ΠΆΠ΄ΡΠ΅ Π΄Π²Π° β ΡΡΠΈ ΡΠ°ΡΠ°. ΠΠ²ΠΈΠΆΠ΅Π½ΠΈΠ΅ ΡΠΎΠ²Π΅ΡΡΠ°Π΅ΡΡΡ ΠΎΡ Π²Π½Π΅ΡΠ½Π΅Π³ΠΎ ΡΠ³Π»Π° Π³Π»Π°Π·Π° ΠΏΠΎ Π½Π°ΠΏΡΠ°Π²Π»Π΅Π½ΠΈΡ ΠΊ Π²Π½ΡΡΡΠ΅Π½Π½Π΅ΠΌΡ. ΠΠ°Π½Π½Π°Ρ ΠΏΡΠΎΡΠ΅Π΄ΡΡΠ° ΠΏΡΠ΅ΠΊΡΠ°ΡΠ½ΠΎ ΡΠ΄Π°Π»ΡΠ΅Ρ Π³Π½ΠΎΠΉ ΠΈ ΠΊΠΎΡΠΎΡΠΊΠΈ, ΡΠ½ΠΈΠΌΠ°Π΅Ρ Π²ΠΎΡΠΏΠ°Π»Π΅Π½ΠΈΠ΅. ΠΠ°ΡΠ° Π΄Π»Ρ ΠΏΡΠΎΡΠ΅Π΄ΡΡΡ Π½Π΅ ΠΏΠΎΠ΄Ρ ΠΎΠ΄ΠΈΡ, ΡΠ°ΠΊ ΠΊΠ°ΠΊ ΠΎΡΡΠ°Π²ΡΠΈΠ΅ΡΡ Π½Π° ΡΠ»ΠΈΠ·ΠΈΡΡΠΎΠΉ Π²ΠΎΠ»ΠΎΠΊΠ½Π° ΠΌΠΎΠ³ΡΡ ΡΡ ΡΠ΄ΡΠΈΡΡ ΡΠΎΡΡΠΎΡΠ½ΠΈΠ΅.
ΠΠΎΠ½ΡΡΠ½ΠΊΡΠΈΠ²ΠΈΡ β Π»Π΅ΡΠ΅Π½ΠΈΠ΅ Π°ΠΏΡΠ΅ΡΠ½ΡΠΌΠΈ ΠΏΡΠ΅ΠΏΠ°ΡΠ°ΡΠ°ΠΌΠΈ
Π‘ ΠΎΡΡΡΡΠΌ Π³Π½ΠΎΠΉΠ½ΡΠΌ ΠΊΠΎΠ½ΡΡΠ½ΠΊΡΠΈΠ²ΠΈΡΠΎΠΌ ΠΌΠΎΠΆΠ½ΠΎ ΡΠΏΡΠ°Π²ΠΈΡΡΡΡ Π·Π° ΠΏΠ°ΡΡ Π΄Π½Π΅ΠΉ, Π² ΡΠΎΠΌ ΡΠ»ΡΡΠ°Π΅, Π΅ΡΠ»ΠΈ ΡΠΎΠ±Π»ΡΠ΄Π°ΡΡ Π²ΡΠ΅ ΠΏΡΠ½ΠΊΡΡ. ΠΠ΅ΠΊΠ°ΡΡΡΠ²Π° ΠΌΠΎΠΆΠ½ΠΎ ΠΈΡΠΏΠΎΠ»ΡΠ·ΠΎΠ²Π°ΡΡ ΡΠ°ΠΌΡΠ΅ ΠΏΡΠΎΡΡΡΠ΅, Π½ΠΎ Π½Π°Π΄Π΅ΠΆΠ½ΡΠ΅. ΠΠΎΡΡΠ΅Π±ΡΠ΅ΡΡΡ ΡΠ°ΡΡΠ²ΠΎΡ ΠΌΠ°ΡΠ³Π°Π½ΡΠΎΠ²ΠΊΠΈ, Π½ΠΎ ΡΠ²Π΅Ρ Π΄ΠΎΠ»ΠΆΠ΅Π½ Π±ΡΡΡ Π΅Π΄Π²Π° Π·Π°ΠΌΠ΅ΡΠ½ΡΠΌ, Π±Π»Π΅Π΄Π½ΠΎ ΡΠΎΠ·ΠΎΠ²ΡΠΌ. ΠΡΠ΅ Π»Π΅Π²ΠΎΠΌΠΈΡΠ΅ΡΠΈΠ½ΠΎΠ²ΡΠ΅ ΠΊΠ°ΠΏΠ»ΠΈ, ΡΠ°ΡΡΠ²ΠΎΡ 0, 25 ΠΏΡΠΎΡΠ΅Π½ΡΠΎΠ², β ΠΌΠΎΠΆΠ½ΠΎ ΠΊΡΠΏΠΈΡΡ ΠΏΡΠ°ΠΊΡΠΈΡΠ΅ΡΠΊΠΈ Π² Π»ΡΠ±ΠΎΠΉ Π°ΠΏΡΠ΅ΠΊΠ΅. Π’Π°ΠΊΠΆΠ΅ Π²ΠΎΠ·ΡΠΌΠΈΡΠ΅ ΡΠ΅ΡΡΠ°ΡΠΈΠΊΠ»ΠΈΠ½ΠΎΠ²ΡΡ ΠΌΠ°Π·Ρ Π΄Π»Ρ Π³Π»Π°Π· (Π½Π΅ ΠΏΠ΅ΡΠ΅ΠΏΡΡΠ°ΠΉΡΠ΅ Ρ ΠΏΡΠ΅ΠΏΠ°ΡΠ°ΡΠΎΠΌ Π΄Π»Ρ Π½Π°ΡΡΠΆΠ½ΠΎΠ³ΠΎ ΠΏΡΠΈΠΌΠ΅Π½Π΅Π½ΠΈΡ).
ΠΠ°Π»Π΅Π΅ Π²Π°ΡΠΈ Π΄Π΅ΠΉΡΡΠ²ΠΈΡ ΡΠ°ΠΊΠΎΠ²Ρ: ΠΏΠΎΡΠ»Π΅ Π½ΠΎΡΠ½ΠΎΠ³ΠΎ ΡΠ½Π° ΡΠΌΠ°ΡΠΈΠ²Π°Π΅ΡΠ΅ ΡΠ°ΠΌΠΏΠΎΠ½ Π² ΡΠ°ΡΡΠ²ΠΎΡΠ΅ ΠΌΠ°ΡΠ³Π°Π½ΡΠΎΠ²ΠΊΠΈ. ΠΠ°ΡΠ΅ΠΌ ΡΠ°ΡΠΊΡΡΠ²Π°Π΅ΡΠ΅ Π²Π΅ΠΊΠΈ, ΠΈ ΡΡΠ°ΡΠ΅Π»ΡΠ½ΠΎ ΠΏΡΠΎΠΌΡΠ²Π°Π΅ΡΠ΅ ΠΎΠ±Π»Π°ΡΡΡ ΠΊΠΎΠ½ΡΡΠ½ΠΊΡΠΈΠ²Ρ ΡΡΠΈΠΌ ΠΆΠ΅ ΡΠ°ΡΡΠ²ΠΎΡΠΎΠΌ. ΠΠΎΠΆΠ½ΠΎ Π½Π°Π±ΡΠ°ΡΡ Π² ΡΠΏΡΠΈΡ Π±Π΅Π· ΠΈΠ³Π»Ρ, ΠΈ Π½Π°ΠΏΡΠ°Π²ΠΈΡΡ ΡΡΡΡΡ Π΄Π»Ρ ΠΏΡΠΎΠΌΡΠ²Π°Π½ΠΈΡ. ΠΠΎΡΠ»Π΅ ΡΡΠΎΠΉ ΠΏΡΠΎΡΠ΅Π΄ΡΡΡ Π·Π°ΠΊΠ°ΠΏΠ°ΠΉΡΠ΅ ΠΎΠ΄Π½Ρ ΠΊΠ°ΠΏΠ»Ρ Π»Π΅Π²ΠΎΠΌΠΈΡΠ΅ΡΠΈΠ½Π°. Π ΡΠ΅ΡΠ΅Π½ΠΈΠ΅ Π΄Π½Ρ Π½ΡΠΆΠ½ΠΎ ΠΊΠ°ΠΏΠ°ΡΡ ΠΊΠ°ΠΆΠ΄ΡΠΉ ΡΠ°Ρ. ΠΠ΅ΡΠΊΠΎΠ»ΡΠΊΠΎ ΡΠ°Π· ΠΏΠΎΠ²ΡΠΎΡΠΈΡΡ ΠΏΡΠΎΠΌΡΠ²Π°Π½ΠΈΠ΅ ΠΌΠ°ΡΠ³Π°Π½ΡΠΎΠ²ΠΊΠΎΠΉ. ΠΠ΅ΡΠ΅Π΄ ΡΠ΅ΠΌ, ΠΊΠ°ΠΊ Π»Π΅ΡΡ ΡΠΏΠ°ΡΡ, ΠΈΡΠΏΠΎΠ»ΡΠ·ΠΎΠ²Π°ΡΡ ΡΠ΅ΡΡΠ°ΡΠΈΠΊΠ»ΠΈΠ½ΠΎΠ²ΡΡ ΠΌΠ°Π·Ρ, β Π΅Π΅ Π½ΡΠΆΠ½ΠΎ Π·Π°Π»ΠΎΠΆΠΈΡΡ Π·Π° Π²Π΅ΠΊΠΈ.
ΠΡΠΈ ΠΎΡΡΡΠΎΠΌ Π·Π°Π±ΠΎΠ»Π΅Π²Π°Π½ΠΈΠΈ ΡΠ΅ΠΊΠΎΠΌΠ΅Π½Π΄ΡΠ΅ΡΡΡ ΡΠ°ΡΡΠΎ ΠΏΡΠΎΠΌΡΠ²Π°ΡΡ Π³Π»Π°Π·Π½ΠΎΠ΅ ΡΠ±Π»ΠΎΠΊΠΎ, ΡΡΠΎΠ±Ρ ΡΡΡΡΠ°Π½ΠΈΡΡ Π³Π½ΠΎΠΉΠ½ΡΠ΅ Π²ΡΠ΄Π΅Π»Π΅Π½ΠΈΡ. Π‘ ΡΡΠΎΠΉ ΡΠ΅Π»ΡΡ ΠΏΡΠΈΠΌΠ΅Π½ΡΠ΅ΡΡΡ Π±ΠΎΡΠ½Π°Ρ ΠΊΠΈΡΠ»ΠΎΡΠ° ( Π΄Π²ΡΡ ΠΏΡΠΎΡΠ΅Π½ΡΠ½ΡΠΉ ΡΠ°ΡΡΠ²ΠΎΡ), ΡΠ°ΡΡΠ²ΠΎΡ ΡΡΡΠ°ΡΠΈΠ»ΠΈΠ½Π° (1: 5000). ΠΠ»Ρ Π·Π°ΠΊΠ°ΠΏΡΠ²Π°Π½ΠΈΡ ΠΌΠΎΠΆΠ½ΠΎ ΠΈΡΠΏΠΎΠ»ΡΠ·ΠΎΠ²Π°ΡΡ ΡΠΎΠ²ΡΠ΅ΠΌΠ΅Π½Π½ΡΠ΅ ΠΏΡΠΎΡΠΈΠ²ΠΎΠΌΠΈΠΊΡΠΎΠ±Π½ΡΠ΅ ΠΏΡΠ΅ΠΏΠ°ΡΠ°ΡΡ, Π½Π°ΠΏΡΠΈΠΌΠ΅Ρ, ΠΠΊΠΎΠΌΠΈΡΡΠΈΠ½. ΠΡΠΎ Π»Π΅ΠΊΠ°ΡΡΡΠ²ΠΎ ΡΠΈΡΠΎΠΊΠΎ ΠΈΡΠΏΠΎΠ»ΡΠ·ΡΠ΅ΡΡΡ ΠΊΠ°ΠΊ Π»Π΅ΡΠ΅Π±Π½ΠΎΠ΅ ΠΈ ΠΏΡΠΎΡΠΈΠ»Π°ΠΊΡΠΈΡΠ΅ΡΠΊΠΎΠ΅ ΡΡΠ΅Π΄ΡΡΠ²ΠΎ, ΠΊΠΎΡΠΎΡΠΎΠ΅ Π²Π»ΠΈΡΠ΅Ρ Π½Π΅ ΡΠΎΠ»ΡΠΊΠΎ Π½Π° Π±Π°ΠΊΡΠ΅ΡΠΈΠΈ, Π½ΠΎ ΠΈ Π½Π° Π²ΠΈΡΡΡΡ, Π³ΡΠΈΠ±ΠΊΠΈ, ΠΏΡΠΎΡΡΠ΅ΠΉΡΠΈΠ΅.
ΠΠ΅ΡΠ΅Π½ΠΈΠ΅ Π½Π°ΡΠΎΠ΄Π½ΡΠΌΠΈ ΡΡΠ΅Π΄ΡΡΠ²Π°ΠΌΠΈ
ΠΠ΅ΡΠ΅Π½ΠΈΠ΅ ΠΊΠΎΠ½ΡΡΠ½ΠΊΡΠΈΠ²ΠΈΡΠ° ΡΠΎΠΊΠΎΠΌ Π°Π»ΠΎΡ
ΠΠ· Π»ΠΈΡΡΡΠ΅Π² Π°Π»ΠΎΡ Π²ΡΠΆΠ°ΡΡ ΡΠΎΠΊ, ΠΈ ΡΠ°Π·Π²Π΅ΡΡΠΈ Π΅Π³ΠΎ ΠΊΠΈΠΏΡΡΠ΅Π½ΠΎΠΉ Π²ΠΎΠ΄ΠΎΠΉ Π² ΡΠΎΠΎΡΠ½ΠΎΡΠ΅Π½ΠΈΠΈ ΠΎΠ΄ΠΈΠ½ ΠΊ Π΄Π΅ΡΡΡΠΈ. ΠΠ°ΠΏΠ°ΡΡ Π² ΠΊΠ°ΠΆΠ΄ΡΠΉ Π³Π»Π°Π· ΡΡΠΈΠΆΠ΄Ρ Π² Π΄Π΅Π½Ρ.
ΠΠΎΠΌΠΏΡΠ΅ΡΡ ΠΈΠ· ΡΠ΅ΡΠ½ΠΎΠ³ΠΎ ΡΠ°Ρ
ΠΠ°Π²Π°ΡΠΊΠ° Β ΠΊΡΠ΅ΠΏΠΊΠΎΠ³ΠΎ ΡΠ΅ΡΠ½ΠΎΠ³ΠΎ ΡΠ°Ρ ΠΎΡ Π»Π°ΠΆΠ΄Π°Π΅ΡΡΡ Π΄ΠΎ ΠΊΠΎΠΌΠ½Π°ΡΠ½ΠΎΠΉ ΡΠ΅ΠΌΠΏΠ΅ΡΠ°ΡΡΡΡ. ΠΠ΅Π»Π°ΡΡ ΠΊΠΎΠΌΠΏΡΠ΅ΡΡΡ Π½Π° Π²ΠΎΡΠΏΠ°Π»Π΅Π½Π½ΡΠ΅ Π³Π»Π°Π·Π°. Β ΠΠΎΠ»ΠΈΡΠ΅ΡΡΠ²ΠΎ ΠΏΡΠΎΡΠ΅Π΄ΡΡ Π½Π΅ ΠΎΠ³ΡΠ°Π½ΠΈΡΠ΅Π½ΠΎ, ΡΠ΅ΠΌ ΡΠ°ΡΠ΅, ΡΠ΅ΠΌ Π»ΡΡΡΠ΅. Π‘Π½ΠΈΠΌΠ°Π΅Ρ Π²ΠΎΡΠΏΠ°Π»Π΅Π½ΠΈΠ΅ ΠΈ ΡΡΠΊΠΎΡΡΠ΅Ρ Π²ΡΠ·Π΄ΠΎΡΠΎΠ²Π»Π΅Π½ΠΈΠ΅.
ΠΠ°Π·Ρ ΠΈΠ· ΡΠΈΡΠ½ΡΡ Π±Π΅Π»ΠΊΠΎΠ²
ΠΠ΅Π»ΠΊΠΈ ΡΠΈΡ Π² ΠΊΠΎΠ»ΠΈΡΠ΅ΡΡΠ²Π΅ Π΄Π²ΡΡ ΡΡΡΠΊ ΡΠΌΠ΅ΡΠ°ΡΡ Ρ ΠΏΠΎΠ»ΡΡΠ°ΠΊΠ°Π½Π° ΠΎΡ Π»Π°ΠΆΠ΄Π΅Π½Π½ΠΎΠΉ ΠΊΠΈΠΏΡΡΠ΅Π½ΠΎΠΉ Π²ΠΎΠ΄Ρ.Β ΠΡΠ΄Π΅ΡΠΆΠ°ΡΡ ΠΏΠΎΠ»ΡΠ°ΡΠ° Π² ΡΠ΅ΠΌΠ½ΠΎΡΠ΅. Π‘ΠΌΠ°Π·ΡΠ²Π°ΡΡ Π²ΠΎΡΠΏΠ°Π»Π΅Π½Π½ΡΠ΅ Π³Π»Π°Π·Π° Π·Π° ΡΠ΅ΡΠ²Π΅ΡΡΡ ΡΠ°ΡΠ° ΠΏΠ΅ΡΠ΅Π΄ ΡΠ½ΠΎΠΌ.
ΠΠ°ΡΠ»ΠΎ Π³ΡΠ΅ΡΠΊΠΈΡ ΠΎΡΠ΅Ρ ΠΎΠ²
ΠΡΠΈ ΠΊΠΎΠ½ΡΡΠ½ΠΊΡΠΈΠ²ΠΈΡΠ΅ ΠΏΠΎΠΌΠΎΠ³Π°Π΅Ρ ΠΌΠ°ΡΠ»ΠΎ Π³ΡΠ΅ΡΠΊΠΈΡ ΠΎΡΠ΅Ρ ΠΎΠ². Π‘Π»Π΅Π΄ΡΠ΅Ρ Π½Π°Π½ΠΎΡΠΈΡΡ Π΅Π³ΠΎ Π½Π° Π²Π΅ΠΊΠΈ Π΄ΠΎ ΡΠ΅ΡΡΡΠ΅Ρ ΡΠ°Π· Π² Π΄Π΅Π½Ρ, ΠΏΠΎΠΊΠ° Π²ΠΎΡΠΏΠ°Π»Π΅Π½ΠΈΠ΅ Π½Π΅ ΠΏΡΠ΅ΠΊΡΠ°ΡΠΈΡΡΡ.
ΠΡΠΎΡΠΈΠ»Π°ΠΊΡΠΈΠΊΠ° ΠΊΠΎΠ½ΡΡΠ½ΠΊΡΠΈΠ²ΠΈΡΠ°
ΠΠ°Π½Π½ΠΎΠ΅ Π·Π°Π±ΠΎΠ»Π΅Π²Π°Π½ΠΈΠ΅ ΠΏΠ΅ΡΠ΅Π΄Π°Π΅ΡΡΡ ΠΏΠΎΡΡΠ΅Π΄ΡΡΠ²ΠΎΠΌ Π½Π΅ΠΌΡΡΡΡ ΡΡΠΊ, ΠΏΡΠΈ ΠΎΠ±ΡΠ΅Π½ΠΈΠΈ Ρ Π±ΠΎΠ»ΡΠ½ΡΠΌ ΡΠ΅Π»ΠΎΠ²Π΅ΠΊΠΎΠΌ, Π²ΠΎΠ·Π΄ΡΡΠ½ΠΎ ΠΊΠ°ΠΏΠ΅Π»ΡΠ½ΡΠΌ ΠΏΡΡΠ΅ΠΌ.Β Π§ΡΠΎΠ±Ρ ΠΈΠ·Π±Π΅ΠΆΠ°ΡΡ ΠΈΠ½ΡΠ΅ΠΊΡΠΈΠΈ, Π³Π»Π°Π²Π½ΠΎΠ΅, ΡΡΠΎ Π²Ρ Π΄ΠΎΠ»ΠΆΠ½Ρ Π΄Π΅Π»Π°ΡΡ β ΡΠΎΠ±Π»ΡΠ΄Π°ΡΡ Π»ΠΈΡΠ½ΡΡ Π³ΠΈΠ³ΠΈΠ΅Π½Ρ. ΠΡΠΎΠ±Π΅Π½Π½ΠΎ ΡΡΠΎΠΈΡ ΠΏΠΎΠ΄ΡΠ΅ΡΠΊΠ½ΡΡΡ, ΡΡΠΎ Π½ΠΈ Π² ΠΊΠΎΠ΅ΠΌ ΡΠ»ΡΡΠ°Π΅ Π½Π΅Π»ΡΠ·Ρ ΡΡΠΎΠ³Π°ΡΡ Π³Π»Π°Π·Π°, Π΅ΡΠ»ΠΈ Π²Ρ Π½Π΅ ΡΠ²Π΅ΡΠ΅Π½Ρ Π² ΡΠΈΡΡΠΎΡΠ΅ ΡΡΠΊ.Β ΠΡΠ»ΠΈ Π²Ρ Π²ΡΠ½ΡΠΆΠ΄Π΅Π½Ρ ΠΎΠ±ΡΠ°ΡΡΡΡ Ρ ΡΠ΅Π»ΠΎΠ²Π΅ΠΊΠΎΠΌ, ΠΊΠΎΡΠΎΡΡΠΉ Π±ΠΎΠ»Π΅Π½ ΠΊΠΎΠ½ΡΡΠ½ΠΊΡΠΈΠ²ΠΈΡΠΎΠΌ, Π΄Π»Ρ ΠΏΡΠΎΡΠΈΠ»Π°ΠΊΡΠΈΠΊΠΈ Π·Π°ΠΊΠ°ΠΏΡΠ²Π°ΠΉΡΠ΅ Π² Π³Π»Π°Π·Π° ΠΠΊΠΎΠΌΠΈΡΡΠΈΠ½ Π² ΡΠ΅ΡΠ΅Π½ΠΈΠ΅ ΡΡΠ΅Ρ Π΄Π½Π΅ΠΉ.
ΠΠ΅ Π·Π½Π°Π΅ΡΠ΅ ΠΊΠ°ΠΊ ΠΏΠΎΠ΄ΠΎΠ±ΡΠ°ΡΡ ΠΊΠ»ΠΈΠ½ΠΈΠΊΡ ΠΈΠ»ΠΈ Π²ΡΠ°ΡΠ° ΠΏΠΎ ΠΏΡΠΈΠ΅ΠΌΠ»Π΅ΠΌΡΠΌ ΡΠ΅Π½Π°ΠΌ? ΠΠ΄ΠΈΠ½ΡΠΉ ΡΠ΅Π½ΡΡ Π·Π°ΠΏΠΈΡΠΈ ΠΏΠΎ ΡΠ΅Π»Π΅ΡΠΎΠ½Ρ +7Β (499)Β 519-32-84.Β
www.knigamedika.ru
ΠΠΎΠ½ΡΡΠ½ΠΊΡΠΈΠ²ΠΈΡ Β - ΡΡΠΎ Β Π²ΠΎΡΠΏΠ°Π»Π΅Π½ΠΈΠ΅ ΡΠ»ΠΈΠ·ΠΈΡΡΠΎΠΉ ΠΎΠ±ΠΎΠ»ΠΎΡΠΊΠΈ Π³Π»Π°Π·Π°. ΠΠ° ΡΠ΅Π³ΠΎΠ΄Π½ΡΡΠ½ΠΈΠΉ Π΄Π΅Π½Ρ ΠΊΠΎΠ½ΡΡΠ½ΠΊΡΠΈΠ²ΠΈΡ Π΄ΠΎΠ²ΠΎΠ»ΡΠ½ΠΎ ΡΠ°ΡΠΏΡΠΎΡΡΡΠ°Π½Π΅Π½Π½ΠΎΠ΅ Π·Π°Π±ΠΎΠ»Π΅Π²Π°Π½ΠΈΠ΅. ΠΡΠΈΡΠΈΠ½Ρ Π½Π°ΡΡΡΠΏΠ»Π΅Π½ΠΈΡ ΠΌΠΎΠ³ΡΡ Π±ΡΡΡ ΡΠ°ΠΌΡΠΌΠΈ ΡΠ°Π·Π½ΡΠΌΠΈ. ΠΠΎΡΠΏΠ°Π»ΠΈΡΠ΅Π»ΡΠ½ΡΠΉ ΠΏΡΠΎΡΠ΅ΡΡ ΠΌΠΎΠΆΠ΅Ρ ΡΠΏΡΠΎΠ²ΠΎΡΠΈΡΠΎΠ²Π°ΡΡ Π±Π°Π½Π°Π»ΡΠ½ΠΎΠ΅ ΠΏΠΎΠΏΠ°Π΄Π°Π½ΠΈΠ΅ Π² Π³Π»Π°Π·Π° ΠΏΡΠ»ΠΈ ΠΈΠ»ΠΈ Π±ΡΡΠΎΠ²ΠΎΠΉ Ρ
ΠΈΠΌΠΈΠΈ; ΠΏΡΠΎΡΠ΅ΠΊΠ°ΡΡΠΈΠ΅ Π·Π°Π±ΠΎΠ»Π΅Π²Π°Π½ΠΈΡ Π² Π½ΠΎΡΡ ΠΈ Π² Π³Π°ΠΉΠΌΠΎΡΠΎΠ²ΡΡ
ΠΏΠ°Π·ΡΡ
Π°Ρ
; Π½Π΅Π΄ΠΎΡΡΠ°ΡΠΎΠΊ Π²ΠΈΡΠ°ΠΌΠΈΠ½ΠΎΠ²; Π½Π°ΡΡΡΠ΅Π½ΠΈΠ΅ ΠΎΠ±ΠΌΠ΅Π½Π½ΡΡ
ΠΏΡΠΎΡΠ΅ΡΡΠΎΠ². ΠΡΠ·ΡΠ²Π°ΡΡ ΠΊΠΎΠ½ΡΡΠ½ΠΊΡΠΈΠ²ΠΈΡΡ ΠΈ Π·Π°Π±ΠΎΠ»Π΅Π²Π°Π½ΠΈΡ Π²Π΅ΠΊ.
ΠΡΠΎΡΠ°Ρ ΡΠΎΡΠΌΠ° - Π±Π°ΠΊΡΠ΅ΡΠΈΠ°Π»ΡΠ½ΡΠΉ ΠΊΠΎΠ½ΡΡΠ½ΠΊΡΠΈΠ²ΠΈΡ. ΠΠΎΡΠ°ΠΆΠ°ΡΡΡΡ ΡΡΠ°Π·Ρ ΠΎΠ±Π° Π³Π»Π°Π·Π°, ΡΠΆΠ΅ Π½Π° ΠΏΠ΅ΡΠ²ΠΎΠΉ ΡΡΠ°Π΄ΠΈΠΈ Π±ΠΎΠ»Π΅Π·Π½Ρ ΡΠΎΠΏΡΠΎΠ²ΠΎΠΆΠ΄Π°ΡΡ ΠΎΠ±ΠΈΠ»ΡΠ½ΡΠ΅ Π³Π½ΠΎΠΉΠ½ΡΠ΅ Π²ΡΠ΄Π΅Π»Π΅Π½ΠΈΡ.